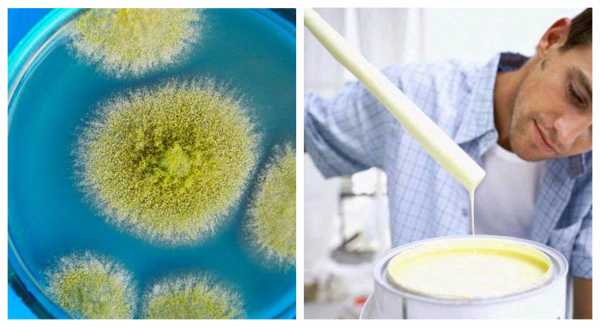

Π‘ΠΈΠ»ΠΈΠΊΠΎΠ½ΠΎΠ²Π°Ρ ΠΊΡΠ°ΡΠΊΠ° Π΄Π»Ρ ΡΠ°ΡΠ°Π΄Π° Ρ Π°ΡΠ°ΠΊΡΠ΅ΡΠΈΡΡΠΈΠΊΠ° β ΠΏΠ»ΡΡΡ ΠΈ ΠΌΠΈΠ½ΡΡΡ ΠΏΠΎΠΊΡΡΡΠΈΡ Π΄Π»Ρ ΡΠ°ΡΠ°Π΄Π° Π½Π° ΡΠΈΠ»ΠΈΠΊΠΎΠ½ΠΎΠ²ΠΎΠΉ ΠΎΡΠ½ΠΎΠ²Π΅ + ΡΠ΅Ρ Π½ΠΈΡΠ΅ΡΠΊΠΈΠ΅ Ρ Π°ΡΠ°ΠΊΡΠ΅ΡΠΈΡΡΠΈΠΊΠΈ
Π‘ΠΈΠ»ΠΈΠΊΠΎΠ½ΠΎΠ²Π°Ρ ΠΊΡΠ°ΡΠΊΠ°:Π΄Π»Ρ ΡΠ°ΡΠ°Π΄Π°, ΡΡΠ΅Π½ ΠΈ ΠΏΠΎΡΠΎΠ»ΠΊΠ°, ΠΊΠ°ΠΊ Π²ΡΠ±ΡΠ°ΡΡ
ΠΠ° ΡΠ΅Π³ΠΎΠ΄Π½ΡΡΠ½ΠΈΠΉ Π΄Π΅Π½Ρ ΡΠΈΠ»ΠΈΠΊΠΎΠ½ΠΎΠ²Π°Ρ ΡΠ°ΡΠ°Π΄Π½Π°Ρ ΠΊΡΠ°ΡΠΊΠ° ΡΠ²Π»ΡΠ΅ΡΡΡ ΡΠ°ΠΌΡΠΌ ΠΏΠΎΠΏΡΠ»ΡΡΠ½ΡΠΌ ΠΌΠ°ΡΠ΅ΡΠΈΠ°Π»ΠΎΠΌ Π΄Π»Ρ Π²Π½Π΅ΡΠ½Π΅ΠΉ ΠΎΡΠ΄Π΅Π»ΠΊΠΈ Π·Π΄Π°Π½ΠΈΠΉ. Π’Π°ΠΊΠ°Ρ ΡΠ°Π·Π½ΠΎΠ²ΠΈΠ΄Π½ΠΎΡΡΡ ΠΏΠΎΡΠ²ΠΈΠ»Π°ΡΡ Π½Π° ΡΡΠ½ΠΊΠ΅ Π·Π½Π°ΡΠΈΡΠ΅Π»ΡΠ½ΠΎ ΠΏΠΎΠ·ΠΆΠ΅, ΡΠ΅ΠΌ Π°ΠΊΡΠΈΠ»ΠΎΠ²ΡΠ΅ ΠΈ ΡΠΈΠ»ΠΈΠΊΠ°ΡΠ½ΡΠ΅ Π°Π½Π°Π»ΠΎΠ³ΠΈ. ΠΡΠΎ Π½Π΅ ΠΏΠΎΠΌΠ΅ΡΠ°Π»ΠΎ Π΅ΠΉ Π·Π°Π²ΠΎΠ΅Π²Π°ΡΡ ΡΡΠ½ΠΎΠΊ ΠΈ ΡΡΠ°ΡΡ Π²ΠΎΡΡΡΠ΅Π±ΠΎΠ²Π°Π½Π΅Π΅ Π΄ΡΡΠ³ΠΈΡ
. ΠΡΠ΅ Π±Π»Π°Π³ΠΎΠ΄Π°ΡΡ Ρ
ΠΎΡΠΎΡΠΈΠΌ Ρ
Π°ΡΠ°ΠΊΡΠ΅ΡΠΈΡΡΠΈΠΊΠ°ΠΌ ΠΏΡΠΈ ΡΠΊΡΠΏΠ»ΡΠ°ΡΠ°ΡΠΈΠΈ, Π² ΠΊΠΎΡΠΎΡΡΡ
Π΅ΡΡΡ Π²ΡΠ΅ ΠΏΡΠ΅ΠΈΠΌΡΡΠ΅ΡΡΠ²Π° Π΄ΡΡΠ³ΠΈΡ
ΡΠΎΡΡΠ°Π²ΠΎΠ² ΠΊΡΠ°ΡΠΎΠΊ.
ΠΡΠ»ΠΈΡΠΈΡ ΠΎΡ ΡΠΈΠ»ΠΈΠΊΠ°ΡΠ½ΠΎΠΉ ΠΊΡΠ°ΡΠΊΠΈ
ΠΠΎ ΠΌΠ½Π΅Π½ΠΈΡ ΠΌΠ½ΠΎΠ³ΠΈΡ
Π»ΡΠ΄Π΅ΠΉ, ΡΠΈΠ»ΠΈΠΊΠ°ΡΠ½ΡΠ΅ ΠΏΠΎΠΊΡΡΡΠΈΡ ΠΈ ΡΠΈΠ»ΠΈΠΊΠΎΠ½ΠΎΠ²ΡΠ΅ β ΠΎΠ΄Π½ΠΎ ΠΈ ΡΠΎ ΠΆΠ΅. ΠΠΎ ΠΈΡ
ΡΠΎΡΡΠ°Π² ΠΎΡΠ΅Π½Ρ ΠΎΡΠ»ΠΈΡΠ°Π΅ΡΡΡ.
Π‘ΠΈΠ»ΠΈΠΊΠΎΠ½ΠΎΠ²Π°Ρ ΠΊΡΠ°ΡΠΊΠ° β Π½Π°ΡΡΡΠ°Π»ΡΠ½ΡΠΉ ΠΌΠ°ΡΠ΅ΡΠΈΠ°Π» Π΄Π»Ρ ΠΎΡΠ΄Π΅Π»ΠΊΠΈ ΡΡΠ΅Π½. ΠΡ ΠΎΡΠ½ΠΎΠ²Ρ ΡΠΎΡΡΠ°Π²Π»ΡΠ΅Ρ ΠΆΠΈΠ΄ΠΊΠΎΠ΅ ΠΊΠ°Π»ΠΈΠΉΠ½ΠΎΠ΅ ΡΡΠ΅ΠΊΠ»ΠΎ. ΠΠ°Π»ΠΈΠΉΠ½ΠΎΠ΅ ΡΡΠ΅ΠΊΠ»ΠΎ β ΡΡΠΎ Π²ΠΎΠ΄Π½ΡΠΉ ΡΠ°ΡΡΠ²ΠΎΡ ΠΊΠ°Π»ΠΈΡ ΠΈΠ»ΠΈ ΡΠΈΠ»ΠΈΠΊΠ°ΡΠ° ΠΊΠ°Π»ΠΈΡ. Π ΠΏΠΎΡΠ»Π΅Π΄Π½ΠΈΠ΅ Π³ΠΎΠ΄Ρ ΡΠ°ΡΠ΅ ΡΡΠ°Π»ΠΈ ΠΈΡΠΏΠΎΠ»ΡΠ·ΠΎΠ²Π°ΡΡ ΡΠ°ΡΡΠ²ΠΎΡ ΠΊΠ°Π»ΠΈΡ, ΠΎΠ½ Π½Π°ΠΌΠ½ΠΎΠ³ΠΎ Π»ΡΡΡΠ΅ ΡΠΈΠ»ΠΈΠΊΠ°ΡΠ° ΠΏΠΎ Ρ Π°ΡΠ°ΠΊΡΠ΅ΡΠΈΡΡΠΈΠΊΠ°ΠΌ ΡΠΊΡΠΏΠ»ΡΠ°ΡΠ°ΡΠΈΠΈ.
Π‘ΠΈΠ»ΠΈΠΊΠ°ΡΠ½ΡΠ΅ ΡΠ°ΡΠ°Π΄Π½ΡΠ΅ ΠΌΠ°ΡΠ΅ΡΠΈΠ°Π»Ρ ΠΎΡΠ½ΠΎΡΡΡΡΡ ΠΊ ΡΠ°ΠΌΡΠΌ ΡΡΠΎΠΉΠΊΠΈΠΌ ΡΡΠ΅Π΄ΠΈ ΠΎΡΡΠ°Π»ΡΠ½ΡΡ ΠΎΡΠ΄Π΅Π»ΠΎΡΠ½ΡΡ ΠΌΠ°ΡΠ΅ΡΠΈΠ°Π»ΠΎΠ². ΠΡ ΡΠ°ΡΡΠΎ ΠΏΡΡΠ°ΡΡ Ρ Π΄ΠΈΡΠΏΠ΅ΡΡΠΈΠΎΠ½Π½ΡΠΌ ΡΠΎΡΡΠ°Π²ΠΎΠΌ ΡΠΈΠ»ΠΈΠΊΠ°ΡΠ°. ΠΠΎ Ρ ΠΈΠΌΠΈΡΠ΅ΡΠΊΠΎΠΌΡ ΡΠΎΡΡΠ°Π²Ρ ΠΎΠ½ΠΈ Π±Π»ΠΈΠ·ΠΊΠΈ, Π½ΠΎ Π² ΡΠΎΡΡΠ°Π² Π΄ΠΈΡΠΏΠ΅ΡΡΠΈΠΈ Π²Ρ ΠΎΠ΄ΠΈΡ ΡΠΈΡΡΡΠΉ Π°ΠΊΡΠΈΠ», ΠΊΠΎΡΠΎΡΡΠΉ Π·Π½Π°ΡΠΈΡΠ΅Π»ΡΠ½ΠΎ ΡΠΊΠΎΠ½ΠΎΠΌΠΈΡ Π½Π° ΠΏΡΠΎΠΈΠ·Π²ΠΎΠ΄ΡΡΠ²Π΅. ΠΠ½ Π²ΡΡΡΡΠΏΠ°Π΅Ρ ΠΊΠ°ΠΊ ΡΠ²ΡΠ·ΡΡΡΠΈΠΉ ΠΌΠ°ΡΠ΅ΡΠΈΠ°Π», Π½ΠΎ ΠΏΡΠΈ ΡΠΊΡΠΏΠ»ΡΠ°ΡΠ°ΡΠΈΠΈ ΡΠ°ΠΊΠ°Ρ ΠΊΡΠ°ΡΠΊΠ° ΠΈΠΌΠ΅Π΅Ρ Ρ ΡΠ΄ΡΠΈΠ΅ ΠΏΠΎΠΊΠ°Π·Π°ΡΠ΅Π»ΠΈ. Π§Π°ΡΡΠΎ ΡΠΎΠ΄Π΅ΡΠΆΠ°Π½ΠΈΠ΅ Π°ΠΊΡΠΈΠ»Π° Π² ΠΊΡΠ°ΡΠΊΠ΅ Π΄ΠΎΡΡΠΈΠ³Π°Π΅Ρ 8%. ΠΠΈΡΠΏΠ΅ΡΡΠΈΡ Π΄Π»Ρ ΡΡΠ΅Π½, Π² ΠΎΡΠ»ΠΈΡΠΈΠ΅ ΠΎΡ ΠΌΠ°ΡΠ΅ΡΠΈΠ°Π»Π° Π² ΡΠΈΡΡΠΎΠΌ Π²ΠΈΠ΄Π΅, Π² ΠΏΡΠΎΠ΄Π°ΠΆΠ΅ ΠΏΡΠ΅Π΄ΡΡΠ°Π²Π»Π΅Π½Π° Π² ΡΠ°Π·Π²Π΅Π΄ΡΠ½Π½ΠΎΠΌ Π²ΠΈΠ΄Π΅. Π Π°Π·Π±Π°Π²Π»Π΅Π½Π½Π°Ρ Π΄ΠΈΡΠΏΠ΅ΡΡΠΈΠΎΠ½Π½Π°Ρ ΠΊΡΠ°ΡΠΊΠ° ΡΠ²Π»ΡΠ΅ΡΡΡ ΠΎΠ΄Π½ΠΎΠΊΠΎΠΌΠΏΠΎΠ½Π΅Π½ΡΠ½ΡΠΌ ΡΠΎΡΡΠ°Π²ΠΎΠΌ, ΠΊΠΎΡΠΎΡΡΠΉ ΠΌΠΎΠΆΠ½ΠΎ ΡΡΠ°Π·Ρ ΠΆΠ΅ ΠΈΡΠΏΠΎΠ»ΡΠ·ΠΎΠ²Π°ΡΡ.
Π ΡΠΈΡΡΠΎΠΌ Π²ΠΈΠ΄Π΅ ΡΠΎΡΡΠ°Π² ΡΠΈΠ»ΠΈΠΊΠ°ΡΠ½ΠΎΠΉ ΠΊΡΠ°ΡΠΊΠΈ Π²Ρ ΠΎΠ΄ΠΈΡ Π΄Π²Π° ΠΊΠΎΠΌΠΏΠΎΠ½Π΅Π½ΡΠ° β ΠΏΠΎΡΠΎΡΠΎΠΊ ΠΈ ΡΡΠ΅ΠΊΠ»ΠΎ Π² ΠΆΠΈΠ΄ΠΊΠΎΠΌ Π²ΠΈΠ΄Π΅. Π ΡΠ°Π·Π²Π΅Π΄ΡΠ½Π½ΠΎΠΌ Π²ΠΈΠ΄Π΅ ΡΠ°ΠΊΠΎΠΉ ΡΠΎΡΡΠ°Π² Ρ ΡΠ°Π½ΠΈΡΡΡ Π½Π΅Π΄ΠΎΠ»Π³ΠΎ, ΠΏΠΎΡΠΎΠΌΡ ΡΡΠΎ ΠΌΠ°ΡΠ΅ΡΠΈΠ°Π» ΡΠΊΠ»ΠΎΠ½Π΅Π½ ΠΊ Π±ΡΡΡΡΠΎΠΌΡ ΠΏΡΠΎΡΠ΅ΡΡΡ ΠΊΠ°ΡΠ±ΠΎΠ½ΠΈΠ·Π°ΡΠΈΠΈ. Π’Π°ΠΊΠ°Ρ ΠΊΡΠ°ΡΠΊΠ° ΠΎΠ±Π»Π°Π΄Π°Π΅Ρ Ρ ΠΎΡΠΎΡΠΈΠΌΠΈ ΡΠΊΡΠΏΠ»ΡΠ°ΡΠ°ΡΠΈΠΎΠ½Π½ΡΠΌΠΈ ΡΠ²ΠΎΠΉΡΡΠ²Π°ΠΌΠΈ. ΠΠΌΠ΅Π΅Ρ Π²ΡΡΠΎΠΊΡΡ Π΄ΠΈΡΡΡΠ·ΠΈΡ ΠΈ ΠΏΠ°ΡΠΎΠΏΡΠΎΠ½ΠΈΡΠ°Π΅ΠΌΠΎΡΡΡ.
Π‘ΠΈΠ»ΠΈΠΊΠ°ΡΠ½Π°Ρ ΠΊΡΠ°ΡΠΊΠ° Π΄Π»Ρ ΡΠ°ΡΠ°Π΄ΠΎΠ² Ρ ΠΎΡΠΎΡΠΎ ΠΏΠΎΠ΄Ρ ΠΎΠ΄ΠΈΡ Π΄Π»Ρ ΡΡΠ΅Π½, ΡΡΠ΅ΠΏΠ»ΡΠ½Π½ΡΡ ΠΏΠ΅Π½ΠΎΠΏΠΎΠ»ΠΈΡΡΠΈΡΠΎΠ»ΠΎΠΌ, Π²Π΅Π΄Ρ ΠΎΠ½Π° ΠΏΠΎΠ·Π²ΠΎΠ»ΡΠ΅Ρ ΠΏΠΎΠ²Π΅ΡΡ Π½ΠΎΡΡΠΈ Π΄ΡΡΠ°ΡΡ. Π§Π°ΡΡΠΎ Π΅Ρ ΠΈΡΠΏΠΎΠ»ΡΠ·ΡΡΡ Π΄Π»Ρ ΠΏΠΎΠ²Π΅ΡΡ Π½ΠΎΡΡΠ΅ΠΉ, ΠΈΠ·Π³ΠΎΡΠΎΠ²Π»Π΅Π½Π½ΡΡ ΠΈΠ· Π½Π°ΡΡΡΠ°Π»ΡΠ½ΡΡ ΠΌΠ°ΡΠ΅ΡΠΈΠ°Π»ΠΎΠ² ΠΈΠ»ΠΈ ΡΠΎΠ΄Π΅ΡΠΆΠ°ΡΠΈΡ ΠΏΠ΅ΡΠΎΠΊ. Π‘ΠΈΠ»ΠΈΠΊΠ°ΡΠ½ΡΠ΅ ΠΏΠΎΠΊΡΡΡΠΈΡ ΡΠ°ΠΊΠΆΠ΅ ΡΠΎΡΠ΅ΡΠ°ΡΡΡΡ Ρ ΠΈΠ·Π²Π΅ΡΡΠΊΠΎΠ²ΡΠΌΠΈ ΡΡΡΠΊΠ°ΡΡΡΠΊΠ°ΠΌΠΈ. ΠΠΎ Π½Π΅ ΠΏΠΎΠ΄ΠΎΠΉΠ΄ΡΡ Π΄Π»Ρ ΠΏΠΎΠ²Π΅ΡΡ Π½ΠΎΡΡΠ΅ΠΉ ΠΈΠ· ΡΠΈΠ½ΡΠ΅ΡΠΈΡΠ΅ΡΠΊΠΈΡ ΠΌΠ°ΡΠ΅ΡΠΈΠ°Π»ΠΎΠ².
Π‘ΠΈΠ»ΠΈΠΊΠ°ΡΠ½ΡΠ΅ Π»Π°ΠΊΠΎΠΊΡΠ°ΡΠΎΡΠ½ΡΠ΅ ΠΌΠ°ΡΠ΅ΡΠΈΠ°Π»Ρ ΠΈΠΌΠ΅ΡΡ Π²ΡΡΠΎΠΊΡΡ Π°Π΄Π³Π΅Π·ΠΈΡ. ΠΡΠΈ ΠΏΠΎΡΠ»Π΅Π΄ΡΡΡΠ΅ΠΌ ΡΠ΅ΠΌΠΎΠ½ΡΠ΅ ΠΏΠΎΠΊΡΡΡΠΈΠ΅ Π±ΡΠ΄Π΅Ρ ΠΎΡΠ΅Π½Ρ ΡΡΠΆΠ΅Π»ΠΎ ΡΠ½ΡΡΡ. ΠΡΠ°ΡΠΊΠ° ΠΈΠΌΠ΅Π΅Ρ ΠΎΠ³ΡΠ°Π½ΠΈΡΠ΅Π½Π½ΡΡ ΠΏΠ°Π»ΠΈΡΡΡ ΡΠ²Π΅ΡΠΎΠ², ΠΊΠΎΡΠΎΡΡΠ΅ Π°Π±ΡΠΎΠ»ΡΡΠ½ΠΎ Π½Π΅ ΡΠΏΠΎΡΠΎΠ±Π½Ρ ΠΏΡΠΎΡΠΈΠ²ΠΎΡΡΠΎΡΡΡ ΠΏΡΡΠΌΡΠΌ ΡΠΎΠ»Π½Π΅ΡΠ½ΡΠΌ Π»ΡΡΠ°ΠΌ.
ΠΠ»Π°Π²Π½ΠΎΠ΅ ΠΏΡΠ΅ΠΈΠΌΡΡΠ΅ΡΡΠ²ΠΎ ΡΠΈΠ»ΠΈΠΊΠ°ΡΠΎΠ² Π² ΡΠΎΠΌ, ΡΡΠΎ ΠΎΠ½ΠΈ Π½Π΅ Π½Π°ΠΊΠ°ΠΏΠ»ΠΈΠ²Π°ΡΡ ΡΡΠ°ΡΠΈΡΠ΅ΡΠΊΠΎΠ΅ ΡΠ»Π΅ΠΊΡΡΠΈΡΠ΅ΡΡΠ²ΠΎ. ΠΠ»Π°Π³ΠΎΠ΄Π°ΡΡ ΡΡΠΎΠΌΡ Π½Π° ΡΠ°ΡΠ°Π΄Π΅ Π·Π΄Π°Π½ΠΈΡ Π±ΡΠ΄Π΅Ρ ΠΌΠ΅Π½ΡΡΠ΅ ΠΏΡΠ»ΠΈ. Π ΡΠ°ΠΊΠΆΠ΅ Π½Π° Π½ΡΠΌ Π½ΠΈΠΊΠΎΠ³Π΄Π° Π½Π΅ ΠΏΠΎΡΠ²ΠΈΡΡΡ Π³ΡΠΈΠ±ΠΎΠΊ ΠΈ ΠΏΠ»Π΅ΡΠ΅Π½Ρ.
ΠΠ°ΠΆΠ½ΠΎ ΠΏΡΠΈ Π²ΡΠ±ΠΎΡΠ΅ Π»Π°ΠΊΠΎΠΊΡΠ°ΡΠΎΡΠ½ΡΡ ΠΌΠ°ΡΠ΅ΡΠΈΠ°Π»ΠΎΠ² ΡΡΠ΅ΡΡΡ Π²ΡΠ΅ Π½ΡΠ°Π½ΡΡ. ΠΠ· ΠΊΠ°ΠΊΠΎΠ³ΠΎ ΠΌΠ°ΡΠ΅ΡΠΈΠ°Π»Π° Π²ΠΎΠ·Π²Π΅Π΄Π΅Π½Ρ ΡΡΠ΅Π½Ρ, ΡΠΈΠΏ ΠΈ ΡΠΎΡΡΠΎΡΠ½ΠΈΠ΅ ΡΠ°ΡΠ°Π΄Π°, ΠΌΠ΅ΡΡΠ½ΠΎΡΡΡ. ΠΠ΅ΠΌΠ°Π»ΠΎΠ²Π°ΠΆΠ½ΡΡ ΡΠΎΠ»Ρ ΠΈΠ³ΡΠ°ΡΡ ΡΡΠ»ΠΎΠ²ΠΈΡ ΠΏΠΎΠΊΡΠ°ΡΠΊΠΈ ΠΈ ΡΠ°Π·ΠΌΠ΅Ρ Π±ΡΠ΄ΠΆΠ΅ΡΠ°, Π²ΡΠ΄Π΅Π»Π΅Π½Π½ΠΎΠ³ΠΎ Π½Π° ΠΌΠ°ΡΠ΅ΡΠΈΠ°Π».
ΠΡΠ΅ΠΈΠΌΡΡΠ΅ΡΡΠ²Π° ΠΈ Π½Π΅Π΄ΠΎΡΡΠ°ΡΠΊΠΈ ΠΏΠΎΠΊΡΡΡΠΈΡ
Π£Π½ΠΈΠ²Π΅ΡΡΠ°Π»ΡΠ½ΡΠΌ ΠΏΠΎΠΊΡΡΡΠΈΠ΅ΠΌ ΡΠ²Π»ΡΠ΅ΡΡΡ ΡΠΈΠ»ΠΈΠΊΠΎΠ½ΠΎΠ²Π°Ρ ΠΊΡΠ°ΡΠΊΠ° Π΄Π»Ρ ΡΡΠ΅Π½. ΠΡΠΎ ΡΠΎΡΠ΅ΡΠ°Π½ΠΈΠ΅ Π²ΡΠ΅Ρ ΠΏΡΠ΅ΠΈΠΌΡΡΠ΅ΡΡΠ² ΠΊΠΎΠ½ΠΊΡΡΠ΅Π½ΡΠ½ΡΡ ΠΌΠ°ΡΠ΅ΡΠΈΠ°Π»ΠΎΠ², ΡΠΈΠ»ΠΈΠΊΠ°ΡΠ½ΡΡ ΠΈ Π°ΠΊΡΠΈΠ»ΠΎΠ²ΡΡ ΠΊΡΠ°ΡΠΎΠΊ. ΠΠΎ, ΠΊ ΡΠΎΠΆΠ°Π»Π΅Π½ΠΈΡ, ΡΠ°ΠΊΠΎΠΉ ΡΠΎΡΡΠ°Π² ΠΈΠΌΠ΅Π΅Ρ ΠΈ Π½Π΅Π΄ΠΎΡΡΠ°ΡΠΊΠΈ.
ΠΡ ΡΠΈΠ»ΠΈΠΊΠ°ΡΠ½ΡΡ ΡΠΎΡΡΠ°Π²ΠΎΠ² ΡΠΈΠ»ΠΈΠΊΠΎΠ½ΠΎΠ²ΠΎΠ΅ ΠΏΠΎΠΊΡΡΡΠΈΠ΅ Π²Π·ΡΠ»ΠΎ ΡΠ°ΠΊΠΎΠ΅ ΡΠ²ΠΎΠΉΡΡΠ²ΠΎ, ΠΊΠ°ΠΊ Π²ΡΡΠΎΠΊΠ°Ρ ΠΏΠ°ΡΠΎΠΏΡΠΎΠ½ΠΈΡΠ°Π΅ΠΌΠΎΡΡΡ. ΠΠ½Π° ΠΏΠΎΠ΄ΠΎΠΉΠ΄ΡΡ Π΄Π»Ρ ΡΡΡΠΎΠ΅Π½ΠΈΠΉ Ρ ΠΏΠ»ΠΎΡ ΠΎΠΉ Π³ΠΈΠ΄ΡΠΎΠΈΠ·ΠΎΠ»ΡΡΠΈΠ΅ΠΉ ΡΡΠ½Π΄Π°ΠΌΠ΅Π½ΡΠ°. ΠΠΎΠ²Π΅ΡΡ Π½ΠΎΡΡΡ, ΠΏΠΎΠΊΡΡΡΠ°Ρ ΡΠ°ΠΊΠΎΠΉ ΠΊΡΠ°ΡΠΊΠΎΠΉ, Π½Π΅ ΠΏΠΎΠ΄Π²Π΅ΡΠΆΠ΅Π½Π° ΠΏΠΎΡΠ²Π»Π΅Π½ΠΈΡ ΠΏΠ»Π΅ΡΠ΅Π½ΠΈ ΠΈ Π΄ΡΡΠ³ΠΈΡ Π³ΡΠΈΠ±ΠΊΠΎΠ².
Π£ ΡΠΈΠ»ΠΈΠΊΠΎΠ½ΠΎΠ²ΠΎΠ³ΠΎ Π»Π°ΠΊΠΎΠΊΡΠ°ΡΠΎΡΠ½ΠΎΠ³ΠΎ ΠΌΠ°ΡΠ΅ΡΠΈΠ°Π»Π° Π² ΠΊΠ°ΡΠ΅ΡΡΠ²Π΅ ΡΠ²ΡΠ·ΡΡΡΠ΅Π³ΠΎ Π²Π΅ΡΠ΅ΡΡΠ²Π° Π²ΡΡΡΡΠΏΠ°ΡΡ ΡΠΌΠΎΠ»Ρ. ΠΠΎΡΠ»Π΅ Π²ΡΡΡΡ Π°Π½ΠΈΡ ΠΏΠΎΠΊΡΡΡΠΈΠ΅ ΡΠΌΠΎΡΡΠΈΡΡΡ ΡΠ°ΠΊ, ΠΊΠ°ΠΊ Π±ΡΠ΄ΡΠΎ ΡΡΠΎ Π½Π°ΡΡΡΠ°Π»ΡΠ½ΡΠΉ ΠΌΠ°ΡΠ΅ΡΠΈΠ°Π». ΠΠΎΠ²Π΅ΡΡ Π½ΠΎΡΡΡ ΡΡΠ°Π½ΠΎΠ²ΠΈΡΡΡ ΠΎΠ΄Π½ΠΎΡΠΎΠ΄Π½ΠΎΠΉ, Π² ΡΠΎ ΠΆΠ΅ Π²ΡΠ΅ΠΌΡ ΡΠΎΡ ΡΠ°Π½ΡΠ΅ΡΡΡ Π΅ΡΡΠ΅ΡΡΠ²Π΅Π½Π½Π°Ρ ΡΠ΅ΠΊΡΡΡΡΠ° ΡΡΠ΅Π½. ΠΠ»Π°Π³ΠΎΠ΄Π°ΡΡ ΠΎΠ±ΡΠ°Π·ΠΎΠ²Π°Π½ΠΈΡ Π²ΠΎΠ΄ΠΎΠ½Π΅ΠΏΡΠΎΠ½ΠΈΡΠ°Π΅ΠΌΠΎΠΉ ΠΏΠ»ΡΠ½ΠΊΠΈ, ΡΠΎΡΡΠ°Π² Π·Π°ΡΠΈΡΠ°Π΅Ρ ΡΠ°ΡΠ°Π΄ ΠΎΡ ΠΊΠΎΠ½Π΄Π΅Π½ΡΠ°ΡΠ°.
Π‘ΠΈΠ»ΠΈΠΊΠΎΠ½ΠΎΠ²ΡΠ΅ ΠΏΠΎΠΊΡΡΡΠΈΡ ΠΏΠΎΠ»ΡΡΠΈΠ»ΠΈ Π²ΡΡΠΎΠΊΠΎΠ΅ ΠΏΡΠΈΠ·Π½Π°Π½ΠΈΠ΅ ΡΠΏΠ΅ΡΠΈΠ°Π»ΠΈΡΡΠΎΠ² ΠΈΠ·-Π·Π° ΡΠ°Π·Π½ΠΎΠΎΠ±ΡΠ°Π·Π½ΡΡ Π΄Π΅ΠΊΠΎΡΠ°ΡΠΈΠ²Π½ΡΡ Π²ΠΎΠ·ΠΌΠΎΠΆΠ½ΠΎΡΡΠ΅ΠΉ ΠΈ ΠΎΡΠ»ΠΈΡΠ½ΡΡ ΡΠΊΡΠΏΠ»ΡΠ°ΡΠ°ΡΠΈΠΎΠ½Π½ΡΡ Ρ Π°ΡΠ°ΠΊΡΠ΅ΡΠΈΡΡΠΈΠΊ. Π ΠΎΡΠ»ΠΈΡΠΈΠ΅ ΠΎΡ ΡΠΈΠ»ΠΈΠΊΠ°ΡΠ½ΡΡ ΠΈ Π°ΠΊΡΠΈΠ»ΠΎΠ²ΡΡ Π°Π½Π°Π»ΠΎΠ³ΠΎΠ², ΠΎΠ½ΠΈ Π½Π΅ ΠΎΠ±ΡΠ°Π·ΡΡΡ ΠΌΠΈΠΊΡΠΎΡΡΠ΅ΡΠΈΠ½ Π½Π° ΠΏΠΎΠ²Π΅ΡΡ Π½ΠΎΡΡΠΈ. ΠΠ΅Π΄Ρ ΠΏΡΠΈ Π²ΡΡΡΡ Π°Π½ΠΈΠΈ ΠΈΠΌΠ΅ΡΡ Π½Π΅Π±ΠΎΠ»ΡΡΠΎΠ΅ ΠΏΠΎΠ²Π΅ΡΡ Π½ΠΎΡΡΠ½ΠΎΠ΅ Π½Π°ΠΏΡΡΠΆΠ΅Π½ΠΈΠ΅. ΠΠΎΡΡΠΎΠΌΡ ΡΠΈΠ»ΠΈΠΊΠΎΠ½ΠΎΠ²ΡΡ ΡΠ°ΡΠ°Π΄Π½ΡΡ ΠΊΡΠ°ΡΠΊΡ ΠΌΠΎΠΆΠ½ΠΎ ΠΏΡΠΈΠΌΠ΅Π½ΡΡΡ Π΄Π°ΠΆΠ΅ Π½Π° ΠΏΡΠΎΠ±Π»Π΅ΠΌΠ½ΡΡ ΡΡΠ΅Π½Π°Ρ .
Π’Π°ΠΊΠΆΠ΅ ΡΠ°ΠΊΠΈΠ΅ ΡΠΎΡΡΠ°Π²Ρ ΠΎΡΠ»ΠΈΡΠ°ΡΡΡΡ Π²ΡΡΠΎΠΊΠΎΠΉ Π°Π΄Π³Π΅Π·ΠΈΠ΅ΠΉ. ΠΠΎΠ»ΡΡΠΈΠ½ΡΡΠ²ΠΎ ΡΠΈΠ»ΠΈΠΊΠΎΠ½ΠΎΠ²ΡΡ ΡΠ°Π·Π½ΠΎΠ²ΠΈΠ΄Π½ΠΎΡΡΠ΅ΠΉ ΠΌΠΎΠΆΠ½ΠΎ Π½Π°Π½ΠΎΡΠΈΡΡ Π΄Π°ΠΆΠ΅ ΠΏΡΠΈ ΡΠ΅ΠΌΠΏΠ΅ΡΠ°ΡΡΡΠ΅ +2 Β°C. ΠΡΠ° Ρ Π°ΡΠ°ΠΊΡΠ΅ΡΠΈΡΡΠΈΠΊΠ° ΠΏΠΎΠ·Π²ΠΎΠ»ΠΈΡ Π·Π½Π°ΡΠΈΡΠ΅Π»ΡΠ½ΠΎ ΡΡΠΊΠΎΡΠΈΡΡ ΠΎΡΠ΄Π΅Π»ΠΎΡΠ½ΡΠ΅ ΡΠ°Π±ΠΎΡΡ.
ΠΠ΅ΡΠΌΠΎΡΡΡ Π½Π° Π²ΡΠ΅ ΠΏΡΠ΅ΠΈΠΌΡΡΠ΅ΡΡΠ²Π°, Ρ ΡΡΠΎΠ³ΠΎ ΠΌΠ°ΡΠ΅ΡΠΈΠ°Π»Π° Π΅ΡΡΡ ΠΈ Π½Π΅Π΄ΠΎΡΡΠ°ΡΠΊΠΈ. ΠΠ½ΠΈ ΡΠΊΠ»ΠΎΠ½Π½Ρ ΠΊ Π²ΡΠ³ΠΎΡΠ°Π½ΠΈΡ, ΠΏΡΡΡΡ ΠΈ Π½Π΅ ΡΠ°ΠΊ Π±ΡΡΡΡΠΎ, ΠΏΠΎ ΡΡΠ°Π²Π½Π΅Π½ΠΈΡ Ρ ΡΠΈΠ»ΠΈΠΊΠ°ΡΠ½ΡΠΌΠΈ ΡΠ°Π·Π½ΠΎΠ²ΠΈΠ΄Π½ΠΎΡΡΡΠΌΠΈ. Π‘ΠΈΠ»ΠΈΠΊΠΎΠ½ Π»Π΅Π³ΠΊΠΎ ΠΏΠΎΠ²ΡΠ΅Π΄ΠΈΡΡ. ΠΠ½ Π½Π΅ΡΡΡΠΎΠΉΡΠΈΠ² ΠΊ ΠΌΠ΅Ρ Π°Π½ΠΈΡΠ΅ΡΠΊΠΈΠΌ ΠΏΠΎΠ²ΡΠ΅ΠΆΠ΄Π΅Π½ΠΈΡΠΌ ΠΈ ΡΠ°ΡΠ°ΠΏΠΈΠ½Π°ΠΌ. ΠΠ»Ρ ΠΏΡΠΎΠ΄Π»Π΅Π½ΠΈΡ ΡΡΠΎΠΊΠ° ΡΠ»ΡΠΆΠ±Ρ ΠΏΠΎΠΊΡΡΡΠΈΡ ΡΠ΅ΠΊΠΎΠΌΠ΅Π½Π΄ΡΠ΅ΡΡΡ ΠΊΠ°ΠΊ ΠΌΠΎΠΆΠ½ΠΎ ΡΠ΅ΠΆΠ΅ ΠΏΠΎΠ΄Π²Π΅ΡΠ³Π°ΡΡ ΠΏΠΎΠ²Π΅ΡΡ Π½ΠΎΡΡΡ ΡΠΈΡΡΠΊΠ΅. ΠΡΠΎΠΌΠ΅ ΡΠΎΠ³ΠΎ, ΠΌΠ°ΡΠ΅ΡΠΈΠ°Π» ΠΌΠ΅Π½Π΅Π΅ ΡΠ»Π°ΡΡΠΈΡΠ΅Π½ ΠΏΠΎ ΡΡΠ°Π²Π½Π΅Π½ΠΈΡ Ρ Π°ΠΊΡΠΈΠ»ΠΎΠ²ΡΠΌ ΠΏΠΎΠΊΡΡΡΠΈΠ΅ΠΌ.
Π¦Π²Π΅ΡΠΎΠ²Π°Ρ ΠΏΠ°Π»ΠΈΡΡΠ°
ΠΡΠΈ Π²ΡΠ±ΠΎΡΠ΅ Π»Π°ΠΊΠΎΠΊΡΠ°ΡΠΎΡΠ½ΡΡ
ΠΏΠΎΠΊΡΡΡΠΈΠΉ ΠΌΠ½ΠΎΠ³ΠΈΠ΅ Π·Π°Π΄Π°ΡΡΡΡ Π²ΠΎΠΏΡΠΎΡΠΎΠΌ, Π·Π°Π²ΠΈΡΠΈΡ Π»ΠΈ Ρ
ΠΈΠΌΠΈΡΠ΅ΡΠΊΠΈΠΉ ΡΠΎΡΡΠ°Π² ΠΏΠΎΠΊΡΡΡΠΈΡ ΠΎΡ ΡΠ²Π΅ΡΠ°.
ΠΠ·Π²Π΅ΡΡΠΊΠΎΠ²ΡΠ΅ Π»Π°ΠΊΠΎΠΊΡΠ°ΡΠΎΡΠ½ΡΠ΅ ΡΠ°Π·Π½ΠΎΠ²ΠΈΠ΄Π½ΠΎΡΡΠΈ ΠΎΡΠ»ΠΈΡΠ°ΡΡΡΡ ΡΠΊΡΠ΄Π½ΠΎΠΉ ΡΠ²Π΅ΡΠΎΠ²ΠΎΠΉ ΠΏΠ°Π»ΠΈΡΡΠΎΠΉ.
Π§Π΅Π³ΠΎ Π½Π΅ ΡΠΊΠ°ΠΆΠ΅ΡΡ ΠΎ ΡΠ²Π΅ΡΠΎΠ²ΠΎΠΌ ΡΠ΅ΡΠ΅Π½ΠΈΠΈ ΡΠΈΠ»ΠΈΠΊΠΎΠ½ΠΎΠ²ΡΡ ΠΊΡΠ°ΡΠΎΠΊ Π΄Π»Ρ ΡΠ°ΡΠ°Π΄ΠΎΠ². ΠΠ½ΠΈ ΠΈΠΌΠ΅ΡΡ ΡΠΈΡΠΎΠΊΠΈΠΉ Π²ΡΠ±ΠΎΡ ΡΠ²Π΅ΡΠΎΠ². ΠΠ°ΡΡΡΠ΅Π½Π½ΠΎΡΡΡ ΡΠ²Π΅ΡΠ° ΡΠΎΡ ΡΠ°Π½ΠΈΡΡΡ Π² ΡΠ΅ΡΠ΅Π½ΠΈΠ΅ Π΄Π»ΠΈΡΠ΅Π»ΡΠ½ΠΎΠ³ΠΎ Π²ΡΠ΅ΠΌΠ΅Π½ΠΈ. ΠΠΎΠ½Π΅ΡΠ½ΠΎ ΠΆΠ΅, ΡΠΈΠ»ΠΈΠΊΠΎΠ½ΠΎΠ²ΠΎΠ΅ ΠΏΠΎΠΊΡΡΡΠΈΠ΅ Π½Π΅ Π»ΠΈΡΠ΅Π½ΠΎ Π²ΡΡΠ²Π΅ΡΠ°Π½ΠΈΡ. ΠΠΎ ΡΡΠΎΡ ΠΏΡΠΎΡΠ΅ΡΡ Π½Π΅Π±ΡΡΡΡΡΠΉ. ΠΠ½ΡΠ΅Π½ΡΠΈΠ²Π½ΠΎΡΡΡ ΡΠ²Π΅ΡΠ° ΡΠΈΠ»ΠΈΠΊΠΎΠ½ΠΎΠ²ΡΡ ΡΠ°Π·Π½ΠΎΠ²ΠΈΠ΄Π½ΠΎΡΡΠ΅ΠΉ, ΠΊ ΡΠΎΠΆΠ°Π»Π΅Π½ΠΈΡ, ΡΡΡΡΠΏΠ°Π΅Ρ, Π°ΠΊΡΠΈΠ»ΠΎΠ²ΡΠΌ ΠΏΠΎΠΊΡΡΡΠΈΡΠΌ.
ΠΠΈΡΠΏΠ»Π΅ΠΉ ΠΊΠΎΠΌΠΏΡΡΡΠ΅ΡΠ° ΠΈΠ»ΠΈ ΠΏΠ»Π°Π½ΡΠ΅ΡΠ° Π½Π΅ ΠΌΠΎΠΆΠ΅Ρ ΡΡΡΠΊΠΎ ΠΏΠ΅ΡΠ΅Π΄Π°ΡΡ ΡΠ²Π΅Ρ, ΠΊΠΎΡΠΎΡΡΠΉ Π΅ΡΡΡ Π² Π΄Π΅ΠΉΡΡΠ²ΠΈΡΠ΅Π»ΡΠ½ΠΎΡΡΠΈ. ΠΠ΅Π΄Ρ ΡΠ²Π΅ΡΠΎΠΏΠ΅ΡΠ΅Π΄Π°ΡΠ° Ρ ΠΊΠ°ΠΆΠ΄ΠΎΠ³ΠΎ ΡΡΡΡΠΎΠΉΡΡΠ²Π° ΡΠ°Π·Π½Π°Ρ. Π¦Π²Π΅Ρ ΠΌΠ°ΡΠ΅ΡΠΈΠ°Π»Π° Π½Π° ΠΎΠ±ΡΠ°Π·ΡΠ΅ Π² ΠΌΠ°Π³Π°Π·ΠΈΠ½Π΅ ΠΈ ΡΠ΅Π·ΡΠ»ΡΡΠ°Ρ Π½Π° ΡΡΠ΅Π½Π΅ ΡΠ°ΠΊΠΆΠ΅ ΠΌΠΎΠΆΠ΅Ρ ΠΎΡΠ»ΠΈΡΠ°ΡΡΡΡ. Π’Π°ΠΊΠΆΠ΅ Π½Π°ΡΡΡΠ΅Π½Π½ΡΠ΅ ΠΈ ΡΡΠΌΠ½ΡΠ΅ ΡΠ²Π΅ΡΠ° Π½Π° ΡΠ°ΠΌΠΎΠΌ ΡΠ°ΡΠ°Π΄Π΅ Π±ΡΠ΄ΡΡ Π³Π»ΡΠ±ΠΆΠ΅ ΠΈ ΠΈΠ½ΡΠ΅Π½ΡΠΈΠ²Π½Π΅Π΅, ΡΠ΅ΠΌ Π½Π° ΠΎΠ±ΡΠ°Π·ΡΠ΅.
ΠΠΎΡΡΠΎΠΌΡ ΠΏΡΠΈ ΠΏΠΎΠΊΡΠΏΠΊΠ΅ ΠΏΠΎΠΊΡΡΡΠΈΡ Π΅ΡΡΡ Π΄Π²Π° Π²Π°ΡΠΈΠ°Π½ΡΠ°:
- ΠΡΠ±ΡΠ°ΡΡ Π½Π° Π½Π΅ΡΠΊΠΎΠ»ΡΠΊΠΎ ΡΠΎΠ½ΠΎΠ² ΡΠ²Π΅ΡΠ»Π΅Π΅, ΡΠ΅ΠΌ ΠΏΠΎΠ½ΡΠ°Π²ΠΈΠ²ΡΠ΅ΠΉΡΡ ΠΎΠ±ΡΠ°Π·Π΅Ρ.
- ΠΡΠΏΠΈΡΡ Π»Π°ΠΊΠΎΠΊΡΠ°ΡΠΎΡΠ½ΡΠΉ ΠΌΠ°ΡΠ΅ΡΠΈΠ°Π» Π΄Π»Ρ ΡΡΠ΅Π½ Π΄Π²ΡΡ Π±Π»ΠΈΠ·ΠΊΠΈΡ ΠΎΡΡΠ΅Π½ΠΊΠΎΠ². ΠΠΎ ΠΎΠ΄Π½ΠΎΠΉ Π±Π°Π½ΠΊΠ΅ ΠΊΠ°ΠΆΠ΄ΠΎΠ³ΠΎ ΡΠ²Π΅ΡΠ°. Π ΡΠ»ΡΡΠ°Π΅ Π΅ΡΠ»ΠΈ ΠΎΠ΄ΠΈΠ½ ΡΠ²Π΅Ρ Π½Π΅ ΠΏΠΎΠ΄ΠΎΠΉΠ΄ΡΡ, Π΅ΡΡΡ Π²ΠΎΠ·ΠΌΠΎΠΆΠ½ΠΎΡΡΡ ΠΏΠΎΠΏΡΠΎΠ±ΠΎΠ²Π°ΡΡ Π΄ΡΡΠ³ΠΎΠΉ. ΠΡΠΈΡΡΠΌ ΠΏΡΠΈ ΠΏΠΎΠΊΡΡΡΠΈΠΈ Π΄ΡΡΠ³ΠΈΠΌ ΡΠ²Π΅ΡΠΎΠΌ, ΠΏΠ΅ΡΠ²ΡΠΉ ΡΠ»ΠΎΠΉ ΠΊΡΠ°ΡΠΊΠΈ ΠΏΠΎΠ»Π½ΠΎΡΡΡΡ ΠΏΠ΅ΡΠ΅ΠΊΡΠΎΠ΅ΡΡΡ Π΄ΡΡΠ³ΠΈΠΌ ΡΠ²Π΅ΡΠΎΠΌ.
Π£ΡΡΠΎΠΉΡΠΈΠ²ΠΎΡΡΡ ΠΊ Π·Π°Π³ΡΡΠ·Π½Π΅Π½ΠΈΡΠΌ

Π₯ΠΈΠΌΠΈΡΠ΅ΡΠΊΠΈΠΉ ΡΠΎΡΡΠ°Π² ΠΌΠ°ΡΠ΅ΡΠΈΠ°Π»Π° ΡΠΎΡΠΌΠΈΡΡΠ΅Ρ Π·Π°ΡΠΈΡΠ½ΡΡ ΠΏΠ»ΡΠ½ΠΊΡ ΠΎΡ Π²Π»Π°Π³ΠΈ. ΠΠ½Π° Π½Π΅ Π΄Π°ΡΡ Π²Π»Π°Π³Π΅ ΠΏΡΠΎΠ½ΠΈΠΊΠ½ΡΡΡ ΠΏΠΎΠ΄ ΠΏΠΎΠΊΡΡΡΠΈΠ΅ ΠΈ ΠΊΠ°ΠΏΠ»ΠΈ, ΡΡΠ΅ΠΊΠ°Ρ ΡΠΎ ΡΡΠ΅Π½, ΠΎΡΠΈΡΠ°ΡΡ ΠΏΠΎΠ²Π΅ΡΡ Π½ΠΎΡΡΡ ΠΎΡ ΠΏΡΠ»ΠΈ ΠΈ Π³ΡΡΠ·ΠΈ.
Π‘ΠΏΠΎΡΠΎΠ±Π½ΠΎΡΡΡ ΠΏΠΎΠΊΡΡΡΠΈΡ ΠΊ ΡΠ°ΠΌΠΎΠΎΡΠΈΡΠ΅Π½ΠΈΡ ΠΏΠΎΡΠ²Π»ΡΠ΅ΡΡΡ Π½Π΅ ΡΡΠ°Π·Ρ. Π§ΡΠΎΠ±Ρ ΠΏΠΎΠ²Π΅ΡΡ Π½ΠΎΡΡΡ ΡΡΠ°Π»Π° Π΄ΠΎΡΡΠ°ΡΠΎΡΠ½ΠΎ ΠΏΡΠΎΡΠ½ΠΎΠΉ ΠΈ Π²ΠΎΠ΄ΠΎΠ½Π΅ΠΏΡΠΎΠ½ΠΈΡΠ°Π΅ΠΌΠΎΠΉ, Π΄ΠΎΠ»ΠΆΠ½ΠΎ ΠΏΡΠΎΠΉΡΠΈ Π½Π΅ ΠΌΠ΅Π½Π΅Π΅ ΠΌΠ΅ΡΡΡΠ°. Π’Π°ΠΊΠΎΠ΅ ΡΠ²ΠΎΠΉΡΡΠ²ΠΎ ΠΏΠΎΡΠ²Π»ΡΠ΅ΡΡΡ ΠΈΠ·-Π·Π° ΡΠΌΠΎΠ», Π²Ρ ΠΎΠ΄ΡΡΠΈΡ Π² ΡΠΎΡΡΠ°Π² ΠΏΠΎΠΊΡΡΡΠΈΡ. Π§Π΅ΠΌ ΠΈΡ Π±ΠΎΠ»ΡΡΠ΅, ΡΠ΅ΠΌ ΡΡΠ° Ρ Π°ΡΠ°ΠΊΡΠ΅ΡΠΈΡΡΠΈΠΊΠ° ΡΠΈΠ»ΡΠ½Π΅Π΅. Π‘ΠΈΠ»ΠΈΠΊΠΎΠ½ΠΎΠ²ΡΠ΅ ΠΊΡΠ°ΡΠΊΠΈ ΡΠ²Π»ΡΡΡΡΡ Π½Π΅ΠΎΡΠΏΠΎΡΠΈΠΌΡΠΌ Π»ΠΈΠ΄Π΅ΡΠΎΠΌ ΡΡΠ΅Π΄ΠΈ Π°Π½Π°Π»ΠΎΠ³ΠΎΠ².
Π ΡΠΎΠΆΠ°Π»Π΅Π½ΠΈΡ, ΠΏΡΠΎΠΈΠ·Π²ΠΎΠ΄ΠΈΡΠ΅Π»ΠΈ Π½Π΅ ΡΠΊΠ°Π·ΡΠ²Π°ΡΡ ΠΊΠΎΠ»ΠΈΡΠ΅ΡΡΠ²ΠΎ ΡΠΌΠΎΠ» Π½Π° ΡΡΠΈΠΊΠ΅ΡΠΊΠ΅. ΠΠΎ ΠΌΠΎΠΆΠ½ΠΎ Π²ΡΠ±ΡΠ°ΡΡ Π»ΡΠ±ΠΎΠ΅ ΠΏΠΎΠΊΡΡΡΠΈΠ΅ Π΄Π»Ρ ΡΠ°ΡΠ°Π΄ΠΎΠ² Ρ ΡΠΈΠ»ΠΈΠΊΠΎΠ½ΠΎΠ²ΡΠΌ ΡΠΎΡΡΠ°Π²ΠΎΠΌ. ΠΠ½ΠΎ Π±ΡΠ΄Π΅Ρ ΠΈΠΌΠ΅ΡΡ ΡΠ°ΠΊΡΡ Ρ Π°ΡΠ°ΠΊΡΠ΅ΡΠΈΡΡΠΈΠΊΡ, ΠΊΠ°ΠΊ ΡΠ°ΠΌΠΎΠΎΡΠΈΡΠ΅Π½ΠΈΠ΅.
ΠΠ΅ Π²ΡΠ΅ΠΌ Π·Π°Π³ΡΡΠ·Π½Π΅Π½ΠΈΡΠΌ ΠΏΠΎΠ΄ ΡΠΈΠ»Ρ ΡΡΠ½ΠΊΡΠΈΠΈ ΡΠ°ΠΌΠΎΠΎΡΠΈΡΠ΅Π½ΠΈΡ. ΠΡΠ»ΠΈ Π΄ΠΎΠΆΠ΄Π΅Π²ΡΠ΅ ΠΊΠ°ΠΏΠ»ΠΈ ΠΌΠΎΠ³ΡΡ ΡΠΌΡΡΡ ΠΏΡΠ»Ρ, ΡΠΎ ΠΌΠ°ΡΠ»ΡΠ½ΠΎΠ΅ ΠΏΡΡΠ½ΠΎ ΠΏΡΠΈΠ΄ΡΡΡΡ ΠΎΡΠΌΡΠ²Π°ΡΡ ΡΠ°ΠΌΠΎΡΡΠΎΡΡΠ΅Π»ΡΠ½ΠΎ. ΠΡΠΈΡΡΠΌ ΡΠ΅ΠΊΠΎΠΌΠ΅Π½Π΄ΡΡΡ ΠΊΠ°ΠΊ ΠΌΠΎΠΆΠ½ΠΎ ΡΠ΅ΠΆΠ΅ ΠΏΡΠΎΠ²ΠΎΠ΄ΠΈΡΡ ΠΌΠ΅Ρ Π°Π½ΠΈΡΠ΅ΡΠΊΡΡ ΡΠΈΡΡΠΊΡ Π΄Π»Ρ ΠΏΡΠΎΠ΄Π»Π΅Π½ΠΈΡ ΠΆΠΈΠ·Π½ΠΈ ΠΏΠΎΠΊΡΡΡΠΈΡ.
Π£ΡΡΠΎΠΉΡΠΈΠ²ΠΎΡΡΡ ΠΊ Π²Π½Π΅ΡΠ½ΠΈΠΌ Π²ΠΎΠ·Π΄Π΅ΠΉΡΡΠ²ΠΈΡΠΌ
ΠΠ»Ρ ΠΊΠ°ΠΆΠ΄ΠΎΠ³ΠΎ ΠΌΠ°ΡΠ΅ΡΠΈΠ°Π»Π° ΡΡΡΠ΅ΡΡΠ²ΡΡΡ ΡΠ²ΠΎΠΈ ΡΡΠ»ΠΎΠ²ΠΈΡ ΠΈΡΠΏΠΎΠ»ΡΠ·ΠΎΠ²Π°Π½ΠΈΡ. Π‘ΠΈΠ»ΠΈΠΊΠΎΠ½ΠΎΠ²Π°Ρ ΠΊΡΠ°ΡΠΊΠ° Π΄Π»Ρ ΡΠ°ΡΠ°Π΄Π° ΠΎΡΠ»ΠΈΡΠ°Π΅ΡΡΡ ΠΎΡ Π΄ΡΡΠ³ΠΈΡ
Π°Π½Π°Π»ΠΎΠ³ΠΈΡΠ½ΡΡ
ΠΏΡΠΎΠ΄ΡΠΊΡΠΎΠ² ΡΡΡΠΎΠΉΡΠΈΠ²ΠΎΡΡΡΡ ΠΊ Π²ΠΎΠ·Π΄Π΅ΠΉΡΡΠ²ΠΈΡ ΠΈΠ·Π²Π½Π΅.
ΠΡΠΎΠ΄ΡΠΊΡ Ρ ΡΠ°ΠΊΠΈΠΌ ΡΠΎΡΡΠ°Π²ΠΎΠΌ ΡΠ½ΠΈΠ²Π΅ΡΡΠ°Π»Π΅Π½, Π΅Π³ΠΎ ΠΌΠΎΠΆΠ½ΠΎ ΠΈΡΠΏΠΎΠ»ΡΠ·ΠΎΠ²Π°ΡΡ Π΄Π»Ρ Π·Π΄Π°Π½ΠΈΠΉ Π² ΠΏΡΠΎΠΌΡΡΠ»Π΅Π½Π½ΡΡ Π·ΠΎΠ½Π°Ρ , Π³Π΄Π΅ Π² Π²ΠΎΠ·Π΄ΡΡ Π΅ ΡΠΎΠ΄Π΅ΡΠΆΠ°ΡΡΡ Π²ΡΠ΅Π΄Π½ΡΠ΅ Π²ΡΠ±ΡΠΎΡΡ Ρ ΠΏΡΠ΅Π΄ΠΏΡΠΈΡΡΠΈΠΉ ΠΈ ΠΊΠΈΡΠ»ΠΎΡΠ½ΡΠ΅ ΠΎΡΡΠ°ΡΠΊΠΈ. ΠΡΠ΄Π΅ΡΠΆΠ°ΡΡ ΡΠ°ΠΊΡΡ Π°ΡΠΌΠΎΡΡΠ΅ΡΡ ΡΠΌΠΎΠΆΠ΅Ρ Π»ΡΠ±ΠΎΠΉ ΡΠΎΡΡΠ°Π² Ρ ΡΠΈΠ»ΠΈΠΊΠΎΠ½ΠΎΠ²ΡΠΌΠΈ ΡΠΌΠΎΠ»Π°ΠΌΠΈ. ΠΠΎ ΡΠΈΠ»ΠΈΠΊΠΎΠ½ΠΎΠ²ΡΠ΅ ΠΊΡΠ°ΡΠΊΠΈ ΠΈΠΌΠ΅ΡΡ Π±ΠΎΠ»ΡΡΡΡ ΡΠΎΠΏΡΠΎΡΠΈΠ²Π»ΡΠ΅ΠΌΠΎΡΡΡ ΠΊ ΡΠ°ΠΊΠΈΠΌ Π²ΠΎΠ·Π΄Π΅ΠΉΡΡΠ²ΠΈΡΠΌ.
ΠΡΠΈ Π²ΡΠ±ΠΎΡΠ΅ Π»Π°ΠΊΠΎΠΊΡΠ°ΡΠΎΡΠ½ΠΎΠ³ΠΎ ΠΌΠ°ΡΠ΅ΡΠΈΠ°Π»Π° ΡΡΠΎΠΈΡ ΡΡΠΈΡΡΠ²Π°ΡΡ, Π½Π° ΠΊΠ°ΠΊΠΎΠ΅ ΠΎΡΠ½ΠΎΠ²Π°Π½ΠΈΠ΅ ΠΎΠ½ Π±ΡΠ΄Π΅Ρ Π½Π°Π½ΠΎΡΠΈΡΡΡΡ. Π‘ΠΈΠ»ΠΈΠΊΠΎΠ½ΠΎΠ²ΡΠ΅ ΠΏΠΎΠΊΡΡΡΠΈΡ ΠΏΡΠ°ΠΊΡΠΈΡΠ΅ΡΠΊΠΈ ΡΠ½ΠΈΠ²Π΅ΡΡΠ°Π»ΡΠ½Ρ. ΠΠ½ΠΈ ΠΏΠΎΠ΄ΠΎΠΉΠ΄ΡΡ, ΠΊΠ°ΠΊ Π΄Π»Ρ Π±Π΅ΡΠΎΠ½Π½ΡΡ ΠΎΡΠ½ΠΎΠ²Π°Π½ΠΈΠΉ, ΡΠ°ΠΊ ΠΈ Π΄Π»Ρ Π»ΡΠ±ΠΎΠ³ΠΎ ΠΎΡΠ³Π°Π½ΠΈΡΠ΅ΡΠΊΠΎΠ³ΠΎ ΠΎΡΠ½ΠΎΠ²Π°Π½ΠΈΡ.
ΠΠ΅ ΡΠ΅ΠΊΠΎΠΌΠ΅Π½Π΄ΡΠ΅ΡΡΡ ΠΈΡΠΏΠΎΠ»ΡΠ·ΠΎΠ²Π°ΡΡ ΡΠ°ΠΊΠΎΠ΅ ΠΏΠΎΠΊΡΡΡΠΈΠ΅ Π΄Π»Ρ Π½Π°Π½Π΅ΡΠ΅Π½ΠΈΡ Π½Π° ΡΠΈΠ»ΠΈΠΊΠ°ΡΠ½ΡΠ΅ ΠΊΠΈΡΠΏΠΈΡΠΈ ΠΈΠ»ΠΈ ΡΠΈΠ»ΠΈΠΊΠ°ΡΠ½ΡΡ ΡΡΡΠΊΠ°ΡΡΡΠΊΡ. ΠΠ»Ρ ΡΠ°ΠΊΠΈΡ ΠΎΡΠ½ΠΎΠ²Π°Π½ΠΈΠΉ Π½ΠΈΠΊΠ°ΠΊ Π»ΡΡΡΠ΅ ΠΏΠΎΠ΄ΠΎΠΉΠ΄ΡΡ ΡΠΈΠ»ΠΈΠΊΠ°ΡΠ½ΡΠ΅ ΠΈΠ»ΠΈ ΠΏΠΎΠ»ΠΈΠΊΡΠ΅ΠΌΠ½Π΅Π²ΡΠ΅ ΡΠ°ΡΠ°Π΄Π½ΡΠ΅ ΠΊΡΠ°ΡΠΊΠΈ.
Π£Ρ ΠΎΠ΄ Π·Π° ΡΠΈΠ»ΠΈΠΊΠΎΠ½ΠΎΠ²ΡΠΌ ΠΏΠΎΠΊΡΡΡΠΈΠ΅ΠΌ
ΠΡΠΎΠ±ΠΎΠ³ΠΎ ΡΡ ΠΎΠ΄Π° ΡΠΈΠ»ΠΈΠΊΠΎΠ½ΠΎΠ²ΠΎΠ΅ ΠΏΠΎΠΊΡΡΡΠΈΠ΅ Π½Π΅ ΡΡΠ΅Π±ΡΠ΅Ρ. ΠΠΎΠ΄ΠΎΠ½Π΅ΠΏΡΠΎΠ½ΠΈΡΠ°Π΅ΠΌΠΎΡΡΡ ΠΏΠΎΠΌΠΎΠ³Π°Π΅Ρ Π΄ΠΎΠΆΠ΄Ρ ΠΎΡΠΈΡΡΠΈΡΡ Π΄ΠΎΠΌ ΠΎΡ ΠΏΡΠ»ΠΈ ΠΈ Π²ΡΡ Π»ΠΎΠΏΠΎΠ² ΠΌΠ°ΡΠΈΠ½. Π Π΅ΡΠ»ΠΈ Π΄ΠΎΠΆΠ΄Π΅ΠΉ Π΄Π°Π²Π½ΠΎ Π½Π΅ Π±ΡΠ»ΠΎ, ΡΠΌΡΡΡ Π·Π°Π³ΡΡΠ·Π½Π΅Π½ΠΈΡ ΠΌΠΎΠΆΠ½ΠΎ Ρ ΠΏΠΎΠΌΠΎΡΡΡ ΡΠ»Π°Π½Π³Π° Ρ Π²ΠΎΠ΄ΠΎΠΉ.
planken.guru
Ρ Π°ΡΠ°ΠΊΡΠ΅ΡΠΈΡΡΠΈΠΊΠ°, ΠΊΠ°ΠΊΠ°Ρ Π»ΡΡΡΠ΅, ΡΠ΅Ρ Π½ΠΎΠ»ΠΎΠ³ΠΈΡ Π½Π°Π½Π΅ΡΠ΅Π½ΠΈΡ, ΠΎΡΠ·ΡΠ²Ρ ΠΏΠΎΡΡΠ΅Π±ΠΈΡΠ΅Π»Π΅ΠΉ, ΡΠΎΡΠΎ, Π²ΠΈΠ΄Π΅ΠΎ

Π‘ΠΈΠ»ΠΈΠΊΠ°ΡΠ½Π°Ρ ΠΈ ΡΠΈΠ»ΠΈΠΊΠΎΠ½ΠΎΠ²Π°Ρ ΠΊΡΠ°ΡΠΊΠΈ ΡΠ²Π»ΡΡΡΡΡ Π½Π°ΠΈΠ±ΠΎΠ»Π΅Π΅ ΡΠΎΠ²ΡΠ΅ΠΌΠ΅Π½Π½ΡΠΌΠΈ ΡΠ°ΡΠ°Π΄Π½ΡΠΌΠΈ ΠΎΡΠ΄Π΅Π»ΠΎΡΠ½ΡΠΌΠΈ ΠΌΠ°ΡΠ΅ΡΠΈΠ°Π»Π°ΠΌΠΈΠ‘ΠΈΠ»ΠΈΠΊΠ°ΡΠ½Π°Ρ ΠΈ ΡΠΈΠ»ΠΈΠΊΠΎΠ½ΠΎΠ²Π°Ρ ΠΊΡΠ°ΡΠΊΠΈ ΡΠ²Π»ΡΡΡΡΡ Π½Π°ΠΈΠ±ΠΎΠ»Π΅Π΅ ΡΠΎΠ²ΡΠ΅ΠΌΠ΅Π½Π½ΡΠΌΠΈ ΠΈ ΠΊΠ°ΡΠ΅ΡΡΠ²Π΅Π½Π½ΡΠΌΠΈ ΡΠ°ΡΠ°Π΄Π½ΡΠΌΠΈ ΠΎΡΠ΄Π΅Π»ΠΎΡΠ½ΡΠΌΠΈ ΠΌΠ°ΡΠ΅ΡΠΈΠ°Π»Π°ΠΌΠΈ, ΠΊΠΎΡΠΎΡΡΠ΅ ΠΎΠΏΡΠΈΠΌΠ°Π»ΡΠ½ΠΎ ΡΠΎΡΠ΅ΡΠ°ΡΡ Π² ΡΠ΅Π±Π΅ Π»ΡΡΡΠΈΠ΅ ΠΊΠ°ΡΠ΅ΡΡΠ²Π΅Π½Π½ΡΠ΅ Ρ Π°ΡΠ°ΠΊΡΠ΅ΡΠΈΡΡΠΈΠΊΠΈ, Π²ΠΊΠ»ΡΡΠ°Ρ Π΄ΠΎΠ»Π³ΠΎΠ²Π΅ΡΠ½ΠΎΡΡΡ ΠΏΠΎΠΊΡΡΡΠΈΡ. ΠΡΠΎ Π½Π°ΠΈΠ±ΠΎΠ»Π΅Π΅ ΠΏΠΎΠ΄Ρ ΠΎΠ΄ΡΡΠΈΠ΅ Π΄Π»Ρ Π½Π°ΡΡΠΆΠ½ΡΡ ΠΎΡΠ΄Π΅Π»ΠΎΡΠ½ΡΡ ΡΠ°Π±ΠΎΡ ΡΠΈΠΏΡ ΠΌΠ°ΡΠ΅ΡΠΈΠ°Π»ΠΎΠ², ΠΏΡΠ°ΠΊΡΠΈΡΠ΅ΡΠΊΠΈ ΠΏΠΎΠ²ΡΠ΅ΠΌΠ΅ΡΡΠ½ΠΎ ΠΈΡΠΏΠΎΠ»ΡΠ·ΡΠ΅ΠΌΡΠ΅ ΠΏΡΠΈ Π½Π΅ΠΎΠ±Ρ ΠΎΠ΄ΠΈΠΌΠΎΡΡΠΈ Π²ΡΠΏΠΎΠ»Π½ΠΈΡΡ Π±ΡΡΡΡΡΡ ΠΈ ΠΊΠ°ΡΠ΅ΡΡΠ²Π΅Π½Π½ΡΡ ΠΎΡΠ΄Π΅Π»ΠΊΡ Π²Π½Π΅ΡΠ½ΠΈΡ ΡΡΠ΅Π½.
Π₯Π°ΡΠ°ΠΊΡΠ΅ΡΠΈΡΡΠΈΠΊΠ° ΠΊΡΠ°ΡΠΊΠΈ
ΠΠ°ΠΊ ΠΈ Π»ΡΠ±ΠΎΠΉ ΠΊΡΠ°ΡΡΡΠΈΠΉ ΡΠΎΡΡΠ°Π², ΡΠΈΠ»ΠΈΠΊΠ°ΡΠ½ΡΠ΅ ΠΈ ΡΠΈΠ»ΠΈΠΊΠΎΠ½ΠΎΠ²ΡΠ΅ ΠΊΡΠ°ΡΠΊΠΈ ΠΎΠ±Π»Π°Π΄Π°ΡΡ ΠΎΠΏΡΠ΅Π΄Π΅Π»Π΅Π½Π½ΡΠΌ Π½Π°Π±ΠΎΡΠΎΠΌ Ρ Π°ΡΠ°ΠΊΡΠ΅ΡΠΈΡΡΠΈΠΊ, ΠΊΠΎΡΠΎΡΡΠ΅ Π²Π»ΠΈΡΡΡ Π½Π° ΠΊΠ°ΡΠ΅ΡΡΠ²Π΅Π½Π½ΡΠ΅ ΠΏΠΎΠΊΠ°Π·Π°ΡΠ΅Π»ΠΈ ΠΌΠ°ΡΠ΅ΡΠΈΠ°Π»Π°.
Π‘ΠΈΠ»ΠΈΠΊΠΎΠ½ΠΎΠ²ΡΠ΅ ΠΊΡΠ°ΡΠΊΠΈ
ΠΡΡΠ΅ΠΊΡΠΈΠ²Π½Π°Ρ ΡΠ²ΡΠ·ΡΡΡΠ°Ρ ΠΎΡΠ½ΠΎΠ²Π° Π² ΡΠΈΠ»ΠΈΠΊΠΎΠ½ΠΎΠ²ΡΡ ΠΈΠ»ΠΈ ΡΠΈΠ»ΠΎΠΊΡΠ°Π½ΠΎΠ²ΡΡ Π»Π°ΠΊΠΎΠΊΡΠ°ΡΠΎΡΠ½ΡΡ ΡΠΎΡΡΠ°Π²Π°Ρ ΠΏΡΠ΅Π΄ΡΡΠ°Π²Π»Π΅Π½Π° ΡΠΌΡΠ»ΡΠ³ΠΈΡΠΎΠ²Π°Π½Π½ΠΎΠΉ Π² Π²ΠΎΠ΄Π½ΡΡ ΡΡΠ΅Π΄Ρ ΡΠΈΠ»ΠΈΠΊΠΎΠ½ΠΎΠ²ΠΎΠΉ ΡΠΌΠΎΠ»ΠΎΠΉ. Π‘ΠΈΠ»ΠΈΠΊΠΎΠ½ΠΎΠ²Π°Ρ ΡΠΌΠΎΠ»Π° ΠΏΡΠ΅Π΄ΡΡΠ°Π²Π»ΡΠ΅Ρ ΡΠΎΠ±ΠΎΠΉ ΠΏΡΠΎΠΌΠ΅ΠΆΡΡΠΎΡΠ½ΡΡ ΡΠΎΡΠΌΡ ΠΌΠ΅ΠΆΠ΄Ρ Ρ ΠΈΠΌΠΈΡΠ΅ΡΠΊΠΈ ΡΠΈΡΡΡΠΌΠΈ ΠΎΡΠ³Π°Π½ΠΈΡΠ΅ΡΠΊΠΈΠΌ ΠΈ Π½Π΅ΠΎΡΠ³Π°Π½ΠΈΡΠ΅ΡΠΊΠΈΠΌ Π²Π΅ΡΠ΅ΡΡΠ²Π°ΠΌΠΈ.
Π‘ΠΈΠ»ΠΈΠΊΠΎΠ½ΠΎΠ²Π°Ρ ΡΠ°ΡΠ°Π΄Π½Π°Ρ ΠΊΡΠ°ΡΠΊΠ° ΡΠΏΠΎΡΠΎΠ±Π½Π° ΡΡΠΎΡΠΌΠΈΡΠΎΠ²Π°ΡΡ Π²ΠΎΠ΄ΠΎΠΎΡΡΠ°Π»ΠΊΠΈΠ²Π°ΡΡΡΡ ΠΏΠΎΠ²Π΅ΡΡ
Π½ΠΎΡΡΡ
Π‘ΠΈΠ»ΠΈΠΊΠΎΠ½ΠΎΠ²Π°Ρ ΡΠ°ΡΠ°Π΄Π½Π°Ρ ΠΊΡΠ°ΡΠΊΠ° ΡΠΏΠΎΡΠΎΠ±Π½Π° ΡΡΠΎΡΠΌΠΈΡΠΎΠ²Π°ΡΡ Π²ΠΎΠ΄ΠΎΠΎΡΡΠ°Π»ΠΊΠΈΠ²Π°ΡΡΡΡ ΠΏΠΎΠ²Π΅ΡΡ Π½ΠΎΡΡΡ, ΡΡΠΎ Π·Π°ΡΠΈΡΠ°Π΅Ρ ΠΏΠΎΠ΄Π»ΠΎΠΆΠΊΡ ΠΎΡ ΡΠ²Π»Π°ΠΆΠ½Π΅Π½ΠΈΡ. ΠΠ°ΡΠΎΠΏΡΠΎΠ½ΠΈΡΠ°Π΅ΠΌΠΎΡΡΡ ΡΠΈΠ»ΠΈΠΊΠΎΠ½ΠΎΠ²ΡΡ ΠΊΡΠ°ΡΡΡΠΈΡ ΡΠΎΡΡΠ°Π²ΠΎΠ² Π°Π½Π°Π»ΠΎΠ³ΠΈΡΠ½Π° ΠΏΠΎ ΠΏΠΎΠΊΠ°Π·Π°ΡΠ΅Π»ΡΠΌ ΡΠ°ΠΊΠΎΠΉ ΠΆΠ΅ Ρ Π°ΡΠ°ΠΊΡΠ΅ΡΠΈΡΡΠΈΠΊΠ΅ ΡΠΈΠ»ΠΈΠΊΠ°ΡΠ½ΡΡ ΠΊΡΠ°ΡΠΎΠΊ. ΠΡΡΠΎΠΊΠΈΠΉ ΡΡΠΎΠ²Π΅Π½Ρ ΠΏΠ°ΡΠΎΠΏΡΠΎΠ½ΠΈΡΠ°Π΅ΠΌΠΎΡΡΠΈ ΠΎΠ±ΡΡΡΠ½ΡΠ΅ΡΡΡ ΠΎΡΡΡΡΡΡΠ²ΠΈΠ΅ΠΌ ΡΠ΅Π»ΠΎΡΡΠ½ΠΎΠΉ ΠΏΠ»Π΅Π½ΠΊΠΈ. ΠΠΎΠΌΠΈΠΌΠΎ ΠΏΠ°ΡΠΎΠ², ΠΏΠΎΡΠΈΡΡΠΎΠ΅ ΡΠΈΠ»ΠΈΠΊΠΎΠ½ΠΎΠ²ΠΎΠ΅ ΠΏΠΎΠΊΡΡΡΠΈΠ΅ ΡΠΏΠΎΡΠΎΠ±Π½ΠΎ ΠΏΡΠΎΠΏΡΡΠΊΠ°ΡΡ Π΄Π²ΡΠΎΠΊΠΈΡΡ ΡΠ³Π»Π΅ΡΠΎΠ΄Π°, ΡΡΠΎ ΠΎΡΠ΅Π½Ρ Π²Π°ΠΆΠ½ΠΎ Π΄Π»Ρ ΠΌΠ°ΠΊΡΠΈΠΌΠ°Π»ΡΠ½ΠΎΠΉ ΠΏΡΠΎΡΠ½ΠΎΡΡΠΈ.
Π‘ΠΈΠ»ΠΈΠΊΠΎΠ½ΠΎΠ²Π°Ρ ΠΊΡΠ°ΡΠΊΠ° Π½Π΅ ΠΏΡΠΎΠ²ΠΎΡΠΈΡΡΠ΅Ρ Π²ΠΎΠ·Π½ΠΈΠΊΠ½ΠΎΠ²Π΅Π½ΠΈΡ ΠΏΠΎΠ²Π΅ΡΡ Π½ΠΎΡΡΠ½ΠΎΠ³ΠΎ Π½Π°ΠΏΡΡΠΆΠ΅Π½ΠΈΡ, ΠΏΠΎΡΡΠΎΠΌΡ ΡΠ²Π»ΡΠ΅ΡΡΡ ΠΎΠΏΡΠΈΠΌΠ°Π»ΡΠ½ΡΠΌ ΡΠ΅ΡΠ΅Π½ΠΈΠ΅ΠΌ Π΄Π»Ρ ΠΎΠΊΡΠ°ΡΠΈΠ²Π°Π½ΠΈΡ ΠΎΡΡΡΠΊΠ°ΡΡΡΠ΅Π½Π½ΡΡ ΠΏΠΎΠ²Π΅ΡΡ Π½ΠΎΡΡΠ΅ΠΉ. Π‘ΠΈΠ»ΠΈΠΊΠΎΠ½ΠΎΠ²ΡΠ΅ ΠΏΠΎΠΊΡΡΡΠΈΡ Π½Π΅ ΡΠ°Π·ΠΌΡΠ³ΡΠ°ΡΡΡΡ Π² ΠΏΡΠΎΡΠ΅ΡΡΠ΅ Π½Π°Π³ΡΠ΅Π²Π° ΠΈ Ρ Π°ΡΠ°ΠΊΡΠ΅ΡΠΈΠ·ΡΡΡΡΡ ΠΏΠΎΠ½ΠΈΠΆΠ΅Π½Π½ΡΠΌ ΡΠ΄Π΅ΡΠΆΠ°Π½ΠΈΠ΅ΠΌ Π·Π°Π³ΡΡΠ·Π½Π΅Π½ΠΈΠΉ. Π’Π°ΠΊΠΈΠ΅ ΠΊΡΠ°ΡΡΡΠΈΠ΅ ΡΠΎΡΡΠ°Π²Ρ ΠΌΠΎΠ³ΡΡ Π±ΡΡΡ ΠΈΡΠΏΠΎΠ»ΡΠ·ΠΎΠ²Π°Π½Ρ ΠΏΡΠ°ΠΊΡΠΈΡΠ΅ΡΠΊΠΈ Π½Π° Π»ΡΠ±ΡΡ ΡΠΈΠΏΠ°Ρ ΠΏΠΎΠ²Π΅ΡΡ Π½ΠΎΡΡΠΈ ΠΈ ΠΎΠ±Π»Π°Π΄Π°ΡΡ ΠΎΡΠ»ΠΈΡΠ½ΠΎΠΉ Π°Π΄Π³Π΅Π·ΠΈΠ΅ΠΉ Ρ ΠΎΡΠ³Π°Π½ΠΈΡΠ΅ΡΠΊΠΈΠΌΠΈ ΠΊΡΠ°ΡΠΊΠ°ΠΌΠΈ.
ΠΡΠ½ΠΎΠ²ΠΎΠΉ ΡΠΈΠ»ΠΈΠΊΠ°ΡΠ½ΡΡ
ΠΊΡΠ°ΡΠΎΠΊ ΡΠ»ΡΠΆΠΈΡ ΠΆΠΈΠ΄ΠΊΠΎΠ΅ ΡΡΠ΅ΠΊΠ»ΠΎ
Π‘ΠΈΠ»ΠΈΠΊΠΎΠ½ΠΎΠ²ΡΡ ΠΊΡΠ°ΡΠΊΡ ΠΏΠ΅ΡΠ΅Π΄ Π½Π°Π½Π΅ΡΠ΅Π½ΠΈΠ΅ΠΌ ΡΠ»Π΅Π΄ΡΠ΅Ρ ΡΠ°Π·Π±Π°Π²Π»ΡΡΡ Π²ΠΎΠ΄ΠΎΠΉ. ΠΠ΅ΠΌΠ°Π»ΠΎΠ²Π°ΠΆΠ½ΡΠΌ ΡΠ²Π»ΡΠ΅ΡΡΡ ΠΎΡΡΡΡΡΡΠ²ΠΈΠ΅ Ρ Π°ΡΠ°ΠΊΡΠ΅ΡΠ½ΠΎΠΉ Π΄Π»Ρ ΡΠΈΠ»ΠΈΠΊΠ°ΡΠ½ΡΡ ΡΠΎΡΡΠ°Π²ΠΎΠ² ΡΠ΅Π»ΠΎΡΠ½ΠΎΠΉ Π°Π³ΡΠ΅ΡΡΠΈΠ²Π½ΠΎΠΉ ΡΠ΅Π°ΠΊΡΠΈΠΈ.
Π‘ΠΈΠ»ΠΈΠΊΠ°ΡΠ½ΡΠ΅ ΠΊΡΠ°ΡΠΊΠΈ
ΠΡΠ½ΠΎΠ²ΠΎΠΉ ΡΠΈΠ»ΠΈΠΊΠ°ΡΠ½ΡΡ ΠΊΡΠ°ΡΠΎΠΊ ΡΠ»ΡΠΆΠΈΡ ΠΆΠΈΠ΄ΠΊΠΎΠ΅ ΡΡΠ΅ΠΊΠ»ΠΎ. ΠΡΠΎΠΈΠ·Π²ΠΎΠ΄ΠΈΡΠ΅Π»ΠΈ ΠΌΠΎΠ³ΡΡ Π²Π²ΠΎΠ΄ΠΈΡΡ Π² ΡΠΎΡΡΠ°Π² ΠΊΡΠ΅ΠΌΠ½ΠΈΠΉ-ΠΎΡΠ³Π°Π½ΠΈΡΠ΅ΡΠΊΡΡ ΡΠΌΠΎΠ»Ρ, ΠΊΠΎΡΠΎΡΠ°Ρ ΠΎΠΊΠ°Π·ΡΠ²Π°Π΅Ρ Π±Π»Π°Π³ΠΎΡΠ²ΠΎΡΠ½ΠΎΠ΅ Π²Π»ΠΈΡΠ½ΠΈΠ΅ Π½Π° ΠΊΠ°ΡΠ΅ΡΡΠ²Π΅Π½Π½ΡΠ΅ Ρ Π°ΡΠ°ΠΊΡΠ΅ΡΠΈΡΡΠΈΠΊΠΈ ΠΌΠ°ΡΠ΅ΡΠΈΠ°Π»Π°. Π ΡΠΎΡΡΠ°Π² ΠΊΡΠ°ΡΠΎΠΊ Π²Ρ ΠΎΠ΄ΡΡ ΡΠ°Π·Π»ΠΈΡΠ½ΡΠ΅ ΠΏΠΈΠ³ΠΌΠ΅Π½ΡΠΈΡΡΡΡΠΈΠ΅ ΠΏΠΎΡΠΎΡΠΊΠΈ Π½Π° ΠΎΡΠ½ΠΎΠ²Π΅ ΠΌΠ΅ΡΠ°Π»Π»ΠΎΠ², ΠΊΠΎΡΠΎΡΡΠ΅ ΠΏΡΠΈΠ΄Π°ΡΡ ΠΈΠΌ ΠΎΠΏΡΠ΅Π΄Π΅Π»Π΅Π½Π½ΡΠΉ ΡΠ²Π΅Ρ ΠΈΠ»ΠΈ ΠΎΡΡΠ΅Π½ΠΎΠΊ. ΠΡΠΏΠΎΠ»ΡΠ·ΠΎΠ²Π°Π½ΠΈΠ΅ ΠΏΠΈΠ³ΠΌΠ΅Π½ΡΠΎΠ² Π½Π° ΠΎΡΠ½ΠΎΠ²Π΅ Π°Π»ΡΠΌΠΈΠ½ΠΈΡ ΠΈ ΡΠΈΠ½ΠΊΠ° ΠΏΠΎΠ·Π²ΠΎΠ»ΡΠ΅Ρ ΠΏΠΎΠ»ΡΡΠΈΡΡ ΠΊΡΠ°ΡΡΡΠΈΠΉ ΡΠΎΡΡΠ°Π², ΠΎΠ±Π»Π°Π΄Π°ΡΡΠΈΠΉ Π°Π½ΡΠΈΠΊΠΎΡΡΠΎΠ·ΠΈΠΎΠ½Π½ΡΠΌΠΈ ΡΠ²ΠΎΠΉΡΡΠ²Π°ΠΌΠΈ. Π§ΡΠΎΠ±Ρ ΠΏΠΎΠ»ΡΡΠΈΡΡ ΠΎΠΏΡΠΈΠΌΠ°Π»ΡΠ½ΡΡ ΠΊΠΎΠ½ΡΠΈΡΡΠ΅Π½ΡΠΈΡ, Π² ΡΠΈΠ»ΠΈΠΊΠ°ΡΠ½ΡΠ΅ ΠΊΡΠ°ΡΠΊΠΈ Π΄ΠΎΠ±Π°Π²Π»ΡΡΡ ΡΠΏΠ΅ΡΠΈΠ°Π»ΡΠ½ΡΠ΅ Π½Π°ΠΏΠΎΠ»Π½ΠΈΡΠ΅Π»ΠΈ, Π² ΠΊΠ°ΡΠ΅ΡΡΠ²Π΅ ΠΊΠΎΡΠΎΡΡΡ ΠΌΠΎΠ³ΡΡ Π±ΡΡΡ Π·Π°Π΄Π΅ΠΉΡΡΠ²ΠΎΠ²Π°Π½Ρ ΡΠ»ΡΠ΄Π°, ΠΌΠ΅Π» ΠΈ ΡΠ°Π»ΡΠΊ.
Π Π½Π΅Π΄ΠΎΡΡΠ°ΡΠΊΠ°ΠΌ ΡΠ°ΠΊΠΎΠ³ΠΎ ΠΌΠ°ΡΠ΅ΡΠΈΠ°Π»Π° ΠΌΠΎΠΆΠ½ΠΎ ΠΎΡΠ½Π΅ΡΡΠΈ ΡΠΎΠΊΡΠΈΡΠ½ΠΎΡΡΡ, ΠΎΡΡΡΡΡΡΠ²ΠΈΠ΅ ΠΊΠ°ΡΠ΅ΡΡΠ²Π΅Π½Π½ΠΎΠΉ ΡΠ»Π°ΡΡΠΈΡΠ½ΠΎΡΡΠΈ, ΡΡΡΠ΄Π½ΠΎΡΡΡ ΡΠ΄Π°Π»Π΅Π½ΠΈΡ Ρ ΠΏΠΎΠ²Π΅ΡΡ Π½ΠΎΡΡΠΈ, Π½Π΅Π²ΠΎΠ·ΠΌΠΎΠΆΠ½ΠΎΡΡΡ ΠΈΡΠΏΠΎΠ»ΡΠ·ΠΎΠ²Π°Π½ΠΈΡ ΡΠΈΠ½ΡΠ΅ΡΠΈΡΠ΅ΡΠΊΠΈΡ ΠΎΡΠ³Π°Π½ΠΈΡΠ΅ΡΠΊΠΈΡ ΠΊΡΠ°ΡΠΎΠΊ Π² ΠΊΠ°ΡΠ΅ΡΡΠ²Π΅ ΠΏΠΎΠ²Π΅ΡΡ Π½ΠΎΡΡΠ½ΠΎΠ³ΠΎ ΡΠ»ΠΎΡ.
Π‘ΠΈΠ»ΠΈΠΊΠΎΠ½ΠΎΠ²Π°Ρ ΠΊΡΠ°ΡΠΊΠ°: ΡΠ΅Ρ Π½ΠΈΠΊΠ° Π½Π°Π½Π΅ΡΠ΅Π½ΠΈΡ (Π²ΠΈΠ΄Π΅ΠΎ)
ΠΡΠΎΠ±Π΅Π½Π½ΠΎΡΡΠΈ Π²ΡΠ±ΠΎΡΠ°
ΠΠ° ΡΠ΅Π³ΠΎΠ΄Π½ΡΡΠ½ΠΈΠΉ Π΄Π΅Π½Ρ Π½Π° ΡΡΠ½ΠΊΠ΅ Π»Π°ΠΊΠΎΠΊΡΠ°ΡΠΎΡΠ½ΡΡ ΠΈΠ·Π΄Π΅Π»ΠΈΠΉ ΠΏΡΠ΅Π΄ΡΡΠ°Π²Π»Π΅Π½ΠΎ Π±ΠΎΠ»ΡΡΠΎΠ΅ ΠΊΠΎΠ»ΠΈΡΠ΅ΡΡΠ²ΠΎ ΠΊΡΠ°ΡΠΎΠΊ Π΄Π»Ρ ΡΠ°ΡΠ°Π΄Π½ΠΎΠΉ ΠΎΡΠ΄Π΅Π»ΠΊΠΈ, ΠΊΠΎΡΠΎΡΡΠ΅ ΠΎΡΠ»ΠΈΡΠ°ΡΡΡΡ Π½Π΅ ΡΠΎΠ»ΡΠΊΠΎ ΡΠΎΡΡΠ°Π²ΠΎΠΌ, Π½ΠΎ ΠΈ ΡΠ²ΠΎΠΉΡΡΠ²Π°ΠΌΠΈ, Π° ΡΠ°ΠΊΠΆΠ΅ ΡΡΠ½ΠΊΡΠΈΠΎΠ½Π°Π»ΡΠ½ΡΠΌ Π½Π°Π·Π½Π°ΡΠ΅Π½ΠΈΠ΅ΠΌ.
| Π’ΠΈΠΏ Π»Π°ΠΊΠΎΠΊΡΠ°ΡΠΎΡΠ½ΠΎΠ³ΠΎ ΡΠΎΡΡΠ°Π²Π° | ΠΡΡΡΠΈΠ΅ ΠΏΡΠΎΠΈΠ·Π²ΠΎΠ΄ΠΈΡΠ΅Π»ΠΈ | ΠΠΎΡΡΠΎΠΈΠ½ΡΡΠ²Π° | ΠΠ΅Π΄ΠΎΡΡΠ°ΡΠΊΠΈ |
| Π‘ΠΈΠ»ΠΈΠΊΠ°ΡΠ½ΡΠ΅ ΠΊΡΠ°ΡΠΊΠΈ | Π€Π°ΡΠ°Π΄Π½Π°Ρ ΠΊΡΠ°ΡΠΊΠ° Β«KivitexΒ» ΠΎΡ ΠΏΠΎΠΏΡΠ»ΡΡΠ½ΠΎΠ³ΠΎ ΠΈ ΠΎΡΠ΅Π½Ρ ΠΈΠ·Π²Π΅ΡΡΠ½ΠΎΠ³ΠΎ ΠΊΠ°ΠΊ Π² Π½Π°ΡΠ΅ΠΉ ΡΡΡΠ°Π½Π΅, ΡΠ°ΠΊ ΠΈ Π·Π° ΡΡΠ±Π΅ΠΆΠΎΠΌ ΠΏΡΠΎΠΈΠ·Π²ΠΎΠ΄ΠΈΡΠ΅Π»Ρ Β«TikkurilaΒ» | ΠΠ°ΠΈΠ»ΡΡΡΠΈΠΉ Π²Π°ΡΠΈΠ°Π½Ρ Π΄Π»Ρ ΠΎΠΊΡΠ°ΡΠΈΠ²Π°Π½ΠΈΡ Π°Π±ΡΠΎΠ»ΡΡΠ½ΠΎ Π»ΡΠ±ΡΡ ΡΠΈΠΏΠΎΠ² ΠΈΠ·Π²Π΅ΡΡΠΊΠΎΠ²ΡΡ ΡΠ°ΡΠ°Π΄Π½ΡΡ ΠΏΠΎΠ²Π΅ΡΡ Π½ΠΎΡΡΠ΅ΠΉ | ΠΡΠ΅Π½Ρ ΡΠ»Π°Π±ΡΠ΅ ΠΏΠΎΠΊΠ°Π·Π°ΡΠ΅Π»ΠΈ Π°Π΄Π³Π΅Π·ΠΈΠΈ Ρ ΡΠ°Π·Π»ΠΈΡΠ½ΡΠΌΠΈ Π²ΠΈΠ΄Π°ΠΌΠΈ ΠΎΡΠ³Π°Π½ΠΈΡΠ΅ΡΠΊΠΎΠΉ ΠΎΡΠ½ΠΎΠ²Ρ, Π° ΡΠ°ΠΊΠΆΠ΅ ΡΠΎ ΡΡΠ°ΡΡΠΌΠΈ ΠΏΠΎΠΊΡΡΡΠΈΡΠΌΠΈ Π½Π° ΠΎΡΠ½ΠΎΠ²Π΅ ΡΠΈΠ»ΠΈΠΊΠΎΠ½ΠΎΠ²ΡΡ ΠΈΠ»ΠΈ Π°ΠΊΡΠΈΠ»ΠΎΠ²ΡΡ ΠΊΡΠ°ΡΠΎΠΊ |
| Π‘ΠΈΠ»ΠΈΠΊΠΎΠ½ΠΎΠ²ΡΠ΅ ΠΊΡΠ°ΡΠΊΠΈ | Β«PufasΒ», Β«KreiselΒ», Β«Caparol-ThermoSanΒ» ΠΈ Β«TikkurilaΒ» | ΠΠΏΡΠΈΠΌΠ°Π»ΡΠ½ΠΎΠ΅ ΡΠΎΡΠ΅ΡΠ°Π½ΠΈΠ΅ Π°ΠΊΡΠΈΠ»Π° ΠΈ ΡΠΈΠ»ΠΈΠΊΠ°ΡΠ°. ΠΠΌΠ΅ΡΡ Π½ΠΈΠ·ΠΊΠΈΠ΅ ΠΏΠΎΠΊΠ°Π·Π°ΡΠ΅Π»ΠΈ Π²ΠΎΠ΄ΠΎΠΏΠΎΠ³Π»ΠΎΡΠ°Π΅ΠΌΠΎΡΡΠΈ ΠΈ ΠΏΠ°ΡΠΎΠΏΡΠΎΠ½ΠΈΡΠ°Π΅ΠΌΠΎΡΡΠΈ. ΠΡΡΠΎΠΊΠΈΠΉ ΡΡΠΎΠ²Π΅Π½Ρ Π·Π°ΡΠΈΡΡ ΠΎΡ ΡΠ»ΡΡΡΠ°ΡΠΈΠΎΠ»Π΅ΡΠ°, ΠΌΠ΅Ρ Π°Π½ΠΈΡΠ΅ΡΠΊΠΈΡ Π²ΠΎΠ·Π΄Π΅ΠΉΡΡΠ²ΠΈΠΉ ΠΈ ΡΠ΅Π·ΠΊΠΈΡ ΡΠ΅ΠΌΠΏΠ΅ΡΠ°ΡΡΡΠ½ΡΡ ΠΏΠ΅ΡΠ΅ΠΏΠ°Π΄ΠΎΠ² | ΠΡΡΠΎΠΊΠ°Ρ ΡΡΠΎΠΈΠΌΠΎΡΡΡ; ΠΏΡΠΈ Π½Π°Π½Π΅ΡΠ΅Π½ΠΈΠΈ ΡΠ°ΠΊΠΎΠΉ ΠΊΡΠ°ΡΠΊΠΈ Π½Π° Π°ΡΠΌΠΈΡΠΎΠ²Π°Π½Π½ΡΠΉ Π±Π΅ΡΠΎΠ½ ΡΠ»Π΅Π΄ΡΠ΅Ρ ΠΈΡΠΏΠΎΠ»ΡΠ·ΠΎΠ²Π°ΡΡ Π°Π½ΡΠΈΠΊΠΎΡΡΠΎΠ·ΠΈΠΉΠ½ΡΡ Π·Π°ΡΠΈΡΡ |
Π’Π΅Ρ Π½ΠΎΠ»ΠΎΠ³ΠΈΡ Π½Π°Π½Π΅ΡΠ΅Π½ΠΈΡ
ΠΡΠΈ ΡΠ°Π±ΠΎΡΠ°Ρ ΠΏΠΎ Π½Π°Π½Π΅ΡΠ΅Π½ΠΈΡ ΡΠ°ΡΠ°Π΄Π½ΠΎΠΉ ΠΊΡΠ°ΡΠΊΠΈ ΡΠ»Π΅Π΄ΡΠ΅Ρ ΡΡΠΈΡΡΠ²Π°ΡΡ Π½Π΅ΠΊΠΎΡΠΎΡΡΠ΅ ΡΡΠ΅Π±ΠΎΠ²Π°Π½ΠΈΡ, ΠΎΠ±ΡΡΠ»ΠΎΠ²Π»Π΅Π½Π½ΡΠ΅ ΠΎΡΠΎΠ±Π΅Π½Π½ΠΎΡΡΡΠΌΠΈ ΡΠΎΡΡΠ°Π²Π°:
- ΡΠΈΠ»ΠΈΠΊΠΎΠ½ΠΎΠ²ΡΠ΅ ΠΊΡΠ°ΡΠΊΠΈ Π±ΠΎΠ»Π΅Π΅ ΡΠΊΠΎΠ»ΠΎΠ³ΠΈΡΠ½Ρ, ΠΈ ΠΏΡΠΈ ΡΠ°Π±ΠΎΡΠ΅ Π½Π΅ ΡΡΠ΅Π±ΡΠ΅ΡΡΡ ΡΠΎΠ±Π»ΡΠ΄Π΅Π½ΠΈΡ ΠΎΡΠΎΠ±ΡΡ ΠΌΠ΅Ρ ΠΏΡΠ΅Π΄ΠΎΡΡΠΎΡΠΎΠΆΠ½ΠΎΡΡΠΈ;
- ΡΠΈΠ»ΠΈΠΊΠ°ΡΠ½Π°Ρ ΠΊΡΠ°ΡΠΊΠ° ΡΠΎΠ΄Π΅ΡΠΆΠΈΡ ΡΠ΅Π»ΠΎΡΠ½ΡΠ΅ ΠΊΠΎΠΌΠΏΠΎΠ½Π΅Π½ΡΡ, ΠΏΠΎΡΡΠΎΠΌΡ ΡΠ°Π±ΠΎΡΠ°ΡΡ Ρ Π½Π΅ΠΉ Π½ΡΠΆΠ½ΠΎ ΠΎΡΡΠΎΡΠΎΠΆΠ½ΠΎ;
- ΡΠΈΠ»ΠΈΠΊΠ°ΡΠ½ΡΠ΅ ΠΊΡΠ°ΡΠΊΠΈ ΠΏΡΠΈΠ³ΠΎΠ΄Π½Ρ Π΄Π»Ρ Π½Π°Π½Π΅ΡΠ΅Π½ΠΈΡ Π½Π° ΠΏΠΎΠ²Π΅ΡΡ Π½ΠΎΡΡΠΈ, ΠΊΠΎΡΠΎΡΡΠ΅ ΠΈΠΌΠ΅ΡΡ ΠΌΠΈΠ½Π΅ΡΠ°Π»ΡΠ½ΡΡ ΠΎΡΠ½ΠΎΠ²Ρ;
- ΠΏΠ΅ΡΠ΅Π΄ Π½Π°Π½Π΅ΡΠ΅Π½ΠΈΠ΅ΠΌ ΡΡΠ΅Π±ΡΠ΅ΡΡΡ Π²ΡΡΠΎΠ²Π½ΡΡΡ ΠΏΠΎΠ²Π΅ΡΡ Π½ΠΎΡΡΡ ΡΡΠ΅Π½, Π·Π°Π΄Π΅Π»Π°ΡΡ ΡΡΠ΅ΡΠΈΠ½Ρ ΡΠΏΠ°ΠΊΠ»Π΅Π²ΠΊΠ°ΠΌΠΈ ΠΈΠ»ΠΈ ΡΡΡΠΊΠ°ΡΡΡΠΊΠ°ΠΌΠΈ;
CΠΈΠ»ΠΈΠΊΠΎΠ½ΠΎΠ²ΡΠ΅ ΠΊΡΠ°ΡΠΊΠΈ Π±ΠΎΠ»Π΅Π΅ ΡΠΊΠΎΠ»ΠΎΠ³ΠΈΡΠ½Ρ, ΠΈ ΠΏΡΠΈ ΡΠ°Π±ΠΎΡΠ΅ Π½Π΅ ΡΡΠ΅Π±ΡΠ΅ΡΡΡ ΡΠΎΠ±Π»ΡΠ΄Π΅Π½ΠΈΡ ΠΎΡΠΎΠ±ΡΡ
ΠΌΠ΅Ρ ΠΏΡΠ΅Π΄ΠΎΡΡΠΎΡΠΎΠΆΠ½ΠΎΡΡΠΈ
- ΡΠ΅ΠΊΠΎΠΌΠ΅Π½Π΄ΡΠ΅ΡΡΡ ΠΏΠΎΠ»Π½ΠΎΡΡΡΡ ΡΠ΄Π°Π»ΠΈΡΡ ΡΡΠ°ΡΡΠΉ ΠΊΡΠ°ΡΡΡΠΈΠΉ ΡΠΎΡΡΠ°Π² Ρ ΠΏΠΎΠ²Π΅ΡΡ Π½ΠΎΡΡΠΈ, ΠΏΠΎΠ΄Π»Π΅ΠΆΠ°ΡΠ΅ΠΉ ΠΎΠΊΡΠ°ΡΠΈΠ²Π°Π½ΠΈΡ;
- ΠΏΠΎΠ²Π΅ΡΡ Π½ΠΎΡΡΡ Π΄ΠΎΠ»ΠΆΠ½Π° Π±ΡΡΡ ΠΌΠ°ΠΊΡΠΈΠΌΠ°Π»ΡΠ½ΠΎ ΡΠΈΡΡΠΎΠΉ, ΡΡΡ ΠΎΠΉ ΠΈ ΡΠΎΠ²Π½ΠΎΠΉ, Π° ΠΏΡΠΈ Π½Π΅ΠΎΠ±Ρ ΠΎΠ΄ΠΈΠΌΠΎΡΡΠΈ ΠΏΡΠΎΠ²ΠΎΠ΄ΠΈΡΡΡ ΠΎΠ±ΡΠ°Π±ΠΎΡΠΊΠ° ΠΏΡΠΎΡΠΈΠ² ΠΏΠ»Π΅ΡΠ΅Π½ΠΈ ΠΈ Π³ΡΠΈΠ±ΠΊΠ°.
ΠΠΎΡΠ»Π΅ ΠΏΠΎΠ»Π½ΠΎΠΉ ΠΏΠΎΠ΄Π³ΠΎΡΠΎΠ²ΠΊΠΈ Π½Π°Π½ΠΎΡΠΈΡΡΡ Π³ΡΡΠ½ΡΠΎΠ²ΠΊΠ°. Π‘ΠΈΠ»ΠΈΠΊΠ°ΡΠ½ΡΡ ΠΊΡΠ°ΡΠΊΡ Π½Π΅Π»ΡΠ·Ρ Π½Π°Π½ΠΎΡΠΈΡΡ Π½Π° Π½Π΅ Π·Π°ΡΠ²Π΅ΡΠ΄Π΅Π²ΡΡΡ ΡΡΡΠΊΠ°ΡΡΡΠΊΡ. ΠΠ»Ρ Π½Π°Π½Π΅ΡΠ΅Π½ΠΈΡ ΡΠΈΠ»ΠΈΠΊΠ°ΡΠ½ΠΎΠΉ ΠΊΡΠ°ΡΠΊΠΈ ΠΈΡΠΏΠΎΠ»ΡΠ·ΡΡΡΡΡ ΠΊΠΈΡΡΠΈ, Π²Π°Π»ΠΈΠΊΠΈ ΠΈ ΠΊΡΠ°ΡΠΊΠΎΠΏΡΠ»ΡΡΡ.
ΠΡ Π²Π°ΠΌ ΡΠ°ΠΊΠΆΠ΅ ΠΏΡΠ΅Π΄Π»Π°Π³Π°Π΅ΠΌΒ ΠΏΡΠΎΡΠΈΡΠ°ΡΡ ΡΡΠ°ΡΡΡ, Π² ΠΊΠΎΡΠΎΡΠΎΠΉ ΡΠ°ΡΡΠΊΠ°Π·ΡΠ²Π°Π΅ΡΡΡ ΠΎΠ± ΠΎΡΠΎΠ±Π΅Π½Π½ΠΎΡΡΡΡ ΠΈΡΠΏΠΎΠ»ΡΠ·ΠΎΠ²Π°Π½ΠΈΡ ΠΊΡΠ°ΡΠΊΠΈ ΠΏΡΠΈ ΠΎΠ±Π»ΠΈΡΠΎΠ²ΠΊΠ΅ ΡΠ°ΡΠ°Π΄ΠΎΠ² Π·Π΄Π°Π½ΠΈΠΉ.
Π Π΅ΠΊΠΎΠΌΠ΅Π½Π΄ΡΠ΅ΡΡΡ ΠΏΠΎΠ»Π½ΠΎΡΡΡΡ ΡΠ΄Π°Π»ΠΈΡΡ ΡΡΠ°ΡΡΠΉ ΠΊΡΠ°ΡΡΡΠΈΠΉ ΡΠΎΡΡΠ°Π² Ρ ΠΏΠΎΠ²Π΅ΡΡ
Π½ΠΎΡΡΠΈ, ΠΏΠΎΠ΄Π»Π΅ΠΆΠ°ΡΠ΅ΠΉ ΠΎΠΊΡΠ°ΡΠΈΠ²Π°Π½ΠΈΡ
ΠΡΠ·ΡΠ²Ρ ΠΏΠΎΡΡΠ΅Π±ΠΈΡΠ΅Π»Π΅ΠΉ
ΠΠΎ ΠΌΠ½Π΅Π½ΠΈΡ Π±ΠΎΠ»ΡΡΠΈΠ½ΡΡΠ²Π° ΠΏΠΎΡΡΠ΅Π±ΠΈΡΠ΅Π»Π΅ΠΉ, ΠΊΡΠ°ΡΠΊΠΈ Π½Π° ΠΎΡΠ½ΠΎΠ²Π΅ ΡΠΈΠ»ΠΈΠΊΠΎΠ½ΠΎΠ²ΡΡ ΡΠΌΠΎΠ» ΠΎΡΠ½ΠΎΡΡΡΡΡ ΠΊ ΠΊΠ°ΡΠ΅Π³ΠΎΡΠΈΠΈ ΡΠ°ΠΌΡΡ ΡΠ½ΠΈΠ²Π΅ΡΡΠ°Π»ΡΠ½ΡΡ ΠΎΡΠ΄Π΅Π»ΠΎΡΠ½ΡΡ ΠΌΠ°ΡΠ΅ΡΠΈΠ°Π»ΠΎΠ² Π΄Π»Ρ ΡΠ°ΡΠ°Π΄Π½ΠΎΠΉ ΡΠ°ΡΡΠΈ Π·Π΄Π°Π½ΠΈΡ. ΠΠ½ΠΈ ΠΎΠΏΡΠΈΠΌΠ°Π»ΡΠ½ΠΎ ΠΏΠΎΠ΄Ρ ΠΎΠ΄ΡΡ Π΄Π»Ρ ΠΎΠΊΡΠ°ΡΠΈΠ²Π°Π½ΠΈΡ ΠΏΡΠ°ΠΊΡΠΈΡΠ΅ΡΠΊΠΈ Π»ΡΠ±ΡΡ ΠΏΠΎΠ²Π΅ΡΡ Π½ΠΎΡΡΠ΅ΠΉ ΠΈ ΠΎΠ±Π»Π°Π΄Π°ΡΡ ΠΎΡΠΌΠ΅Π½Π½ΡΠΌΠΈ Ρ Π°ΡΠ°ΠΊΡΠ΅ΡΠΈΡΡΠΈΠΊΠ°ΠΌΠΈ Π²ΠΎ Π²ΡΠ΅Ρ ΠΎΡΠ½ΠΎΡΠ΅Π½ΠΈΡΡ . ΠΠ΄Π½Π°ΠΊΠΎ ΡΡΠΎΠΈΠΌΠΎΡΡΡ ΡΠ°ΠΊΠΎΠ³ΠΎ ΠΌΠ°ΡΠ΅ΡΠΈΠ°Π»Π° Π΄Π°Π»Π΅ΠΊΠ° ΠΎΡ Π±ΡΠ΄ΠΆΠ΅ΡΠ½ΠΎΠΉ, ΠΏΠΎΡΡΠΎΠΌΡ ΡΠ°ΡΠ΅ Π²ΡΠ΅Π³ΠΎ ΠΏΡΠ΅Π΄ΠΏΠΎΡΡΠ΅Π½ΠΈΠ΅ ΠΎΡΠ΄Π°Π΅ΡΡΡ ΡΠΈΠ»ΠΈΠΊΠ°ΡΠ½ΡΠΌ ΠΊΡΠ°ΡΠΊΠ°ΠΌ.
ΠΠ°ΠΊΠΎΠ²Ρ ΠΏΡΠ΅ΠΈΠΌΡΡΠ΅ΡΡΠ²Π° ΡΠΈΠ»ΠΈΠΊΠΎΠ½ΠΎΠ²ΡΡ ΠΊΡΠ°ΡΠΎΠΊ (Π²ΠΈΠ΄Π΅ΠΎ)
Π‘Π°ΠΌΡΠ΅ ΠΏΠΎΠ»ΠΎΠΆΠΈΡΠ΅Π»ΡΠ½ΡΠ΅ ΠΎΡΠ·ΡΠ²Ρ Π·Π°ΡΠ»ΡΠΆΠΈΠ»Π° ΡΠΈΠ»ΠΈΠΊΠ°ΡΠ½Π°Ρ ΠΊΡΠ°ΡΠΊΠ° Β«Reine SilikatfarbeΒ», ΠΊΠΎΡΠΎΡΠ°Ρ ΠΎΡΠ»ΠΈΡΠ½ΠΎ Π·Π°ΡΠ΅ΠΊΠΎΠΌΠ΅Π½Π΄ΠΎΠ²Π°Π»Π° ΡΠ΅Π±Ρ Π±Π»Π°Π³ΠΎΠ΄Π°ΡΡ ΠΏΡΠ΅Π²ΠΎΡΡ ΠΎΠ΄Π½ΠΎΠΉ Π΄ΠΈΡΡΡΠ·ΠΈΠΎΠ½Π½ΠΎΠΉ ΡΠΏΠΎΡΠΎΠ±Π½ΠΎΡΡΠΈ. ΠΡΠΎΠΌΠ΅ ΡΠΎΠ³ΠΎ, ΠΌΠ°ΡΠ΅ΡΠΈΠ°Π» ΠΈΠΌΠ΅Π΅Ρ Π²ΡΡΠΎΠΊΠΈΠΉ ΡΠ΅Π»ΠΎΡΠ½ΠΎΠΉ ΡΡΠΎΠ²Π΅Π½Ρ ΠΈ ΡΠΏΠΎΡΠΎΠ±Π΅Π½ ΠΎΠΊΠ°Π·ΡΠ²Π°ΡΡ ΡΡΠ½Π³ΠΈΡΠΈΠ΄Π½ΠΎΠ΅ ΠΈ Π°Π½ΡΠΈΠ±Π°ΠΊΡΠ΅ΡΠΈΠ°Π»ΡΠ½ΠΎΠ΅ Π²ΠΎΠ·Π΄Π΅ΠΉΡΡΠ²ΠΈΡ. ΠΠΎΠ²Π΅ΡΡ Π½ΠΎΡΡΡ, ΠΎΠΊΡΠ°ΡΠ΅Π½Π½Π°Ρ ΡΠ°ΠΊΠΎΠΉ ΠΊΡΠ°ΡΠΊΠΎΠΉ, Ρ Π°ΡΠ°ΠΊΡΠ΅ΡΠΈΠ·ΡΠ΅ΡΡΡ ΡΡΡΠΎΠΉΡΠΈΠ²ΠΎΡΡΡΡ ΠΊ ΠΈΡΡΠΈΡΠ°Π½ΠΈΡ, ΠΏΠΎΠ³ΠΎΠ΄Π½ΡΠΌ ΡΡΠ»ΠΎΠ²ΠΈΡΠΌ ΠΈ Ρ ΠΈΠΌΠΈΠΊΠ°ΡΠ°ΠΌ. ΠΠ²ΡΡ ΠΊΠΎΠΌΠΏΠΎΠ½Π΅Π½ΡΠ½ΡΠΉ ΡΠΎΡΡΠ°Π² ΠΎΡΠ΅Π½Ρ Π΄ΠΎΠ»Π³ΠΎΠ²Π΅ΡΠ΅Π½ ΠΈ ΡΠ΅ΠΊΠΎΠΌΠ΅Π½Π΄ΡΠ΅ΡΡΡ Π΄Π»Ρ ΠΎΠΊΡΠ°ΡΠΈΠ²Π°Π½ΠΈΡ ΡΠ°ΡΠ°Π΄ΠΎΠ² ΠΌΠ½ΠΎΠ³ΠΈΠΌΠΈ ΡΠΏΠ΅ΡΠΈΠ°Π»ΠΈΡΡΠ°ΠΌΠΈ.
ΠΠΎΠ±Π°Π²ΠΈΡΡ ΠΊΠΎΠΌΠΌΠ΅Π½ΡΠ°ΡΠΈΠΉ
housefasad.ru
Π‘ΠΈΠ»ΠΈΠΊΠΎΠ½ΠΎΠ²ΡΠ΅ ΠΊΡΠ°ΡΠΊΠΈ: Π²ΠΈΠ΄Ρ, ΡΠΎΡΡΠ°Π², Ρ Π°ΡΠ°ΠΊΡΠ΅ΡΠΈΡΡΠΈΠΊΠΈ, ΠΏΡΠΈΠΌΠ΅Π½Π΅Π½ΠΈΠ΅
ΠΠ»Ρ Π΄ΠΎΡΡΠΈΠΆΠ΅Π½ΠΈΡ Π²ΡΡΠΎΠΊΠΎΠ³ΠΎ ΡΠ΅Π·ΡΠ»ΡΡΠ°ΡΠ° ΠΏΡΠΈ Π²ΡΠΏΠΎΠ»Π½Π΅Π½ΠΈΠΈ ΡΠ΅ΠΌΠΎΠ½ΡΠ½ΠΎ-ΡΡΡΠΎΠΈΡΠ΅Π»ΡΠ½ΡΡ ΡΠ°Π±ΠΎΡ Π½Π΅Π΄ΠΎΡΡΠ°ΡΠΎΡΠ½ΠΎ ΡΠΎΠ»ΡΠΊΠΎ Π½Π°Π²ΡΠΊΠΎΠ² ΠΈ Π·Π½Π°Π½ΠΈΠΉ ΠΌΠ°ΡΡΠ΅ΡΠ°. ΠΠ΅ΠΌΠ°Π»ΠΎΠ²Π°ΠΆΠ½ΠΎΠΉ ΡΠΎΡΡΠ°Π²Π»ΡΡΡΠ΅ΠΉ ΡΠ²Π»ΡΠ΅ΡΡΡ ΠΊΠ°ΡΠ΅ΡΡΠ²ΠΎ ΠΏΡΠΈΠΌΠ΅Π½ΡΠ΅ΠΌΡΡ ΠΌΠ°ΡΠ΅ΡΠΈΠ°Π»ΠΎΠ². ΠΠ΄Π½ΠΈΠΌ ΠΈΠ· ΠΏΠΎΠΊΡΡΡΠΈΠΉ, ΠΎΡΠ²Π΅ΡΠ°ΡΡΠΈΡ ΠΎΡΠ½ΠΎΠ²Π½ΡΠΌ ΡΡΠ΅Π±ΠΎΠ²Π°Π½ΠΈΡΠΌ ΡΡΡΠΎΠΈΡΠ΅Π»ΡΠ½ΠΎΠΉ ΠΈΠ½Π΄ΡΡΡΡΠΈΠΈ, ΡΠ²Π»ΡΡΡΡΡ ΡΠΈΠ»ΠΈΠΊΠΎΠ½ΠΎΠ²ΡΠ΅ ΠΊΡΠ°ΡΠΊΠΈ.
ΠΡΠΎ ΡΠ½ΠΈΠΊΠ°Π»ΡΠ½ΡΠΉ ΠΏΡΠΎΠ΄ΡΠΊΡ, ΠΊΠΎΡΠΎΡΡΠΉ Π½Π΅ ΡΠ°ΠΊ Π΄Π°Π²Π½ΠΎ ΡΡΠ°Π» Π΄ΠΎΡΡΡΠΏΠ΅Π½ ΡΡΠ΅Π΄Π½Π΅ΡΡΠ°ΡΠΈΡΡΠΈΡΠ΅ΡΠΊΠΎΠΌΡ ΠΏΠΎΡΡΠ΅Π±ΠΈΡΠ΅Π»Ρ. Π Π΅Π³ΠΎ ΠΎΡΠ½ΠΎΠ²Π΅ Π»Π΅ΠΆΠΈΡ ΠΈΡΠΏΠΎΠ»ΡΠ·ΠΎΠ²Π°Π½ΠΈΠ΅ ΠΊΡΠ΅ΠΌΠ½ΠΈΠΉΠΎΡΠ³Π°Π½ΠΈΡΠ΅ΡΠΊΠΈΡ ΡΠΎΠ΅Π΄ΠΈΠ½Π΅Π½ΠΈΠΉ β ΡΠΌΠΎΠ». ΠΠ»Π°Π³ΠΎΠ΄Π°ΡΡ ΠΈΠΌ ΠΊΡΠ°ΡΠΊΠ° Π½Π° ΡΠΈΠ»ΠΈΠΊΠΎΠ½ΠΎΠ²ΠΎΠΉ ΠΎΡΠ½ΠΎΠ²Π΅ ΡΠ²Π»ΡΠ΅ΡΡΡ ΡΠ½ΠΈΠ²Π΅ΡΡΠ°Π»ΡΠ½ΡΠΌ ΠΌΠ°ΡΠ΅ΡΠΈΠ°Π»ΠΎΠΌ, ΠΊΠΎΡΠΎΡΡΠΉ ΠΌΠΎΠΆΠ½ΠΎ ΠΏΡΠΈΠΌΠ΅Π½ΡΡΡ Π΄Π»Ρ ΠΏΡΠΎΠ²Π΅Π΄Π΅Π½ΠΈΡ Π½Π΅ ΡΠΎΠ»ΡΠΊΠΎ Π²Π½ΡΡΡΠ΅Π½Π½ΠΈΡ , Π½ΠΎ ΠΈ Π½Π°ΡΡΠΆΠ½ΡΡ ΡΠ°Π±ΠΎΡ.
Π‘ΠΎΡΡΠ°Π² ΡΠΈΠ»ΠΈΠΊΠΎΠ½ΠΎΠ²ΠΎΠΉ ΡΠΌΡΠ»ΡΡΠΈΠΈ
Π‘ΠΈΠ»ΠΈΠΊΠΎΠ½ΠΎΠ²ΡΠ΅ ΠΊΡΠ°ΡΠΊΠΈ ΠΎΠ±ΡΠ΅Π΄ΠΈΠ½ΡΡΡ Π² ΡΠ΅Π±Π΅ ΡΠ»Π΅Π΄ΡΡΡΠΈΠ΅ ΡΠ»Π΅ΠΌΠ΅Π½ΡΡ: Π²ΠΎΠ΄Ρ, ΡΠΌΠΎΠ»Ρ, ΠΎΡΠ³Π°Π½ΠΈΡΠ΅ΡΠΊΠΈΠ΅ ΡΠ°ΡΡΠΈΡΡ. ΠΠ½ΠΎΠ³Π΄Π° Π² ΡΠΎΡΡΠ°Π² ΡΠΌΡΠ»ΡΡΠΈΠΈ Π²ΠΊΠ»ΡΡΠ°ΡΡ ΡΠΎΠΏΠΎΠ»ΠΈΠΌΠ΅ΡΡ Π°ΠΊΡΠΈΠ»Π°. ΠΠ΄Π½ΠΎΠΉ ΠΈΠ· ΠΎΡΠΎΠ±Π΅Π½Π½ΠΎΡΡΠ΅ΠΉ ΠΊΡΠ°ΡΠΊΠΈ ΡΠ²Π»ΡΠ΅ΡΡΡ ΠΎΡΡΡΡΡΡΠ²ΠΈΠ΅ Π°Π³ΡΠ΅ΡΡΠΈΠ²Π½ΡΡ Ρ ΠΈΠΌΠΈΡΠ΅ΡΠΊΠΈΡ ΠΊΠΎΠΌΠΏΠΎΠ½Π΅Π½ΡΠΎΠ², ΡΠΏΠΎΡΠΎΠ±Π½ΡΡ Π½Π°Π½Π΅ΡΡΠΈ Π²ΡΠ΅Π΄ Π·Π΄ΠΎΡΠΎΠ²ΡΡ ΡΠ΅Π»ΠΎΠ²Π΅ΠΊΠ°.
Π£Π½ΠΈΠΊΠ°Π»ΡΠ½ΡΠ΅ ΡΠ²ΠΎΠΉΡΡΠ²Π° ΡΠΈΠ»ΠΈΠΊΠΎΠ½ΠΎΠ²ΠΎΠΉ ΠΊΡΠ°ΡΠΊΠΈ ΠΎΠ±Π΅ΡΠΏΠ΅ΡΠΈΠ²Π°ΡΡ ΠΈΠΌΠ΅Π½Π½ΠΎ ΠΊΠΈΡΠ»ΠΎΡΠΎΠ΄ΠΎΡΠΎΠ΄Π΅ΡΠΆΠ°ΡΠΈΠ΅ ΡΠΌΠΎΠ»Ρ. ΠΠΎ ΡΠ²ΠΎΠ΅ΠΉ ΡΡΡΡΠΊΡΡΡΠ΅ ΠΎΠ½ΠΈ Π±Π»ΠΈΠ·ΠΊΠΈ ΠΊ ΡΠ°ΡΡΠΈΡΠ°ΠΌ ΠΊΠ²Π°ΡΡΠ°, Ρ ΠΎΡΡ Π² ΠΈΡ ΡΠΈΠ½ΡΠ΅Π·Π΅ ΠΏΡΠΈΠ½ΠΈΠΌΠ°Π΅Ρ ΡΡΠ°ΡΡΠΈΠ΅ Π΄ΡΡΠ³ΠΎΠΉ Ρ ΠΈΠΌΠΈΡΠ΅ΡΠΊΠΈΠΉ ΡΠ»Π΅ΠΌΠ΅Π½Ρ β ΠΊΡΠ΅ΠΌΠ½ΠΈΠΉ.

ΠΠΎΡΡΠΎΠΈΠ½ΡΡΠ²Π° ΠΈ Π½Π΅Π΄ΠΎΡΡΠ°ΡΠΊΠΈ
Π ΠΎΡΠ½ΠΎΠ²Π½ΡΠΌ ΠΏΠ»ΡΡΠ°ΠΌ ΡΠΌΡΠ»ΡΡΠΈΠΈ, ΠΈΠ·Π³ΠΎΡΠΎΠ²Π»Π΅Π½Π½ΠΎΠΉ Π½Π° ΠΎΡΠ½ΠΎΠ²Π°Π½ΠΈΠΈ ΡΠΈΠ»ΠΈΠΊΠΎΠ½Π°, ΡΠ²Π»ΡΠ΅ΡΡΡ Π΅Π΅ Π±Π΅Π·ΠΎΠΏΠ°ΡΠ½ΠΎΡΡΡ Π΄Π»Ρ ΡΠ΅Π»ΠΎΠ²Π΅ΠΊΠ°. Π ΠΏΡΠΎΡΠ΅ΡΡΠ΅ ΠΈΡΠΏΠΎΠ»ΡΠ·ΠΎΠ²Π°Π½ΠΈΡ ΠΊΡΠ°ΡΠΊΠΈ Π΄Π»Ρ Π²Π½ΡΡΡΠ΅Π½Π½ΠΈΡ ΡΠ°Π±ΠΎΡ Π½Π΅Ρ Π½Π΅ΠΎΠ±Ρ ΠΎΠ΄ΠΈΠΌΠΎΡΡΠΈ ΠΏΡΠΈΠΌΠ΅Π½ΡΡΡ ΡΠ΅ΡΠΏΠΈΡΠ°ΡΠΎΡΡ ΠΈΠ»ΠΈ ΠΊΠ°ΠΊΠΈΠ΅-Π»ΠΈΠ±ΠΎ Π΄ΡΡΠ³ΠΈΠ΅ Π·Π°ΡΠΈΡΠ½ΡΠ΅ ΠΏΡΠΈΡΠΏΠΎΡΠΎΠ±Π»Π΅Π½ΠΈΡ. ΠΠΎΠΌΠ΅ΡΠ΅Π½ΠΈΠ΅, Π² ΠΊΠΎΡΠΎΡΠΎΠΌ ΠΏΡΠΎΠ²ΠΎΠ΄ΠΈΡΡΡ ΡΠ΅ΠΌΠΎΠ½Ρ, Π½Π΅ Π½ΡΠΆΠ΄Π°Π΅ΡΡΡ Π² ΠΏΠΎΡΡΠΎΡΠ½Π½ΠΎΠΌ ΠΏΡΠΈΡΠΎΠΊΠ΅ ΡΠ²Π΅ΠΆΠ΅Π³ΠΎ Π²ΠΎΠ·Π΄ΡΡ Π°.
ΠΠΌΡΠ»ΡΡΠΈΡ ΠΎΠ±Π»Π°Π΄Π°Π΅Ρ Π΅ΡΠ΅ ΡΡΠ΄ΠΎΠΌ Π΄ΠΎΡΡΠΎΠΈΠ½ΡΡΠ²:
- ΠΠΎΠ»ΡΡΠΎΠΉ ΡΠΏΠ΅ΠΊΡΡ ΡΠ²Π΅ΡΠΎΠ². Π‘ΠΈΠ»ΠΈΠΊΠΎΠ½ΠΎΠ²Π°Ρ ΠΊΡΠ°ΡΠΊΠ° Π΄Π»Ρ ΡΡΠ΅Π½ ΠΈ Π΄ΡΡΠ³ΠΈΡ ΡΠ»Π΅ΠΌΠ΅Π½ΡΠΎΠ² Π΄ΠΎΠΌΠ° Π±Π΅Π»Π°Ρ. Π ΠΏΡΠΈΠ΄Π°ΡΡ Π΅ΠΉ Π»ΡΠ±ΠΎΠΉ Π½Π΅ΠΎΠ±Ρ ΠΎΠ΄ΠΈΠΌΡΠΉ ΠΎΡΡΠ΅Π½ΠΎΠΊ ΠΌΠΎΠΆΠ½ΠΎ ΠΏΡΠΈ ΠΏΠΎΠΌΠΎΡΠΈ ΠΊΠΎΠ»Π΅ΡΠΎΠ².
- Π£Π½ΠΈΠ²Π΅ΡΡΠ°Π»ΡΠ½ΠΎΡΡΡ. ΠΠ°ΡΠ΅ΡΠΈΠ°Π» ΠΏΡΠΈΠ³ΠΎΠ΄Π΅Π½ Π΄Π»Ρ Π½Π°Π½Π΅ΡΠ΅Π½ΠΈΡ ΠΏΡΠ°ΠΊΡΠΈΡΠ΅ΡΠΊΠΈ Π½Π° Π»ΡΠ±ΡΡ ΠΏΠΎΠ²Π΅ΡΡ Π½ΠΎΡΡΡ. ΠΠ³ΠΎ ΠΌΠΎΠΆΠ½ΠΎ ΠΈΡΠΏΠΎΠ»ΡΠ·ΠΎΠ²Π°ΡΡ Π΄Π»Ρ ΠΎΠ±ΡΠ°Π±ΠΎΡΠΊΠΈ Π½Π΅ ΡΠΎΠ»ΡΠΊΠΎ Π²Π½ΡΡΡΠ΅Π½Π½ΠΈΡ ΠΏΠ΅ΡΠ΅Π³ΠΎΡΠΎΠ΄ΠΎΠΊ, Π½ΠΎ ΠΈ Π²Π½Π΅ΡΠ½ΠΈΡ ΡΠ°ΡΡΠ΅ΠΉ Π·Π΄Π°Π½ΠΈΡ.
- ΠΠΎΠ»Π³ΠΎΠ²Π΅ΡΠ½ΠΎΡΡΡ. ΠΡΠ°ΡΠΊΠ° ΡΠ°ΡΠ°Π΄Π½Π°Ρ, ΠΊΡΠ°ΡΠΊΠΈ Π΄Π»Ρ Π²Π°Π½Π½ΠΎΠΉ ΠΈΠ»ΠΈ Π΄Π»Ρ ΠΊΡΡ Π½ΠΈ, Π° ΡΠ°ΠΊΠΆΠ΅ ΡΠΌΡΠ»ΡΡΠΈΡ, Π½Π°Π½Π΅ΡΠ΅Π½Π½Π°Ρ Π½Π° ΠΏΠΎΠ²Π΅ΡΡ Π½ΠΎΡΡΠΈ Π² Π»ΡΠ±ΡΡ Π΄ΡΡΠ³ΠΈΡ ΠΏΠΎΠΌΠ΅ΡΠ΅Π½ΠΈΡΡ , Π±ΡΠ΄Π΅Ρ Π²ΡΠ³Π»ΡΠ΄Π΅ΡΡ ΠΈΠ΄Π΅Π°Π»ΡΠ½ΠΎ Π΄Π°ΠΆΠ΅ ΡΠ΅ΡΠ΅Π· 20β25 Π»Π΅Ρ ΡΠΊΡΠΏΠ»ΡΠ°ΡΠ°ΡΠΈΠΈ ΠΊΠΎΠΌΠ½Π°Ρ.
- Π£ΡΡΠΎΠΉΡΠΈΠ²ΠΎΡΡΡ ΠΊ ΠΌΠ΅Ρ Π°Π½ΠΈΡΠ΅ΡΠΊΠΈΠΌ ΠΈ Π΄ΡΡΠ³ΠΈΠΌ Π²ΠΈΠ΄Π°ΠΌ ΠΏΠΎΠ²ΡΠ΅ΠΆΠ΄Π΅Π½ΠΈΡ.
- Π£Π΄ΠΎΠ±ΡΡΠ²ΠΎ Π½Π°Π½Π΅ΡΠ΅Π½ΠΈΡ Π½Π° ΠΏΠΎΠ²Π΅ΡΡ Π½ΠΎΡΡΡ.
- ΠΡΠ°ΠΊΡΠΈΡΠ΅ΡΠΊΠΈ Π½Π΅ ΠΏΠΎΠ΄Π²Π΅ΡΠ³Π°Π΅ΡΡΡ Π·Π°Π³ΡΡΠ·Π½Π΅Π½ΠΈΡ. ΠΡΠΈ Π½Π΅ΠΎΠ±Ρ ΠΎΠ΄ΠΈΠΌΠΎΡΡΠΈ ΠΏΠΎΠΊΡΡΡΠΈΠ΅ Π»Π΅Π³ΠΊΠΎ ΠΌΠΎΠ΅ΡΡΡ.
ΠΠ΅ΡΠΌΠΎΡΡΡ Π½Π° Π½Π°Π»ΠΈΡΠΈΠ΅ Π±ΠΎΠ»ΡΡΠΎΠ³ΠΎ ΠΊΠΎΠ»ΠΈΡΠ΅ΡΡΠ²Π° Π΄ΠΎΡΡΠΎΠΈΠ½ΡΡΠ² Ρ ΡΠΈΠ»ΠΈΠΊΠΎΠ½ΠΎΠ²ΡΡ ΠΊΡΠ°ΡΠΎΠΊ Π΄Π»Ρ ΡΠ°ΡΠ°Π΄Π° ΠΈ ΠΏΠΎΠΌΠ΅ΡΠ΅Π½ΠΈΠΉ Π΅ΡΡΡ ΠΈ Π½Π΅ΡΠΊΠΎΠ»ΡΠΊΠΎ Π½Π΅Π΄ΠΎΡΡΠ°ΡΠΊΠΎΠ²:
- ΠΠ΅ ΠΏΠΎΠ΄Ρ ΠΎΠ΄ΠΈΡ Π΄Π»Ρ Π½Π°Π½Π΅ΡΠ΅Π½ΠΈΡ Π½Π° Π°ΡΠΌΠΈΡΠΎΠ²Π°Π½Π½ΡΠ΅ Π±Π΅ΡΠΎΠ½Π½ΡΠ΅ ΠΊΠΎΠ½ΡΡΡΡΠΊΡΠΈΠΈ. ΠΡΠΎ ΠΎΠ±ΡΡΠ»ΠΎΠ²Π»Π΅Π½ΠΎ ΠΎΠ΄Π½ΠΎΠΉ ΠΈΠ· Ρ Π°ΡΠ°ΠΊΡΠ΅ΡΠΈΡΡΠΈΠΊ ΡΠΌΡΠ»ΡΡΠΈΠΈ β Π³Π°Π·ΠΎΠΏΡΠΎΠ½ΠΈΡΠ°Π΅ΠΌΠΎΡΡΡΡ. ΠΠ°Π½Π½ΠΎΠ΅ ΡΠ²ΠΎΠΉΡΡΠ²ΠΎ ΡΠΏΠΎΡΠΎΠ±ΡΡΠ²ΡΠ΅Ρ ΠΏΠΎΡΠ²Π»Π΅Π½ΠΈΡ Π½Π° ΠΌΠ΅ΡΠ°Π»Π»Π΅ ΡΠΆΠ°Π²ΡΠΈΠ½Ρ. ΠΠΎ ΠΏΡΠΎΠ±Π»Π΅ΠΌΠ° ΡΡΠΏΠ΅ΡΠ½ΠΎ ΡΠ΅ΡΠ°Π΅ΡΡΡ ΠΏΡΠΎΠΈΠ·Π²ΠΎΠ΄ΠΈΡΠ΅Π»ΡΠΌΠΈ Π»Π°ΠΊΠΎΠΊΡΠ°ΡΠΎΡΠ½ΡΡ ΠΌΠ°ΡΠ΅ΡΠΈΠ°Π»ΠΎΠ²: Π² ΡΠΎΡΡΠ°Π² ΡΠΌΡΠ»ΡΡΠΈΠΈ Π΄ΠΎΠ±Π°Π²Π»ΡΡΡ ΡΠ»Π΅ΠΌΠ΅Π½ΡΡ, ΠΏΡΠ΅ΠΏΡΡΡΡΠ²ΡΡΡΠΈΠ΅ ΠΊΠΎΡΡΠΎΠ·ΠΈΠΈ.
- Π‘ΠΈΠ»ΠΈΠΊΠΎΠ½ΠΎΠ²Π°Ρ ΡΠ°ΡΠ°Π΄Π½Π°Ρ ΠΊΡΠ°ΡΠΊΠ° ΠΈΠ»ΠΈ ΡΠΌΡΠ»ΡΡΠΈΡ Π΄Π»Ρ Π²Π½ΡΡΡΠ΅Π½Π½ΠΈΡ ΡΠ°Π±ΠΎΡ Π½Π΅ ΡΠ²Π»ΡΠ΅ΡΡΡ Π±ΡΠ΄ΠΆΠ΅ΡΠ½ΡΠΌ Π²Π°ΡΠΈΠ°Π½ΡΠΎΠΌ. ΠΠ΅ ΡΡΠΎΠΈΠΌΠΎΡΡΡ Π΄ΠΎΠ²ΠΎΠ»ΡΠ½ΠΎ Π²ΡΡΠΎΠΊΠ°Ρ.
- ΠΠΎΠ»ΡΡΠΎΠΉ ΡΠ°ΡΡ ΠΎΠ΄ ΠΏΡΠΈ Π½Π°Π½Π΅ΡΠ΅Π½ΠΈΠΈ Π½Π° ΡΠ»Π΅ΠΌΠ΅Π½ΡΡ, ΠΈΠ·Π³ΠΎΡΠΎΠ²Π»Π΅Π½Π½ΡΠ΅ ΠΈΠ· Π΄ΡΠ΅Π²Π΅ΡΠΈΠ½Ρ.
ΠΠ°ΡΠ΅ΡΡΠ²Π°, ΠΏΡΠΎΡΠ²Π»ΡΠ΅ΠΌΡΠ΅ Π² ΠΏΡΠΎΡΠ΅ΡΡΠ΅ ΡΠΊΡΠΏΠ»ΡΠ°ΡΠ°ΡΠΈΠΈ
ΠΡΠ°ΡΠΊΠ° Π½Π° ΡΠΈΠ»ΠΈΠΊΠΎΠ½ΠΎΠ²ΠΎΠΉ ΠΎΡΠ½ΠΎΠ²Π΅ ΠΎΠ±Π»Π°Π΄Π°Π΅Ρ ΡΠ»Π΅Π΄ΡΡΡΠΈΠΌΠΈ ΡΠΊΡΠΏΠ»ΡΠ°ΡΠ°ΡΠΈΠΎΠ½Π½ΡΠΌΠΈ Ρ Π°ΡΠ°ΠΊΡΠ΅ΡΠΈΡΡΠΈΠΊΠ°ΠΌΠΈ:
- ΠΠ»Π°Π³ΠΎΡΡΠΎΠΉΠΊΠΎΡΡΡ. ΠΠΎΠ·Π²ΠΎΠ»ΡΠ΅Ρ ΠΈΡΠΏΠΎΠ»ΡΠ·ΠΎΠ²Π°ΡΡ ΡΠΈΠ»ΠΈΠΊΠΎΠ½ΠΎΠ²ΡΡ ΠΊΡΠ°ΡΠΊΡ Π΄Π»Ρ Π²Π°Π½Π½ΠΎΠΉ ΠΊΠΎΠΌΠ½Π°ΡΡ, Π΄Π»Ρ ΡΠ°ΡΠ°Π΄Π½ΡΡ ΡΠ°Π±ΠΎΡ. ΠΡΠΎ ΡΠ²ΠΎΠΉΡΡΠ²ΠΎ ΠΏΡΠΈΡΡΡΠ΅ ΡΠΌΠΎΠ»Π°ΠΌ, ΠΏΠΎΡΡΠΎΠΌΡ Π² ΡΠΎΡΡΠ°Π² ΡΠΌΡΠ»ΡΡΠΈΠΈ Π½Π΅ Π΄ΠΎΠ±Π°Π²Π»ΡΠ΅ΡΡΡ Π½ΠΈΠΊΠ°ΠΊΠΈΡ Π΄ΠΎΠΏΠΎΠ»Π½ΠΈΡΠ΅Π»ΡΠ½ΡΡ ΠΊΠΎΠΌΠΏΠΎΠ½Π΅Π½ΡΠΎΠ².
- ΠΠ°ΡΠΎΠΏΡΠΎΠ½ΠΈΡΠ°Π΅ΠΌΠΎΡΡΡ. Π‘Π²ΠΎΠΉΡΡΠ²ΠΎ ΠΏΡΠΎΡΠ²Π»ΡΠ΅ΡΡΡ ΠΏΡΠΈ Π½Π°Π½Π΅ΡΠ΅Π½ΠΈΠΈ ΡΠΎΡΡΠ°Π²Π° ΠΏΠΎ ΡΡΡΠΊΠ°ΡΡΡΠΊΠ΅ ΠΏΡΠΈ Π½Π°ΡΡΠΆΠ½ΡΡ ΠΈΠ»ΠΈ Π²Π½ΡΡΡΠ΅Π½Π½ΠΈΡ ΡΠ°Π±ΠΎΡΠ°Ρ . ΠΠ½ΠΎ ΠΏΠΎΠ·Π²ΠΎΠ»ΡΠ΅Ρ ΡΠ»ΠΎΡ ΠΊΡΠ°ΡΠΊΠΈ ΠΏΡΠΎΠ½ΠΈΠΊΠ°ΡΡ Π² ΡΡΡΡΠΊΡΡΡΡ ΡΠ΅ΡΠ½ΠΎΠ²ΠΎΠΉ ΠΏΠΎΠ²Π΅ΡΡ Π½ΠΎΡΡΠΈ, ΡΡΠΎ ΠΎΠ±Π΅ΡΠΏΠ΅ΡΠΈΠ²Π°Π΅Ρ Π²ΡΡΠΎΠΊΡΡ ΡΡΠ΅ΠΏΠ΅Π½Ρ ΡΡΠ΅ΠΏΠ»Π΅Π½ΠΈΡ. Π ΠΏΡΠΎΡΠ΅ΡΡΠ΅ ΡΠΊΡΠΏΠ»ΡΠ°ΡΠ°ΡΠΈΠΈ ΡΠΌΡΠ»ΡΡΠΈΡ Π½Π΅ Π±ΡΠ΄Π΅Ρ ΠΎΡΡΠ»Π°ΠΈΠ²Π°ΡΡΡΡ.
- Π’Π΅ΡΠΌΠΎΡΡΠΎΠΉΠΊΠΎΡΡΡ. ΠΠ°ΡΠ΅ΡΠΈΠ°Π» Π½Π΅ ΠΌΠ΅Π½ΡΠ΅Ρ ΡΠ²ΠΎΠ΅Π³ΠΎ ΡΠΎΡΡΠΎΡΠ½ΠΈΡ ΠΏΡΠΈ Π½Π°Π³ΡΠ΅Π²Π°Π½ΠΈΠΈ, ΡΠΎ Π΅ΡΡΡ ΠΎΠ½ Π½Π΅ ΡΠ°Π·ΠΌΡΠ³ΡΠ°Π΅ΡΡΡ ΠΈ Π½Π΅ ΡΡΠ΅ΡΠΊΠ°Π΅ΡΡΡ Π² ΠΏΠΎΡΠ»Π΅Π΄ΡΡΡΠ΅ΠΌ.
- ΠΠ»Π°ΡΡΠΈΡΠ½ΠΎΡΡΡ. Π‘ΠΈΠ»ΠΈΠΊΠΎΠ½ΠΎΠ²ΠΎΠ΅ ΠΏΠΎΠΊΡΡΡΠΈΠ΅ ΡΠΏΠΎΡΠΎΠ±Π½ΠΎ ΡΠ΄Π΅Π»Π°ΡΡ ΡΠ΅ΡΡΠ°Π²ΡΡ ΠΏΠΎΠ²Π΅ΡΡ Π½ΠΎΡΡΡ Π³Π»Π°Π΄ΠΊΠΎΠΉ ΠΈ Π·Π°ΠΏΠΎΠ»Π½ΠΈΡΡ ΡΠΎΠ±ΠΎΠΉ ΡΡΠ΅ΡΠΈΠ½Ρ, ΡΠΈΡΠΈΠ½Π° ΠΊΠΎΡΠΎΡΡΡ ΠΌΠΎΠΆΠ΅Ρ Π΄ΠΎΡΡΠΈΠ³Π°ΡΡ Π½Π΅ΡΠΊΠΎΠ»ΡΠΊΠΈΡ ΠΌΠΈΠ»Π»ΠΈΠΌΠ΅ΡΡΠΎΠ².
- ΠΡΡΠΎΠΊΠΈΠ΅ ΡΡΡΠ΅ΡΠΈΡΠ΅ΡΠΊΠΈΠ΅ ΡΠ²ΠΎΠΉΡΡΠ²Π°. ΠΠΌΡΠ»ΡΡΠΈΡ ΠΎΠ±ΡΠ°Π·ΡΠ΅Ρ ΠΏΡΠΈΠ²Π»Π΅ΠΊΠ°ΡΠ΅Π»ΡΠ½ΡΡ ΠΌΠ°ΡΠΎΠ²ΡΡ ΠΏΠΎΠ²Π΅ΡΡ Π½ΠΎΡΡΡ.
- Π£ΡΡΠΎΠΉΡΠΈΠ²ΠΎΡΡΡ ΠΊ ΡΠ»ΡΡΡΠ°ΡΠΈΠΎΠ»Π΅ΡΠΎΠ²ΠΎΠΌΡ ΠΈΠ·Π»ΡΡΠ΅Π½ΠΈΡ. ΠΠ΅ΡΠ΅Π³ΠΎΡΠΎΠ΄ΠΊΠ° ΠΈΠ»ΠΈ Π΄ΡΡΠ³Π°Ρ ΠΊΠΎΠ½ΡΡΡΡΠΊΡΠΈΡ, ΠΏΠΎΠΊΡΡΡΠ°Ρ ΡΠΈΠ»ΠΈΠΊΠΎΠ½ΠΎΠ²ΠΎΠΉ ΡΠΌΡΠ»ΡΡΠΈΠ΅ΠΉ, Π½Π΅ ΡΠ΅ΡΡΠ΅Ρ ΡΠ²Π΅Ρ ΠΏΠΎΠ΄ Π²ΠΎΠ·Π΄Π΅ΠΉΡΡΠ²ΠΈΠ΅ΠΌ ΡΠΎΠ»Π½ΡΠ°.
- Π‘ΡΠΎΠΉΠΊΠΎΡΡΡ ΠΊ ΡΠ°Π·Π²ΠΈΡΠΈΡ ΠΌΠΈΠΊΡΠΎΠΎΡΠ³Π°Π½ΠΈΠ·ΠΌΠΎΠ². ΠΠ° ΡΡΠ΅Π½Π°Ρ , ΠΏΠΎΡΠΎΠ»ΠΊΠ΅ ΠΈ Π΄ΡΡΠ³ΠΈΡ ΠΏΠΎΠ²Π΅ΡΡ Π½ΠΎΡΡΡΡ , Π½Π° ΠΊΠΎΡΠΎΡΡΠ΅ Π½Π°Π½Π΅ΡΠ΅Π½ ΡΠ»ΠΎΠΉ ΡΠΈΠ»ΠΈΠΊΠΎΠ½ΠΎΠ²ΠΎΠΉ ΠΊΡΠ°ΡΠΊΠΈ, Π½ΠΈΠΊΠΎΠ³Π΄Π° Π½Π΅ ΠΏΠΎΡΠ²ΠΈΡΡΡ Π³ΡΠΈΠ±ΠΎΠΊ ΠΈΠ»ΠΈ ΠΏΠ»Π΅ΡΠ΅Π½Ρ.
Π‘ΠΎΡΡΠ°Π²Ρ Π΄Π»Ρ Π½Π°ΡΡΠΆΠ½ΡΡ ΡΠ°Π±ΠΎΡ
ΠΡΠ°ΡΠΊΠ° Π΄Π»Ρ ΡΠ°ΡΠ°Π΄Π° ΡΠΈΠ»ΠΈΠΊΠΎΠ½ΠΎΠ²Π°Ρ ΡΡΠ»ΠΎΠ²Π½ΠΎ ΠΏΠΎΠ΄ΡΠ°Π·Π΄Π΅Π»ΡΠ΅ΡΡΡ Π½Π° Π΄Π²Π΅ ΠΎΡΠ½ΠΎΠ²Π½ΡΠ΅ Π³ΡΡΠΏΠΏΡ: Π³ΡΡΠ½ΡΠΎΠ²ΠΊΠ° ΠΈ Π·Π°ΡΠΈΡΠ½Π°Ρ ΡΠΌΡΠ»ΡΡΠΈΡ. ΠΠ±Π΅ ΠΊΠ°ΡΠ΅Π³ΠΎΡΠΈΠΈ ΠΎΠ±Π»Π°Π΄Π°ΡΡ ΡΡ ΠΎΠΆΠΈΠΌΠΈ ΡΠ²ΠΎΠΉΡΡΠ²Π°ΠΌΠΈ, Π³Π»Π°Π²Π½ΠΎΠ΅ ΠΈΠ· ΠΊΠΎΡΠΎΡΡΡ β ΡΠΎΠ·Π΄Π°Π½ΠΈΠ΅ Π²Π»Π°Π³ΠΎΡΡΠΎΠΉΠΊΠΎΠ³ΠΎ ΠΏΠΎΠΊΡΡΡΠΈΡ.
ΠΠ΅ΡΠ²Π°Ρ Π³ΡΡΠΏΠΏΠ° ΠΊΡΠ°ΡΠΎΠΊ ΡΠΎΠ·Π΄Π°Π΅Ρ ΠΏΡΠΎΡΠ½ΡΡ ΠΎΡΠ½ΠΎΠ²Ρ Π΄Π»Ρ Π²ΡΠΏΠΎΠ»Π½Π΅Π½ΠΈΡ ΠΏΠΎΡΠ»Π΅Π΄ΡΡΡΠ΅ΠΉ Π΄Π΅ΠΊΠΎΡΠ°ΡΠΈΠ²Π½ΠΎΠΉ ΠΎΡΠ΄Π΅Π»ΠΊΠΈ ΠΏΠΎΠ²Π΅ΡΡ Π½ΠΎΡΡΠΈ. ΠΠ½Π° Π΄Π΅Π»Π°Π΅Ρ ΠΎΡΠ½ΠΎΠ²Ρ Π±ΠΎΠ»Π΅Π΅ ΠΊΡΠ΅ΠΏΠΊΠΎΠΉ ΠΈ Π½Π΅Π²ΠΎΡΠΏΡΠΈΠΈΠΌΡΠΈΠ²ΠΎΠΉ ΠΊ Π²ΠΎΠ·Π΄Π΅ΠΉΡΡΠ²ΠΈΡ Π½Π΅Π³Π°ΡΠΈΠ²Π½ΡΡ ΡΠ°ΠΊΡΠΎΡΠΎΠ².
ΠΡΠΎΡΠ°Ρ Π³ΡΡΠΏΠΏΠ° Π½Π°Π½ΠΎΡΠΈΡΡΡ Π½Π° ΠΎΡΡΡΠΊΠ°ΡΡΡΠ΅Π½Π½ΡΡ, ΡΡΠ΅ΠΏΠ»Π΅Π½Π½ΡΡ ΠΈΠ»ΠΈ ΠΎΠ±Π»ΠΈΡΠΎΠ²Π°Π½Π½ΡΡ ΠΏΠΎΠ²Π΅ΡΡ Π½ΠΎΡΡΡ Π² ΠΊΠ°ΡΠ΅ΡΡΠ²Π΅ ΡΠΈΠ½ΠΈΡΠ½ΠΎΠΉ ΠΎΡΠ΄Π΅Π»ΠΊΠΈ. ΠΠ½Π° ΡΠΎΠ·Π΄Π°Π΅Ρ Π·Π°ΡΠΈΡΠ½ΡΠΉ ΡΠ»ΠΎΠΉ.
ΠΠ½ΡΡΡΠ΅Π½Π½ΡΡ ΠΎΡΠ΄Π΅Π»ΠΊΠ° ΠΏΠΎΠΌΠ΅ΡΠ΅Π½ΠΈΠΉ
ΠΡΠΈ ΠΏΡΠΎΠ²Π΅Π΄Π΅Π½ΠΈΠΈ ΡΠΈΠ½ΠΈΡΠ½ΡΡ ΠΎΡΠ΄Π΅Π»ΠΎΡΠ½ΡΡ ΡΠ°Π±ΠΎΡ Π²Π½ΡΡΡΠΈ ΠΏΠΎΠΌΠ΅ΡΠ΅Π½ΠΈΠΉ ΠΈΡΠΏΠΎΠ»ΡΠ·ΡΠ΅ΡΡΡ ΠΏΡΠ΅Π΄Π½Π°Π·Π½Π°ΡΠ΅Π½Π½Π°Ρ Π΄Π»Ρ ΡΡΠΎΠ³ΠΎ ΠΊΡΠ°ΡΠΊΠ° Π½Π° ΠΎΡΠ½ΠΎΠ²Π΅ ΡΠΈΠ»ΠΈΠΊΠΎΠ½Π°. ΠΠ½Π° ΠΎΠ±Π»Π°Π΄Π°Π΅Ρ Π²ΡΡΠΎΠΊΠΈΠΌΠΈ ΡΠΊΡΠΏΠ»ΡΠ°ΡΠ°ΡΠΈΠΎΠ½Π½ΡΠΌΠΈ ΠΈ Π΄Π΅ΠΊΠΎΡΠ°ΡΠΈΠ²Π½ΡΠΌΠΈ ΠΊΠ°ΡΠ΅ΡΡΠ²Π°ΠΌΠΈ. ΠΠ°ΠΏΡΠΈΠΌΠ΅Ρ, ΡΠΈΠ»ΠΈΠΊΠΎΠ½ΠΎΠ²Π°Ρ ΠΊΡΠ°ΡΠΊΠ° Π΄Π»Ρ ΠΏΠΎΡΠΎΠ»ΠΊΠ° ΠΏΠΎΠ·Π²ΠΎΠ»ΡΠ΅Ρ ΡΠΎΠ·Π΄Π°ΡΡ ΠΏΠΎΠΊΡΡΡΠΈΠ΅, ΠΊΠΎΡΠΎΡΠΎΠ΅ Π½Π΅ Π±ΡΠ΄Π΅Ρ ΠΏΠ°ΡΠΊΠ°ΡΡΡΡ. Π’Π°ΠΊΠ°Ρ ΠΏΠΎΠ²Π΅ΡΡ Π½ΠΎΡΡΡ Π½Π΅ ΡΡΠ΅Π±ΡΠ΅Ρ ΠΎΡΠΎΠ±ΠΎΠ³ΠΎ ΡΡ ΠΎΠ΄Π°, Π° Π·Π½Π°ΡΠΈΡ, ΠΎΠ½Π° ΠΏΡΠ°ΠΊΡΠΈΡΠ½Π° ΠΈ ΡΡΠ½ΠΊΡΠΈΠΎΠ½Π°Π»ΡΠ½Π°.
ΠΠ°Π½Π½Π°Ρ ΠΈΠ»ΠΈ ΠΊΡΡ Π½Ρ ΡΡΠ΅Π±ΡΡΡ ΠΎΡΠΎΠ±ΠΎΠΉ ΠΎΡΠ΄Π΅Π»ΠΊΠΈ. ΠΡΠΈ ΠΏΠΎΠΌΠ΅ΡΠ΅Π½ΠΈΡ ΠΏΠΎΠ΄Π²Π΅ΡΠΆΠ΅Π½Ρ ΡΡΠΈΠ»Π΅Π½Π½ΠΎΠΌΡ Π²ΠΎΠ·Π΄Π΅ΠΉΡΡΠ²ΠΈΡ Π²Π»Π°Π³ΠΈ ΠΈ Π³ΡΡΠ·ΠΈ. Π‘ΠΈΠ»ΠΈΠΊΠΎΠ½ΠΎΠ²Π°Ρ ΡΠΌΡΠ»ΡΡΠΈΡ ΡΠΏΠΎΡΠΎΠ±Π½Π° ΡΠ΅ΡΠΈΡΡ ΠΏΡΠΎΠ±Π»Π΅ΠΌΡ Π΄Π΅ΠΊΠΎΡΠΈΡΠΎΠ²Π°Π½ΠΈΡ Π΄Π°ΠΆΠ΅ Π² Π½ΠΈΡ . ΠΠ΅ ΠΎΡΠΎΠ±ΡΠ΅ ΠΊΠ°ΡΠ΅ΡΡΠ²Π°: Π²Π»Π°Π³ΠΎΡΡΠΎΠΉΠΊΠΎΡΡΡ ΠΈ ΡΠ°ΠΌΠΎΠΎΡΠΈΡΠ΅Π½ΠΈΠ΅. ΠΠ½ΠΈ ΠΏΠΎΠ·Π²ΠΎΠ»ΡΡΡ ΡΠΎΠ·Π΄Π°ΡΡ ΠΏΠΎΠΊΡΡΡΠΈΠ΅, ΠΊΠΎΡΠΎΡΠΎΠ΅ ΠΏΡΠΎΡΠ»ΡΠΆΠΈΡ Π½Π΅ ΠΌΠ΅Π½Π΅Π΅ 20 Π»Π΅Ρ ΠΈ Π½Π°Π΄Π΅ΠΆΠ½ΠΎ Π·Π°ΡΠΈΡΠΈΡ ΡΡΠ΅Π½Ρ ΠΈΠ»ΠΈ ΠΏΠΎΡΠΎΠ»ΠΎΠΊ ΠΎΡ ΠΏΠ°ΡΠ°, Π³Π°Π·Π° ΠΈ Π΄ΡΡΠ³ΠΈΡ Π½Π΅Π³Π°ΡΠΈΠ²Π½ΡΡ ΡΠ°ΠΊΡΠΎΡΠΎΠ².
Π Π΅ΠΊΠΎΠΌΠ΅Π½Π΄Π°ΡΠΈΠΈ ΠΈ ΠΎΡΠΎΠ±Π΅Π½Π½ΠΎΡΡΠΈ ΡΠ°Π±ΠΎΡΡ Ρ ΡΠΈΠ»ΠΈΠΊΠΎΠ½ΠΎΠ²ΠΎΠΉ ΡΠΌΡΠ»ΡΡΠΈΠ΅ΠΉ
Π‘ΡΡΠ΅ΡΡΠ²ΡΠ΅Ρ Π½Π΅ΡΠΊΠΎΠ»ΡΠΊΠΎ ΠΏΡΠΎΡΡΡΡ ΠΏΡΠ°Π²ΠΈΠ», ΠΊΠΎΡΠΎΡΡΠ΅ ΡΠ΅ΠΊΠΎΠΌΠ΅Π½Π΄ΡΠ΅ΡΡΡ ΡΠΎΠ±Π»ΡΠ΄Π°ΡΡ ΠΏΡΠΈ ΠΏΠΎΠΊΡΠΏΠΊΠ΅ ΠΈ ΠΏΠΎΡΠ»Π΅Π΄ΡΡΡΠ΅ΠΉ ΡΠ°Π±ΠΎΡΠ΅ Ρ ΡΠΈΠ»ΠΈΠΊΠΎΠ½ΠΎΠ²ΠΎΠΉ ΠΊΡΠ°ΡΠΊΠΎΠΉ:
- ΠΠ° ΡΡΠ½ΠΊΠ΅ ΡΡΡΠΎΠΈΡΠ΅Π»ΡΠ½ΡΡ ΠΌΠ°ΡΠ΅ΡΠΈΠ°Π»ΠΎΠ² ΠΏΡΠ΅Π΄ΡΡΠ°Π²Π»Π΅Π½Ρ ΡΠΌΡΠ»ΡΡΠΈΠΈ Π½Π° ΠΎΡΠ½ΠΎΠ²Π΅ ΡΠΈΠ»ΠΈΠΊΠΎΠ½Π° ΡΠ°Π·Π½ΡΡ ΠΏΡΠΎΠΈΠ·Π²ΠΎΠ΄ΠΈΡΠ΅Π»Π΅ΠΉ, Π² ΡΠΎΠΌ ΡΠΈΡΠ»Π΅ ΠΈ Π½Π΅Π΄ΠΎΠ±ΡΠΎΡΠΎΠ²Π΅ΡΡΠ½ΡΡ . ΠΠΎΡΡΠΎΠΌΡ ΠΏΡΠΈΠΎΠ±ΡΠ΅ΡΠ°Ρ ΠΈΡ Π½ΡΠΆΠ½ΠΎ ΡΠΈΡΠ°ΡΡ ΡΠΎΡΡΠ°Π², Π° ΡΠ°ΠΊΠΆΠ΅ ΠΎΠ±ΡΠ°ΡΠ°ΡΡ Π²Π½ΠΈΠΌΠ°Π½ΠΈΠ΅ Π½Π° ΡΡΠΎΠΈΠΌΠΎΡΡΡ. Π§Π΅ΠΌ ΠΌΠ΅Π½ΡΡΠ΅ ΡΠΎΠ΄Π΅ΡΠΆΠ°Π½ΠΈΠ΅ Ρ ΠΈΠΌΠΈΡΠ΅ΡΠΊΠΈΡ Π²Π΅ΡΠ΅ΡΡΠ² Π² ΠΌΠ°ΡΠ΅ΡΠΈΠ°Π»Π΅, ΡΠ΅ΠΌ ΠΎΠ½ ΠΊΠ°ΡΠ΅ΡΡΠ²Π΅Π½Π½Π΅ΠΉ, Π° ΡΠΎΠΎΡΠ²Π΅ΡΡΡΠ²Π΅Π½Π½ΠΎ ΠΈ Π΄ΠΎΡΠΎΠΆΠ΅.
- ΠΠ°Π½ΠΎΡΠΈΡΡ ΠΏΠΎΠΊΡΡΡΠΈΠ΅ ΠΌΠΎΠΆΠ½ΠΎ ΡΠΎΠ»ΡΠΊΠΎ ΠΏΡΠΈ ΠΏΠ»ΡΡΠΎΠ²ΠΎΠΉ ΡΠ΅ΠΌΠΏΠ΅ΡΠ°ΡΡΡΠ΅.
- ΠΠ΅ ΡΡΠΎΠΈΡ ΠΈΡΠΏΠΎΠ»ΡΠ·ΠΎΠ²Π°ΡΡ Π² ΡΠ°Π±ΠΎΡΠ΅ ΡΠΌΡΠ»ΡΡΠΈΡ, ΡΡΠΎΠΊ Π³ΠΎΠ΄Π½ΠΎΡΡΠΈ ΠΊΠΎΡΠΎΡΠΎΠΉ ΠΈΡΡΠ΅ΠΊ.
- ΠΠ»Ρ ΡΠ°Π±ΠΎΡΡ ΠΌΠΎΠΆΠ½ΠΎ ΠΏΡΠΈΠΎΠ±ΡΠ΅ΡΡΠΈ ΠΏΡΠ»ΡΠ²Π΅ΡΠΈΠ·Π°ΡΠΎΡ. ΠΠΎ ΡΠ°ΠΊΠΎΠΉ ΡΠ°Π³ ΠΏΡΠΈΠ²Π΅Π΄Π΅Ρ ΠΊ Π»ΠΈΡΠ½ΠΈΠΌ ΠΌΠ°ΡΠ΅ΡΠΈΠ°Π»ΡΠ½ΡΠΌ Π·Π°ΡΡΠ°ΡΠ°ΠΌ. ΠΠ°Π½ΠΎΡΠΈΡΡ ΠΊΡΠ°ΡΠΊΡ Π½Π° ΠΏΠΎΠ²Π΅ΡΡ Π½ΠΎΡΡΠΈ ΠΌΠΎΠΆΠ½ΠΎ Π²Π°Π»ΠΈΠΊΠΎΠΌ. ΠΠ΄ΠΈΠ½ΡΡΠ²Π΅Π½Π½Π°Ρ ΡΠ΅ΠΊΠΎΠΌΠ΅Π½Π΄Π°ΡΠΈΡ: Π²ΠΎΡΡ ΠΈΠ½ΡΡΡΡΠΌΠ΅Π½ΡΠ° Π΄ΠΎΠ»ΠΆΠ΅Π½ Π±ΡΡΡ ΡΡΠ΅Π΄Π½Π΅ΠΉ Π΄Π»ΠΈΠ½Ρ. ΠΡΠΎ ΠΏΠΎΠ·Π²ΠΎΠ»ΠΈΡ ΡΠΌΠ΅Π½ΡΡΠΈΡΡ ΡΠ°ΡΡ ΠΎΠ΄ ΡΠΌΡΠ»ΡΡΠΈΠΈ.
- ΠΠ΅ ΡΠ΅ΠΊΠΎΠΌΠ΅Π½Π΄ΡΠ΅ΡΡΡ ΠΎΠΊΡΠ°ΡΠΈΠ²Π°ΡΡ Π²Π»Π°ΠΆΠ½ΡΠ΅ ΠΊΠΎΠ½ΡΡΡΡΠΊΡΠΈΠΈ.
ΠΠ΅ΡΠ΅Π΄ ΠΏΠΎΠΊΡΠ°ΡΠΊΠΎΠΉ Π΄Π΅ΠΊΠΎΡΠΈΡΡΠ΅ΠΌΡΡ ΠΏΠΎΠ²Π΅ΡΡ Π½ΠΎΡΡΡ Π½Π΅ΠΎΠ±Ρ ΠΎΠ΄ΠΈΠΌΠΎ ΠΏΠΎΠ΄Π³ΠΎΡΠΎΠ²ΠΈΡΡ. ΠΠ΅ΡΠ²ΡΠΌ ΡΡΠ°ΠΏΠΎΠΌ ΡΡΠ°Π½Π΅Ρ ΡΠ΄Π°Π»Π΅Π½ΠΈΠ΅ ΡΠΎ ΡΡΠ΅Π½ ΠΈ ΠΏΠΎΡΠΎΠ»ΠΊΠ° Π³ΡΡΠ·ΠΈ, ΡΠ»Π΅Π΄ΠΎΠ² ΠΆΠΈΡΠ° ΠΈ ΠΏΡΠ»ΠΈ. ΠΠ΅Π·Π½Π°ΡΠΈΡΠ΅Π»ΡΠ½ΡΠ΅ ΡΠ΅ΡΠΎΡ ΠΎΠ²Π°ΡΠΎΡΡΠΈ ΠΈ Π½Π΅Π±ΠΎΠ»ΡΡΠΈΠ΅ ΡΡΠ΅ΡΠΈΠ½Ρ Π½Π΅ ΡΡΠ°Π½ΡΡ ΠΏΠΎΠΌΠ΅Ρ ΠΎΠΉ Π΄Π»Ρ Π½Π°Π½Π΅ΡΠ΅Π½ΠΈΡ ΡΠΈΠ»ΠΈΠΊΠΎΠ½ΠΎΠ²ΠΎΠ³ΠΎ ΠΌΠ°ΡΠ΅ΡΠΈΠ°Π»Π°. Π Π²ΠΎΡ ΡΡΡΠ΅ΡΡΠ²Π΅Π½Π½ΡΠ΅ Π½Π΅ΡΠΎΠ²Π½ΠΎΡΡΠΈ ΠΈ Π΄Π΅ΡΠ΅ΠΊΡΡ ΡΡΠ΅Π½Ρ Π½ΡΠΆΠ½ΠΎ ΡΠ΄Π°Π»ΠΈΡΡ. ΠΡΠΈΠΌΠ΅Π½Π΅Π½ΠΈΠ΅ ΡΠΌΡΠ»ΡΡΠΈΠΈ ΠΈΡ Π½Π΅ ΡΡΡΡΠ°Π½ΠΈΡ, Π° ΡΠΎΠ»ΡΠΊΠΎ ΡΡΡΠ³ΡΠ±ΠΈΡ ΡΠΈΡΡΠ°ΡΠΈΡ.
ΠΠ° 8 ΡΠ°ΡΠΎΠ² Π΄ΠΎ Π½Π°ΡΠ°Π»Π° ΠΎΠΊΡΠ°ΡΠΈΠ²Π°Π½ΠΈΡ ΠΏΠ΅ΡΠ΅Π³ΠΎΡΠΎΠ΄ΠΎΠΊ ΠΈ ΠΊΠΎΠ½ΡΡΡΡΠΊΡΠΈΠΉ ΠΈΡ Π½Π΅ΠΎΠ±Ρ ΠΎΠ΄ΠΈΠΌΠΎ ΠΏΠΎΠΊΡΡΡΡ Π³ΡΡΠ½ΡΠΎΠ²ΠΊΠΎΠΉ. ΠΡΠΎ ΡΠ»ΡΡΡΠΈΡ ΡΡΠ΅ΠΏΠ»Π΅Π½ΠΈΠ΅ ΡΠΌΡΠ»ΡΡΠΈΠΈ Ρ ΠΏΠΎΠ²Π΅ΡΡ Π½ΠΎΡΡΡΡ ΠΈ ΡΠΎΠ·Π΄Π°ΡΡ Π΄ΠΎΠΏΠΎΠ»Π½ΠΈΡΠ΅Π»ΡΠ½ΡΠΉ Π·Π°ΡΠΈΡΠ½ΡΠΉ ΡΠ»ΠΎΠΉ.
ΠΠ°ΡΠ΅ΡΡΠ²Π΅Π½Π½Π°Ρ ΠΊΡΠ°ΡΠΊΠ° ΠΎΠ±ΡΡΠ½ΠΎ Π½Π°Π½ΠΎΡΠΈΡΡΡ Π΅Π΄ΠΈΠ½ΠΎΠΆΠ΄Ρ. ΠΠ½ΠΎΠ³Π΄Π° Π½Π΅ΠΎΠ±Ρ ΠΎΠ΄ΠΈΠΌΠ° ΠΏΠΎΠ²ΡΠΎΡΠ½Π°Ρ ΠΎΠ±ΡΠ°Π±ΠΎΡΠΊΠ° ΠΏΠΎΠ²Π΅ΡΡ Π½ΠΎΡΡΠΈ. ΠΠ΅ ΠΌΠΎΠΆΠ½ΠΎ ΠΏΡΠΎΠ²ΠΎΠ΄ΠΈΡΡ ΡΠΎΠ»ΡΠΊΠΎ ΠΏΠΎΡΠ»Π΅ ΠΏΠΎΠ»Π½ΠΎΠ³ΠΎ Π²ΡΡΡΡ Π°Π½ΠΈΡ ΠΏΡΠ΅Π΄ΡΠ΄ΡΡΠ΅Π³ΠΎ ΡΠ»ΠΎΡ.
ΠΡΠ°ΡΠΊΠ°, ΠΈΠ·Π³ΠΎΡΠΎΠ²Π»Π΅Π½Π½Π°Ρ Π½Π° ΠΎΡΠ½ΠΎΠ²Π°Π½ΠΈΠΈ ΡΠΈΠ»ΠΈΠΊΠΎΠ½ΠΎΠ²ΡΡ ΡΠΌΠΎΠ», ΡΠ²Π»ΡΠ΅ΡΡΡ ΠΈΠ΄Π΅Π°Π»ΡΠ½ΡΠΌ ΠΌΠ°ΡΠ΅ΡΠΈΠ°Π»ΠΎΠΌ Π΄Π»Ρ ΠΎΠ±ΡΠ°Π±ΠΎΡΠΊΠΈ Π²Π½ΡΡΡΠ΅Π½Π½ΠΈΡ ΠΈ Π²Π½Π΅ΡΠ½ΠΈΡ ΠΊΠΎΠ½ΡΡΡΡΠΊΡΠΈΠΉ Π΄ΠΎΠΌΠ°. ΠΠ½Π° ΡΠ½ΠΈΠ²Π΅ΡΡΠ°Π»ΡΠ½Π° ΠΈ ΡΠ΄ΠΎΠ±Π½Π° Π² ΠΏΡΠΈΠΌΠ΅Π½Π΅Π½ΠΈΠΈ. ΠΠΊΡΠ°ΡΠΈΠ²Π°Π½ΠΈΠ΅ Π½Π΅ ΡΡΠ΅Π±ΡΠ΅Ρ Π½Π°Π»ΠΈΡΠΈΡ ΠΎΡΠΎΠ±ΡΡ Π½Π°Π²ΡΠΊΠΎΠ². Π ΡΠΎΠ±Π»ΡΠ΄Π΅Π½ΠΈΠ΅ ΠΏΡΠΎΡΡΡΡ ΠΏΡΠ°Π²ΠΈΠ» ΠΈ ΡΠ΅ΠΊΠΎΠΌΠ΅Π½Π΄Π°ΡΠΈΠΉ ΠΏΠΎΠ·Π²ΠΎΠ»ΠΈΡ ΡΠΎΠ·Π΄Π°ΡΡ ΡΠΎΠ²Π½ΠΎΠ΅ ΠΈ ΠΊΠ°ΡΠ΅ΡΡΠ²Π΅Π½Π½ΠΎΠ΅ ΠΏΠΎΠΊΡΡΡΠΈΠ΅!
kraskaton.ru
Π§ΡΠΎ ΡΠ°ΠΊΠΎΠ΅ ΡΠΈΠ»ΠΈΠΊΠΎΠ½ΠΎΠ²Π°Ρ ΡΠ°ΡΠ°Π΄Π½Π°Ρ ΠΊΡΠ°ΡΠΊΠ°? ΠΠ°ΠΊ ΡΡ Π°ΠΆΠΈΠ²Π°ΡΡ Π·Π° ΠΏΠΎΠ²Π΅ΡΡ Π½ΠΎΡΡΡΡ?
ΠΠ΄Π½ΠΈΠΌ ΠΈΠ· ΡΠ°ΠΌΡΡ ΠΏΠΎΠΏΡΠ»ΡΡΠ½ΡΡ ΠΌΠ°ΡΠ΅ΡΠΈΠ°Π»ΠΎΠ² Π΄Π»Ρ Π½Π°ΡΡΠΆΠ½ΠΎΠΉ ΠΎΡΠ΄Π΅Π»ΠΊΠΈ ΡΠ²Π»ΡΠ΅ΡΡΡΒ ΡΠΈΠ»ΠΈΠΊΠΎΠ½ΠΎΠ²Π°ΡΒ ΡΠ°ΡΠ°Π΄Π½Π°ΡΒ ΠΊΡΠ°ΡΠΊΠ°. ΠΡΠΈ ΡΠΎΡΡΠ°Π²Ρ ΠΏΠΎΡΠ²ΠΈΠ»ΠΈΡΡ Π½Π° ΡΡΠ½ΠΊΠ΅ ΠΏΠΎΠ·ΠΆΠ΅ Π΄ΡΡΠ³ΠΈΡ ΡΠ°Π·Π½ΠΎΠ²ΠΈΠ΄Π½ΠΎΡΡΠ΅ΠΉ β Π°ΠΊΡΠΈΠ»ΠΎΠ²ΡΡ ΠΈ ΡΠΈΠ»ΠΈΠΊΠ°ΡΠ½ΡΡ ΠΊΡΠ°ΡΠΎΠΊ, Π½ΠΎ Π±ΡΡΡΡΠΎ Π·Π°Π²ΠΎΠ΅Π²Π°Π»ΠΈ ΠΏΠΎΠΏΡΠ»ΡΡΠ½ΠΎΡΡΡ Π±Π»Π°Π³ΠΎΠ΄Π°ΡΡ ΠΎΡΠ»ΠΈΡΠ½ΡΠΌ ΡΠΊΡΠΏΠ»ΡΠ°ΡΠ°ΡΠΈΠΎΠ½Π½ΡΠΌ Ρ Π°ΡΠ°ΠΊΡΠ΅ΡΠΈΡΡΠΈΠΊΠ°ΠΌ, Π² ΠΊΠΎΡΠΎΡΡΡ ΡΠΎΡΠ΅ΡΠ°ΡΡΡΡ ΠΏΡΠ΅ΠΈΠΌΡΡΠ΅ΡΡΠ²Π° ΠΏΠ΅ΡΠ΅ΡΠΈΡΠ»Π΅Π½Π½ΡΡ ΠΊΡΠ°ΡΠΎΡΠ½ΡΡ ΡΠΎΡΡΠ°Π²ΠΎΠ².

Π‘ΠΈΠ»ΠΈΠΊΠΎΠ½ΠΎΠ²ΡΠ΅ ΠΊΡΠ°ΡΠΊΠΈ Π΄Π»Ρ ΡΠ°ΡΠ°Π΄Π° β Π½ΠΎΠ²ΡΠΉ ΡΠΈΠΏ ΠΊΡΠ°ΡΠΎΠΊ
Π‘ΠΈΠ»ΠΈΠΊΠ°ΡΠ½ΡΠ΅ ΠΊΡΠ°ΡΠΊΠΈ
ΠΠ½ΠΎΠ³ΠΈΠ΅ Π»ΡΠ΄ΠΈ ΠΏΡΡΠ°ΡΡ ΡΠΈΠ»ΠΈΠΊΠΎΠ½ΠΎΠ²ΡΠ΅ ΠΈ ΡΠΈΠ»ΠΈΠΊΠ°ΡΠ½ΡΠ΅ ΠΏΠΎΠΊΡΡΡΠΈΡ. ΠΠ΅ΡΠΌΠΎΡΡΡ Π½Π° ΡΠΎ ΡΡΠΎ ΠΈΡ Π½Π°Π·Π²Π°Π½ΠΈΡ ΠΏΠΎΡ ΠΎΠΆΠΈ, ΠΌΠ°ΡΠ΅ΡΠΈΠ°Π»Ρ ΡΠΈΠ»ΡΠ½ΠΎ ΠΎΡΠ»ΠΈΡΠ°ΡΡΡΡ ΠΏΠΎ ΡΠΎΡΡΠ°Π²Ρ.
- ΠΡΠ°ΡΠΊΠ°Β ΡΠΈΠ»ΠΈΠΊΠ°ΡΠ½Π°ΡΒ ΡΠ°ΡΠ°Π΄Π½Π°ΡΒ ΠΎΡΠ½ΠΎΡΠΈΡΡΡ ΠΊ Π½Π°ΡΡΡΠ°Π»ΡΠ½ΡΠΌ ΠΎΡΠ΄Π΅Π»ΠΎΡΠ½ΡΠΌ ΠΌΠ°ΡΠ΅ΡΠΈΠ°Π»Π°ΠΌ, ΠΏΠΎΡΠΊΠΎΠ»ΡΠΊΡ ΠΏΡΠΎΠΈΠ·Π²ΠΎΠ΄ΠΈΡΡΡ Π½Π° ΠΎΡΠ½ΠΎΠ²Π΅ ΠΆΠΈΠ΄ΠΊΠΎΠ³ΠΎ ΠΊΠ°Π»ΠΈΠΉΠ½ΠΎΠ³ΠΎ ΡΡΠ΅ΠΊΠ»Π°, ΡΠΎ Π΅ΡΡΡ ΠΏΡΠ΅Π΄ΡΡΠ°Π²Π»ΡΠ΅Ρ ΡΠΎΠ±ΠΎΠΉ Π²ΠΎΠ΄Π½ΡΠΉ ΡΠ°ΡΡΠ²ΠΎΡ ΡΠΈΠ»ΠΈΠΊΠ°ΡΠ° Π½Π°ΡΡΠΈΡ ΠΈΠ»ΠΈ ΠΊΠ°Π»ΠΈΡ. ΠΡΠΈΡΠ΅ΠΌ Π² ΠΏΠΎΡΠ»Π΅Π΄Π½ΠΈΠ΅ Π³ΠΎΠ΄Ρ Π΄Π»Ρ ΡΡΠΈΡ ΡΠ΅Π»Π΅ΠΉ ΠΈΡΠΏΠΎΠ»ΡΠ·ΡΠ΅ΡΡΡ ΠΏΡΠ΅ΠΈΠΌΡΡΠ΅ΡΡΠ²Π΅Π½Π½ΠΎ ΠΊΠ°Π»ΠΈΠΉ, ΠΏΠΎΡΠΊΠΎΠ»ΡΠΊΡ ΡΠΈΠ»ΠΈΠΊΠ°Ρ Π½Π°ΡΡΠΈΡ Π½Π΅ΠΌΠ½ΠΎΠ³ΠΎ ΡΡΡΡΠΏΠ°Π΅Ρ Π΅ΠΌΡ ΠΏΠΎ ΡΠ²ΠΎΠΈΠΌ ΡΠΊΡΠΏΠ»ΡΠ°ΡΠ°ΡΠΈΠΎΠ½Π½ΡΠΌ Ρ Π°ΡΠ°ΠΊΡΠ΅ΡΠΈΡΡΠΈΠΊΠ°ΠΌ. Π‘ΠΈΠ»ΠΈΠΊΠ°Ρ ΠΊΠ°Π»ΠΈΡ ΠΏΡΠΎΠΈΠ·Π²ΠΎΠ΄ΠΈΡΡΡ ΠΈΠ· ΠΊΠ²Π°ΡΡΠ΅Π²ΠΎΠ³ΠΎ ΠΏΠ΅ΡΠΊΠ° ΠΈ ΠΏΠΎΡΠ°ΡΠ°. ΠΡΠΈ ΠΈΠ½Π³ΡΠ΅Π΄ΠΈΠ΅Π½ΡΡ ΡΠΏΠ΅ΠΊΠ°ΡΡΡΡ ΠΏΡΠΈ ΠΎΡΠ΅Π½Ρ Π²ΡΡΠΎΠΊΠΈΡ ΡΠ΅ΠΌΠΏΠ΅ΡΠ°ΡΡΡΠ°Ρ , ΠΏΠ΅ΡΠ΅ΠΌΠ°Π»ΡΠ²Π°ΡΡΡΡ, Π° Π·Π°ΡΠ΅ΠΌ ΠΏΠ΅ΡΠ΅ΡΠ°Π±Π°ΡΡΠ²Π°ΡΡΡΡ Π² Π²ΠΎΠ΄Π½ΡΠΉ ΡΠ°ΡΡΠ²ΠΎΡ.
- Π‘ΠΈΠ»ΠΈΠΊΠ°ΡΠ½ΡΠ΅ ΡΠΎΡΡΠ°Π²Ρ ΠΏΡΠΈΠ·Π½Π°Π½Ρ ΠΎΠ΄Π½ΠΈΠΌΠΈ ΠΈΠ· ΡΠ°ΠΌΡΡ ΡΡΠΎΠΉΠΊΠΈΡ ΡΡΠ΅Π΄ΠΈ ΡΠ΅Ρ , ΡΡΠΎ ΠΈΡΠΏΠΎΠ»ΡΠ·ΡΡΡΡΡ Π΄Π»Ρ ΠΎΡΠ΄Π΅Π»ΠΊΠΈ ΡΠ°ΡΠ°Π΄ΠΎΠ². ΠΠΎ ΠΈΠ½ΠΎΠ³Π΄Π° ΠΈΡ ΠΏΡΡΠ°ΡΡ Ρ ΠΏΡΠ΅Π΄ΡΡΠ°Π²Π»Π΅Π½Π½ΠΎΠΉ Π½Π° ΡΡΠ½ΠΊΠ΅ Π΄ΠΈΡΠΏΠ΅ΡΡΠΈΠΎΠ½Π½ΠΎΠΉ ΡΠΈΠ»ΠΈΠΊΠ°ΡΠ½ΠΎΠΉ ΠΊΡΠ°ΡΠΊΠΎΠΉ. ΠΠΎΡΠ»Π΅Π΄Π½ΡΡ Π΄Π΅ΠΉΡΡΠ²ΠΈΡΠ΅Π»ΡΠ½ΠΎ Π±Π»ΠΈΠ·ΠΊΠ° ΠΊ ΠΎΡΠΈΠ³ΠΈΠ½Π°Π»Ρ ΠΏΠΎ Ρ ΠΈΠΌΠΈΡΠ΅ΡΠΊΠΎΠΌΡ ΡΠΎΡΡΠ°Π²Ρ, Π½ΠΎ Π² Π½Π΅ΠΉ ΠΏΡΠΈΡΡΡΡΡΠ²ΡΠ΅Ρ ΠΈ ΡΠΈΠ½ΡΠ΅ΡΠΈΡΠ΅ΡΠΊΠΈΠΉ ΠΊΠΎΠΌΠΏΠΎΠ½Π΅Π½Ρ β ΡΠΈΡΡΡΠΉ Π°ΠΊΡΠΈΠ» (Π΅Π³ΠΎ ΡΠΎΠ΄Π΅ΡΠΆΠ°Π½ΠΈΠ΅ ΠΌΠΎΠΆΠ΅Ρ Π΄ΠΎΡ ΠΎΠ΄ΠΈΡΡ Π΄ΠΎ 8%), ΠΊΠΎΡΠΎΡΡΠΉ ΡΠ²Π»ΡΠ΅ΡΡΡ Π² Π΄Π°Π½Π½ΠΎΠΌ ΡΠ»ΡΡΠ°Π΅ ΡΠ²ΡΠ·ΡΡΡΠΈΠΌ ΠΊΠΎΠΌΠΏΠΎΠ½Π΅Π½ΡΠΎΠΌ. ΠΠ½ Π½Π΅ΡΠΊΠΎΠ»ΡΠΊΠΎ ΡΠ΄Π΅ΡΠ΅Π²Π»ΡΠ΅Ρ ΠΏΡΠΎΠΈΠ·Π²ΠΎΠ΄ΡΡΠ²ΠΎ, Π½ΠΎ ΠΏΡΠΈ ΡΡΠΎΠΌ ΡΡ ΡΠ΄ΡΠ°Π΅Ρ ΡΠΊΡΠΏΠ»ΡΠ°ΡΠ°ΡΠΈΠΎΠ½Π½ΡΠ΅ Ρ Π°ΡΠ°ΠΊΡΠ΅ΡΠΈΡΡΠΈΠΊΠΈ. Π ΠΎΡΠ»ΠΈΡΠΈΠ΅ ΠΎΡ ΡΠΈΡΡΡΡ ΡΠΈΠ»ΠΈΠΊΠ°ΡΠ½ΡΡ ΠΌΠ°ΡΠ΅ΡΠΈΠ°Π»ΠΎΠ², ΡΠ°ΠΊΠ°Ρ Π΄ΠΈΡΠΏΠ΅ΡΡΠΈΡ ΠΏΡΠΎΠ΄Π°Π΅ΡΡΡ ΡΠ°Π·Π²Π΅Π΄Π΅Π½Π½ΠΎΠΉ, ΡΡΠΎ ΠΎΠ΄Π½ΠΎΠΊΠΎΠΌΠΏΠΎΠ½Π΅Π½ΡΠ½ΡΠΉ ΡΠΎΡΡΠ°Π², Π³ΠΎΡΠΎΠ²ΡΠΉ ΠΊ ΡΠΏΠΎΡΡΠ΅Π±Π»Π΅Π½ΠΈΡ.

Π‘ΠΈΠ»ΠΈΠΊΠ°ΡΠ½ΡΠ΅ ΠΊΡΠ°ΡΠΊΠΈ ΡΠΎΡΡΠΎΡΡ ΠΈΠ· ΠΆΠΈΠ΄ΠΊΠΎΠ³ΠΎ ΡΡΠ΅ΠΊΠ»Π° ΠΈ ΠΊΡΠ°ΡΡΡΠ΅Π³ΠΎ ΠΏΠΎΡΠΎΡΠΊΠ°
Π Π²ΠΎΡΒ ΡΠΈΠ»ΠΈΠΊΠ°ΡΠ½Π°ΡΒ ΠΊΡΠ°ΡΠΊΠ°Β Π² ΡΠΈΡΡΠΎΠΌ Π²ΠΈΠ΄Π΅ β ΡΡΠΎ Π΄Π²ΡΡ ΠΊΠΎΠΌΠΏΠΎΠ½Π΅Π½ΡΠ½ΡΠΉ ΡΠΎΡΡΠ°Π² (ΠΆΠΈΠ΄ΠΊΠΎΠ΅ ΡΡΠ΅ΠΊΠ»ΠΎ ΠΈ ΠΏΠΎΡΠΎΡΠΎΠΊ). ΠΠ΅ Π½Π΅Π»ΡΠ·Ρ Π΄ΠΎΠ»Π³ΠΎ Ρ ΡΠ°Π½ΠΈΡΡ Π² ΡΠ°Π·Π²Π΅Π΄Π΅Π½Π½ΠΎΠΌ Π²ΠΈΠ΄Π΅, ΠΏΠΎΡΠΊΠΎΠ»ΡΠΊΡ ΠΎΠ½Π° ΠΌΠΎΠΆΠ΅Ρ Π±ΡΡΡΡΠΎ ΠΊΠ°ΡΠ±ΠΎΠ½ΠΈΠ·ΠΈΡΠΎΠ²Π°ΡΡΡΡ, ΡΠΎ Π΅ΡΡΡ ΠΏΡΠ΅Π²ΡΠ°ΡΠΈΡΡΡΡ Π² ΠΊΡΡΠΎΠΊ ΡΠ²Π΅ΡΠ΄ΠΎΠ³ΠΎ ΠΊΠ°ΠΌΠ½Ρ. Π‘Π°ΠΌ ΠΏΠΎ ΡΠ΅Π±Π΅ ΡΡΠΎΡ ΡΠΎΡΡΠ°Π² ΠΎΠ±Π»Π°Π΄Π°Π΅Ρ ΠΏΡΠ΅Π²ΠΎΡΡ ΠΎΠ΄Π½ΡΠΌΠΈ Ρ Π°ΡΠ°ΠΊΡΠ΅ΡΠΈΡΡΠΈΠΊΠ°ΠΌΠΈ, Π² ΡΠΎΠΌ ΡΠΈΡΠ»Π΅ ΠΈ Π²ΡΡΠΎΠΊΠΈΠΌΠΈ Π΄ΠΈΡΡΡΠ·ΠΈΠΎΠ½Π½ΡΠΌΠΈ ΡΠ²ΠΎΠΉΡΡΠ²Π°ΠΌΠΈ. Π‘ΠΈΠ»ΠΈΠΊΠ°ΡΠ½ΡΠ΅ ΡΠ°ΡΠ°Π΄Π½ΡΠ΅ ΠΊΡΠ°ΡΠΊΠΈ Π½Π΅ ΡΠΎΠ·Π΄Π°ΡΡ Π½Π° ΠΏΠΎΠ²Π΅ΡΡ Π½ΠΎΡΡΠΈ ΠΏΠ»Π΅Π½ΠΊΠΈ, ΡΡΠΎ Π³ΠΎΠ²ΠΎΡΠΈΡ ΠΎΠ± ΠΈΡ Π²ΡΡΠΎΠΊΠΎΠΉ ΠΏΠ°ΡΠΎΠΏΡΠΎΠ½ΠΈΡΠ°Π΅ΠΌΠΎΡΡΠΈ. ΠΠ½ΠΈ ΠΏΡΠΎΠΏΡΡΠΊΠ°ΡΡ Π²Π»Π°Π³Ρ, ΠΏΠΎΠ²Π΅ΡΡ Π½ΠΎΡΡΡ ΠΏΠΎΠ΄ Π½ΠΈΠΌΠΈ Π΄ΡΡΠΈΡ, ΠΏΠΎΡΡΠΎΠΌΡ ΠΈΡ ΠΌΠΎΠΆΠ½ΠΎ ΠΏΡΠΈΠΌΠ΅Π½ΡΡΡ Π΄Π°ΠΆΠ΅ Π½Π° ΡΠ΅Ρ ΡΠ°ΡΠ°Π΄Π°Ρ , ΠΊΠΎΡΠΎΡΡΠ΅ ΡΡΠ΅ΠΏΠ»ΡΠ»ΠΈΡΡ ΠΏΠ΅Π½ΠΎΠΏΠΎΠ»ΠΈΡΡΠΈΡΠΎΠ»ΠΎΠΌ. Π’Π°ΠΊΠΈΠ΅ ΡΠΎΡΡΠ°Π²Ρ ΠΈΡΠΏΠΎΠ»ΡΠ·ΡΡΡ Π΄Π»Ρ Π»ΡΠ±ΡΡ ΠΎΡΠ½ΠΎΠ²Π°Π½ΠΈΠΉ, ΠΈΠ·Π³ΠΎΡΠΎΠ²Π»Π΅Π½Π½ΡΡ ΠΈΠ· Π½Π°ΡΡΡΠ°Π»ΡΠ½ΡΡ ΠΌΠ°ΡΠ΅ΡΠΈΠ°Π»ΠΎΠ² ΠΈ ΡΠΎΠ΄Π΅ΡΠΆΠ°ΡΠΈΡ ΠΏΠ΅ΡΠΎΠΊ ΠΈ ΠΊΠ²Π°ΡΡ, ΡΠΎ Π΅ΡΡΡ ΡΠΏΠΎΡΠΎΠ±Π½ΡΡ ΠΊ ΡΠΈΠ»ΠΈΠΊΠ°ΡΠΈΠ·Π°ΡΠΈΠΈ. ΠΡΠΈ ΠΏΠΎΠΊΡΡΡΠΈΡ Ρ ΠΎΡΠΎΡΠΎ ΡΠΎΡΠ΅ΡΠ°ΡΡΡΡ Ρ ΠΈΠ·Π²Π΅ΡΡΠΊΠΎΠ²ΡΠΌΠΈ ΠΈ ΠΈΠ·Π²Π΅ΡΡΠΊΠΎΠ²ΠΎ-ΡΠ΅ΠΌΠ΅Π½ΡΠ½ΡΠΌΠΈ ΡΡΡΠΊΠ°ΡΡΡΠΊΠ°ΠΌΠΈ, Ρ ΠΏΡΠΈΡΠΎΠ΄Π½ΡΠΌ ΠΈ ΡΠΈΠ½ΡΠ΅ΡΠΈΡΠ΅ΡΠΊΠΈΠΌ ΠΊΠ°ΠΌΠ½Π΅ΠΌ, Π½Π°Π½ΠΎΡΡΡ ΠΈΡ ΠΈ Π½Π° ΡΡΠ°ΡΠΎΠ΅ ΠΏΠΎΠΊΡΡΡΠΈΠ΅ ΠΈΠ· ΡΠΈΠ»ΠΈΠΊΠ°ΡΠ½ΡΡ ΠΊΡΠ°ΡΠΎΠΊ. Π Π²ΠΎΡ ΠΏΠΎΠ²Π΅ΡΡ ΡΠΈΠ½ΡΠ΅ΡΠΈΡΠ΅ΡΠΊΠΈΡ ΡΠΎΡΡΠ°Π²ΠΎΠ² ΠΈΡ ΠΏΡΠΈΠΌΠ΅Π½ΡΡΡ Π½Π΅Π»ΡΠ·Ρ.
Π£ ΡΠΈΠ»ΠΈΠΊΠ°ΡΠ½ΠΎΠ³ΠΎ ΠΏΠΎΠΊΡΡΡΠΈΡ Π΅ΡΡΡ ΠΈ Π΄ΠΎΡΡΠΎΠΈΠ½ΡΡΠ²Π°, ΠΈ Π½Π΅Π΄ΠΎΡΡΠ°ΡΠΊΠΈ.
- Π ΡΠΈΡΠ»Ρ ΠΏΡΠ΅ΠΈΠΌΡΡΠ΅ΡΡΠ² ΡΡΠΎΠΈΡ ΠΎΡΠ½Π΅ΡΡΠΈ ΠΈ ΡΠΎ, ΡΡΠΎ Π½Π° ΡΠ°ΠΊΠΈΡ ΠΏΠΎΠ²Π΅ΡΡ Π½ΠΎΡΡΡΡ Π½Π΅ Π·Π°Π²ΠΎΠ΄ΡΡΡΡ Π³ΡΠΈΠ±ΠΊΠΈ ΠΈ ΠΏΠ»Π΅ΡΠ΅Π½Ρ. ΠΠΎ Π³Π»Π°Π²Π½ΠΎΠ΅ β ΡΡΠΎ Π²ΡΡΠΎΠΊΠ°Ρ Π°Π΄Π³Π΅Π·ΠΈΡ ΠΊ ΠΏΠ΅ΡΠ΅ΡΠΈΡΠ»Π΅Π½Π½ΡΠΌ ΠΎΡΠ½ΠΎΠ²Π°Π½ΠΈΡΠΌ.
- ΠΡΠΎ ΡΠ²ΠΎΠΉΡΡΠ²ΠΎ ΡΠΈΠ»ΠΈΠΊΠ°ΡΠ½ΡΡ ΠΊΡΠ°ΡΠΎΠΊ ΠΌΠΎΠΆΠ΅Ρ ΠΏΡΠ΅Π²ΡΠ°ΡΠ°ΡΡΡΡ Π² ΠΈΡ Π½Π΅Π΄ΠΎΡΡΠ°ΡΠΎΠΊ, ΠΏΠΎΡΠΊΠΎΠ»ΡΠΊΡ ΠΏΡΠΈ ΡΠ»Π΅Π΄ΡΡΡΠ΅ΠΌ ΡΠ΅ΠΌΠΎΠ½ΡΠ΅ ΡΡΠΎ ΠΏΠΎΠΊΡΡΡΠΈΠ΅ ΠΎΡΠ΅Π½Ρ ΡΡΠΆΠ΅Π»ΠΎ ΡΠ½ΡΡΡ. ΠΡΠΎΠΌΠ΅ ΡΠΎΠ³ΠΎ, Π½Π΅Π΄ΠΎΡΡΠ°ΡΠΊΠΎΠΌ ΡΡΠΎΠ³ΠΎ ΡΠΈΠΏΠ° ΠΏΠΎΠΊΡΡΡΠΈΠΉ ΡΠ²Π»ΡΠ΅ΡΡΡ ΠΎΡΠ½ΠΎΡΠΈΡΠ΅Π»ΡΠ½ΠΎ Π½Π΅Π±ΠΎΠ»ΡΡΠΎΠΉ Π²ΡΠ±ΠΎΡ ΡΠ²Π΅ΡΠΎΠ². ΠΡΠ΅ ΠΎΠ½ΠΈ ΠΏΠ»ΠΎΡ ΠΎ ΠΏΡΠΎΡΠΈΠ²ΠΎΡΡΠΎΡΡ Π²ΠΎΠ·Π΄Π΅ΠΉΡΡΠ²ΠΈΡ ΠΏΡΡΠΌΡΡ ΡΠΎΠ»Π½Π΅ΡΠ½ΡΡ Π»ΡΡΠ΅ΠΉ.
- ΠΠ°ΡΠΎ ΡΠΈΠ»ΠΈΠΊΠ°ΡΡ, ΠΊΠΎΡΠΎΡΡΠ΅ Π²Ρ ΠΎΠ΄ΡΡ Π² Π΅Π³ΠΎ ΡΠΎΡΡΠ°Π², ΠΏΡΠ°ΠΊΡΠΈΡΠ΅ΡΠΊΠΈ Π½Π΅ Π½Π°ΠΊΠ°ΠΏΠ»ΠΈΠ²Π°ΡΡ ΡΡΠ°ΡΠΈΡΠ΅ΡΠΊΠΎΠ΅ ΡΠ»Π΅ΠΊΡΡΠΈΡΠ΅ΡΡΠ²ΠΎ, ΠΏΠΎΡΡΠΎΠΌΡ Π½Π° ΠΏΠΎΠ²Π΅ΡΡ Π½ΠΎΡΡΠΈ ΡΠΎΠ±ΠΈΡΠ°Π΅ΡΡΡ ΠΌΠ΅Π½ΡΡΠ΅ ΠΏΡΠ»ΠΈ.
Π‘ΠΈΠ»ΠΈΠΊΠΎΠ½ΠΎΠ²ΡΠ΅ ΠΊΡΠ°ΡΠΊΠΈ
ΠΡΠΈ Π²ΡΠ±ΠΎΡΠ΅ Π»ΡΠ±ΡΡ Π»Π°ΠΊΠΎΠΊΡΠ°ΡΠΎΡΠ½ΡΡ ΡΡΠ΅Π΄ΡΡΠ² ΡΡΠΈΡΡΠ²Π°Π΅ΡΡΡ ΠΌΠ½ΠΎΠΆΠ΅ΡΡΠ²ΠΎ ΡΠ°ΠΊΡΠΎΡΠΎΠ². ΠΡΠΎ ΠΈ ΡΠΈΠΏ ΡΠ°ΡΠ°Π΄Π°, ΠΈ ΠΌΠ°ΡΠ΅ΡΠΈΠ°Π», ΠΈΠ· ΠΊΠΎΡΠΎΡΠΎΠ³ΠΎ Π²ΠΎΠ·Π²Π΅Π΄Π΅Π½Ρ ΡΡΠ΅Π½Ρ, ΠΈ ΡΠ΅Ρ Π½ΠΈΡΠ΅ΡΠΊΠΎΠ΅ ΡΠΎΡΡΠΎΡΠ½ΠΈΠ΅ Π΄ΠΎΠΌΠ°, ΠΈ ΠΌΠ΅ΡΡΠ½ΠΎΡΡΡ, Π³Π΄Π΅ ΠΎΠ½ ΡΠ°ΡΠΏΠΎΠ»ΠΎΠΆΠ΅Π½. ΠΡΠΎΠΌΠ΅ ΡΠΎΠ³ΠΎ, Π²Π°ΠΆΠ½ΡΡ ΡΠΎΠ»Ρ ΠΈΠ³ΡΠ°ΡΡ ΡΡΠ»ΠΎΠ²ΠΈΡ ΠΏΡΠΎΠ²Π΅Π΄Π΅Π½ΠΈΡ ΡΠ°Π±ΠΎΡ, Π²ΡΠ΄Π΅Π»Π΅Π½Π½ΡΠΉ Π½Π° ΡΡΠΎ Π±ΡΠ΄ΠΆΠ΅Ρ ΠΈ ΠΏΡΠΎΡΠΈΠ΅ ΠΏΠΎΠ΄ΠΎΠ±Π½ΡΠ΅ ΡΠ°ΠΊΡΠΎΡΡ. ΠΠΎΠ»Π΅Π΅ ΡΠ½ΠΈΠ²Π΅ΡΡΠ°Π»ΡΠ½ΡΠΌ Π²Π°ΡΠΈΠ°Π½ΡΠΎΠΌ Ρ ΡΡΠ΅ΡΠΎΠΌ ΠΏΠ΅ΡΠ΅ΡΠΈΡΠ»Π΅Π½Π½ΡΡ ΠΊΡΠΈΡΠ΅ΡΠΈΠ΅Π² ΡΠ²Π»ΡΡΡΡΡ ΡΠΈΠ»ΠΈΠΊΠΎΠ½ΠΎΠ²ΡΠ΅ ΡΠ°ΡΠ°Π΄Π½ΡΠ΅ ΠΏΠΎΠΊΡΡΡΠΈΡ, ΠΊΠΎΡΠΎΡΡΠ΅ ΡΠΎΡΠ΅ΡΠ°ΡΡ Π² ΡΠ΅Π±Π΅ Π²ΡΠ΅ ΠΏΡΠ΅ΠΈΠΌΡΡΠ΅ΡΡΠ²Π° Π°ΠΊΡΠΈΠ»ΠΎΠ²ΡΡ ΠΈ ΡΠΈΠ»ΠΈΠΊΠ°ΡΠ½ΡΡ ΡΠΎΡΡΠ°Π²ΠΎΠ², Π½ΠΎ ΠΏΡΠΈ ΡΡΠΎΠΌ Π»ΠΈΡΠ΅Π½Ρ ΠΈΡ Π½Π΅Π΄ΠΎΡΡΠ°ΡΠΊΠΎΠ².
Π£ Π½ΠΈΡ Π²ΡΡΠΎΠΊΠ°Ρ ΠΏΠ°ΡΠΎΠΏΡΠΎΠ½ΠΈΡΠ°Π΅ΠΌΠΎΡΡΡ, ΠΏΠΎΡΡΠΎΠΌΡ ΠΈΡ ΠΌΠΎΠΆΠ½ΠΎ ΠΈΡΠΏΠΎΠ»ΡΠ·ΠΎΠ²Π°ΡΡ Π΄Π°ΠΆΠ΅ Π΄Π»Ρ Π·Π΄Π°Π½ΠΈΠΉ Ρ Π½Π΅Π΄ΠΎΡΡΠ°ΡΠΎΡΠ½ΠΎ Ρ ΠΎΡΠΎΡΠ΅ΠΉ Π³ΠΈΠ΄ΡΠΎΠΈΠ·ΠΎΠ»ΡΡΠΈΠ΅ΠΉ ΡΡΠ½Π΄Π°ΠΌΠ΅Π½ΡΠΎΠ². ΠΠ° ΡΠ°ΠΊΠΈΡ ΠΏΠΎΠ²Π΅ΡΡ Π½ΠΎΡΡΡΡ Π½Π΅ Π·Π°Π²ΠΎΠ΄ΡΡΡΡ Π³ΡΠΈΠ±ΠΊΠΈ ΠΈ ΠΏΠ»Π΅ΡΠ΅Π½Ρ.

Π‘ΠΈΠ»ΠΈΠΊΠΎΠ½ΠΎΠ²ΡΠ΅ ΠΊΡΠ°ΡΠΊΠΈ ΡΠΎΡΠ΅ΡΠ°ΡΡ Π² ΡΠ΅Π±Π΅ ΠΏΡΠ΅ΠΈΠΌΡΡΠ΅ΡΡΠ²Π° Π°ΠΊΡΠΈΠ»ΠΎΠ²ΡΡ ΠΈ ΡΠΈΠ»ΠΈΠΊΠ°ΡΠ½ΡΡ ΠΊΡΠ°ΡΠΎΠΊ
Π‘Π²ΡΠ·ΡΡΡΠΈΠΌ Π²Π΅ΡΠ΅ΡΡΠ²ΠΎΠΌ Π·Π΄Π΅ΡΡ ΡΠ²Π»ΡΡΡΡΡ ΠΊΡΠ΅ΠΌΠ½ΠΈΠΉΠΎΡΠ³Π°Π½ΠΈΡΠ΅ΡΠΊΠΈΠ΅ ΡΠΌΠΎΠ»Ρ. ΠΠΎΡΠ»Π΅ Π²ΡΡΡΡ Π°Π½ΠΈΡ ΡΠΎΡΡΠ°Π²Π° ΠΏΠΎΠ²Π΅ΡΡ Π½ΠΎΡΡΡ Π²ΡΠ³Π»ΡΠ΄ΠΈΡ ΡΠ°ΠΊ, ΠΊΠ°ΠΊ Π±ΡΠ΄ΡΠΎ ΠΏΠΎΠΊΡΡΡΠ° Π½Π°ΡΡΡΠ°Π»ΡΠ½ΠΎΠΉ ΠΊΡΠ°ΡΠΊΠΎΠΉ, ΡΠΌΠΎΡΡΠΈΡΡΡ ΠΎΠ΄Π½ΠΎΡΠΎΠ΄Π½ΠΎΠΉ, ΠΈ ΠΏΡΠΈ ΡΡΠΎΠΌ ΠΎΠΊΡΠ°ΡΠΈΠ²Π°Π½ΠΈΠ΅ Π½Π΅ ΠΏΠΎΡΡΠΈΡ ΡΠ°ΠΊΡΡΡΡ ΡΡΠ΅Π½Ρ, ΡΠΎΡΡΠ°Π² ΠΎΠ±ΡΠ°Π·ΡΠ΅Ρ Π½Π° Π½Π΅ΠΉ Π²ΠΎΠ΄ΠΎΠ½Π΅ΠΏΡΠΎΠ½ΠΈΡΠ°Π΅ΠΌΡΡ ΠΏΠ»Π΅Π½ΠΊΡ, ΠΏΠΎΠ΄ ΠΊΠΎΡΠΎΡΠΎΠΉ Π½Π΅ ΡΠΎΠ±ΠΈΡΠ°Π΅ΡΡΡ ΠΊΠΎΠ½Π΄Π΅Π½ΡΠ°Ρ.
Π‘ΠΏΠ΅ΡΠΈΠ°Π»ΠΈΡΡΡ ΠΏΡΠΈΠ·Π½Π°ΡΡ Π²ΡΡΠΎΠΊΠΈΠ΅ Π΄Π΅ΠΊΠΎΡΠ°ΡΠΈΠ²Π½ΡΠ΅ ΠΈ ΡΠΊΡΠΏΠ»ΡΠ°ΡΠ°ΡΠΈΠΎΠ½Π½ΡΠ΅ ΠΊΠ°ΡΠ΅ΡΡΠ²Π° ΡΠΈΠ»ΠΈΠΊΠΎΠ½ΠΎΠ²ΡΡ ΡΠΎΡΡΠ°Π²ΠΎΠ². ΠΡΠΎΠΌΠ΅ ΡΠΎΠ³ΠΎ, ΡΠ°ΠΊΠΈΠ΅ ΠΏΠΎΠΊΡΡΡΠΈΡ Π²ΡΡΡΡ Π°ΡΡ Ρ ΠΌΠ΅Π½ΡΡΠΈΠΌ ΠΏΠΎΠ²Π΅ΡΡ Π½ΠΎΡΡΠ½ΡΠΌ Π½Π°ΠΏΡΡΠΆΠ΅Π½ΠΈΠ΅ΠΌ ΠΏΠΎ ΡΡΠ°Π²Π½Π΅Π½ΠΈΡ ΡΠΎ ΡΠ²ΠΎΠΈΠΌΠΈ Π°ΠΊΡΠΈΠ»ΠΎΠ²ΡΠΌΠΈ ΠΈ ΡΠΈΠ»ΠΈΠΊΠ°ΡΠ½ΡΠΌΠΈ Π°Π½Π°Π»ΠΎΠ³Π°ΠΌΠΈ, ΠΏΠΎΡΡΠΎΠΌΡ Π½Π° ΡΡΠ΅Π½Π°Ρ Π½Π΅ ΠΎΠ±ΡΠ°Π·ΡΡΡΡΡ ΠΌΠΈΠΊΡΠΎΡΡΠ΅ΡΠΈΠ½Ρ. ΠΠ»Π°Π³ΠΎΠ΄Π°ΡΡ ΡΡΠΎΠΌΡ ΡΠΈΠ»ΠΈΠΊΠΎΠ½ΠΎΠ²ΡΠ΅ ΡΠΎΡΡΠ°Π²Ρ ΠΌΠΎΠΆΠ½ΠΎ ΠΈΡΠΏΠΎΠ»ΡΠ·ΠΎΠ²Π°ΡΡ Π΄Π°ΠΆΠ΅ Π΄Π»Ρ ΠΏΡΠΎΠ±Π»Π΅ΠΌΠ½ΡΡ ΠΊΠΎΠ½ΡΡΡΡΠΊΡΠΈΠΉ, Π³Π΄Π΅ ΡΡΠ΅Π½Ρ ΡΠ»Π°Π±ΡΠ΅, ΠΎΡΡΠ΅ΠΌΠΎΠ½ΡΠΈΡΠΎΠ²Π°Π½Π½ΡΠ΅ Ρ ΠΏΡΠΈΠΌΠ΅Π½Π΅Π½ΠΈΠ΅ΠΌ Π½Π΅ΠΈΠ·Π²Π΅ΡΡΠ½ΡΡ ΠΈ ΡΠ°Π·Π½ΠΎΡΠΎΠ΄Π½ΡΡ ΠΌΠ°ΡΠ΅ΡΠΈΠ°Π»ΠΎΠ².
Π‘ΡΠ΅Π΄ΠΈ ΠΏΡΠΎΡΠΈΡ Π΄ΠΎΡΡΠΎΠΈΠ½ΡΡΠ² ΡΠ°ΠΊΠΈΡ ΡΠΎΡΡΠ°Π²ΠΎΠ² β Π²ΡΡΠΎΠΊΠ°Ρ Π°Π΄Π³Π΅Π·ΠΈΡ, Π½Π΅ Ρ ΡΠΆΠ΅ ΡΠ΅ΠΌ Ρ ΡΠΈΠ»ΠΈΠΊΠ°ΡΠ½ΡΡ ΡΠ°Π·Π½ΠΎΠ²ΠΈΠ΄Π½ΠΎΡΡΠ΅ΠΉ. ΠΡΠΆΠ½ΠΎ Π²Π½ΠΈΠΌΠ°ΡΠ΅Π»ΡΠ½ΠΎ ΡΠΈΡΠ°ΡΡ ΠΈΠ½ΡΡΡΡΠΊΡΠΈΡ ΠΏΡΠΎΠΈΠ·Π²ΠΎΠ΄ΠΈΡΠ΅Π»Ρ, Π½ΠΎ Π±ΠΎΠ»ΡΡΠΈΠ½ΡΡΠ²ΠΎ ΡΠΈΠ»ΠΈΠΊΠΎΠ½ΠΎΠ²ΡΡ ΠΊΡΠ°ΡΠΎΠΊ ΠΌΠΎΠΆΠ½ΠΎ ΠΏΡΠΈΠΌΠ΅Π½ΡΡΡ ΠΏΡΠΈ ΠΌΠΈΠ½ΠΈΠΌΠ°Π»ΡΠ½ΠΎΠΉ ΡΠ΅ΠΌΠΏΠ΅ΡΠ°ΡΡΡΠ΅ +2 Β°Π‘, ΡΡΠΎ ΠΏΠΎΠ·Π²ΠΎΠ»ΡΠ΅Ρ Π·Π½Π°ΡΠΈΡΠ΅Π»ΡΠ½ΠΎ ΡΡΠΊΠΎΡΠΈΡΡ ΡΠ°ΡΠ°Π΄Π½ΡΠ΅ ΡΠ°Π±ΠΎΡΡ.
ΠΡΡΡ Ρ ΡΠΈΠ»ΠΈΠΊΠΎΠ½ΠΎΠ²ΡΡ
ΠΊΡΠ°ΡΠΎΠΊ ΠΈ ΡΠ²ΠΎΠΈ Π½Π΅Π΄ΠΎΡΡΠ°ΡΠΊΠΈ. Π₯ΠΎΡΡ ΠΎΠ½ΠΈ Π½Π΅ ΡΠ°ΠΊ Π±ΡΡΡΡΠΎ Π²ΡΠ³ΠΎΡΠ°ΡΡ Π½Π° ΡΠΎΠ»Π½ΡΠ΅, ΠΊΠ°ΠΊ ΡΠΈΠ»ΠΈΠΊΠ°ΡΠ½ΡΠ΅ ΠΌΠ°ΡΠ΅ΡΠΈΠ°Π»Ρ, Π½ΠΎ Π² Π΄Π»ΠΈΡΠ΅Π»ΡΠ½ΠΎΠΉ ΠΏΠ΅ΡΡΠΏΠ΅ΠΊΡΠΈΠ²Π΅ ΠΏΠΎΠ΄ΠΎΠ±Π½ΡΠΉ ΡΠΈΡΠΊ ΡΠΎΡ
ΡΠ°Π½ΡΠ΅ΡΡΡ. ΠΡΠΎΠΌΠ΅ ΡΠΎΠ³ΠΎ, ΡΠΈΠ»ΠΈΠΊΠΎΠ½ ΠΏΠ»ΠΎΡ
ΠΎ ΠΏΡΠΎΡΠΈΠ²ΠΎΡΡΠΎΠΈΡ ΠΈΡΡΠΈΡΠ°Π½ΠΈΡ ΠΈ ΠΌΠ΅Ρ
Π°Π½ΠΈΡΠ΅ΡΠΊΠΈΠΌ ΠΏΠΎΠ²ΡΠ΅ΠΆΠ΄Π΅Π½ΠΈΡΠΌ, ΠΏΠΎΡΡΠΎΠΌΡ ΡΠΎ, ΡΡΠΎ ΡΠ°ΠΊΠΈΠ΅ ΠΏΠΎΠ²Π΅ΡΡ
Π½ΠΎΡΡΠΈ Π½Π΅ Π½ΡΠΆΠ΄Π°ΡΡΡΡ Π² ΡΠ°ΡΡΠΎΠΉ ΡΠΈΡΡΠΊΠ΅, Π·Π½Π°ΡΠΈΡΠ΅Π»ΡΠ½ΠΎ ΠΏΡΠΎΠ΄Π»Π΅Π²Π°Π΅Ρ ΡΡΠΎΠΊ ΡΠ»ΡΠΆΠ±Ρ ΠΏΠΎΠΊΡΡΡΠΈΡ. ΠΠ»Π°ΡΡΠΈΡΠ½ΠΎΡΡΡ Ρ ΡΠ°ΠΊΠΎΠ³ΠΎ ΠΏΠΎΠΊΡΡΡΠΈΡ ΠΌΠ΅Π½ΡΡΠ΅, ΡΠ΅ΠΌ Ρ Π°ΠΊΡΠΈΠ»ΠΎΠ²ΠΎΠ³ΠΎ.
Π ΠΌΠ°Π³Π°Π·ΠΈΠ½Π΅ ΡΠ°ΡΠ΅ Π²ΡΠ΅Π³ΠΎ Π²ΡΡΡΠ΅ΡΠ°ΡΡΡΡ ΡΠΈΠ»ΠΈΠΊΠΎΠ½ΠΎΠ²ΡΠ΅ ΠΊΡΠ°ΡΠΊΠΈ Π½Π° Π²ΠΎΠ΄Π½ΠΎΠΉ ΠΎΡΠ½ΠΎΠ²Π΅. ΠΠ΄Π½Π°ΠΊΠΎ Π΅ΡΡΡ ΠΈ ΡΠΎΡΡΠ°Π²Ρ Π½Π° ΠΎΡΠ½ΠΎΠ²Π΅ ΠΎΡΠ³Π°Π½ΠΈΡΠ΅ΡΠΊΠΎΠ³ΠΎ ΡΠ°ΡΡΠ²ΠΎΡΠΈΡΠ΅Π»Ρ, ΡΠ°ΠΊ ΡΡΠΎ Π½ΡΠΆΠ½ΠΎ ΠΎΡΠ΅Π½Ρ Π²Π½ΠΈΠΌΠ°ΡΠ΅Π»ΡΠ½ΠΎ ΡΠΈΡΠ°ΡΡ ΡΡΠΈΠΊΠ΅ΡΠΊΡ.
Π‘ΠΈΠ»ΠΈΠΊΠΎΠ½ΠΎΠ²ΡΠ΅ ΠΊΡΠ°ΡΠΊΠΈ ΠΈ ΠΈΡ ΡΠ²Π΅ΡΠΎΠ²Π°Ρ Π³Π°ΠΌΠΌΠ°
ΠΠ½ΠΎΠ³ΠΈΡ Π΄ΠΎΠΌΠΎΠ²Π»Π°Π΄Π΅Π»ΡΡΠ΅Π² ΠΈΠ½ΡΠ΅ΡΠ΅ΡΡΠ΅Ρ, Π²Π»ΠΈΡΠ΅Ρ Π»ΠΈ Ρ ΠΈΠΌΠΈΡΠ΅ΡΠΊΠΈΠΉ ΡΠΎΡΡΠ°Π² ΠΊΡΠ°ΡΠΎΡΠ½ΠΎΠ³ΠΎ ΠΏΠΎΠΊΡΡΡΠΈΡ Π½Π° Π²ΡΠ±ΠΎΡ ΠΎΡΡΠ΅Π½ΠΊΠ°.
- ΠΠ° ΡΠ°ΠΌΠΎΠΌ Π΄Π΅Π»Π΅ ΠΎΡΠ½ΠΎΡΠΈΡΠ΅Π»ΡΠ½ΠΎ Π±Π΅Π΄Π½ΠΎΠΉ ΠΏΠ°Π»ΠΈΡΡΠΎΠΉ ΠΎΡΠ»ΠΈΡΠ°ΡΡΡΡ ΡΠΎΠ»ΡΠΊΠΎ ΡΠ΅ΠΌΠ΅Π½ΡΠ½ΡΠ΅ ΠΈ ΠΈΠ·Π²Π΅ΡΡΠΊΠΎΠ²ΡΠ΅ ΠΊΡΠ°ΡΠΎΡΠ½ΡΠ΅ ΡΠΎΡΡΠ°Π²Ρ.Β Π‘ΠΈΠ»ΠΈΠΊΠ°ΡΠ½ΡΠ΅Β ΠΊΡΠ°ΡΠΊΠΈΒ Π΄Π»ΡΒ ΡΠ°ΡΠ°Π΄Π°Β Π²ΡΠΏΡΡΠΊΠ°ΡΡ Π² Π΄ΠΎΡΡΠ°ΡΠΎΡΠ½ΠΎ ΡΠΈΡΠΎΠΊΠΎΠΉ ΡΠ²Π΅ΡΠΎΠ²ΠΎΠΉ Π³Π°ΠΌΠΌΠ΅, Π½ΠΎ ΡΡΠΊΠΈΡ ΠΎΡΡΠ΅Π½ΠΊΠΎΠ² Π²ΡΠΏΡΡΠΊΠ°Π΅ΡΡΡ ΠΎΡΠ΅Π½Ρ ΠΌΠ°Π»ΠΎ, ΠΈ Π²ΡΠ΅ ΡΠ°Π²Π½ΠΎ ΠΎΠ½ΠΈ ΠΌΠΎΠ³ΡΡ Π·Π½Π°ΡΠΈΡΠ΅Π»ΡΠ½ΠΎ ΠΏΠΎΠ±Π»Π΅ΠΊΠ½ΡΡΡ Π·Π° Π³ΠΎΠ΄.
- Π‘ΠΎΠ²ΡΠ΅ΠΌ Π΄ΡΡΠ³ΠΎΠ΅ Π΄Π΅Π»ΠΎ β ΡΠΈΠ»ΠΈΠΊΠΎΠ½ΠΎΠ²ΡΠ΅ ΡΠ°ΡΠ°Π΄Π½ΡΠ΅ ΠΊΡΠ°ΡΠΊΠΈ. ΠΠ½ΠΈ Π²ΡΠΏΡΡΠΊΠ°ΡΡΡΡ Π² ΡΠΈΡΠΎΠΊΠΎΠΉ ΡΠ²Π΅ΡΠΎΠ²ΠΎΠΉ Π³Π°ΠΌΠΌΠ΅ ΠΈ Π² ΡΠ΅ΡΠ΅Π½ΠΈΠ΅ Π΄Π»ΠΈΡΠ΅Π»ΡΠ½ΠΎΠ³ΠΎ Π²ΡΠ΅ΠΌΠ΅Π½ΠΈ ΡΠΎΡ ΡΠ°Π½ΡΡΡ ΠΏΠ΅ΡΠ²ΠΎΠ½Π°ΡΠ°Π»ΡΠ½ΡΠΉ ΠΎΡΡΠ΅Π½ΠΎΠΊ. ΠΠΎΠ½Π΅ΡΠ½ΠΎ, Π΄Π°ΠΆΠ΅ ΡΠΈΠ»ΠΈΠΊΠΎΠ½ΠΎΠ²ΡΠ΅ ΠΏΠΎΠΊΡΡΡΠΈΡ ΠΎΡΠ΅Π½Ρ ΡΡΠΊΠΎΠ³ΠΎ ΠΎΡΡΠ΅Π½ΠΊΠ° ΡΠΎ Π²ΡΠ΅ΠΌΠ΅Π½Π΅ΠΌ ΠΌΠΎΠ³ΡΡ ΠΏΠΎΠ±Π»Π΅ΠΊΠ½ΡΡΡ, Π½ΠΎ ΡΡΠΎ ΡΠ»ΡΡΠΈΡΡΡ Π½Π΅ Π·Π° Π³ΠΎΠ΄ ΠΈ Π½Π΅ Π·Π° Π΄Π²Π°, Ρ ΠΎΡΡ ΠΏΠΎ ΠΈΠ½ΡΠ΅Π½ΡΠΈΠ²Π½ΠΎΡΡΠΈ ΡΠ²Π΅ΡΠ° ΠΎΠ½ΠΈ Π²ΡΠ΅-ΡΠ°ΠΊΠΈ Π½Π΅ΠΌΠ½ΠΎΠ³ΠΎ ΡΡΡΡΠΏΠ°ΡΡ Π°ΠΊΡΠΈΠ»ΠΎΠ²ΡΠΌ ΡΠΎΡΡΠ°Π²Π°ΠΌ.

ΠΠΎΠ΄Π±ΠΈΡΠ°ΡΡ Π½Π΅ΠΎΠ±Ρ ΠΎΠ΄ΠΈΠΌΡΠΉ ΡΠ²Π΅Ρ ΡΠ»Π΅Π΄ΡΠ΅Ρ Π½Π΅ΠΏΠΎΡΡΠ΅Π΄ΡΡΠ²Π΅Π½Π½ΠΎ Π½Π° ΡΡΠ΅Π½Π΅
ΠΠΎΠΌΠΏΡΡΡΠ΅ΡΠ½Π°Ρ ΠΏΡΠΎΠ³ΡΠ°ΠΌΠΌΠ° Π½Π΅ ΡΠΌΠΎΠΆΠ΅Ρ ΠΏΡΠ°Π²ΠΈΠ»ΡΠ½ΠΎ ΠΏΠ΅ΡΠ΅Π΄Π°ΡΡ ΡΠ²Π΅Ρ ΡΠΈΠ»ΠΈΠΊΠΎΠ½ΠΎΠ²ΠΎΠΉ ΠΊΡΠ°ΡΠΊΠΈ, ΠΏΠΎΡΠΊΠΎΠ»ΡΠΊΡ Π½Π΅ ΡΡΠΈΡΡΠ²Π°Π΅Ρ ΠΌΠ½ΠΎΠΆΠ΅ΡΡΠ²ΠΎ ΡΠ°ΠΊΡΠΎΡΠΎΠ², Π² ΡΠΎΠΌ ΡΠΈΡΠ»Π΅ ΠΈ ΡΠ΅Π°Π»ΡΠ½ΡΡ ΡΡΠ»ΠΎΠ²ΠΈΠΉ ΠΎΡΠ²Π΅ΡΠ΅Π½Π½ΠΎΡΡΠΈ. ΠΠ±ΡΠ°Π·ΡΡ ΠΊΡΠ°ΡΠΊΠΈ, ΠΊΠΎΡΠΎΡΡΠ΅ ΠΏΡΠ΅Π΄Π»Π°Π³Π°ΡΡ Π² ΡΠ°Π»ΠΎΠ½Π°Ρ ΠΈ ΠΌΠ°Π³Π°Π·ΠΈΠ½Π°Ρ , ΡΠΎΠΆΠ΅ Π½Π΅ ΡΠΌΠΎΠ³ΡΡ Π΄Π°ΡΡ ΠΏΡΠ΅Π΄ΡΡΠ°Π²Π»Π΅Π½ΠΈΠ΅ ΠΎ ΡΠΎΠΌ, ΠΊΠ°ΠΊ ΡΠ°ΠΊΠΎΠΉ ΠΎΡΡΠ΅Π½ΠΎΠΊ Π±ΡΠ΄Π΅Ρ ΡΠΌΠΎΡΡΠ΅ΡΡΡΡ Π½Π° ΠΊΠΎΠ½ΠΊΡΠ΅ΡΠ½ΠΎΠΉ ΡΡΠ΅Π½Π΅. Π’Π΅ΠΌΠ½ΡΠ΅ ΠΈΠ»ΠΈ ΠΏΡΠΎΡΡΠΎ Π½Π°ΡΡΡΠ΅Π½Π½ΡΠ΅ ΡΠΎΠ½Π° ΡΠΈΠ»ΠΈΠΊΠΎΠ½ΠΎΠ²ΡΡ ΠΊΡΠ°ΡΠΎΠΊ Π½Π° Π±ΠΎΠ»ΡΡΠΎΠΉ ΠΏΠΎΠ²Π΅ΡΡ Π½ΠΎΡΡΠΈ ΠΌΠΎΠ³ΡΡ Π²ΡΠ³Π»ΡΠ΄Π΅ΡΡ Π΅ΡΠ΅ Π±ΠΎΠ»Π΅Π΅ Π³Π»ΡΠ±ΠΎΠΊΠΈΠΌΠΈ ΠΈ ΠΈΠ½ΡΠ΅Π½ΡΠΈΠ²Π½ΡΠΌΠΈ, ΡΠ΅ΠΌ Π½Π° ΠΎΠ±ΡΠ°Π·ΡΠ°Ρ .
Π£ Π΄ΠΎΠΌΠΎΠ²Π»Π°Π΄Π΅Π»ΡΡΠ° Π΅ΡΡΡ 2 Π²Π°ΡΠΈΠ°Π½ΡΠ°: ΠΌΠΎΠΆΠ½ΠΎ ΠΊΡΠΏΠΈΡΡ ΡΡΡΡ Π±ΠΎΠ»Π΅Π΅ ΡΠ²Π΅ΡΠ»ΡΡ ΠΊΡΠ°ΡΠΊΡ, ΡΠ΅ΠΌ ΡΠ°, ΡΡΠΎ ΠΏΠΎΠ½ΡΠ°Π²ΠΈΠ»Π°ΡΡ Π½Π° ΠΎΠ±ΡΠ°Π·ΡΠ΅, ΠΈΠ»ΠΈ ΠΏΡΠΈΠΎΠ±ΡΠ΅ΡΡΠΈ ΠΊΡΠ°ΡΠΊΡ 2 Π±Π»ΠΈΠ·ΠΊΠΈΡ ΠΎΡΡΠ΅Π½ΠΊΠΎΠ² β ΠΏΠΎ ΠΎΠ΄Π½ΠΎΠΉ Π±Π°Π½ΠΊΠ΅ ΠΊΠ°ΠΆΠ΄ΠΎΠ³ΠΎ. ΠΡΠ»ΠΈ ΠΎΠ΄ΠΈΠ½ ΠΎΡΡΠ΅Π½ΠΎΠΊ Π½Π΅ ΠΏΠΎΠ½ΡΠ°Π²ΠΈΡΡΡ, ΠΌΠΎΠΆΠ½ΠΎ ΠΏΠΎΠΏΡΠΎΠ±ΠΎΠ²Π°ΡΡ Π΄ΡΡΠ³ΠΎΠΉ. ΠΡΠΈΡΠ΅ΠΌ ΡΠ΅ΡΡΠΈΡΠΎΠ²Π°ΡΡ ΠΈΡ Π½ΡΠΆΠ½ΠΎ ΠΈΠΌΠ΅Π½Π½ΠΎ Π½Π° ΡΡΠ΅Π½Π΅. ΠΠ΅ ΡΡΠΎΠΈΡ Π±ΠΎΡΡΡΡΡ, ΡΡΠΎ ΡΠ°ΠΊΠΈΠ΅ ΡΠΊΡΠΏΠ΅ΡΠΈΠΌΠ΅Π½ΡΡ Π½Π΅ ΡΠ΄Π°ΡΡΡΡ Π·Π°ΠΊΡΡΡΡ: ΠΏΡΠΈ ΡΠ°ΠΊΠΎΠΌ ΡΠΎΡΡΠ°Π²Π΅ ΠΊΡΠ°ΡΠΎΠΊ ΠΏΠ΅ΡΠ²ΡΠΉ ΡΠ»ΠΎΠΉ ΠΏΠΎΠ»Π½ΠΎΡΡΡΡ ΠΏΠ΅ΡΠ΅ΠΊΡΡΠ²Π°Π΅ΡΡΡ Π²ΡΠΎΡΡΠΌ.
Π‘ΠΈΠ»ΠΈΠΊΠΎΠ½ΠΎΠ²ΡΠ΅ ΠΊΡΠ°ΡΠΊΠΈ: ΡΡΡΠΎΠΉΡΠΈΠ²ΠΎΡΡΡ ΠΊ Π·Π°Π³ΡΡΠ·Π½Π΅Π½ΠΈΡ
Π₯ΠΎΡΡ ΠΌΠ½ΠΎΠ³ΠΈΠ΅ ΡΡΠΈΡΠ°ΡΡ, ΡΡΠΎΒ ΡΠ°ΡΠ°Π΄Π½Π°ΡΒ ΠΊΡΠ°ΡΠΊΠ°Β Π½Π°Β ΡΠΈΠ»ΠΈΠΊΠΎΠ½ΠΎΠ²ΠΎΠΉΒ ΠΎΡΠ½ΠΎΠ²Π΅Β ΡΠΎΡΠΌΠΈΡΡΠ΅Ρ ΠΏΠΎΠ²Π΅ΡΡ Π½ΠΎΡΡΡ, ΠΊΠΎΡΠΎΡΠ°Ρ ΡΠΎΠ²Π΅ΡΡΠ΅Π½Π½ΠΎ Π½Π΅ ΠΏΠ°ΡΠΊΠ°Π΅ΡΡΡ, Π½Π° ΡΠ°ΠΌΠΎΠΌ Π΄Π΅Π»Π΅ ΡΡΠΎ Π½Π΅ ΡΠ°ΠΊ. ΠΠ°Π³ΡΡΠ·Π½ΡΡΡΡΡ Π²ΡΠ΅ ΠΏΠΎΠ²Π΅ΡΡ Π½ΠΎΡΡΠΈ Π½Π΅Π·Π°Π²ΠΈΡΠΈΠΌΠΎ ΠΎΡ ΡΠΎΠ³ΠΎ, ΠΊΠ°ΠΊΠΎΠΉ ΠΊΡΠ°ΡΠΊΠΎΠΉ ΠΎΠ½ΠΈ ΠΎΠΊΡΠ°ΡΠ΅Π½Ρ. ΠΡΠΎΡΡΠΎ Π΅ΡΡΡ ΠΊΡΠ°ΡΠΊΠΈ, ΡΠΎΡΠΌΠΈΡΡΡΡΠΈΠ΅ Π»ΡΡΡΡΡ Π·Π°ΡΠΈΡΡ. ΠΡ ΡΡΠΎΠΈΡ Π²ΡΠ±ΠΈΡΠ°ΡΡ Π΄Π»Ρ Π΄ΠΎΠΌΠΎΠ², ΡΠ°ΡΠ°Π΄Ρ ΠΊΠΎΡΠΎΡΡΡ Π²ΡΡ ΠΎΠ΄ΡΡ Π½Π° ΡΠ»ΠΈΡΠ½ΡΠ΅ ΠΌΠ°Π³ΠΈΡΡΡΠ°Π»ΠΈ Ρ ΠΈΠ½ΡΠ΅Π½ΡΠΈΠ²Π½ΡΠΌ Π΄Π²ΠΈΠΆΠ΅Π½ΠΈΠ΅ΠΌ ΡΡΠ°Π½ΡΠΏΠΎΡΡΠ°. ΠΡΠ»ΠΈ ΡΠ°ΠΊΠΈΠ΅ ΡΠ°ΡΠ°Π΄Ρ ΠΏΠΎΠΊΡΠ°ΡΠΈΡΡ ΠΊΡΠ°ΡΠΊΠΎΠΉ, Π½Π΅ΠΎΠ±Π»Π°Π΄Π°ΡΡΠ΅ΠΉ ΡΠΏΠΎΡΠΎΠ±Π½ΠΎΡΡΡΡ ΠΊ ΡΠ°ΠΌΠΎΠΎΡΠΈΡΠ΅Π½ΠΈΡ, ΡΠΎ ΡΠΆΠ΅ ΡΠ΅ΡΠ΅Π· ΠΏΠΎΠ»Π³ΠΎΠ΄Π° Π΄ΠΎΠΌ ΡΡΠ°Π½Π΅Ρ ΡΠ΅ΡΡΠΌ, ΠΈ ΠΈΠ·Π±Π°Π²ΠΈΡΡΡΡ ΠΎΡ ΡΡΠΎΠ³ΠΎ ΠΎΡΡΠ΅Π½ΠΊΠ° Π±ΡΠ΄Π΅Ρ ΠΎΡΠ΅Π½Ρ ΡΡΠΆΠ΅Π»ΠΎ. ΠΡΠ»ΠΈ ΠΆΠ΅ ΠΏΠΎΠΊΡΠ°ΡΠΈΡΡ ΡΠ°ΡΠ°Π΄ ΠΊΡΠ°ΡΠΊΠΎΠΉ, ΠΊΠΎΡΠΎΡΠ°Ρ ΡΠΏΠΎΡΠΎΠ±Π½Π° ΠΊ ΡΠ°ΠΌΠΎΠΎΡΠΈΡΠ΅Π½ΠΈΡ, ΡΠΎ Π΄Π°ΠΆΠ΅ Π½Π΅Π±ΠΎΠ»ΡΡΠΎΠΉ Π΄ΠΎΠΆΠ΄Ρ ΡΠΌΠΎΠΆΠ΅Ρ Π²Π΅ΡΠ½ΡΡΡ ΡΡΠ΅Π½Π°ΠΌ ΠΏΠ΅ΡΠ²ΠΎΠ½Π°ΡΠ°Π»ΡΠ½ΡΠΉ ΠΎΡΡΠ΅Π½ΠΎΠΊ.

Π‘ΠΈΠ»ΠΈΠΊΠΎΠ½ΠΎΠ²ΡΠ΅ ΠΊΡΠ°ΡΠΊΠΈ ΡΠΏΠΎΡΠΎΠ±Π½Ρ ΠΊ ΡΠ°ΠΌΠΎΠΎΡΠΈΡΠ΅Π½ΠΈΡ
Π‘ΠΈΠ»ΠΈΠΊΠΎΠ½ΠΎΠ²ΡΠ΅ ΠΊΡΠ°ΡΠΊΠΈ ΠΊΠ°ΠΊ ΡΠ°Π· ΠΈ ΠΎΠ±Π»Π°Π΄Π°ΡΡ ΡΠΏΠΎΡΠΎΠ±Π½ΠΎΡΡΡΡ ΠΊ ΡΠ°ΠΌΠΎΠΎΡΠΈΡΠ΅Π½ΠΈΡ. ΠΠ΅ΠΊΠΎΡΠΎΡΡΠ΅ ΠΏΡΠΎΠΈΠ·Π²ΠΎΠ΄ΠΈΡΠ΅Π»ΠΈ Π΄Π°ΠΆΠ΅ Π½Π°Π·ΡΠ²Π°ΡΡ ΡΡΠΎ ΠΈΡ ΡΠ²ΠΎΠΉΡΡΠ²ΠΎ ΡΡΡΠ΅ΠΊΡΠΎΠΌ Π»ΠΎΡΠΎΡΠ°. ΠΡΠΎ Π½Π΅ΠΏΡΠΎΡΡΠΎ ΠΏΠΎΡΡΠΈΡΠ΅ΡΠΊΠΎΠ΅ ΡΡΠ°Π²Π½Π΅Π½ΠΈΠ΅. ΠΠ΅Π»ΠΎ Π² ΡΠΎΠΌ, ΡΡΠΎ Π½Π΅ΡΠΌΠΎΡΡΡ Π½Π° ΡΠΎ, ΡΡΠΎ Π»ΠΎΡΠΎΡ ΡΠ²Π»ΡΠ΅ΡΡΡ Π²ΠΎΠ΄ΡΠ½ΡΠΌ ΡΠ°ΡΡΠ΅Π½ΠΈΠ΅ΠΌ, Π΅Π³ΠΎ Π»ΠΈΡΡΡΡ Π½ΠΈΠΊΠΎΠ³Π΄Π° Π½Π΅ Π½Π°ΠΌΠΎΠΊΠ°ΡΡ. Π Π²ΡΠ΅ ΠΏΠΎΡΠΎΠΌΡ, ΡΡΠΎ ΠΊΠ°ΠΏΠ»ΠΈ Π²ΠΎΠ΄Ρ ΡΠΊΠ°ΡΡΠ²Π°ΡΡΡΡ Ρ ΠΏΠΎΠ²Π΅ΡΡ Π½ΠΎΡΡΠΈ, Π·Π°Ρ Π²Π°ΡΡΠ²Π°Ρ ΠΈ Π²ΡΠ΅ ΠΎΠΊΠ°Π·Π°Π²ΡΠΈΠ΅ΡΡ Π½Π° ΠΈΡ ΠΏΡΡΠΈ ΡΠ°ΡΡΠΈΡΡ Π·Π°Π³ΡΡΠ·Π½Π΅Π½ΠΈΡ. ΠΠ±ΡΡΡΠ½ΡΠ΅ΡΡΡ ΡΡΠΎ ΠΎΡΠΎΠ±ΠΎΠΉ ΡΡΡΡΠΊΡΡΡΠΎΠΉ Π»ΠΈΡΡΠ°. Π’ΠΎ ΠΆΠ΅ ΠΏΡΠΎΠΈΡΡ ΠΎΠ΄ΠΈΡ ΠΈ Ρ ΠΏΠΎΠ²Π΅ΡΡ Π½ΠΎΡΡΡΡ, ΠΎΠΊΡΠ°ΡΠ΅Π½Π½ΠΎΠΉ ΡΠΈΠ»ΠΈΠΊΠΎΠ½ΠΎΠ²ΠΎΠΉ ΠΊΡΠ°ΡΠΊΠΎΠΉ.
ΠΠ»Π°Π³ΠΎΠ΄Π°ΡΡ ΡΠ²ΠΎΠ΅ΠΌΡ Ρ ΠΈΠΌΠΈΡΠ΅ΡΠΊΠΎΠΌΡ ΡΠΎΡΡΠ°Π²Ρ, ΡΡΠ° ΠΊΡΠ°ΡΠΊΠ° ΡΠΎΡΠΌΠΈΡΡΠ΅Ρ Π½Π° ΠΏΠΎΠ²Π΅ΡΡ Π½ΠΎΡΡΠΈ ΡΡΠ΅Π½Ρ Π²ΠΎΠ΄ΠΎΠΎΡΡΠ°Π»ΠΊΠΈΠ²Π°ΡΡΡΡ ΠΏΠ»Π΅Π½ΠΊΡ. ΠΠΌΠ΅Π½Π½ΠΎ ΠΎΠ½Π° Π½Π΅ Π΄Π°Π΅Ρ Π²Π»Π°Π³Π΅ ΠΏΡΠΎΠ½ΠΈΠΊΠ°ΡΡ ΠΏΠΎΠ΄ ΠΊΡΠ°ΡΠΎΡΠ½ΡΠΉ ΡΠ»ΠΎΠΉ, ΠΈ ΠΊΠ°ΠΏΠ»ΠΈ Π²ΠΎΠ΄Ρ ΠΏΡΠΎΡΡΠΎ ΡΡΠ΅ΠΊΠ°ΡΡ ΠΏΠΎ ΠΏΠΎΠ²Π΅ΡΡ Π½ΠΎΡΡΠΈ, ΡΠΌΡΠ²Π°Ρ Π²ΡΠ΅ Π·Π°Π³ΡΡΠ·Π½Π΅Π½ΠΈΡ.
ΠΠ½ΡΠ΅ΡΠ΅ΡΠ½ΠΎ, ΡΡΠΎ ΡΠ°ΠΊΠΈΠ΅ Π²ΠΎΠ΄ΠΎΠΎΡΡΠ°Π»ΠΊΠΈΠ²Π°ΡΡΠΈΠ΅ ΡΠ²ΠΎΠΉΡΡΠ²Π° ΠΊΡΠ°ΡΠΊΠΈ ΠΏΡΠΎΡΠ²Π»ΡΡΡΡΡ Π½Π΅ ΡΡΠ°Π·Ρ. ΠΠ°ΠΊ ΠΏΡΠ°Π²ΠΈΠ»ΠΎ, ΠΏΡΠΎΡ ΠΎΠ΄ΠΈΡ ΠΎΠΊΠΎΠ»ΠΎ ΠΌΠ΅ΡΡΡΠ° (Π² ΡΡΠ΅Π΄Π½Π΅ΠΌ, 28 Π΄Π½Π΅ΠΉ, ΠΊΠ°ΠΊ ΠΏΠΎΠΊΠ°Π·ΡΠ²Π°ΡΡ ΠΈΡΡΠ»Π΅Π΄ΠΎΠ²Π°Π½ΠΈΡ), ΠΏΡΠ΅ΠΆΠ΄Π΅ ΡΠ΅ΠΌ ΠΊΡΠ°ΡΠΎΡΠ½Π°Ρ ΠΏΠ»Π΅Π½ΠΊΠ° ΡΡΠ°Π½Π΅Ρ Π΄ΠΎΡΡΠ°ΡΠΎΡΠ½ΠΎ ΠΏΡΠΎΡΠ½ΠΎΠΉ ΠΈ Π½Π΅ΠΏΡΠΎΠ½ΠΈΡΠ°Π΅ΠΌΠΎΠΉ. Π‘ΠΈΠ»ΠΈΠΊΠ°ΡΠ½ΡΠ΅ ΠΊΡΠ°ΡΠΊΠΈ ΡΠΎΠΆΠ΅ ΠΎΠ±Π»Π°Π΄Π°ΡΡ ΠΏΠΎΠ΄ΠΎΠ±Π½ΡΠΌΠΈ ΡΠ²ΠΎΠΉΡΡΠ²Π°ΠΌΠΈ. ΠΠΎ Ρ ΡΠΈΠ»ΠΈΠΊΠΎΠ½ΠΎΠ²ΡΡ ΠΊΡΠ°ΡΠΎΠΊ ΡΡΠΎΡ ΠΏΠΎΠΊΠ°Π·Π°ΡΠ΅Π»Ρ Π²ΡΡΠ΅. ΠΠ΅Π»ΠΎ Π² ΡΠΎΠΌ, ΡΡΠΎ ΡΠΏΠΎΡΠΎΠ±Π½ΠΎΡΡΡ ΠΊΡΠ°ΡΠΎΠΊ ΠΊ ΡΠ°ΠΌΠΎΠΎΡΠΈΡΠ΅Π½ΠΈΡ Π½Π°ΠΏΡΡΠΌΡΡ Π·Π°Π²ΠΈΡΠΈΡ ΠΎΡ ΠΊΠΎΠ»ΠΈΡΠ΅ΡΡΠ²Π° ΡΠΌΠΎΠ», ΠΊΠΎΡΠΎΡΡΠ΅ ΡΠΎΠ΄Π΅ΡΠΆΠ°ΡΡΡ Π² ΠΈΡ ΡΠΎΡΡΠ°Π²Π΅. Π Π·Π΄Π΅ΡΡ ΡΠΈΠ»ΠΈΠΊΠΎΠ½ΠΎΠ²ΡΠ΅ ΠΊΡΠ°ΡΠΊΠΈ ΡΠ²Π»ΡΡΡΡΡ Π±Π΅ΡΡΠΏΠΎΡΠ½ΡΠΌ Π»ΠΈΠ΄Π΅ΡΠΎΠΌ. Π ΡΠΎΠΆΠ°Π»Π΅Π½ΠΈΡ, ΠΏΡΠΎΠΈΠ·Π²ΠΎΠ΄ΠΈΡΠ΅Π»ΠΈ Π½Π΅ ΡΠΊΠ°Π·ΡΠ²Π°ΡΡ Π½Π° ΡΠΏΠ°ΠΊΠΎΠ²ΠΊΠ΅ ΠΊΠΎΠ»ΠΈΡΠ΅ΡΡΠ²ΠΎ ΡΠΌΠΎΠ» Π² ΠΊΡΠ°ΡΠΊΠ°Ρ ΡΠΎΠ³ΠΎ ΠΈΠ»ΠΈ ΠΈΠ½ΠΎΠ³ΠΎ ΡΠΈΠΏΠ°, Π½ΠΎ Π² ΡΠ΅Π»ΠΎΠΌ ΠΌΠΎΠΆΠ½ΠΎ Π²ΡΠ±ΡΠ°ΡΡ Π»ΡΠ±ΠΎΠΉ ΡΠΈΠ»ΠΈΠΊΠΎΠ½ΠΎΠ²ΡΠΉ ΡΠΎΡΡΠ°Π² Π΄Π»Ρ ΠΎΠΊΡΠ°ΡΠΊΠΈ ΡΠ°ΡΠ°Π΄Π°, ΠΈ ΠΎΠ½ Π±ΡΠ΄Π΅Ρ ΠΎΠ±Π»Π°Π΄Π°ΡΡ Π²ΡΡΠΎΠΊΠΈΠΌΠΈ ΡΠΏΠΎΡΠΎΠ±Π½ΠΎΡΡΡΠΌΠΈ ΠΊ ΡΠ°ΠΌΠΎΠΎΡΠΈΡΠ΅Π½ΠΈΡ.
ΠΡΡΡ Π΅ΡΠ΅ ΠΎΠ΄ΠΈΠ½ Π²Π°ΠΆΠ½ΡΠΉ ΠΌΠΎΠΌΠ΅Π½Ρ: ΡΠΏΠΎΡΠΎΠ±Π½ΠΎΡΡΡ ΠΊΡΠ°ΡΠΎΠΊ ΠΊ ΡΠ°ΠΌΠΎΠΎΡΠΈΡΠ΅Π½ΠΈΡ ΡΠ°ΡΠΏΡΠΎΡΡΡΠ°Π½ΡΠ΅ΡΡΡ Π΄Π°Π»Π΅ΠΊΠΎ Π½Π΅ Π½Π° Π²ΡΠ΅ ΡΠΈΠΏΡ Π·Π°Π³ΡΡΠ·Π½Π΅Π½ΠΈΠΉ. ΠΠ°ΠΏΡΠΈΠΌΠ΅Ρ, Π΄ΠΎΠΆΠ΄Ρ ΠΌΠΎΠΆΠ΅Ρ ΡΠΌΡΡΡ ΠΏΡΠ»Ρ, Π½ΠΎ Π½Π΅ ΠΌΠ°ΡΠ»ΡΠ½ΡΠ΅ ΠΏΡΡΠ½Π°. Π ΡΠ°ΠΊΠΈΡ ΡΠ»ΡΡΠ°ΡΡ ΡΠ°ΡΠ°Π΄ ΠΏΡΠΈΠ΄Π΅ΡΡΡ ΡΠΈΡΡΠΈΡΡ. ΠΠ΅ Π²ΡΠ΅ ΡΠΎΡΡΠ°Π²Ρ ΡΡΡ ΠΏΡΠΎΡΠ΅Π΄ΡΡΡ Π²ΡΠ΄Π΅ΡΠΆΠΈΠ²Π°ΡΡ. ΠΠΎΠ²Π΅ΡΡ Π½ΠΎΡΡΡ, ΠΎΠΊΡΠ°ΡΠ΅Π½Π½ΡΡ ΡΠΈΠ»ΠΈΠΊΠΎΠ½ΠΎΠ²ΡΠΌΠΈ ΠΊΡΠ°ΡΠΊΠ°ΠΌΠΈ, ΡΠΈΡΡΠΈΡΡ ΠΌΠΎΠΆΠ½ΠΎ.
ΠΠ»Ρ ΠΊΠ°ΠΊΠΈΡ ΡΠ»ΡΡΠ°Π΅Π² ΠΏΠΎΠ΄Ρ ΠΎΠ΄ΠΈΡ ΡΠΈΠ»ΠΈΠΊΠΎΠ½ΠΎΠ²Π°Ρ ΠΊΡΠ°ΡΠΊΠ°?
Π£ ΠΊΠ°ΠΆΠ΄ΠΎΠ³ΠΎ ΠΊΡΠ°ΡΡΡΠ΅Π³ΠΎ ΡΠΎΡΡΠ°Π²Π° ΡΠ²ΠΎΡ ΡΡΠ΅ΡΠ° ΠΏΡΠΈΠΌΠ΅Π½Π΅Π½ΠΈΡ.Β Π‘ΠΈΠ»ΠΈΠΊΠΎΠ½ΠΎΠ²Π°ΡΒ ΠΊΡΠ°ΡΠΊΠ°Β Π΄Π»ΡΒ ΡΠ°ΡΠ°Π΄Π°Β ΠΎΠ±Π»Π°Π΄Π°Π΅Ρ Π²ΡΡΠΎΠΊΠΎΠΉ ΡΡΡΠΎΠΉΡΠΈΠ²ΠΎΡΡΡΡ ΠΊ Π²ΠΎΠ·Π΄Π΅ΠΉΡΡΠ²ΠΈΡ ΡΠ°Π·Π»ΠΈΡΠ½ΡΡ Ρ ΠΈΠΌΠΈΡΠ΅ΡΠΊΠΈΡ ΡΠΎΠ΅Π΄ΠΈΠ½Π΅Π½ΠΈΠΉ. ΠΠΎ ΡΡΠΎΠΌΡ ΠΏΠΎΠΊΠ°Π·Π°ΡΠ΅Π»Ρ ΠΎΠ½Π° ΠΏΡΠ΅Π²ΠΎΡΡ ΠΎΠ΄ΠΈΡ Π²ΡΠ΅ ΠΎΡΡΠ°Π»ΡΠ½ΡΠ΅ ΡΠΈΠΏΡ ΠΊΡΠ°ΡΠΎΠΊ. Π₯ΠΎΡΡ ΠΎΠ½Π° ΡΠ½ΠΈΠ²Π΅ΡΡΠ°Π»ΡΠ½Π°, ΠΈ Π΅Ρ ΠΌΠΎΠΆΠ½ΠΎ ΠΎΠΊΡΠ°ΡΠΈΠ²Π°ΡΡ ΠΏΠΎΠ²Π΅ΡΡ Π½ΠΎΡΡΠΈ ΠΏΡΠ°ΠΊΡΠΈΡΠ΅ΡΠΊΠΈ Π»ΡΠ±ΡΡ Π΄ΠΎΠΌΠΎΠ², ΡΡΠΎ ΡΡΡΡ Π»ΠΈ Π½Π΅ Π΅Π΄ΠΈΠ½ΡΡΠ²Π΅Π½Π½ΡΠΉ ΡΠΎΡΡΠ°Π², ΠΊΠΎΡΠΎΡΡΠΉ ΠΌΠΎΠΆΠ½ΠΎ ΠΏΡΠΈΠΌΠ΅Π½ΡΡΡ Π² ΠΏΡΠΎΠΌΡΡΠ»Π΅Π½Π½ΡΡ Π·ΠΎΠ½Π°Ρ , Π³Π΄Π΅ Π² Π°ΡΠΌΠΎΡΡΠ΅ΡΡ ΠΏΠΎΠΏΠ°Π΄Π°ΡΡ Π²ΡΠ±ΡΠΎΡΡ Ρ ΠΏΡΠ΅Π΄ΠΏΡΠΈΡΡΠΈΠΉ, ΠΈ Π΄Π°ΠΆΠ΅ Π²Π΅ΡΠΎΡΡΠ½Ρ ΠΊΠΈΡΠ»ΠΎΡΠ½ΡΠ΅ ΠΎΡΠ°Π΄ΠΊΠΈ. Π£ΡΡΠΎΠΉΡΠΈΠ²ΠΎΡΡΡΡ ΠΊ ΠΈΡ Π²ΠΎΠ·Π΄Π΅ΠΉΡΡΠ²ΠΈΡΠΌ ΠΎΠ±Π»Π°Π΄Π°ΡΡ Π»ΡΠ±ΡΠ΅ ΠΏΠΎΠΊΡΡΡΠΈΡ, Π² ΡΠΎΡΡΠ°Π² ΠΊΠΎΡΠΎΡΡΡ Π²Ρ ΠΎΠ΄ΡΡ ΡΠΈΠ»ΠΈΠΊΠΎΠ½ΠΎΠ²ΡΠ΅ ΡΠΌΠΎΠ»Ρ. ΠΠΎ Ρ ΡΠΈΡΡΡΡ ΡΠΈΠ»ΠΈΠΊΠΎΠ½ΠΎΠ²ΡΡ ΠΊΡΠ°ΡΠΎΠΊ ΡΠΎΠΏΡΠΎΡΠΈΠ²Π»ΡΠ΅ΠΌΠΎΡΡΡ ΠΊ Π²ΠΎΠ·Π΄Π΅ΠΉΡΡΠ²ΠΈΡ ΡΠ°ΠΊΠΈΡ Ρ ΠΈΠΌΠΈΠΊΠ°ΡΠΎΠ² Π²ΡΡΠ΅.
ΠΡΠΈΠΌΠ΅Π½Π΅Π½ΠΈΠ΅ ΡΠΈΠ»ΠΈΠΊΠΎΠ½ΠΎΠ²ΠΎΠΉ ΠΊΡΠ°ΡΠΊΠΈ ΠΎΡΠ½ΠΎΠ²ΡΠ²Π°Π΅ΡΡΡ Π½Π° Π»Π΅Π³ΠΊΠΎΡΡΠΈ Π΅Π΅ Π½Π°Π½Π΅ΡΠ΅Π½ΠΈΡ ΠΈ ΡΡΡΠΎΠΉΡΠΈΠ²ΠΎΡΡΠΈ ΠΊ Π»ΡΠ±ΡΠΌ Π²ΠΎΠ·Π΄Π΅ΠΉΡΡΠ²ΠΈΡΠΌ
Π‘ΡΡΠ΅ΡΡΠ²ΡΠ΅Ρ Π΅ΡΠ΅ ΠΎΠ΄ΠΈΠ½ Π²Π°ΠΆΠ½ΡΠΉ ΠΌΠΎΠΌΠ΅Π½Ρ β ΡΡΠΎ ΠΎΡΠ½ΠΎΠ²Π°Π½ΠΈΠ΅, Π½Π° ΠΊΠΎΡΠΎΡΠΎΠ΅ Π±ΡΠ΄Π΅Ρ Π½Π°Π½ΠΎΡΠΈΡΡΡΡ ΠΊΡΠ°ΡΠΊΠ°. Π‘ΠΈΠ»ΠΈΠΊΠΎΠ½ΠΎΠ²ΡΠ΅ ΡΠΎΡΡΠ°Π²Ρ Π΄Π΅ΠΉΡΡΠ²ΠΈΡΠ΅Π»ΡΠ½ΠΎ ΡΠ½ΠΈΠ²Π΅ΡΡΠ°Π»ΡΠ½Ρ. ΠΡ ΠΌΠΎΠΆΠ½ΠΎ Π½Π°Π½ΠΎΡΠΈΡΡ ΠΏΠΎΠ²Π΅ΡΡ ΡΠ΅ΠΌΠ΅Π½ΡΠ½ΠΎ-ΠΈΠ·Π²Π΅ΡΡΠΊΠΎΠ²ΡΡ ΠΈ ΠΏΡΠΎΡΡΠΎ ΡΠ΅ΠΌΠ΅Π½ΡΠ½ΡΡ ΠΈΠ»ΠΈ ΠΈΠ·Π²Π΅ΡΡΠΊΠΎΠ²ΡΡ ΡΡΡΠΊΠ°ΡΡΡΠΎΠΊ, Π΄Π»Ρ Π½ΠΈΡ ΠΏΠΎΠ΄Ρ ΠΎΠ΄ΠΈΡ Π»ΡΠ±ΠΎΠ΅ ΠΎΡΠ³Π°Π½ΠΈΡΠ΅ΡΠΊΠΎΠ΅ ΠΎΡΠ½ΠΎΠ²Π°Π½ΠΈΠ΅. Π‘ΠΈΠ»ΠΈΠΊΠΎΠ½ΠΎΠ²ΡΠ΅ ΠΏΠΎΠΊΡΡΡΠΈΡ Ρ Π²ΡΡΠΎΠΊΠΈΠΌ ΡΠΎΠ΄Π΅ΡΠΆΠ°Π½ΠΈΠ΅ΠΌ ΡΠΌΠΎΠ» ΠΈΡΠΏΠΎΠ»ΡΠ·ΡΡΡ ΠΈ Π΄Π»Ρ Π±Π΅ΡΠΎΠ½Π½ΡΡ ΠΎΡΠ½ΠΎΠ²Π°Π½ΠΈΠΉ ΠΈ ΠΊΠ΅ΡΠ°ΠΌΠΈΡΠ΅ΡΠΊΠΈΡ ΠΊΠΈΡΠΏΠΈΡΠ΅ΠΉ. ΠΠΎ Π½Π° ΡΠΈΠ»ΠΈΠΊΠ°ΡΠ½ΡΠΉ ΠΊΠΈΡΠΏΠΈΡ ΠΈΡ Π½Π΅ Π½Π°Π½ΠΎΡΡΡ, ΡΠ°ΠΊ ΠΆΠ΅, ΠΊΠ°ΠΊ ΠΈ Π½Π° ΡΠΈΠ»ΠΈΠΊΠ°ΡΠ½ΡΠ΅ ΡΡΡΠΊΠ°ΡΡΡΠΊΠΈ. Π ΡΡΠΎΠΌ ΡΠ»ΡΡΠ°Π΅ ΠΏΡΠΈΠΌΠ΅Π½ΡΡΡ ΠΏΠΎΠ»ΠΈΠΊΡΠ΅ΠΌΠ½ΠΈΠ΅Π²ΡΠ΅ ΠΈΠ»ΠΈ ΡΠΈΠ»ΠΈΠΊΠ°ΡΠ½ΡΠ΅ ΡΠ°ΡΠ°Π΄Π½ΡΠ΅ ΠΊΡΠ°ΡΠΊΠΈ.
ΠΠ°ΠΊ ΡΡ Π°ΠΆΠΈΠ²Π°ΡΡ Π·Π° ΠΏΠΎΠ²Π΅ΡΡ Π½ΠΎΡΡΡΡ, ΠΎΠΊΡΠ°ΡΠ΅Π½Π½ΠΎΠΉ ΡΠΈΠ»ΠΈΠΊΠΎΠ½ΠΎΠ²ΠΎΠΉ ΠΊΡΠ°ΡΠΊΠΎΠΉ
ΠΠΎΠ²Π΅ΡΡ Π½ΠΎΡΡΡ, ΠΎΠΊΡΠ°ΡΠ΅Π½Π½Π°Ρ ΡΠΈΠ»ΠΈΠΊΠΎΠ½ΠΎΠ²ΡΠΌ ΡΠΎΡΡΠ°Π²ΠΎΠΌ, Π½Π΅ ΡΡΠ΅Π±ΡΠ΅Ρ ΠΎΡΠΎΠ±ΠΎΠ³ΠΎ ΡΡ ΠΎΠ΄Π°. ΠΠΎΠΆΠ΄Ρ ΡΠΌΡΠ²Π°Π΅Ρ Ρ Π½Π΅Π΅ ΠΏΡΠ»Ρ ΠΈ ΠΊΠΎΠΏΠΎΡΡ ΠΎΡ Π²ΡΡ Π»ΠΎΠΏΠΎΠ² Π°Π²ΡΠΎΡΡΠ°Π½ΡΠΏΠΎΡΡΠ°, ΡΡΠΎ ΠΏΠΎΠ·Π²ΠΎΠ»ΡΠ΅Ρ ΠΏΠΎΠ΄Π΄Π΅ΡΠΆΠΈΠ²Π°ΡΡ ΡΠ°ΡΠ°Π΄ Π² ΡΠΈΡΡΠΎΡΠ΅. ΠΡΠ»ΠΈ Π΄ΠΎΠΆΠ΄Ρ Π΄Π°Π²Π½ΠΎ Π½Π΅ Π±ΡΠ»ΠΎ, ΠΌΠΎΠΆΠ½ΠΎ ΠΏΡΠΎΡΡΠΎ ΠΏΠΎΠ»ΠΈΡΡ ΡΡΠ΅Π½Ρ Π²ΠΎΠ΄ΠΎΠΉ ΠΈΠ· ΡΠ»Π°Π½Π³Π°, ΠΈ Π·Π°Π³ΡΡΠ·Π½Π΅Π½ΠΈΡ Π±ΡΠ΄ΡΡ ΡΠΌΡΡΡ.

Π£Ρ ΠΎΠ΄ Π·Π° ΠΎΠΊΡΠ°ΡΠ΅Π½Π½ΠΎΠΉ ΠΏΠΎΠ²Π΅ΡΡ Π½ΠΎΡΡΡΡ ΠΎΡΡΡΠ΅ΡΡΠ²Π»ΡΠ΅ΡΡΡ ΠΎΠ±ΡΠΊΠ½ΠΎΠ²Π΅Π½Π½ΡΠΌ ΠΌΡΡΡΠ΅ΠΌ Π²ΠΎΠ΄ΠΎΠΉ
Π‘Π»ΠΎΠΆΠ½Π΅Π΅ Π²ΠΎΡΡΡΠ°Π½Π°Π²Π»ΠΈΠ²Π°ΡΡ ΠΊΡΠ°ΡΠΎΡΠ½ΠΎΠ΅ ΠΏΠΎΠΊΡΡΡΠΈΠ΅. Π₯ΠΎΡΡ ΡΡΠΎΡ ΡΠΎΡΡΠ°Π² ΡΠΎΡΠΌΠΈΡΡΠ΅Ρ Π΄ΠΎΠ²ΠΎΠ»ΡΠ½ΠΎ ΠΏΡΠΎΡΠ½ΡΡ ΠΈ Π΄ΠΎΠ»Π³ΠΎΠ²Π΅ΡΠ½ΡΡ ΠΏΠ»Π΅Π½ΠΊΡ, ΠΊ ΡΠΎΠΆΠ°Π»Π΅Π½ΠΈΡ, ΡΠΈΠ»ΡΠ½ΡΠ΅ ΠΌΠ΅Ρ
Π°Π½ΠΈΡΠ΅ΡΠΊΠΈΠ΅ Π²ΠΎΠ·Π΄Π΅ΠΉΡΡΠ²ΠΈΡ ΠΌΠΎΠ³ΡΡ ΠΎΡΡΠ°Π²ΠΈΡΡ Π½Π° ΠΏΠΎΠ²Π΅ΡΡ
Π½ΠΎΡΡΠΈ ΡΠ°ΡΠ°ΠΏΠΈΠ½Ρ, ΡΠ΅ΡΠ΅Π· ΠΊΠΎΡΠΎΡΡΠ΅ Π±ΡΠ΄Π΅Ρ Π²ΠΈΠ΄Π½Π° ΠΎΡΠ½ΠΎΠ²Π°. ΠΠΎΠ΄ΠΎΠ±ΡΠ°ΡΡ ΡΠΎΡΠ½ΠΎ ΡΠ°ΠΊΠΎΠΉ ΠΆΠ΅ ΡΠ²Π΅Ρ, Π±ΡΠ΄Π΅Ρ Π΄ΠΎΠ²ΠΎΠ»ΡΠ½ΠΎ ΡΠ»ΠΎΠΆΠ½ΠΎ. ΠΠΎΡΡΠΎΠΌΡ Π½ΡΠΆΠ½ΠΎ Π²Π·ΡΡΡ Π±Π΅Π»ΡΡ ΡΠ°ΡΠ°Π΄Π½ΡΡ ΡΠΈΠ»ΠΈΠΊΠΎΠ½ΠΎΠ²ΡΡ ΠΊΡΠ°ΡΠΊΡ β ΠΎΠΊΠΎΠ»ΠΎ 100 Π³, ΠΏΠ΅ΡΠ΅Π»ΠΈΡΡΡ
Π² ΠΎΡΠ΄Π΅Π»ΡΠ½ΡΡ Π΅ΠΌΠΊΠΎΡΡΡ. Π’ΡΠ΄Π° ΠΌΠΎΠΆΠ½ΠΎ ΠΊΠ°ΠΏΠ°ΡΡ ΠΏΠΈΠ³ΠΌΠ΅Π½Ρ (ΠΊΠΎΠ»Π΅Ρ), Π±ΡΠΊΠ²Π°Π»ΡΠ½ΠΎ ΠΏΠΎ ΠΎΠ΄Π½ΠΎΠΉ ΠΊΠ°ΠΏΠ»Π΅ ΠΈ ΡΠ°Π·ΠΌΠ΅ΡΠΈΠ²Π°ΡΡ, ΠΏΠΎΠΊΠ° ΠΎΡΡΠ΅Π½ΠΎΠΊ Π½Π΅ Π±ΡΠ΄Π΅Ρ Π½Π°ΠΏΠΎΠΌΠΈΠ½Π°ΡΡ Π½ΡΠΆΠ½ΡΠΉ. ΠΡΡ ΠΏΡΠΎΠΏΠΎΡΡΠΈΡ Π½ΡΠΆΠ½ΠΎ Π·Π°ΠΏΠΈΡΠ°ΡΡ. ΠΠ°ΡΠ΅ΠΌ ΠΏΠΎΠ»ΡΡΠ΅Π½Π½ΡΠΉ ΠΊΡΠ°ΡΡΡΠΈΠΉ ΡΠΎΡΡΠ°Π² ΠΏΡΠΎΠ±ΡΡΡ Π½Π° ΠΊΠ°ΠΊΠΎΠΌ-ΡΠΎ ΡΡΠ°ΡΡΠΊΠ΅ ΡΡΠ΅Π½Ρ, ΠΊΠΎΡΠΎΡΡΠΉ Π½Π΅ ΡΠ»ΠΈΡΠΊΠΎΠΌ Π·Π°ΠΌΠ΅ΡΠ΅Π½ Ρ ΡΠ»ΠΈΡΡ. Π’ΠΎΠ»ΡΠΊΠΎ Π΅ΡΠ»ΠΈ ΠΏΡΠΎΠ±Ρ ΡΠ΄Π°Π»ΠΈΡΡ, ΠΊΡΠ°ΡΠΊΡ ΠΌΠΎΠΆΠ½ΠΎ ΠΈΡΠΏΠΎΠ»ΡΠ·ΠΎΠ²Π°ΡΡ Π΄Π»Ρ Π²ΠΎΡΡΡΠ°Π½ΠΎΠ²Π»Π΅Π½ΠΈΡ ΠΏΠΎΠ²Π΅ΡΡ
Π½ΠΎΡΡΠΈ. ΠΡΠΎΠ²Π΅ΡΠΈΡΡ, Π½Π°ΡΠΊΠΎΠ»ΡΠΊΠΎ ΠΊΡΠ°ΡΠΊΠ° ΠΏΠΎΠ΄Ρ
ΠΎΠ΄ΠΈΡ ΠΏΠΎ ΡΠ²Π΅ΡΡ, ΠΌΠΎΠΆΠ½ΠΎ ΡΠΎΠ»ΡΠΊΠΎ ΡΠ΅ΡΠ΅Π· 1β1,5 ΡΠ°ΡΠ°, ΠΊΠΎΠ³Π΄Π° ΠΏΠΎΠ²Π΅ΡΡ
Π½ΠΎΡΡΡ Π²ΡΡΠΎΡ
Π½Π΅Ρ.
ΠΡΡΡΠ΅ Π²ΡΠ΅Π³ΠΎ Π΄Π»Ρ ΠΌΠ°ΡΠΊΠΈΡΠΎΠ²ΠΊΠΈ ΡΠ°ΡΠ°ΠΏΠΈΠ½ ΠΈ ΡΡΠ΅ΡΠΈΠ½ Π±ΡΠ°ΡΡ Π΄Π°ΠΆΠ΅ Π½Π΅ ΡΠΈΠ»ΠΈΠΊΠΎΠ½ΠΎΠ²ΡΠΉ, Π° Π°ΠΊΡΠΈΠ» β ΡΠΈΠ»ΠΈΠΊΠΎΠ½ΠΎΠ²ΡΠΉ ΡΠΎΡΡΠ°Π², ΠΏΠΎΡΠΊΠΎΠ»ΡΠΊΡ ΠΎΠ½ Π»ΡΡΡΠ΅ Π»ΠΎΠΆΠΈΡΡΡ. ΠΠ±Π΅ ΡΠ°Π·Π½ΠΎΠ²ΠΈΠ΄Π½ΠΎΡΡΠΈ ΡΠ°Π²Π½ΠΎΠ·Π½Π°ΡΠ½Ρ ΠΏΠΎ ΠΎΡΠ½ΠΎΠ²Π½ΡΠΌ Ρ
Π°ΡΠ°ΠΊΡΠ΅ΡΠΈΡΡΠΈΠΊΠ°ΠΌ.
Β
fasaditut.ru
ΠΠΊΡΠΈΠ»ΠΎΠ²ΠΎ-ΡΠΈΠ»ΠΈΠΊΠΎΠ½ΠΎΠ²ΡΠ΅ ΡΠ°ΡΠ°Π΄Π½ΡΠ΅ ΠΊΡΠ°ΡΠΊΠ° β ΡΠ²ΠΎΠΉΡΡΠ²Π°, ΠΎΡΠΎΠ±Π΅Π½Π½ΠΎΡΡΠΈ, ΠΎΠ±Π»Π°ΡΡΡ ΠΏΡΠΈΠΌΠ΅Π½Π΅Π½ΠΈΡ

ΠΡΠΈ Π²ΡΠ±ΠΎΡΠ΅ ΡΠ°ΡΠ°Π΄Π½ΠΎΠΉ ΠΊΡΠ°ΡΠΊΠΈ Π² ΠΏΠ΅ΡΠ²ΡΡ ΠΎΡΠ΅ΡΠ΅Π΄Ρ ΡΡΠΎΠΈΡ ΠΎΠ±ΡΠ°ΡΠ°ΡΡ Π²Π½ΠΈΠΌΠ°Π½ΠΈΠ΅ Π½Π° Π΅Π΅ ΡΠ²ΠΎΠΉΡΡΠ²Π° ΠΈ ΡΠΈΠΏ ΠΏΠΎΠ²Π΅ΡΡ Π½ΠΎΡΡΠΈ, Π½Π° ΠΊΠΎΡΠΎΡΡΡ ΠΎΠ½Π° Π±ΡΠ΄Π΅Ρ Π½Π°Π½ΠΎΡΠΈΡΡΡΡ. ΠΠΊΡΠΈΠ»ΠΎΠ²ΠΎ-ΡΠΈΠ»ΠΈΠΊΠΎΠ½ΠΎΠ²Π°Ρ ΠΊΡΠ°ΡΠΊΠ° ΡΠΎΠ΄Π΅ΡΠΆΠΈΡ Π² ΡΠ΅Π±Π΅ ΠΎΡΠΎΠ±Π΅Π½Π½ΠΎΡΡΠΈ ΡΡΠ°Π·Ρ Π΄Π²ΡΡ Π²ΠΈΠ΄ΠΎΠ² ΡΠ°ΡΠ°Π΄Π½ΡΡ ΠΏΠΎΠΊΡΡΡΠΈΠΉ β Π°ΠΊΡΠΈΠ»ΠΎΠ²ΠΎΠΉ ΠΈ ΡΠΈΠ»ΠΈΠΊΠΎΠ½ΠΎΠ²ΠΎΠΉ.
Π‘Π²ΠΎΠΉΡΡΠ²ΠΎΠΌ ΠΏΠ΅ΡΠ²ΠΎΠΉ ΡΠ²Π»ΡΠ΅ΡΡΡ Π²ΡΡΠΎΠΊΠ°Ρ ΡΡΡΠΎΠΉΡΠΈΠ²ΠΎΡΡΡ ΠΊ ΠΎΠ±ΡΠ°Π·ΠΎΠ²Π°Π½ΠΈΡ ΡΡΠ΅ΡΠΈΠ½ Π΄Π°ΠΆΠ΅ ΠΏΡΠΈ ΡΡΠ»ΠΎΠ²ΠΈΠΈ ΡΡΠ°Π΄ΠΊΠΈ. Π ΡΠΎΠΌΡ ΠΆΠ΅ Π°ΠΊΡΠΈΠ» ΡΠΏΠΎΡΠΎΠ±ΡΡΠ²ΡΠ΅Ρ ΠΎΡΠ»ΠΈΡΠ½ΠΎΠΉ ΠΏΠ°ΡΠΎΠΏΡΠΎΠ½ΠΈΡΠ°Π΅ΠΌΠΎΡΡΠΈ, ΡΠΎΡ ΡΠ°Π½ΡΡ ΡΠ΅ΠΌ ΡΠ°ΠΌΡΠΌ Π²Π½Π΅ΡΠ½ΠΈΠΉ Π²ΠΈΠ΄ Π΄ΠΎΠΌΠ° Π½Π° Π΄ΠΎΠ»Π³ΠΈΠΉ ΡΡΠΎΠΊ.
ΠΡΠΈΡΡΡΡΡΠ²ΠΈΠ΅ ΡΠΈΠ»ΠΈΠΊΠΎΠ½Π° Π² ΠΊΡΠ°ΡΠΊΠ΅ ΠΎΠ±Π΅ΡΠΏΠ΅ΡΠΈΠ²Π°Π΅Ρ ΡΠΊΠΎΠ»ΠΎΠ³ΠΈΡΠ΅ΡΠΊΠΈ ΡΠΈΡΡΠΎΠ΅ ΠΏΠΎΠΊΡΡΡΠΈΠ΅, ΠΊΠΎΡΠΎΡΠΎΠ΅ ΠΎΠ±Π»Π°Π΄Π°Π΅Ρ ΠΏΠΎΠ²ΡΡΠ΅Π½Π½ΠΎΠΉ ΡΠ»Π°ΡΡΠΈΡΠ½ΠΎΡΡΡΡ. ΠΠ»Π°Π³ΠΎΠ΄Π°ΡΡ ΡΡΠΎΠΌΡ, ΠΊΡΠ°ΡΠΊΠ° Π½Π΅ ΡΠΊΠ°ΠΏΠ»ΠΈΠ²Π°Π΅ΡΡΡ Π½Π° Π²Π°Π»ΠΈΠΊΠ΅ ΠΈ ΠΊΠ°ΠΏΠ°Π΅Ρ Π½Π° ΠΏΠΎΠ». Π ΡΠ΅Π·ΡΠ»ΡΡΠ°ΡΠ΅ Π½Π° ΠΏΠΎΠ²Π΅ΡΡ Π½ΠΎΡΡΠΈ Π½Π΅ Π±ΡΠ΄Π΅Ρ ΠΏΠΎΠ΄ΡΠ΅ΠΊΠΎΠ² ΠΈ Π½Π°ΠΊΠ°ΡΠΎΠ², ΠΎΡΡΠ΅Π³ΠΎ ΠΏΠΎΠΊΡΡΡΠΈΠ΅ ΡΡΠ°Π½ΠΎΠ²ΠΈΡΡΡ ΠΌΠ°ΠΊΡΠΈΠΌΠ°Π»ΡΠ½ΠΎ ΡΠΎΠ²Π½ΡΠΌ.
Π§Π΅ΠΌ ΠΎΡΠ»ΠΈΡΠ°Π΅ΡΡΡ Π°ΠΊΡΠΈΠ»ΠΎΠ²ΠΎ-ΡΠΈΠ»ΠΈΠΊΠΎΠ½ΠΎΠ²Π°Ρ ΠΊΡΠ°ΡΠΊΠ°?
ΠΠ΅ΡΠ²ΠΎΠ΅ ΠΏΡΠ΅ΠΈΠΌΡΡΠ΅ΡΡΠ²ΠΎ Π΄Π°Π½Π½ΠΎΠΉ ΠΏΡΠΎΠ΄ΡΠΊΡΠΈΠΈ Π·Π°ΠΊΠ»ΡΡΠ°Π΅ΡΡΡ Π² Π΅Π³ΠΎ ΡΠ½ΠΈΠ²Π΅ΡΡΠ°Π»ΡΠ½ΠΎΡΡΠΈ. ΠΡΠΎΡ Π²ΠΈΠ΄ ΠΊΡΠ°ΡΠΊΠΈ ΠΌΠΎΠΆΠ½ΠΎ ΠΈΡΠΏΠΎΠ»ΡΠ·ΠΎΠ²Π°ΡΡ Π½Π° ΠΌΠ½ΠΎΠ³ΠΈΡ ΡΠΈΠΏΠ°Ρ ΠΏΠΎΠ²Π΅ΡΡ Π½ΠΎΡΡΠΈ, Π² ΡΠΎΠΌ ΡΠΈΡΠ»Π΅ Π½Π° Π²ΠΈΡΡΠ°ΠΆΠ°Ρ . ΠΡΠΎΡΠΎΠ΅ ΠΎΡΠ»ΠΈΡΠΈΠ΅ ΠΊΡΠΎΠ΅ΡΡΡ Π² ΡΠ½ΠΈΠΊΠ°Π»ΡΠ½ΠΎΠΉ ΠΎΡΠΎΠ±Π΅Π½Π½ΠΎΡΡΠΈ ΡΠΈΠ»ΠΈΠΊΠΎΠ½Π°, Π° ΠΈΠΌΠ΅Π½Π½ΠΎ Π² ΡΠΎΠ·Π΄Π°Π²Π°Π΅ΠΌΠΎΠΌ ΠΈΠΌ Π²ΠΎΠ΄ΠΎΠΎΡΡΠ°Π»ΠΊΠΈΠ²Π°ΡΡΠΈΠΌ ΡΡΡΠ΅ΠΊΡΠ΅, ΠΊΠΎΡΠΎΡΡΠΉ Π·Π°ΡΠΈΡΠ°Π΅Ρ ΠΏΠΎΠ²Π΅ΡΡ Π½ΠΎΡΡΡ ΠΎΡ Π²Π»Π°Π³ΠΈ ΠΈ ΡΠ°Π·Π»ΠΈΡΠ½ΡΡ Π·Π°Π³ΡΡΠ·Π½Π΅Π½ΠΈΠΉ ΠΈ ΡΠΏΠΎΡΠΎΠ±ΡΡΠ²ΡΠ΅Ρ Π΅Π΅ Π±ΡΡΡΡΠΎΠΌΡ ΠΎΡΠΈΡΠ΅Π½ΠΈΡ.
Π’Π΅Ρ Π½ΠΈΡΠ΅ΡΠΊΠΈΠ΅ Ρ Π°ΡΠ°ΠΊΡΠ΅ΡΠΈΡΡΠΈΠΊΠΈ Π°ΠΊΡΠΈΠ»ΠΎΠ²ΠΎ-ΡΠΈΠ»ΠΈΠΊΠΎΠ½ΠΎΠ²ΠΎΠΉ ΠΊΡΠ°ΡΠΊΠΈ
Π¦Π²Π΅Ρ Π²ΠΎΠ΄ΠΎΡΠΌΡΠ»ΡΡΠΈΠΎΠ½Π½ΠΎΠ³ΠΎ ΡΠΎΡΡΠ°Π²Π° ΠΌΠΎΠΆΠ΅Ρ Π±ΡΡΡ ΡΠ°Π·Π½ΡΠΌ, ΠΈ Π²Ρ ΠΌΠΎΠΆΠ΅ΡΠ΅ Π΄ΠΎΠ±ΠΈΡΡΡΡ Π½Π΅ΠΎΠ±Ρ ΠΎΠ΄ΠΈΠΌΠΎΠ³ΠΎ ΠΎΡΡΠ΅Π½ΠΊΠ°, Π΅ΡΠ»ΠΈ Π΄ΠΎΠ±Π°Π²ΠΈΡΠ΅ Π² ΡΠΌΠ΅ΡΡ ΡΠΎΠΎΡΠ²Π΅ΡΡΡΠ²ΡΡΡΠΈΠΉ ΠΊΡΠ°ΡΠΈΡΠ΅Π»Ρ. Π ΠΊΠ°ΡΠ΅ΡΡΠ²Π΅ ΡΠ²ΡΠ·ΡΡΡΠ΅Π³ΠΎ ΠΊΡΠ°ΡΠΊΠΈ ΠΌΠΎΠΆΠ΅Ρ ΠΈΡΠΏΠΎΠ»ΡΠ·ΠΎΠ²Π°ΡΡΡΡ Π½Π΅ ΡΠΎΠ»ΡΠΊΠΎ ΡΠΎΠΏΠΎΠ»ΠΈΠΌΠ΅Ρ Ρ ΡΠΈΠ»ΠΈΠΊΠΎΠ½ΠΎΠΌ, Π½ΠΎ ΠΈ Π°ΠΊΡΠΈΠ»ΠΎΠ²ΠΎ-ΡΠΈΠ»ΠΈΠΊΠΎΠ½ΠΎΠ²Π°Ρ Π΄ΠΈΡΠΏΠ΅ΡΡΠΈΡ. ΠΡΠ΅ Π·Π°Π²ΠΈΡΠΈΡ ΠΎΡ ΠΏΡΠΎΠΈΠ·Π²ΠΎΠ΄ΠΈΡΠ΅Π»Ρ ΠΈ ΡΡΠΎΠΈΠΌΠΎΡΡΡ Π»Π°ΠΊΠΎΠΊΡΠ°ΡΠΎΡΠ½ΠΎΠ³ΠΎ ΡΡΠ΅Π΄ΡΡΠ²Π°.
Π ΠΊΠ°ΡΠ΅ΡΡΠ²Π΅ ΡΠ°Π·Π±Π°Π²ΠΈΡΠ΅Π»Ρ ΠΊΡΠ°ΡΠΊΠΈ ΠΏΡΠΈΠΌΠ΅Π½ΡΠ΅ΡΡΡ Π²ΠΎΠ΄Π°. Π§ΡΠΎ ΠΊΠ°ΡΠ°Π΅ΡΡΡ ΡΠ°ΡΠΎΠ²ΠΊΠΈ, ΡΠΎ ΡΡΡ Π²ΡΠ΅ Π·Π°Π²ΠΈΡΠΈΡ ΠΎΡ ΠΊΠΎΠ½ΠΊΡΠ΅ΡΠ½ΠΎΠΉ ΠΌΠ°ΡΠΊΠΈ, ΠΎΠ΄Π½Π°ΠΊΠΎ ΡΠ°ΠΌΡΠΌΠΈ ΡΠ°ΡΠΏΡΠΎΡΡΡΠ°Π½Π΅Π½Π½ΡΠΌΠΈ ΡΠ»Π΅Π΄ΡΠ΅Ρ ΡΡΠΈΡΠ°ΡΡ ΡΠΏΠ°ΠΊΠΎΠ²ΠΊΠΈ ΠΎΠ±ΡΠ΅ΠΌΠΎΠΌ Π² 0,9 Π»., 2,7 Π»., 9 Π». ΠΡΠ±ΠΈΡΠ°Ρ Π΄Π°Π½Π½ΡΡ ΠΏΡΠΎΠ΄ΡΠΊΡΠΈΡ, ΡΡΠΈΡΡΠ²Π°Π΅ΡΡΡ ΡΠΎΡ ΡΠ°ΠΊΡ, ΡΡΠΎ Π΄Π°Π½Π½ΡΠΉ Π²ΠΈΠ΄ ΠΊΡΠ°ΡΠΊΠΈ Π½Π΅ ΡΠ°ΡΡΡΠΈΡΠ°Π½ Π½Π° Ρ ΡΠ°Π½Π΅Π½ΠΈΠ΅. ΠΠΎΡΠ»Π΅ Π·Π°Π²Π΅ΡΡΠ΅Π½ΠΈΡ Π»Π°ΠΊΠΎΠΊΡΠ°ΡΠΎΡΠ½ΡΡ ΡΠ°Π±ΠΎΡ ΠΎΡΡΠ°ΡΠΊΠΈ Π½Π΅ΠΎΠ±Ρ ΠΎΠ΄ΠΈΠΌΠΎ ΡΡΠΈΠ»ΠΈΠ·ΠΈΡΠΎΠ²Π°ΡΡ.
ΠΠ»Ρ ΠΊΠ°ΠΊΠΈΡ ΠΏΠΎΠ²Π΅ΡΡ Π½ΠΎΡΡΠ΅ΠΉ ΠΏΠΎΠ΄Ρ ΠΎΠ΄ΠΈΡΒ Π°ΠΊΡΠΈΠ»ΠΎΠ²ΠΎ-ΡΠΈΠ»ΠΈΠΊΠΎΠ½ΠΎΠ²ΡΠ΅ ΠΊΡΠ°ΡΠΊΠΈ?
ΠΠΊΡΠΈΠ»ΠΎΠ²ΠΎ-ΡΠΈΠ»ΠΈΠΊΠΎΠ½ΠΎΠ²Π°Ρ ΠΊΡΠ°ΡΠΊΠ° ΠΈΡΠΏΠΎΠ»ΡΠ·ΡΠ΅ΡΡΡ Π½Π° ΡΠ°ΠΊΠΈΡ Π²ΠΈΠ΄Π°Ρ ΠΏΠΎΠ²Π΅ΡΡ Π½ΠΎΡΡΠ΅ΠΉ, ΠΊΠ°ΠΊ Π±Π΅ΡΠΎΠ½, ΡΠ΅ΠΌΠ΅Π½Ρ, Π³ΠΈΠΏΡ ΠΈ ΠΊΠΈΡΠΏΠΈΡ. ΠΠ°Π½Π½ΠΎΠ΅ ΡΡΠ΅Π΄ΡΡΠ²ΠΎ ΡΠ»Π΅Π΄ΡΠ΅Ρ Π½Π°Π½ΠΎΡΠΈΡΡ Π½Π° ΠΏΡΠ΅Π΄Π²Π°ΡΠΈΡΠ΅Π»ΡΠ½ΠΎ ΠΏΠΎΠ΄Π³ΠΎΡΠΎΠ²Π»Π΅Π½Π½ΡΡ ΠΏΠΎΠ²Π΅ΡΡ Π½ΠΎΡΡΡ. ΠΡΠΈ Π½Π΅ΠΎΠ±Ρ ΠΎΠ΄ΠΈΠΌΠΎΡΡΠΈ Π²Ρ ΡΠ°ΠΊΠΆΠ΅ ΠΌΠΎΠΆΠ΅ΡΠ΅ ΠΈΡΠΏΠΎΠ»ΡΠ·ΠΎΠ²Π°ΡΡ ΡΡΠΎΡ Π²ΠΈΠ΄ ΠΊΡΠ°ΡΠΊΠΈ Π½Π° Π΄Π΅ΡΠ΅Π²ΡΠ½Π½ΠΎΠΌ ΠΏΠΎΠΊΡΡΡΠΈΠΈ.
ΠΠ°ΠΊΠΈΠ΅ Π²ΠΈΠ΄Ρ Π°ΠΊΡΠΈΠ»ΠΎΠ²ΠΎ-ΡΠΈΠ»ΠΈΠΊΠΎΠ½ΠΎΠ²ΠΎΠΉ ΠΊΡΠ°ΡΠΊΠΈ ΡΡΡΠ΅ΡΡΠ²ΡΡΡ?
Π£ Π΄Π°Π½Π½ΠΎΠΉ ΠΏΡΠΎΠ΄ΡΠΊΡΠΈΠΈ ΠΈΠΌΠ΅Π΅ΡΡΡ Π½Π΅ΡΠΊΠΎΠ»ΡΠΊΠΎ ΠΈΠ·Π³ΠΎΡΠΎΠ²ΠΈΡΠ΅Π»Π΅ΠΉ, ΠΈ, ΠΊΠ°ΠΊ ΠΏΡΠ°Π²ΠΈΠ»ΠΎ, ΠΎΠ½ΠΈ Π²ΡΠΏΡΡΠΊΠ°ΡΡΡΡ Π·Π° ΡΡΠ±Π΅ΠΆΠΎΠΌ. ΠΠ· ΡΡΠ΅Π΄ΡΡΠ² ΠΏΡΠ΅ΠΌΠΈΡΠΌ-ΠΊΠ»Π°ΡΡΠ° ΡΠ»Π΅Π΄ΡΠ΅Ρ Π²ΡΠ΄Π΅Π»ΠΈΡΡ ΠΊΠΎΠΌΠΏΠ°Π½ΠΈΡ OLSTA, ΡΡΡ ΠΏΡΠΎΠ΄ΡΠΊΡΠΈΡ ΠΎΡΠ»ΠΈΡΠ°Π΅ΡΡΡ Π²ΡΡΠΎΠΊΠΎΠΉ ΡΡΠ΅ΠΏΠ΅Π½ΡΡ ΡΠ»Π°ΡΡΠΈΡΠ½ΠΎΡΡΠΈ. ΠΠΎΠ²Π΅ΡΡ Π½ΠΎΡΡΠΈ, ΠΏΠΎΠΊΡΡΡΡΠ΅ ΡΡΠΎΠΉ ΠΊΡΠ°ΡΠΊΠΎΠΉ, ΠΎΡΠ΅Π½Ρ Π»Π΅Π³ΠΊΠΎ ΠΌΠΎΡΡΡΡ ΠΈ ΠΊΡΠ°ΠΉΠ½Π΅ ΡΡΡΠΎΠΉΡΠΈΠ²Ρ ΠΊ ΡΠ»ΡΡΡΠ°ΡΠΈΠΎΠ»Π΅ΡΡ. ΠΠΎΠ·Π½ΠΈΠΊΠ½ΠΎΠ²Π΅Π½ΠΈΠ΅ Π³ΡΠΈΠ±ΠΊΠ° ΠΈ ΠΏΠ»Π΅ΡΠ΅Π½ΠΈ Π² Π΄Π°Π½Π½ΠΎΠΌ ΡΠ»ΡΡΠ°Π΅ ΡΠ°ΠΊΠΆΠ΅ ΡΠ½ΠΈΠΆΠ΅Π½ΠΎ ΠΊ ΠΌΠΈΠ½ΠΈΠΌΡΠΌΡ.
ΠΡΠ΅ΠΌΠΈΠ°Π»ΡΠ½ΡΠ΅ ΠΊΡΠ°ΡΠΊΠΈ ΠΏΡΠΎΠΈΠ·Π²ΠΎΠ΄ΡΡΠ²Π° ΡΠΎΠ·Π΄Π°ΡΡΡΡ Π½Π° ΠΎΡΠ½ΠΎΠ²Π΅ ΡΠΈΠ»ΠΈΠΊΠΎΠ½ΠΎΠ²ΠΎΠΉ ΡΠΌΠΎΠ»Ρ ΠΈ ΡΠΈΡΡΠΎΠ°ΠΊΡΠΈΠ»ΠΎΠ²ΠΎΠΉ Π΄ΠΈΡΠΏΠ΅ΡΡΠΈΠΈ. ΠΡΠ½ΠΎΠ²Π½ΡΠΌΠΈ Ρ Π°ΡΠ°ΠΊΡΠ΅ΡΠΈΡΡΠΈΠΊΠ°ΠΌΠΈ Π΄Π°Π½Π½ΠΎΠΉ ΠΏΡΠΎΠ΄ΡΠΊΡΠΈΠΈ ΡΠ²Π»ΡΡΡΡΡ Π²ΡΡΠΎΠΊΠ°Ρ ΡΡΡΠΎΠΉΡΠΈΠ²ΠΎΡΡΡ ΠΊ ΡΠ΅ΠΌΠΏΠ΅ΡΠ°ΡΡΡΠ½ΡΠΌ ΠΏΠ΅ΡΠ΅ΠΏΠ°Π΄Π°ΠΌ ΠΈ ΠΎΡΡΡΡΡΡΠ²ΠΈΠ΅ ΡΠ΅Π·ΠΊΠΎΠ³ΠΎ Π·Π°ΠΏΠ°Ρ Π°, ΠΊΠ°ΠΊ ΠΏΡΠΈ Π½Π°Π½Π΅ΡΠ΅Π½ΠΈΠΈ, ΡΠ°ΠΊ ΠΈ ΠΏΡΠΈ Π²ΡΡΡΡ Π°Π½ΠΈΠΈ.
ΠΡΠ»ΠΈ Π²Π°Ρ ΠΈΠ½ΡΠ΅ΡΠ΅ΡΡΡΡ ΡΠΊΠΎΠ½ΠΎΠΌ Π²Π°ΡΠΈΠ°Π½ΡΡ, ΡΠΎ Π²Π°ΠΌ ΡΠ»Π΅Π΄ΡΠ΅Ρ ΠΎΠ±ΡΠ°ΡΠΈΡΡ Π²Π½ΠΈΠΌΠ°Π½ΠΈΠ΅ Π½Π° ΡΠ°ΠΊΠΈΡ ΠΏΡΠΎΠΈΠ·Π²ΠΎΠ΄ΠΈΡΠ΅Π»Π΅ΠΉ, ΠΊΠ°ΠΊ Symphony ΠΈ ΠΠ°ΠΉΡΠ°ΠΌΠΈΠΊΡ. ΠΠ΅ΡΠΌΠΎΡΡΡ Π½Π° ΡΠ²ΠΎΡ Π΄ΠΎΡΡΡΠΏΠ½ΡΡ ΡΡΠΎΠΈΠΌΠΎΡΡΡ, ΡΡΠΈ ΠΌΠΎΠ΄Π΅Π»ΠΈ ΠΏΠΎΠΊΠ°Π·ΡΠ²Π°ΡΡ Ρ ΠΎΡΠΎΡΠΈΠ΅ ΡΠ΅Π·ΡΠ»ΡΡΠ°ΡΡ, Π³Π°ΡΠ°Π½ΡΠΈΡΡΡ Π΄ΠΎΠ»Π³ΠΎΠ²ΡΠ΅ΠΌΠ΅Π½Π½ΡΠΉ ΠΈ ΡΡΠΎΠΉΠΊΠΈΠΉ ΡΡΡΠ΅ΠΊΡ.
ΠΠΎΠ΄Π³ΠΎΡΠΎΠ²ΠΊΠ° ΠΊ ΠΏΠΎΠ²Π΅ΡΡ Π½ΠΎΡΡΠΈ ΠΏΠ΅ΡΠ΅Π΄ ΠΈΡΠΏΠΎΠ»ΡΠ·ΠΎΠ²Π°Π½ΠΈΠ΅ΠΌ ΠΊΡΠ°ΡΠΊΠΈ
ΠΠ΅ΡΠΌΠΎΡΡΡ Π½Π° ΡΠΎΡ ΡΠ°ΠΊΡ, ΡΡΠΎ Π² ΡΠΌΠ΅ΡΠΈ ΡΠΎΠ΄Π΅ΡΠΆΠΈΡΡΡ Π°ΠΊΡΠΈΠ», ΠΏΡΠ΅Π΄ΡΡΠ°Π²Π»Π΅Π½Π½Π°Ρ ΠΏΡΠΎΠ΄ΡΠΊΡΠΈΡ Π½Π°Π½ΠΎΡΠΈΡΡΡ Π»ΠΈΡΡ ΠΏΡΠΈ ΡΡΠ»ΠΎΠ²ΠΈΠΈ, ΡΡΠΎ Π½Π° ΠΏΠΎΠ²Π΅ΡΡ Π½ΠΎΡΡΡ ΠΎΠ½Π° Π±ΡΠ΄Π΅Ρ Π½Π°Π½Π΅ΡΠ΅Π½Π° ΠΏΡΠΈ ΡΠ΅ΠΌΠΏΠ΅ΡΠ°ΡΡΡΠ΅ Π² +50Π‘. Π€Π°ΡΠ°Π΄ Π·Π΄Π°Π½ΠΈΡ Π½Π΅ΠΎΠ±Ρ ΠΎΠ΄ΠΈΠΌΠΎ ΡΡΠ°ΡΠ΅Π»ΡΠ½ΠΎ Π²ΡΡΠΎΠ²Π½ΡΡΡ. Π‘ΡΠ΅Π½Ρ Π΄ΠΎΠ»ΠΆΠ½Ρ Π±ΡΡΡ Π½Π΅ ΠΏΡΠΎΡΡΠΎ ΡΡΡ ΠΈΠΌΠΈ, Π½ΠΎ ΠΈ ΠΎΠ΄Π½ΠΎΡΠΎΠ΄Π½ΡΠΌΠΈ, Π° ΡΠ°ΠΊΠΆΠ΅ ΡΠΈΡΡΡΠΌΠΈ. ΠΠ΅ΠΏΠΎΡΡΠ΅Π΄ΡΡΠ²Π΅Π½Π½ΠΎ ΠΏΠ΅ΡΠ΅Π΄ Π½Π°Π½Π΅ΡΠ΅Π½ΠΈΠ΅ΠΌ Π²ΠΎΠ·ΠΌΠΎΠΆΠ½ΠΎ ΠΏΡΠΈΠ΄Π΅ΡΡΡ ΠΏΠΎΠΊΡΡΡΡ ΡΠ°Π±ΠΎΡΡΡ ΠΏΠΎΠ²Π΅ΡΡ Π½ΠΎΡΡΡ Π³ΡΡΠ½ΡΠΎΠΌ.
Π§ΡΠΎ Π½Π΅ΠΎΠ±Ρ ΠΎΠ΄ΠΈΠΌΠΎ ΡΡΠ΅ΡΡΡ ΠΏΡΠΈ ΠΈΡΠΏΠΎΠ»ΡΠ·ΠΎΠ²Π°Π½ΠΈΠΈ Π°ΠΊΡΠΈΠ»ΠΎΠ²ΠΎ-ΡΠΈΠ»ΠΈΠΊΠΎΠ½ΠΎΠ²ΡΡ ΡΠ°ΡΠ°Π΄Π½ΡΡ ΠΊΡΠ°ΡΠΎΠΊ?
ΠΠ΅ΡΠ΅Π΄ ΠΏΡΠΈΠΌΠ΅Π½Π΅Π½ΠΈΠ΅ΠΌ Π΄Π°Π½Π½ΠΎΠ³ΠΎ ΡΡΠ΅Π΄ΡΡΠ²Π° Π²Π°ΠΌ ΡΠ»Π΅Π΄ΡΠ΅Ρ ΡΡΠ°ΡΠ΅Π»ΡΠ½ΠΎ ΠΏΠ΅ΡΠ΅ΠΌΠ΅ΡΠ°ΡΡ ΠΊΡΠ°ΡΠΊΡ, ΡΠ΅ΠΌ ΡΠ°ΠΌΡΠΌ ΡΠ°Π²Π½ΠΎΠΌΠ΅ΡΠ½ΠΎ ΡΠ°ΡΠΏΡΠ΅Π΄Π΅Π»ΠΈΠ² ΡΠΎΡΡΠ°Π² Π² Π΅ΠΌΠΊΠΎΡΡΠΈ. Π ΠΊΠ°ΡΠ΅ΡΡΠ²Π΅ ΠΏΠΎΠ΄Ρ ΠΎΠ΄ΡΡΠ΅Π³ΠΎ ΠΈΠ½ΡΡΡΡΠΌΠ΅Π½ΡΠ° Π΄Π»Ρ Π½Π°Π½Π΅ΡΠ΅Π½ΠΈΡ ΠΊΡΠ°ΡΡΡΠ΅ΠΉ ΠΆΠΈΠ΄ΠΊΠΎΡΡΠΈ ΠΌΠΎΠΆΠ½ΠΎ ΠΈΡΠΏΠΎΠ»ΡΠ·ΠΎΠ²Π°ΡΡ ΠΊΠΈΡΡΡ, Π²Π°Π»ΠΈΠΊ, Π° ΡΠ°ΠΊΠΆΠ΅ ΠΊΡΠ°ΡΠΊΠΎΠΏΡΠ»ΡΡ. ΠΠ΄Π½Π°ΠΊΠΎ Π²ΡΠ±ΠΎΡ ΠΏΠΎΠ΄Ρ ΠΎΠ΄ΡΡΠ΅Π³ΠΎ ΡΠΏΠΎΡΠΎΠ±Π° ΠΌΠΎΠΆΠ΅Ρ Π±ΡΡΡ ΡΡΠ»ΠΎΠΆΠ½Π΅Π½ Π½Π΅ΠΊΠΎΡΠΎΡΡΠΌΠΈ ΠΎΠ³ΡΠ°Π½ΠΈΡΠ΅Π½ΠΈΡΠΌΠΈ Π² ΡΠΈΠ½Π°Π½ΡΠ°Ρ .
Π ΠΊΠ»Π°ΡΡΠΈΡΠ΅ΡΠΊΠΈΠ΅, ΠΈ Π²ΡΡΠΎΠΊΠΎΡΠ»Π°ΡΡΠΈΡΠ½ΡΠ΅ ΠΌΠΎΠ΄Π΅Π»ΠΈ ΡΡΠΎΠΈΡ Π½Π°Π½ΠΎΡΠΈΡΡ Π½Π° ΠΏΠΎΠ²Π΅ΡΡ Π½ΠΎΡΡΡ Π² Π΄Π²Π° ΡΠ»ΠΎΡ. ΠΠ΅ΡΠ²ΡΠΉ ΠΈΠ· Π½ΠΈΡ ΡΠ»Π΅Π΄ΡΠ΅Ρ ΡΠ°Π·Π±Π°Π²Π»ΡΡΡ, ΠΈ ΠΏΡΠΎΡΠ΅Π½Ρ ΡΠ°Π·Π±Π°Π²Π»Π΅Π½ΠΈΡ Π·Π°Π²ΠΈΡΠΈΡ ΠΎΡ ΠΊΠΎΠ½ΠΊΡΠ΅ΡΠ½ΠΎΠ³ΠΎ ΡΠΈΠΏΠ° ΠΊΡΠ°ΡΠΊΠΈ.Β ΠΡΠΎΡΠΎΠΉ ΡΠ°Π· Π²Π°ΠΌ ΡΠΆΠ΅ Π½Π΅ Π½ΡΠΆΠ½ΠΎ ΡΠΌΠ΅ΡΠΈΠ²Π°ΡΡ ΠΊΡΠ°ΡΠΊΡ Π²ΠΎΠ΄ΠΎΠΉ, ΡΠ°ΠΊ ΠΊΠ°ΠΊ ΡΠ°ΡΡΠ²ΠΎΡ Π΄ΠΎΠ»ΠΆΠ΅Π½ Π±ΡΡΡ ΠΊΠΎΠ½ΡΠ΅Π½ΡΡΠΈΡΠΎΠ²Π°Π½Π½ΡΠΌ. ΠΡΠ»ΠΈ Π²Ρ ΡΡΠΈΡΠ°Π΅ΡΠ΅, ΡΡΠΎ ΠΏΠΎΠ²Π΅ΡΡ Π½ΠΎΡΡΡ ΠΎΠΊΡΠ°ΡΠ΅Π½Π° Π½Π΅Π΄ΠΎΡΡΠ°ΡΠΎΡΠ½ΠΎ, ΡΡΠΎ ΠΈΠΌΠ΅Π΅Ρ ΡΠΌΡΡΠ» ΠΏΠΎΠ²ΡΠΎΡΠΈΡΡ Π΄Π°Π½Π½ΡΡ ΠΏΡΠΎΡΠ΅Π΄ΡΡΡ ΡΠ΅ΡΠ΅Π· Π½Π΅ΠΊΠΎΡΠΎΡΠΎΠ΅ Π²ΡΠ΅ΠΌΡ. ΠΡΠΎΡ ΠΏΠ΅ΡΠΈΠΎΠ΄, ΠΊΠ°ΠΊ ΠΏΡΠ°Π²ΠΈΠ»ΠΎ, Π½Π°ΡΡΡΠΏΠ°Π΅Ρ Π»ΠΈΡΡ ΡΠ΅ΡΠ΅Π· 4-5 ΡΠ°ΡΠΎΠ² ΠΏΠΎΡΠ»Π΅ ΠΏΠ΅ΡΠ²ΠΈΡΠ½ΠΎΠ³ΠΎ ΠΎΠΊΡΠ°ΡΠΈΠ²Π°Π½ΠΈΡ.
ΠΠ΅ΡΠΌΠΎΡΡΡ Π½Π° ΡΠΎΡ ΡΠ°ΠΊΡ, ΡΡΠΎ ΠΈΡΠΏΠΎΠ»ΡΠ·ΠΎΠ²Π°Π½ΠΈΠ΅ Π°ΠΊΡΠΈΠ»ΠΎΠ²ΠΎ-ΡΠΈΠ»ΠΈΠΊΠΎΠ½ΠΎΠ²ΠΎΠΉ ΠΊΡΠ°ΡΠΊΠΈ Π·Π°ΠΌΠ΅ΡΠ½ΠΎ ΡΠΏΡΠΎΡΠ°Π΅Ρ ΠΏΡΠΎΡΠ΅ΡΡ ΠΎΠΊΡΠ°ΡΠΈΠ²Π°Π½ΠΈΡ, Π²Π°ΠΌ ΡΠ»Π΅Π΄ΡΠ΅Ρ Π³ΡΠ°ΠΌΠΎΡΠ½ΠΎ ΡΠ°ΡΡΡΠΈΡΠ°ΡΡ ΡΠ²ΠΎΠΈ ΡΠΈΠ»Ρ. ΠΡΠΈ Π±ΠΎΠ»ΡΡΠΈΡ ΠΎΠ±ΡΠ΅ΠΌΠ°Ρ ΡΠ΅ΠΊΠΎΠΌΠ΅Π½Π΄ΡΠ΅ΠΌ ΠΎΠ±ΡΠ°ΡΠΈΡΡΡΡ Π² ΡΠΏΠ΅ΡΠΈΠ°Π»ΠΈΠ·ΠΈΡΠΎΠ²Π°Π½Π½ΡΡ ΡΠΈΡΠΌΡ ΠΏΠΎ ΠΏΡΠΎΡΠ΅ΡΡΠΈΠΎΠ½Π°Π»ΡΠ½ΠΎΠΉ ΠΏΠΎΠΊΡΠ°ΡΠΊΠ΅ ΡΠ°ΡΠ°Π΄ΠΎΠ².
www.stroyinlock.ru
ΠΡΠΎΠ±Π΅Π½Π½ΠΎΡΡΠΈ ΡΠΈΠ»ΠΈΠΊΠΎΠ½ΠΎΠ²ΠΎΠΉ ΡΠ°ΡΠ°Π΄Π½ΠΎΠΉ ΠΊΡΠ°ΡΠΊΠΈ
Π€Π°ΡΠ°Π΄Π½Π°Ρ ΠΊΡΠ°ΡΠΊΠ° β ΡΡΠΎ Π³ΡΠ°Π½ΠΈΡΠ½ΡΠΉ ΡΠ»ΠΎΠΉ, ΠΎΡΠ΄Π΅Π»ΡΡΡΠΈΠΉ ΡΡΠ΅Π½ΠΎΠ²ΡΠ΅ ΠΌΠ°ΡΠ΅ΡΠΈΠ°Π»Ρ ΠΎΡ ΠΊΠΎΠ½ΡΠ°ΠΊΡΠ° Ρ Π΄ΠΎΠΆΠ΄Π΅Π²ΠΎΠΉ Π²Π»Π°Π³ΠΎΠΉ, Π²Π΅ΡΡΠΎΠΌ, Π΄Π΅ΠΉΡΡΠ²ΠΈΠ΅ΠΌ ΡΠ΅ΠΌΠΏΠ΅ΡΠ°ΡΡΡ ΠΈ ΠΏΡΠΎΡΠΈΠΌΠΈ Π²Π½Π΅ΡΠ½ΠΈΠΌΠΈ ΠΏΡΠΎΡΠ²Π»Π΅Π½ΠΈΡΠΌΠΈ.
ΠΠ½Π΅ Π·Π°Π²ΠΈΡΠΈΠΌΠΎΡΡΠΈ ΠΎΡ ΡΠΎΡΡΠ°Π²Π°, ΡΡΠ΅ΠΏΠ΅Π½ΠΈ ΡΠ»ΠΎΠΆΠ½ΠΎΡΡΠΈ ΠΈΠ»ΠΈ ΠΈΠ½ΡΡ ΠΏΠ°ΡΠ°ΠΌΠ΅ΡΡΠΎΠ² ΡΡΠ΅Π½, Π²Π½Π΅ΡΠ½ΠΈΠΌ ΡΠ»ΠΎΠ΅ΠΌ Π² Π±ΠΎΠ»ΡΡΠΈΠ½ΡΡΠ²Π΅ ΡΠ»ΡΡΠ°Π΅Π² ΡΠ²Π»ΡΠ΅ΡΡΡ ΡΠ°ΡΠ°Π΄Π½Π°Ρ ΠΊΡΠ°ΡΠΊΠ°. ΠΠ½Π° ΠΎΠ±Π΅ΡΠΏΠ΅ΡΠΈΠ²Π°Π΅Ρ Π·Π°ΡΠΈΡΡ ΠΌΠ°ΡΠ΅ΡΠΈΠ°Π»ΠΎΠ² ΡΡΠ΅Π½, ΡΠΎΠ·Π΄Π°Π΅Ρ Π΄Π΅ΠΊΠΎΡΠ°ΡΠΈΠ²Π½ΡΠΉ ΡΡΡΠ΅ΠΊΡ ΠΈ ΠΏΡΠΈΠ΄Π°Π΅Ρ Π΄ΠΎΠΌΡ ΡΠΎΠ±ΡΡΠ²Π΅Π½Π½ΡΠΉ ΠΎΠ±Π»ΠΈΠΊ, ΠΏΠΎΠ΄ΡΠ΅ΡΠΊΠΈΠ²Π°ΡΡΠΈΠΉ Π²ΠΊΡΡ Π²Π»Π°Π΄Π΅Π»ΡΡΠ° ΠΈ Π·Π°ΠΌΡΡΠ΅Π» Π°ΡΡ ΠΈΡΠ΅ΠΊΡΠΎΡΠ°.
Π’Π°ΠΊΠΎΠΉ Π½Π°Π±ΠΎΡ Π²ΡΠΏΠΎΠ»Π½ΡΠ΅ΠΌΡΡ ΡΡΠ½ΠΊΡΠΈΠΉ ΡΡΠ΅Π±ΡΠ΅Ρ ΠΎΡ ΡΠ°ΡΠ°Π΄Π½ΡΡ ΠΊΡΠ°ΡΠΎΠΊ Π½Π°Π»ΠΈΡΠΈΡ ΠΎΠΏΡΠ΅Π΄Π΅Π»Π΅Π½Π½ΡΡ ΠΊΠ°ΡΠ΅ΡΡΠ². Π‘ΡΡΠ΅ΡΡΠ²ΡΠ΅Ρ Π½Π΅ΡΠΊΠΎΠ»ΡΠΊΠΎ ΡΠ°Π·Π½ΠΎΠ²ΠΈΠ΄Π½ΠΎΡΡΠ΅ΠΉ Π½Π°ΡΡΠΆΠ½ΡΡ ΠΏΠΎΠΊΡΡΡΠΈΠΉ, ΠΎΠ΄Π½Ρ ΠΈΠ· ΠΊΠΎΡΠΎΡΡΡ ΡΠ»Π΅Π΄ΡΠ΅Ρ ΡΠ°ΡΡΠΌΠΎΡΡΠ΅ΡΡ ΠΏΠΎΠ΄ΡΠΎΠ±Π½ΠΎ.
ΠΡΠΎΠ±Π΅Π½Π½ΠΎΡΡΠΈ ΡΠΈΠ»ΠΈΠΊΠΎΠ½ΠΎΠ²ΠΎΠΉ ΡΠ°ΡΠ°Π΄Π½ΠΎΠΉ ΠΊΡΠ°ΡΠΊΠΈ
ΠΡΠ½ΠΎΠ²Π° ΡΠΈΠ»ΠΈΠΊΠΎΠ½ΠΎΠ²ΡΡ ΡΠ°ΡΠ°Π΄Π½ΡΡ ΠΊΡΠ°ΡΠΎΠΊ β Π²ΠΎΠ΄Π½Π°Ρ ΡΠΌΡΠ»ΡΡΠΈΡ ΡΠΈΠ»ΠΈΠΊΠΎΠ½ΠΎΠ²ΡΡ ΡΠΌΠΎΠ». ΠΡΠΎ ΠΎΠ·Π½Π°ΡΠ°Π΅Ρ, ΡΡΠΎ ΡΠ°ΡΠ°Π΄Π½Π°Ρ ΡΠΈΠ»ΠΈΠΊΠΎΠ½ΠΎΠ²Π°Ρ ΠΊΡΠ°ΡΠΊΠ° ΠΎΡΠ½ΠΎΡΠΈΡΡΡ ΠΊ ΡΠ°Π·ΡΡΠ΄Ρ Π²ΠΎΠ΄Π½ΠΎΠ΄ΠΈΡΠΏΠ΅ΡΡΠ½ΡΡ ΠΌΠ°ΡΠ΅ΡΠΈΠ°Π»ΠΎΠ², ΡΡΠΎ Π΄Π°Π΅Ρ ΠΈΠΌ ΠΎΠΏΡΠ΅Π΄Π΅Π»Π΅Π½Π½ΡΠ΅ ΠΏΡΠ΅ΠΈΠΌΡΡΠ΅ΡΡΠ²Π°, Π½ΠΎ ΠΈ ΡΠΎΠ·Π΄Π°Π΅Ρ Π½Π΅ΠΊΠΎΡΠΎΡΡΠ΅ ΠΎΠ³ΡΠ°Π½ΠΈΡΠ΅Π½ΠΈΡ, ΡΡΠ΅Π±ΡΠ΅Ρ ΡΠΎΠ±Π»ΡΠ΄Π΅Π½ΠΈΡ ΠΎΠΏΡΠ΅Π΄Π΅Π»Π΅Π½Π½ΡΡ ΡΡΠ»ΠΎΠ²ΠΈΠΉ Π² ΡΠ°Π±ΠΎΡΠ΅.
ΠΡΠΎΠΌΠ΅ ΡΠΎΠ³ΠΎ, Π² ΡΠΎΡΡΠ°Π²Π΅ ΡΠΌΠ΅ΡΠΈ ΡΠΎΠ΄Π΅ΡΠΆΠ°ΡΡΡ ΡΠ°Π·Π»ΠΈΡΠ½ΡΠ΅ Π΄ΠΎΠ±Π°Π²ΠΊΠΈ, Π½Π°ΠΏΠΎΠ»Π½ΠΈΡΠ΅Π»ΠΈ ΠΈΠ»ΠΈ ΠΏΠΈΠ³ΠΌΠ΅Π½ΡΡ, Π΄Π°ΡΡΠΈΠ΅ ΠΏΠΎΠΊΡΡΡΠΈΡ ΠΏΡΠΎΡΠ½ΠΎΡΡΡ, ΡΡΠΊΠΎΡΡΡΡΠΈΠ΅ Π·Π°ΡΡΡ Π°Π½ΠΈΠ΅ ΠΈ Π²ΡΠΏΠΎΠ»Π½ΡΡΡΠΈΠ΅ Π΄ΡΡΠ³ΠΈΠ΅ ΡΠΏΠ΅ΡΠΈΠ°Π»ΡΠ½ΡΠ΅ Π·Π°Π΄Π°ΡΠΈ.
ΠΠΎ ΡΠ²ΠΎΠΈΠΌ ΠΎΡΠ½ΠΎΠ²Π½ΡΠΌ ΠΏΠ°ΡΠ°ΠΌΠ΅ΡΡΠ°ΠΌ ΡΠΈΠ»ΠΈΠΊΠΎΠ½ΠΎΠ²Π°Ρ ΠΊΡΠ°ΡΠΊΠ° ΠΎΡΠ»ΠΈΡΠ½ΠΎ ΠΏΠΎΠ΄Ρ ΠΎΠ΄ΠΈΡ Π΄Π»Ρ Π½Π°ΡΡΠΆΠ½ΠΎΠ³ΠΎ ΠΏΡΠΈΠΌΠ΅Π½Π΅Π½ΠΈΡ. ΠΠΎΠΊΡΡΡΠΈΠ΅ ΠΎΠ±Π΅ΡΠΏΠ΅ΡΠΈΠ²Π°Π΅Ρ Π½ΡΠΆΠ½ΡΡ ΠΏΠ°ΡΠΎΠΏΡΠΎΠ½ΠΈΡΠ°Π΅ΠΌΠΎΡΡΡ, Π³ΠΈΠ΄ΡΠΎΠ·Π°ΡΠΈΡΡ, ΠΈΠΌΠ΅Π΅Ρ Π²ΡΡΠΎΠΊΡΡ ΡΠ»Π°ΡΡΠΈΡΠ½ΠΎΡΡΡ.
ΠΠ°Π·ΠΎΠ²ΡΠΉ ΡΠΎΡΡΠ°Π² ΡΠΈΠ»ΠΈΠΊΠ°ΡΠ½ΠΎΠΉ ΡΠ°ΡΠ°Π΄Π½ΠΎΠΉ ΠΊΡΠ°ΡΠΊΠΈ ΠΈΠΌΠ΅Π΅Ρ ΡΠΈΡΡΡΠΉ Π±Π΅Π»ΡΠΉ ΡΠ²Π΅Ρ, Π΄Π»Ρ ΠΏΠΎΠ»ΡΡΠ΅Π½ΠΈΡ Π½Π΅ΠΎΠ±Ρ ΠΎΠ΄ΠΈΠΌΠΎΠ³ΠΎ ΠΎΡΡΠ΅Π½ΠΊΠ° ΡΠΌΠ΅ΡΡ ΠΊΠΎΠ»Π΅ΡΡΠ΅ΡΡΡ β Π² Π½Π΅Π΅ Π΄ΠΎΠ±Π°Π²Π»ΡΡΡΡΡ Π½ΡΠΆΠ½ΡΠ΅ ΠΏΠΈΠ³ΠΌΠ΅Π½ΡΡ, Π΄Π°ΡΡΠΈΠ΅ ΡΡΠ΅Π±ΡΠ΅ΠΌΡΡ ΠΎΠΊΡΠ°ΡΠΊΡ. ΠΠ°ΡΠΎΠ²Π°Ρ ΠΏΠΎΠ²Π΅ΡΡ Π½ΠΎΡΡΡ ΡΠΎΠ·Π΄Π°Π΅Ρ ΡΠΈΠ»ΡΠ½ΡΠΉ Π΄Π΅ΠΊΠΎΡΠ°ΡΠΈΠ²Π½ΡΠΉ ΡΡΡΠ΅ΠΊΡ β ΡΠ»ΠΎΠΉ ΠΊΡΠ°ΡΠΊΠΈ Π½Π΅ Π±Π»ΠΈΠΊΡΠ΅Ρ Π½Π° ΡΠΎΠ»Π½ΡΠ΅, ΠΏΠ»ΠΎΡΠΊΠΎΡΡΡ ΡΡΠ΅Π½Ρ Π²ΡΠ³Π»ΡΠ΄ΠΈΡ ΠΈΠ΄Π΅Π°Π»ΡΠ½ΠΎ ΡΠΎΠ²Π½ΠΎΠΉ.

ΠΡΠ»ΠΈΡΠΈΡΠ΅Π»ΡΠ½Π°Ρ ΡΠ΅ΡΡΠ° Π²ΠΎΠ΄Π½ΠΎΠ΄ΠΈΡΠΏΠ΅ΡΡΠ½ΡΡ ΠΊΡΠ°ΡΠΎΠΊ β ΠΎΡΡΡΡΡΡΠ²ΠΈΠ΅ Π·Π°ΠΏΠ°Ρ Π° ΠΏΡΠΈ Π½Π°Π½Π΅ΡΠ΅Π½ΠΈΠΈ. ΠΡΠΎ Π½Π΅ΠΌΠ°Π»ΠΎΠ²Π°ΠΆΠ½ΠΎΠ΅ ΠΎΠ±ΡΡΠΎΡΡΠ΅Π»ΡΡΡΠ²ΠΎ, ΡΡΡΠ΅ΡΡΠ²Π΅Π½Π½ΠΎ ΠΎΠ±Π»Π΅Π³ΡΠ°ΡΡΠ΅Π΅ ΠΆΠΈΠ·Π½Ρ Π²ΡΠ΅ΠΌ Π»ΡΠ΄ΡΠΌ, ΠΎΠΊΠ°Π·Π°Π²ΡΠΈΠΌΡΡ ΠΏΠΎΠ±Π»ΠΈΠ·ΠΎΡΡΠΈ β ΠΎΡ ΠΆΠΈΠ»ΡΡΠΎΠ² Π΄ΠΎΠΌΠ° ΠΈΠ»ΠΈ ΡΠΎΡΠ΅Π΄Π΅ΠΉ, Π΄ΠΎ ΡΠ°ΠΌΠΈΡ ΠΌΠ°Π»ΡΡΠΎΠ², ΠΊΠΎΡΠΎΡΡΠΌ Π΄ΠΎΡΡΠ°Π΅ΡΡΡ ΠΌΠ°ΠΊΡΠΈΠΌΡΠΌ Π²ΡΠ΄Π΅Π»Π΅Π½ΠΈΠΉ ΠΎΡ Π½Π°Π½ΠΎΡΠΈΠΌΡΡ ΡΠΎΡΡΠ°Π²ΠΎΠ².
ΠΡΠ΅ ΠΎΠ΄Π½ΠΈΠΌ Π²Π°ΠΆΠ½ΡΠΌ ΡΠ²ΠΎΠΉΡΡΠ²ΠΎΠΌ ΡΠΈΠ»ΠΈΠΊΠΎΠ½ΠΎΠ²ΡΡ ΡΠΎΡΡΠ°Π²ΠΎΠ² ΡΠ²Π»ΡΠ΅ΡΡΡ ΠΏΡΠΈΡΡΡΠΈΠΉ ΠΈΠΌ Β«ΡΡΡΠ΅ΠΊΡ Π»ΠΎΡΠΎΡΠ°Β». Π’ΠΎ Π΅ΡΡΡ, ΠΏΠΎΠ²Π΅ΡΡ Π½ΠΎΡΡΡ ΠΎΠ±Π»Π°Π΄Π°Π΅Ρ Π²ΡΡΠΎΠΊΠΈΠΌΠΈ Π²ΠΎΠ΄ΠΎΠΎΡΡΠ°Π»ΠΊΠΈΠ²Π°ΡΡΠΈΠΌΠΈ ΠΊΠ°ΡΠ΅ΡΡΠ²Π°ΠΌΠΈ, ΠΊ Π½Π΅ΠΉ Π½Π΅ ΠΏΡΠΈΠ»ΠΈΠΏΠ°Π΅Ρ Π³ΡΡΠ·Ρ ΠΈΠ»ΠΈ ΠΏΡΠ»Ρ. ΠΠΎ Π²ΡΡΠΊΠΎΠΌ ΡΠ»ΡΡΠ°Π΅, Π΄Π»Ρ ΠΏΠΎΠ»Π½ΠΎΠΉ ΠΎΡΠΈΡΡΠΊΠΈ ΡΡΠ΅Π½ Π΄ΠΎΠΌΠ° Π΄ΠΎΡΡΠ°ΡΠΎΡΠ½ΠΎ Π½Π΅Π±ΠΎΠ»ΡΡΠΎΠ³ΠΎ Π΄ΠΎΠΆΠ΄Ρ.
Π‘Π»ΠΎΠΉ ΡΠΈΠ»ΠΈΠΊΠΎΠ½ΠΎΠ²ΠΎΠΉ ΡΠ°ΡΠ°Π΄Π½ΠΎΠΉ ΠΊΡΠ°ΡΠΊΠΈ Π½Π΅ ΡΡΠ΅Π±ΡΠ΅Ρ Π½ΠΈΠΊΠ°ΠΊΠΎΠ³ΠΎ ΡΡ ΠΎΠ΄Π°, Π½Π΅ Π½ΡΠΆΠ΄Π°Π΅ΡΡΡ Π² ΠΏΠ΅ΡΠΈΠΎΠ΄ΠΈΡΠ΅ΡΠΊΠΎΠΌ Π½Π°Π½Π΅ΡΠ΅Π½ΠΈΠΈ ΡΠ°Π·Π»ΠΈΡΠ½ΡΡ ΡΠΎΡΡΠ°Π²ΠΎΠ² ΠΈ Ρ.Π΄.
ΠΡΠ»ΠΈΡΠΈΡ ΠΎΡ Π΄ΡΡΠ³ΠΈΡ Π²ΠΈΠ΄ΠΎΠ² ΡΠ°ΡΠ°Π΄Π½ΡΡ ΠΊΡΠ°ΡΠΎΠΊ
Π ΠΎΡΠ»ΠΈΡΠΈΠ΅ ΠΎΡ Π²ΡΠ΅Ρ Π΄ΡΡΠ³ΠΈΡ Π½Π°ΡΡΠΆΠ½ΡΡ ΠΊΡΠ°ΡΠΎΠΊ, ΡΠΈΠ»ΠΈΠΊΠΎΠ½ΠΎΠ²ΡΠ΅ ΡΠΎΡΡΠ°Π²Ρ ΠΈΠΌΠ΅ΡΡ ΡΠ°ΠΌΡΡ Π²ΡΡΠΎΠΊΡΡ ΡΡΠ΅ΠΏΠ΅Π½Ρ ΡΠ»Π°ΡΡΠΈΡΠ½ΠΎΡΡΠΈ. Π‘Π»ΠΎΠΉ ΠΏΠΎΠΊΡΡΡΠΈΡ Π½Π΅ ΠΎΠ±ΡΠ°Π·ΡΠ΅Ρ ΡΡΠ΅ΡΠΈΠ½ ΠΏΡΠΈ Π½Π΅Π±ΠΎΠ»ΡΡΠΈΡ ΠΈΠ·ΠΌΠ΅Π½Π΅Π½ΠΈΡΡ Π»ΠΈΠ½Π΅ΠΉΠ½ΡΡ ΡΠ°Π·ΠΌΠ΅ΡΠΎΠ² ΠΎΡΠ½ΠΎΠ²Ρ.
ΠΡΠΎ Π΄Π°Π΅Ρ Π²ΠΎΠ·ΠΌΠΎΠΆΠ½ΠΎΡΡΡ ΡΠΊΡΡΠ²Π°ΡΡ ΡΡΠ°Π΄ΠΊΡ Π΄ΠΎΠΌΠ°, ΡΠΏΠΎΠΊΠΎΠΉΠ½ΠΎ ΠΏΠ΅ΡΠ΅Π½ΠΎΡΠΈΡΡ Π²ΠΈΠ±ΡΠ°ΡΠΈΠΈ, ΡΠ΅ΠΉΡΠΌΠΈΡΠ΅ΡΠΊΠΈΠ΅ ΠΏΠΎΠ΄Π²ΠΈΠΆΠΊΠΈ ΠΏΠΎΡΠ²Ρ ΠΈ Ρ.Π΄.
Π Π΅ΠΌΠΎΠ½ΡΠ½ΡΠ΅ ΡΠΎΡΡΠ°Π²Ρ ΡΠΈΠ»ΠΈΠΊΠΎΠ½ΠΎΠ²ΠΎΠΉ ΠΊΡΠ°ΡΠΊΠΈ ΠΈΠΌΠ΅ΡΡ ΠΏΠΎΠ²ΡΡΠ΅Π½Π½ΡΡ ΡΠΊΡΡΠ²ΠΈΡΡΠΎΡΡΡ, ΠΎΠ½ΠΈ ΡΠΏΠΎΡΠΎΠ±Π½Ρ Π·Π°Π΄Π΅Π»ΡΠ²Π°ΡΡ ΡΡΠ΅ΡΠΈΠ½Ρ Π΄ΠΎ 2 ΠΌΠΌ ΡΠΈΡΠΈΠ½ΠΎΠΉ.
Π‘ΠΈΠ»ΠΈΠΊΠΎΠ½ΠΎΠ²ΡΠ΅ ΡΠΎΡΡΠ°Π²Ρ ΠΈΠΌΠ΅ΡΡ Π²ΡΡΠΎΠΊΠΈΠΉ ΠΏΠΎΠΊΠ°Π·Π°ΡΠ΅Π»Ρ ΡΠΈΠΊΡΠΎΡΡΠΎΠΏΠ½ΠΎΡΡΠΈ. ΠΡΠΎ ΡΠ²ΠΎΠΉΡΡΠ²ΠΎ Ρ Π°ΡΠ°ΠΊΡΠ΅ΡΠΈΠ·ΡΠ΅ΡΡΡ ΠΏΠΎΠ²ΡΡΠ΅Π½ΠΈΠ΅ΠΌ Π²ΡΠ·ΠΊΠΎΡΡΠΈ ΡΠΎΡΡΠ°Π²Π° Π² ΡΠΎΡΡΠΎΡΠ½ΠΈΠΈ ΠΏΠΎΠΊΠΎΡ.
Π£Π΄ΠΎΠ±Π½ΠΎΠ΅ ΠΊΠ°ΡΠ΅ΡΡΠ²ΠΎ ΠΏΡΠΈ ΡΠ°Π±ΠΎΡΠ΅ Ρ Π²Π°Π»ΠΈΠΊΠΎΠΌ ΠΈΠ»ΠΈ ΠΊΠΈΡΡΡΡ β ΠΊΡΠ°ΡΠΊΠ° ΠΌΠ΅Π½ΡΡΠ΅ ΡΠΊΠ°ΡΡΠ²Π°Π΅ΡΡΡ Ρ ΠΈΠ½ΡΡΡΡΠΌΠ΅Π½ΡΠ°, ΠΏΡΠΎΡΠ΅ΡΡ ΡΡΠ°Π½ΠΎΠ²ΠΈΡΡΡ Π°ΠΊΠΊΡΡΠ°ΡΠ½Π΅Π΅, ΠΎΡΡΠ°Π΅ΡΡΡ ΠΌΠ΅Π½ΡΡΠ΅ ΠΏΡΡΠ΅Π½ ΠΈΠ»ΠΈ ΠΊΠ°ΠΏΠ΅Π»Ρ ΠΊΡΠ°ΡΠΊΠΈ.
ΠΡΠΎΠΌΠ΅ ΡΠΎΠ³ΠΎ, ΡΠΈΠ»ΠΈΠΊΠΎΠ½ΠΎΠ²ΡΠ΅ ΠΏΠΎΠΊΡΡΡΠΈΡ Π΄Π»Ρ ΡΠ°ΡΠ°Π΄Π° ΠΈΠΌΠ΅ΡΡ Π²ΡΡΠΎΠΊΡΡ ΡΡΠ΅ΠΏΠ΅Π½Ρ ΡΡΡΠΎΠΉΡΠΈΠ²ΠΎΡΡΠΈ ΠΊ ΡΠ΅Π»ΠΎΡΠ°ΠΌ. ΠΠ° ΠΏΡΠ°ΠΊΡΠΈΠΊΠ΅ ΡΡΠΎ ΠΎΠ·Π½Π°ΡΠ°Π΅Ρ Π²ΠΎΠ·ΠΌΠΎΠΆΠ½ΠΎΡΡΡ ΠΊΡΠ°ΡΠΈΡΡ ΠΏΠΎΠ²Π΅ΡΡ Π½ΠΎΡΡΡ ΡΠΆΠ΅ ΡΠ΅ΡΠ΅Π· 48 ΡΠ°ΡΠΎΠ² ΠΏΠΎΡΠ»Π΅ Π½Π°Π½Π΅ΡΠ΅Π½ΠΈΡ Π½Π°ΡΡΠΆΠ½ΠΎΠ³ΠΎ ΡΠ»ΠΎΡ ΡΡΡΠΊΠ°ΡΡΡΠΊΠΈ, ΡΠΎΠ³Π΄Π° ΠΊΠ°ΠΊ Π΄ΡΡΠ³ΠΈΠ΅ ΠΊΡΠ°ΡΠΊΠΈ ΠΌΠΎΠΆΠ½ΠΎ Π½Π°Π½ΠΎΡΠΈΡΡ Π»ΠΈΡΡ ΡΠ΅ΡΠ΅Π· ΠΌΠ΅ΡΡΡ, Π΄Π»Ρ ΡΠΎΠ³ΠΎ, ΡΡΠΎΠ±Ρ Π·Π°Π²Π΅ΡΡΠΈΠ»ΠΈΡΡ Π²ΡΠ΅ ΠΏΡΠΎΡΠ΅ΡΡΡ ΠΎΡΠ²Π΅ΡΠΆΠ΄Π΅Π½ΠΈΡ ΡΠ΅ΠΌΠ΅Π½ΡΠ½ΡΡ ΡΠΎΡΡΠ°Π²ΠΎΠ².
ΠΠΎΡΡΠΎΠΈΠ½ΡΡΠ²Π° ΠΈ Π½Π΅Π΄ΠΎΡΡΠ°ΡΠΊΠΈ
Π Π΄ΠΎΡΡΠΎΠΈΠ½ΡΡΠ²Π°ΠΌ ΡΠΈΠ»ΠΈΠΊΠΎΠ½ΠΎΠ²ΡΡ ΠΏΠΎΠΊΡΡΡΠΈΠΉ ΠΌΠΎΠΆΠ½ΠΎ ΠΎΡΠ½Π΅ΡΡΠΈ:
- ΠΡΡΠΎΠΊΠ°Ρ ΡΠ»Π°ΡΡΠΈΡΠ½ΠΎΡΡΡ.
- ΠΠΎΡΠΎΠ·ΠΎΡΡΠΎΠΉΠΊΠΎΡΡΡ.
- Π‘ΠΎΠ²ΠΌΠ΅ΡΡΠΈΠΌΠΎΡΡΡ Ρ Π±ΠΎΠ»ΡΡΠΈΠ½ΡΡΠ²ΠΎΠΌ ΠΎΡΠ½ΠΎΠ²Π°Π½ΠΈΠΉ.
- ΠΠΎΠ΄ΠΎΠΎΡΡΠ°Π»ΠΊΠΈΠ²Π°ΡΡΠ°Ρ ΡΠΏΠΎΡΠΎΠ±Π½ΠΎΡΡΡ ΠΏΠΎΠ²Π΅ΡΡ Π½ΠΎΡΡΠΈ ΠΈΡΠΊΠ»ΡΡΠ°Π΅Ρ Π½Π°Π»ΠΈΠΏΠ°Π½ΠΈΠ΅ Π³ΡΡΠ·ΠΈ ΠΈΠ»ΠΈ ΠΏΡΠ»ΠΈ.
- ΠΡΡΡΡΡΡΠ²ΠΈΠ΅ Ρ Π°ΡΠ°ΠΊΡΠ΅ΡΠ½ΠΎΠ³ΠΎ Π·Π°ΠΏΠ°Ρ Π° ΠΊΡΠ°ΡΠΊΠΈ ΠΏΡΠΈ Π½Π°Π½Π΅ΡΠ΅Π½ΠΈΠΈ.
- ΠΡΠΎΡΠ½ΠΎΡΡΡ, ΡΡΡΠΎΠΉΡΠΈΠ²ΠΎΡΡΡ ΠΊ ΠΈΡΡΠΈΡΠ°Π½ΠΈΡ, ΠΈΠ·Π½ΠΎΡΠΎΡΡΡΠΎΠΉΡΠΈΠ²ΠΎΡΡΡ.
- Π£ΡΡΠΎΠΉΡΠΈΠ²ΠΎΡΡΡ ΠΊ Π²ΠΎΠ·Π΄Π΅ΠΉΡΡΠ²ΠΈΡΠΌ Π±ΠΈΠΎΠ»ΠΎΠ³ΠΈΡΠ΅ΡΠΊΠΎΠ³ΠΎ Ρ Π°ΡΠ°ΠΊΡΠ΅ΡΠ° β ΠΏΠΎΡΠ²Π»Π΅Π½ΠΈΡ ΠΏΠ»Π΅ΡΠ΅Π½ΠΈ, Π³ΡΠΈΠ±ΠΊΠ° ΠΈ Ρ.ΠΏ.
ΠΡΠΈ ΡΡΠΎΠΌ, ΠΈΠΌΠ΅ΡΡΡΡ ΠΎΠΏΡΠ΅Π΄Π΅Π»Π΅Π½Π½ΡΠ΅ Π½Π΅Π΄ΠΎΡΡΠ°ΡΠΊΠΈ:
- ΠΡΡΠΎΠΊΠ°Ρ ΡΡΠΎΠΈΠΌΠΎΡΡΡ ΠΊΡΠ°ΡΠΊΠΈ.
- ΠΠ΅ΠΎΠ±Ρ ΠΎΠ΄ΠΈΠΌΠΎΡΡΡ ΠΊΠΎΠ»Π΅ΡΠΎΠ²ΠΊΠΈ Π² Π½ΡΠΆΠ½ΡΠΉ ΡΠ²Π΅Ρ, ΠΎΡΡΡΡΡΡΠ²ΠΈΠ΅ Π³ΠΎΡΠΎΠ²ΡΡ ΠΊ ΡΠΏΠΎΡΡΠ΅Π±Π»Π΅Π½ΠΈΡ ΡΠ²Π΅ΡΠ½ΡΡ ΡΠΎΡΡΠ°Π²ΠΎΠ².
ΠΠΠΠΠ!
Π¦Π΅Π½Π° ΠΊΡΠ°ΡΠΊΠΈ Π² ΠΊΠ°ΠΊΠΎΠΉ-ΡΠΎ ΠΌΠ΅ΡΠ΅ ΠΊΠΎΠΌΠΏΠ΅Π½ΡΠΈΡΡΠ΅ΡΡΡ ΠΎΡΡΡΡΡΡΠ²ΠΈΠ΅ΠΌ Π½ΡΠΆΠ΄Ρ Π² ΠΏΠΎΠ²ΡΠΎΡΠ½ΡΡ ΡΠ΅ΠΌΠΎΠ½ΡΠ½ΡΡ ΠΌΠ΅ΡΠΎΠΏΡΠΈΡΡΠΈΡΡ , ΠΏΠΎΡΠΊΠΎΠ»ΡΠΊΡ Π΄ΠΎΠ»Π³ΠΎΠ²Π΅ΡΠ½ΠΎΡΡΡ ΠΈ ΠΏΡΠΎΡΠ½ΠΎΡΡΡ ΠΏΠΎΠΊΡΡΡΠΈΡ Π²Π΅ΡΡΠΌΠ° Π²ΡΡΠΎΠΊΠΈ.
Π’Π΅Ρ Π½ΠΈΡΠ΅ΡΠΊΠΈΠ΅ Ρ Π°ΡΠ°ΠΊΡΠ΅ΡΠΈΡΡΠΈΠΊΠΈ
ΠΡΠ°ΡΠΊΠΈ Π½Π° ΡΠΈΠ»ΠΈΠΊΠΎΠ½ΠΎΠ²ΠΎΠΉ ΠΎΡΠ½ΠΎΠ²Π΅ ΠΈΠΌΠ΅ΡΡ Π΄ΠΎΡΡΠ°ΡΠΎΡΠ½ΠΎ ΡΠΈΡΠΎΠΊΠΈΠΉ Π°ΡΡΠΎΡΡΠΈΠΌΠ΅Π½Ρ, ΠΏΠΎΡΡΠΎΠΌΡ Π±ΡΠ΄ΡΡ ΠΏΠ΅ΡΠ΅ΡΠΈΡΠ»Π΅Π½Ρ ΡΡΠ΅Π΄Π½ΠΈΠ΅ Π·Π½Π°ΡΠ΅Π½ΠΈΡ:
- Π’Π΅ΠΌΠΏΠ΅ΡΠ°ΡΡΡΠ° ΠΏΡΠΈ ΡΠΊΡΠΏΠ»ΡΠ°ΡΠ°ΡΠΈΠΈ β ΠΎΡ -50Β° Π΄ΠΎ +70Β°.
- Π’Π΅ΠΌΠΏΠ΅ΡΠ°ΡΡΡΠ° Π΄Π»Ρ Π½Π°Π½Π΅ΡΠ΅Π½ΠΈΡ β ΠΎΡ +5Β° Π΄ΠΎ +30Β°.
- ΠΠ»ΠΎΡΠ½ΠΎΡΡΡ β 1,5 ΠΊΠ³/ΠΊΡΠ±.Π΄ΠΌ.
- ΠΠΎΡΠΎΠ·ΠΎΡΡΠΎΠΉΠΊΠΎΡΡΡ β Π΄ΠΎ 100 ΡΠΈΠΊΠ»ΠΎΠ².
ΠΠΠ ΠΠ’ΠΠ’Π ΠΠΠΠΠΠΠΠ!
ΠΠΎΠΊΠ°Π·Π°ΡΠ΅Π»Ρ ΠΌΠΎΡΠΎΠ·ΠΎΡΡΠΎΠΉΠΊΠΎΡΡΠΈ β ΡΠ°ΡΡΠ΅ΡΠ½ΡΠΉ, Π½Π° ΠΏΡΠ°ΠΊΡΠΈΠΊΠ΅ Π½Π΅ ΠΏΡΠΎΠ²Π΅ΡΠ΅Π½.
- Π£ΡΡΠΎΠΉΡΠΈΠ²ΠΎΡΡΡ ΠΏΠΎΠ²Π΅ΡΡ Π½ΠΎΡΡΠΈ ΠΊ Π²ΠΎΠ·Π΄Π΅ΠΉΡΡΠ²ΠΈΡ Π΄ΠΎΠΆΠ΄Ρ β ΡΠ΅ΡΠ΅Π· 3 ΡΠ°ΡΠ° ΠΏΠΎΡΠ»Π΅ Π½Π°Π½Π΅ΡΠ΅Π½ΠΈΡ.
- ΠΡΠ΅ΠΌΡ Π²ΡΡΡΡ Π°Π½ΠΈΡ β 3 ΡΠ°ΡΠ° Π½Π° ΡΡ Π²Π°ΡΡΠ²Π°Π½ΠΈΠ΅, 8-9 ΡΠ°ΡΠΎΠ² Π½Π° ΠΏΠΎΠ»Π½ΠΎΠ΅ Π²ΡΡΡΡ Π°Π½ΠΈΠ΅ 1 ΡΠ»ΠΎΡ, 12 ΡΠ°ΡΠΎΠ² β Π΄Π»Ρ Π΄Π°Π»ΡΠ½Π΅ΠΉΡΠ΅ΠΉ ΠΎΠ±ΡΠ°Π±ΠΎΡΠΊΠΈ.
- Π£ΠΊΡΡΠ²ΠΈΡΡΠΎΡΡΡ (ΠΌΠΈΠ½) β 120 Π³/ΠΊΠ².ΠΌ.
- Π Π°Π·Π±Π°Π²ΠΈΡΠ΅Π»Ρ β Π²ΠΎΠ΄Π°, Π½Π΅ Π±ΠΎΠ»Π΅Π΅ 5%.

ΠΡΠ½ΠΎΠ²Π½ΡΠ΅ Π²ΠΈΠ΄Ρ ΠΈ ΡΠΈΡΠΌΡ
Π‘ΠΈΠ»ΠΈΠΊΠΎΠ½ΠΎΠ²ΡΠ΅ ΡΠΎΡΡΠ°Π²Ρ ΠΈΠ·Π³ΠΎΡΠ°Π²Π»ΠΈΠ²Π°ΡΡΡΡ ΠΏΡΠ°ΠΊΡΠΈΡΠ΅ΡΠΊΠΈ Π²ΡΠ΅ΠΌΠΈ Π²Π΅Π΄ΡΡΠΈΠΌΠΈ ΡΠΈΡΠΌΠ°ΠΌΠΈ, Π·Π°Π½ΠΈΠΌΠ°ΡΡΠΈΠΌΠΈΡΡ ΠΏΡΠΎΠΈΠ·Π²ΠΎΠ΄ΡΡΠ²ΠΎΠΌ ΠΏΠΎΠ΄ΠΎΠ±Π½ΠΎΠΉ ΠΏΡΠΎΠ΄ΡΠΊΡΠΈΠΈ.
ΠΠΎΠΆΠ½ΠΎ ΡΠΊΠ°Π·Π°ΡΡ ΡΠ»Π΅Π΄ΡΡΡΠΈΠ΅ Π±ΡΠ΅Π½Π΄Ρ:
- Π’ΠΈΠΊΠΊΡΡΠΈΠ»Π°.
- Π€ΠΈΠ½Π½Π³Π°ΡΠ΄.
- Π¦Π΅ΡΠ΅Π·ΠΈΡ.
- ΠΠ»ΡΠΏΠΈΠ½Π°.
- Π‘Π½Π΅ΠΆΠΊΠ°.
ΠΠ· ΡΠΎΡΡΠΈΠΉΡΠΊΠΈΡ :
- Π€Π°ΡΠ°Π΄ΠΊΠ°.
- ΠΡΠ΅ΠΎΠ».
- ΠΠ΄ΠΌΠΈΡΠ°Π» ΠΈ Ρ.Π΄.

Π‘Π»Π΅Π΄ΡΠ΅Ρ ΠΏΠΎΠ½ΠΈΠΌΠ°ΡΡ, ΡΡΠΎ ΠΏΡΠΈΠ½Π°Π΄Π»Π΅ΠΆΠ½ΠΎΡΡΡ ΠΊΠ°ΠΊΠΎΠ³ΠΎ-Π»ΠΈΠ±ΠΎ ΡΠΎΡΡΠ°Π²Π° ΠΊ ΠΈΠ·Π²Π΅ΡΡΠ½ΠΎΠΌΡ Π±ΡΠ΅Π½Π΄Ρ Π΅ΡΠ΅ Π½Π΅ ΠΎΠ·Π½Π°ΡΠ°Π΅Ρ ΠΏΠΎΠ»Π½ΡΡ ΡΠΎΠ²ΠΌΠ΅ΡΡΠΈΠΌΠΎΡΡΡ Ρ Π΄Π°Π½Π½ΡΠΌ ΠΊΠΎΠ½ΠΊΡΠ΅ΡΠ½ΡΠΌ ΠΌΠ°ΡΠ΅ΡΠΈΠ°Π»ΠΎΠΌ, ΠΏΠΎΡΡΠΎΠΌΡ Π½Π΅ΠΎΠ±Ρ ΠΎΠ΄ΠΈΠΌΠΎ ΡΡΠΈΡΡΠ²Π°ΡΡ ΡΡΠ»ΠΎΠ²ΠΈΡ ΡΠΊΡΠΏΠ»ΡΠ°ΡΠ°ΡΠΈΠΈ ΠΈ ΠΌΠ°ΡΠ΅ΡΠΈΠ°Π» ΠΎΡΠ½ΠΎΠ²Π°Π½ΠΈΡ.
ΠΠ»Ρ ΠΊΠ°ΠΊΠΈΡ ΠΏΠΎΠ²Π΅ΡΡ Π½ΠΎΡΡΠ΅ΠΉ ΠΏΠΎΠ΄Ρ ΠΎΠ΄ΠΈΡ
Π‘ΠΈΠ»ΠΈΠΊΠΎΠ½ΠΎΠ²ΡΠ΅ ΡΠ°ΡΠ°Π΄Π½ΡΠ΅ ΠΊΡΠ°ΡΠΊΠΈ ΠΌΠΎΠ³ΡΡ Π±ΡΡΡ Π½Π°Π½Π΅ΡΠ΅Π½Ρ ΠΏΡΠ°ΠΊΡΠΈΡΠ΅ΡΠΊΠΈ Π½Π° Π»ΡΠ±ΠΎΠΉ ΡΠΈΠΏ ΠΎΡΠ½ΠΎΠ²Π°Π½ΠΈΡ:
- ΠΠ΅ΡΠΎΠ½.
- ΠΠΈΡΠΏΠΈΡ.
- Π¨ΡΡΠΊΠ°ΡΡΡΠΊΠ° (ΠΏΠ΅ΡΡΠ°Π½ΠΎ-ΡΠ΅ΠΌΠ΅Π½ΡΠ½Π°Ρ, ΡΠ°ΠΊΡΡΡΠ½Π°Ρ ΠΈ Ρ.Π΄.).
- Π‘ΡΠ°ΡΡΠ΅ ΠΏΠΎΠΊΡΡΡΠΈΡ (ΠΎΠΏΡΠΈΠΌΠ°Π»ΡΠ½ΠΎ β ΡΠΈΠ»ΠΈΠΊΠΎΠ½ΠΎΠ²ΡΠ΅), ΠΏΡΠΈ ΡΡΠ»ΠΎΠ²ΠΈΠΈ ΡΠΎΠ²ΠΌΠ΅ΡΡΠΈΠΌΠΎΡΡΠΈ ΠΏΠΎ Ρ ΠΈΠΌΠΈΡΠ΅ΡΠΊΠΎΠΌΡ ΡΠΎΡΡΠ°Π²Ρ.
ΠΠΎΠ΄Π½ΠΎΠ΄ΠΈΡΠΏΠ΅ΡΡΠΈΠΎΠ½Π½ΡΠ΅ ΡΠΎΡΡΠ°Π²Ρ ΠΏΠ»ΠΎΡ ΠΎ ΠΏΡΠΈΡΡΠ°ΡΡ ΠΊ ΡΡΠ°ΡΡΠΌ ΠΏΠΎΠΊΡΡΡΠΈΡΠΌ, ΠΈΠΌΠ΅ΡΡΠΈΠΌ ΠΆΠΈΡΠ½ΡΡ ΠΏΠΎΠ²Π΅ΡΡ Π½ΠΎΡΡΡ ΠΈΠ»ΠΈ ΡΠ°Π½Π΅Π΅ ΠΏΠΎΠΊΡΡΡΡΠ΅ ΠΌΠ°ΡΠ»ΡΠ½ΡΠΌΠΈ ΡΠΌΠ΅ΡΡΠΌΠΈ.

Π’Π°ΠΊΠΈΠ΅ ΠΏΠΎΠΊΡΡΡΠΈΡ ΠΏΠ΅ΡΠ΅Π΄ Π½Π°Π½Π΅ΡΠ΅Π½ΠΈΠ΅ΠΌ ΡΠΈΠ»ΠΈΠΊΠΎΠ½ΠΎΠ²ΡΡ ΠΌΠ°ΡΠ΅ΡΠΈΠ°Π»ΠΎΠ² Π½Π΅ΠΎΠ±Ρ ΠΎΠ΄ΠΈΠΌΠΎ ΡΠ΄Π°Π»ΡΡΡ, ΠΏΠ΅ΡΠ΅Π΄ Π½Π°Π½Π΅ΡΠ΅Π½ΠΈΠ΅ΠΌ Π½Π°Π΄ΠΎ Π½Π°Π½Π΅ΡΡΠΈ ΡΠ»ΠΎΠΉ ΡΠΈΠ»ΠΈΠΊΠΎΠ½ΠΎΠ²ΠΎΠΉ Π³ΡΡΠ½ΡΠΎΠ²ΠΊΠΈ Π³Π»ΡΠ±ΠΎΠΊΠΎΠ³ΠΎ ΠΏΡΠΎΠ½ΠΈΠΊΠ½ΠΎΠ²Π΅Π½ΠΈΡ Π΄Π»Ρ Π»ΡΡΡΠ΅ΠΉ Π°Π΄Π³Π΅Π·ΠΈΠΈ.
Π Π°ΡΡ ΠΎΠ΄ ΠΊΡΠ°ΡΠΊΠΈ Π½Π° 1ΠΊΠ².ΠΌ.
Π‘ΡΠ΅Π΄Π½ΠΈΠΉ ΡΠ°ΡΡ ΠΎΠ΄ ΡΠΈΠ»ΠΈΠΊΠΎΠ½ΠΎΠ²ΡΡ ΡΠ°ΡΠ°Π΄Π½ΡΡ ΠΊΡΠ°ΡΠΎΠΊ, Π·Π°ΡΠ²Π»ΡΠ΅ΠΌΡΠΉ ΠΏΡΠΎΠΈΠ·Π²ΠΎΠ΄ΠΈΡΠ΅Π»ΡΠΌΠΈ, ΡΠΎΡΡΠ°Π²Π»ΡΠ΅Ρ 150-200 Π³/ΠΊΠ².ΠΌ. (Π½Π΅ΠΊΠΎΡΠΎΡΡΠ΅ ΠΈΡΡΠΎΡΠ½ΠΈΠΊΠΈ ΡΠΊΠ°Π·ΡΠ²Π°ΡΡ Π³ΠΎΡΠ°Π·Π΄ΠΎ Π±ΠΎΠ»ΡΡΠΈΠ΅ Π²Π΅Π»ΠΈΡΠΈΠ½Ρ β ΠΎΡ 0,3 Π΄ΠΎ 0,6 ΠΊΠ³/ΠΊΠ². ΠΌ.).
ΠΡΠΈ ΡΡΠΎΠΌ, Π½Π° ΠΏΡΠ°ΠΊΡΠΈΠΊΠ΅ Π·Π½Π°ΡΠ΅Π½ΠΈΡ ΠΌΠΎΠ³ΡΡ Π±ΡΡΡ ΠΎΡΠ»ΠΈΡΠ½Ρ ΠΎΡ ΡΠΊΠ°Π·Π°Π½Π½ΡΡ Π½Π° ΡΠΏΠ°ΠΊΠΎΠ²ΠΊΠ΅. ΠΡΠΈΡΠΈΠ½Ρ ΡΠ°ΡΡ ΠΎΠΆΠ΄Π΅Π½ΠΈΠΉ Π² ΡΠΎΠΌ, ΡΡΠΎ ΡΡΠ»ΠΎΠ²ΠΈΡ ΡΠ°Π±ΠΎΡ Π½Π° ΠΏΠ»ΠΎΡΠ°Π΄ΠΊΠ΅ Π·Π½Π°ΡΠΈΡΠ΅Π»ΡΠ½ΠΎ ΠΎΡΠ»ΠΈΡΠ°ΡΡΡΡ ΠΎΡ ΠΎΠ±ΡΡΠ°Π½ΠΎΠ²ΠΊΠΈ Π² Π·Π°Π²ΠΎΠ΄ΡΠΊΠΎΠΉ Π»Π°Π±ΠΎΡΠ°ΡΠΎΡΠΈΠΈ, ΠΊΠ°ΡΠ΅ΡΡΠ²ΠΎ ΠΎΡΠ½ΠΎΠ²Π°Π½ΠΈΡ, Π²ΠΏΠΈΡΡΠ²Π°ΡΡΠ°Ρ ΡΠΏΠΎΡΠΎΠ±Π½ΠΎΡΡΡ ΠΈ ΠΏΡΠΎΡΠΈΠ΅ ΡΡΠ»ΠΎΠ²ΠΈΡ Π½Π°Π½Π΅ΡΠ΅Π½ΠΈΡ Π½Π΅ ΠΌΠΎΠ³ΡΡ Π±ΡΡΡ ΡΠΎΠ²Π΅ΡΡΠ΅Π½Π½ΠΎ ΠΎΠ΄ΠΈΠ½Π°ΠΊΠΎΠ²ΡΠΌΠΈ.
ΠΡΠΎΠΌΠ΅ ΡΠΎΠ³ΠΎ, Π½Π° ΡΠ°ΡΡ ΠΎΠ΄ Π²Π»ΠΈΡΠ΅Ρ ΠΏΠΎΠΊΠ°Π·Π°ΡΠ΅Π»Ρ Π²ΡΠ·ΠΊΠΎΡΡΠΈ ΠΊΡΠ°ΡΠΊΠΈ, ΠΎΡΠΎΠ±Π΅Π½Π½ΠΎ Π΅ΡΠ»ΠΈ ΡΡΠ΅ΡΡΡ ΡΠΎ ΠΎΠ±ΡΡΠΎΡΡΠ΅Π»ΡΡΡΠ²ΠΎ, ΡΡΠΎ Π³ΡΡΡΡΠ΅ ΡΠΎΡΡΠ°Π²Ρ ΡΠ°ΡΡΠΎ ΠΈΡΠΏΠΎΠ»ΡΠ·ΡΡΡΡΡ Π΄Π»Ρ ΠΏΠΎΠ»ΡΡΠ΅Π½ΠΈΡ ΡΠ°ΠΊΡΡΡΠ½ΡΡ ΠΏΠΎΠ²Π΅ΡΡ Π½ΠΎΡΡΠ΅ΠΉ.
ΠΡΠΎΠΌΠ΅ ΡΠΎΠ³ΠΎ, Π½Π΅ΠΎΠ±Ρ ΠΎΠ΄ΠΈΠΌΠΎ ΡΡΠΈΡΡΠ²Π°ΡΡ ΡΠ°Π·Π½ΠΈΡΡ Π²ΡΠ·ΠΊΠΎΡΡΠΈ ΡΠΎΡΡΠ°Π²Π° Π΄Π»Ρ ΠΏΠ΅ΡΠ²ΠΎΠ³ΠΎ ΠΈ Π²ΡΠΎΡΠΎΠ³ΠΎ ΡΠ»ΠΎΡ. ΠΡΠ»ΠΈ ΠΏΠ΅ΡΠ²ΡΠΉ ΡΠ»ΠΎΠΉ Π΄Π΅Π»Π°Π΅ΡΡΡ Π±ΠΎΠ»Π΅Π΅ Π³ΡΡΡΡΠΌ, ΡΠΎ Π²ΡΠΎΡΠΎΠΉ ΠΎΠ±ΡΡΠ½ΠΎ ΡΠ°Π·Π±Π°Π²Π»ΡΠ΅ΡΡΡ Π½Π° ΠΏΠΎΠ»ΠΎΠΆΠ΅Π½Π½ΡΠ΅ 5% Π²ΠΎΠ΄ΠΎΠΉ, ΡΡΠΎ ΡΠ½ΠΈΠΆΠ°Π΅Ρ ΡΠ°ΡΡ ΠΎΠ΄.
ΠΠ‘Π’ΠΠ ΠΠΠΠ!
Β ΠΡΠΈ ΡΠ°ΡΡΠ΅ΡΠ΅ Π½ΡΠΆΠ½ΠΎΠ³ΠΎ ΠΊΠΎΠ»ΠΈΡΠ΅ΡΡΠ²Π° ΠΌΠ°ΡΠ΅ΡΠΈΠ°Π»Π° Π½Π΅ΠΎΠ±Ρ ΠΎΠ΄ΠΈΠΌΠΎ ΡΡΠΈΡΡΠ²Π°ΡΡ ΡΠΈΡΠ»ΠΎ ΡΠ»ΠΎΠ΅Π², Π° ΠΏΠΎΠ»ΡΡΠ΅Π½Π½ΠΎΠ΅ ΠΊΠΎΠ»ΠΈΡΠ΅ΡΡΠ²ΠΎ ΠΌΠ°ΡΠ΅ΡΠΈΠ°Π»Π° Π½Π°Π΄ΠΎ ΡΠ²Π΅Π»ΠΈΡΠΈΠ²Π°ΡΡ Π½Π° 15-20% Π΄Π»Ρ ΠΊΠΎΠΌΠΏΠ΅Π½ΡΠ°ΡΠΈΠΈ Π²ΠΎΠ·ΠΌΠΎΠΆΠ½ΡΡ ΠΏΠΎΡΠ΅ΡΡ.
ΠΠΎΠ΄Π³ΠΎΡΠΎΠ²ΠΊΠ° ΠΏΠΎΠ²Π΅ΡΡ Π½ΠΎΡΡΠΈ ΠΊ Π½Π°Π½Π΅ΡΠ΅Π½ΠΈΡ
ΠΠ΅ΡΠ΅Π΄ Π½Π°Π½Π΅ΡΠ΅Π½ΠΈΠ΅ΠΌ ΠΊΡΠ°ΡΠΊΠΈ Π½Π΅ΠΎΠ±Ρ ΠΎΠ΄ΠΈΠΌΠΎ ΠΏΡΠΎΠΈΠ·Π²Π΅ΡΡΠΈ ΡΡΠ°ΡΠ΅Π»ΡΠ½ΡΡ ΠΏΠΎΠ΄Π³ΠΎΡΠΎΠ²ΠΊΡ ΠΏΠΎΠ²Π΅ΡΡ Π½ΠΎΡΡΠΈ ΡΡΠ΅Π½. ΠΠ»Ρ ΡΡΠΎΠ³ΠΎ ΡΠ»Π΅Π΄ΡΠ΅Ρ:
- Π£Π΄Π°Π»ΠΈΡΡ Π²ΡΠ΅ Π½Π°Π²Π΅ΡΠ½ΡΠ΅ ΡΠ»Π΅ΠΌΠ΅Π½ΡΡ β ΡΠΎΠ½Π°ΡΠΈ, ΠΊΡΠΎΠ½ΡΡΠ΅ΠΉΠ½Ρ, Π½Π°Π»ΠΈΡΠ½ΠΈΠΊΠΈ, ΡΠ΅ΠΊΠ»Π°ΠΌΠ½ΡΠ΅ ΡΠΈΡΡ Π²ΡΠ²Π΅ΡΠΊΠΈ ΠΈ Ρ.ΠΏ.
- ΠΡΠΌΠΎΡΡΠ΅ΡΡ ΡΡΠ΅Π½Ρ, ΠΎΠΏΡΠ΅Π΄Π΅Π»ΠΈΡΡ ΠΊΠΎΠ»ΠΈΡΠ΅ΡΡΠ²ΠΎ ΠΈΠ·ΡΡΠ½ΠΎΠ² β ΡΡΠ΅ΡΠΈΠ½, Π²ΡΠ±ΠΎΠΈΠ½, ΠΎΡΡΠΏΠ°Π½ΠΈΠΉ ΠΈΠ»ΠΈ ΠΎΡΡΠ»ΠΎΠ΅Π½ΠΈΠΉ.
- ΠΠ±Π½Π°ΡΡΠΆΠ΅Π½Π½ΡΠ΅ Π½Π΅ΡΠΎΠ²Π½ΠΎΡΡΠΈ ΠΏΠΎΠ΄Π»Π΅ΠΆΠ°Ρ Π·Π°Π΄Π΅Π»ΠΊΠ΅ ΠΏΡΠΈ ΠΏΠΎΠΌΠΎΡΠΈ ΡΠΏΠ°ΠΊΠ»Π΅Π²ΠΊΠΈ. ΠΡΠ»ΠΈ ΠΈΠ·ΡΡΠ½Ρ ΡΠ»ΠΈΡΠΊΠΎΠΌ Π·Π½Π°ΡΠΈΡΠ΅Π»ΡΠ½Ρ, ΡΠΎ ΠΏΡΠΈΠ΄Π΅ΡΡΡ Π½Π°Π½ΠΎΡΠΈΡΡ ΡΠΏΠ»ΠΎΡΠ½ΠΎΠΉ ΡΠ»ΠΎΠΉ ΡΡΡΠΊΠ°ΡΡΡΠΊΠΈ, ΠΎΡΠΎΠ±Π΅Π½Π½ΠΎ ΡΡΠΎ ΠΊΠ°ΡΠ°Π΅ΡΡΡ ΡΡΠ΅Π½ Ρ Π±ΠΎΠ»ΡΡΠΈΠΌ ΠΊΠΎΠ»ΠΈΡΠ΅ΡΡΠ²ΠΎΠΌ ΠΎΡΡΠΏΠ°Π½ΠΈΠΉ.

Π‘Π»ΠΎΠΉ ΡΡΡΠΊΠ°ΡΡΡΠΊΠΈ ΡΠ»Π΅Π΄ΡΠ΅Ρ Π²ΡΡΡΡΠΈΡΡ, Π½Π°Π½Π΅ΡΡΠΈ ΡΠ»ΠΎΠΉ Π³ΡΡΠ½ΡΠΎΠ²ΠΊΠΈ Π³Π»ΡΠ±ΠΎΠΊΠΎΠ³ΠΎ ΠΏΡΠΎΠ½ΠΈΠΊΠ½ΠΎΠ²Π΅Π½ΠΈΡ (ΠΈΡΠΏΠΎΠ»ΡΠ·ΠΎΠ²Π°ΡΡ ΡΠΎΡΡΠ°Π²Ρ, ΠΌΠ°ΠΊΡΠΈΠΌΠ°Π»ΡΠ½ΠΎ ΠΏΡΠΈΠ³ΠΎΠ΄Π½ΡΠ΅ ΠΊ ΠΊΠΎΠ½ΡΠ°ΠΊΡΡ Ρ ΡΠΈΠ»ΠΈΠΊΠΎΠ½ΠΎΠ²ΡΠΌΠΈ ΠΏΠΎΠΊΡΡΡΠΈΡΠΌΠΈ).
ΠΠΎΠ»Π΅ΡΠΎΠ²Π°Π½ΠΈΠ΅ ΠΊΡΠ°ΡΠΊΠΈ
ΠΠΎΠ»Π΅ΡΠΎΠ²Π°Π½ΠΈΠ΅ β ΡΡΠΎ ΠΏΡΠΎΡΠ΅ΡΡ ΡΠΎΠ΅Π΄ΠΈΠ½Π΅Π½ΠΈΡ Π±Π°Π·ΠΎΠ²ΠΎΠ³ΠΎ ΡΠΎΡΡΠ°Π²Π° Ρ ΠΎΠΏΡΠ΅Π΄Π΅Π»Π΅Π½Π½ΡΠΌ ΠΏΠΈΠ³ΠΌΠ΅Π½ΡΠΎΠΌ ΠΈΠ»ΠΈ ΠΊΠΎΠ»Π΅ΡΠΎΠ²ΠΎΡΠ½ΠΎΠΉ ΠΏΠ°ΡΡΠΎΠΉ.
ΠΡΠ° ΠΎΠΏΠ΅ΡΠ°ΡΠΈΡ ΠΌΠΎΠΆΠ΅Ρ ΠΎΡΡΡΠ΅ΡΡΠ²Π»ΡΡΡΡΡ ΠΊΠ°ΠΊ ΡΠ΅Π½ΡΡΠ°Π»ΠΈΠ·ΠΎΠ²Π°Π½Π½ΠΎ β ΠΏΡΠΈ Π·Π°ΠΊΠ°Π·Π΅ Π½Π΅ΠΎΠ±Ρ ΠΎΠ΄ΠΈΠΌΠΎΠ³ΠΎ ΠΊΠΎΠ»ΠΈΡΠ΅ΡΡΠ²Π° ΠΊΡΠ°ΡΠΊΠΈ Ρ ΠΏΡΠΎΠ΄Π°Π²ΡΠ° ΠΌΠΎΠΆΠ½ΠΎ ΡΡΠ°Π·Ρ ΡΠ΅ΡΠΈΡΡ Π²ΠΎΠΏΡΠΎΡ ΠΏΠΎ ΠΊΠΎΠ»Π΅ΡΠΎΠ²Π°Π½ΠΈΡ Π² Π½ΡΠΆΠ½ΡΠΉ ΡΠ²Π΅Ρ β ΡΠ°ΠΊ ΠΈ ΡΠ°ΠΌΠΎΡΡΠΎΡΡΠ΅Π»ΡΠ½ΠΎ.
ΠΠ»Ρ ΡΠΎΠ³ΠΎ, ΡΡΠΎΠ±Ρ ΠΊΠΎΠ»Π΅ΡΠΎΠ²Π°ΡΡ ΠΊΡΠ°ΡΠΊΡ, Π½Π°Π΄ΠΎ ΡΠΌΠ΅ΡΠ°ΡΡ Π±Π°Π·ΠΎΠ²ΡΠΉ ΡΠΎΡΡΠ°Π² Ρ Π½Π΅ΠΊΠΎΡΠΎΡΡΠΌ ΠΊΠΎΠ»ΠΈΡΠ΅ΡΡΠ²ΠΎΠΌ ΠΏΠΈΠ³ΠΌΠ΅Π½ΡΠ° (ΠΊΠΎΠ»Π΅ΡΠΎΠ²ΠΎΡΠ½ΠΎΠΉ ΠΏΠ°ΡΡΡ).
ΠΡΠ°ΠΊΡΠΈΡΠ΅ΡΠΊΠΈ ΡΡΠΎ Π΄ΠΎΡΡΠΈΠ³Π°Π΅ΡΡΡ ΠΎΠ±ΡΡΠ½ΡΠΌ Π²Π½Π΅ΡΠ΅Π½ΠΈΠ΅ΠΌ Π² Π΅ΠΌΠΊΠΎΡΡΡ Ρ ΠΊΡΠ°ΡΠΊΠΎΠΉ Π½Π΅ΠΊΠΎΡΠΎΡΠΎΠ³ΠΎ ΠΊΠΎΠ»ΠΈΡΠ΅ΡΡΠ²Π° ΠΏΠΈΠ³ΠΌΠ΅Π½ΡΠ° ΠΈ ΡΡΠ°ΡΠ΅Π»ΡΠ½ΡΠΌ ΠΏΠ΅ΡΠ΅ΠΌΠ΅ΡΠΈΠ²Π°Π½ΠΈΠ΅ΠΌ ΡΠΎΠ΄Π΅ΡΠΆΠΈΠΌΠΎΠ³ΠΎ Π΄ΠΎ ΠΏΠΎΠ»ΡΡΠ΅Π½ΠΈΡ ΡΠΎΠ²Π΅ΡΡΠ΅Π½Π½ΠΎ ΠΎΠ΄Π½ΠΎΡΠΎΠ΄Π½ΠΎΠΉ ΡΠΌΠ΅ΡΠΈ.
ΠΡΠΈ Π½Π΅ΠΎΠ±Ρ ΠΎΠ΄ΠΈΠΌΠΎΡΡΠΈ ΠΎΡΠ΄Π΅Π»ΡΠ²Π°ΡΡ Π±ΠΎΠ»ΡΡΠΈΠ΅ ΠΏΠ»ΠΎΡΠ°Π΄ΠΈ, Π½Π°Π΄ΠΎ Π²Π½ΠΈΠΌΠ°ΡΠ΅Π»ΡΠ½ΠΎ ΡΠ»Π΅Π΄ΠΈΡΡ Π·Π° ΠΊΠΎΠ»ΠΈΡΠ΅ΡΡΠ²ΠΎΠΌ Π΄ΠΎΠ±Π°Π²Π»ΡΠ΅ΠΌΠΎΠ³ΠΎ ΠΏΠΈΠ³ΠΌΠ΅Π½ΡΠ°, ΡΡΠΎΠ±Ρ Π²ΡΠ΅ Π΅ΠΌΠΊΠΎΡΡΠΈ ΠΈΠΌΠ΅Π»ΠΈ ΠΎΠ΄ΠΈΠ½Π°ΠΊΠΎΠ²ΡΠΉ ΠΎΡΡΠ΅Π½ΠΎΠΊ.
Π’Π΅Ρ Π½ΠΎΠ»ΠΎΠ³ΠΈΡ ΠΏΠΎΠΊΡΠ°ΡΠΊΠΈ ΡΠ°ΡΠ°Π΄Π° ΡΠΈΠ»ΠΈΠΊΠΎΠ½ΠΎΠ²ΠΎΠΉ ΠΊΡΠ°ΡΠΊΠΎΠΉ
ΠΠ»Ρ Π½Π°Π½Π΅ΡΠ΅Π½ΠΈΡ ΡΠ°ΡΠ°Π΄Π½ΠΎΠΉ ΠΊΡΠ°ΡΠΊΠΈ Π½Π΅ΠΎΠ±Ρ ΠΎΠ΄ΠΈΠΌΡ ΠΎΠΏΡΠ΅Π΄Π΅Π»Π΅Π½Π½ΡΠ΅ ΡΡΠ»ΠΎΠ²ΠΈΡ:
- Π’Π΅ΠΌΠΏΠ΅ΡΠ°ΡΡΡΠ° Π²ΠΎΠ·Π΄ΡΡ Π° Π² ΠΏΡΠ΅Π΄Π΅Π»Π°Ρ +5Β° β +30Β°.
- Π‘ΡΡ Π°Ρ ΠΏΠΎΠ³ΠΎΠ΄Π° (ΠΎΡΡΡΡΡΡΠ²ΠΈΠ΅ Π΄ΠΎΠΆΠ΄Ρ).
- ΠΠ΅ΡΠ΅Ρ ΡΠ»Π°Π±ΡΠΉ ΠΈΠ»ΠΈ ΡΠΎΠ²ΡΠ΅ΠΌ ΠΎΡΡΡΡΡΡΠ²ΡΠ΅Ρ.
- ΠΠ΅ΠΆΠ΅Π»Π°ΡΠ΅Π»ΡΠ½Ρ ΠΏΡΡΠΌΡΠ΅ ΡΠΎΠ»Π½Π΅ΡΠ½ΡΠ΅ Π»ΡΡΠΈ (ΠΎΠ±ΡΡΠ½ΠΎ Π»Π΅ΡΠ° Π·Π°Π²Π΅ΡΠΈΠ²Π°ΡΡ ΡΠΏΠ΅ΡΠΈΠ°Π»ΡΠ½ΠΎΠΉ ΡΠ΅ΡΠΊΠΎΠΉ).
ΠΠ°Π½Π΅ΡΠ΅Π½ΠΈΠ΅ ΠΌΠ°ΡΠ΅ΡΠΈΠ°Π»Π° ΠΏΡΠΎΠΈΠ·Π²ΠΎΠ΄ΠΈΡΡΡ Π²ΡΡΡΠ½ΡΡ (ΠΊΠΈΡΡΡΡ ΠΈΠ»ΠΈ Π²Π°Π»ΠΈΠΊΠΎΠΌ) ΠΈΠ»ΠΈ ΠΌΠ΅Ρ Π°Π½ΠΈΡΠ΅ΡΠΊΠΈΠΌ ΡΠΏΠΎΡΠΎΠ±ΠΎΠΌ (ΠΊΡΠ°ΡΠΊΠΎΠΏΡΠ»ΡΡ). ΠΡΠ»ΠΈ ΠΏΠΎΠ²Π΅ΡΡ Π½ΠΎΡΡΡ Ρ ΠΎΡΠΎΡΠΎ Π²ΠΏΠΈΡΡΠ²Π°Π΅Ρ ΠΌΠ°ΡΠ΅ΡΠΈΠ°Π», ΡΠ΅ΠΊΠΎΠΌΠ΅Π½Π΄ΡΠ΅ΡΡΡ ΠΏΠ΅ΡΠ²ΡΠΉ ΡΠ»ΠΎΠΉ Π½Π°Π½ΠΎΡΠΈΡΡ Π±ΠΎΠ»Π΅Π΅ ΠΆΠΈΠ΄ΠΊΠΎΠΉ ΠΊΠΎΠ½ΡΠΈΡΡΠ΅Π½ΡΠΈΠ΅ΠΉ, ΡΠΎΠ³Π΄Π° Π²ΡΠΎΡΠΎΠΉ ΡΠ»ΠΎΠΉ Π»ΡΠΆΠ΅Ρ ΡΠΎΠ²Π½Π΅Π΅, Π±Π΅Π· Π·Π°ΠΌΠ΅ΡΠ½ΡΡ ΠΏΡΡΠ΅Π½.

ΠΡΠ΅Π³ΠΎ ΡΠ΅ΠΊΠΎΠΌΠ΅Π½Π΄ΡΠ΅ΡΡΡ Π΄Π΅Π»Π°ΡΡ 2 ΡΠ»ΠΎΡ, Ρ ΠΎΡΡ Π² ΠΊΠ°ΠΆΠ΄ΠΎΠΌ ΠΊΠΎΠ½ΠΊΡΠ΅ΡΠ½ΠΎΠΌ ΡΠ»ΡΡΠ°Π΅ ΡΡΠΊΠΎΠ²ΠΎΠ΄ΡΡΠ²ΡΡΡΡΡ ΠΏΠΎΠ»ΡΡΠ΅Π½Π½ΡΠΌ ΡΠ΅Π·ΡΠ»ΡΡΠ°ΡΠΎΠΌ ΠΈ ΠΎΠΏΡΠ΅Π΄Π΅Π»ΡΡΡ Π½ΡΠΆΠ½ΠΎΠ΅ ΠΊΠΎΠ»ΠΈΡΠ΅ΡΡΠ²ΠΎ ΡΠ»ΠΎΠ΅Π² Π½Π° ΠΌΠ΅ΡΡΠ΅.
ΠΠΎΡΠ»Π΅ Π½Π°Π½Π΅ΡΠ΅Π½ΠΈΡ ΠΏΠ΅ΡΠ²ΠΎΠ³ΠΎ ΡΠ»ΠΎΡ ΡΡΠ΅Π±ΡΠ΅ΡΡΡ Π²ΡΠ΄Π΅ΡΠΆΠ°ΡΡ ΠΏΠΎΠ²Π΅ΡΡ Π½ΠΎΡΡΡ Π² ΡΠ΅ΡΠ΅Π½ΠΈΠ΅ 2-4 ΡΠ°ΡΠΎΠ² Π΄Π»Ρ Π²ΡΡΡΡ Π°Π½ΠΈΡ, ΠΏΠΎΡΠ»Π΅ ΡΠ΅Π³ΠΎ ΠΌΠΎΠΆΠ½ΠΎ Π½Π°Π½ΠΎΡΠΈΡΡ Π²ΡΠΎΡΠΎΠΉ ΡΠ»ΠΎΠΉ. ΠΠΊΠΎΠ½ΡΠ°ΡΠ΅Π»ΡΠ½ΠΎΠ΅ Π²ΡΡΡΡ Π°Π½ΠΈΠ΅ ΠΏΠΎΠΊΡΡΡΠΈΡ Π½Π°ΡΡΡΠΏΠ°Π΅Ρ ΡΠ΅ΡΠ΅Π· 12 ΡΠ°ΡΠΎΠ².

Π‘ΠΈΠ»ΠΈΠΊΠΎΠ½ΠΎΠ²Π°Ρ ΡΠ°ΡΠ°Π΄Π½Π°Ρ ΠΊΡΠ°ΡΠΊΠ° β ΠΎΡΠ»ΠΈΡΠ½ΠΎΠ΅ Π½Π°ΡΡΠΆΠ½ΠΎΠ΅ ΠΏΠΎΠΊΡΡΡΠΈΠ΅ Π΄Π»Ρ ΡΡΠ΅Π½, ΠΈΠΌΠ΅ΡΡΠ΅Π΅ Π²ΡΡΠΎΠΊΠΈΠ΅ ΡΠΊΡΠΏΠ»ΡΠ°ΡΠ°ΡΠΈΠΎΠ½Π½ΡΠ΅ ΠΊΠ°ΡΠ΅ΡΡΠ²Π°, Ρ ΠΎΡΠΎΡΠΎ ΡΠΎΡΠ΅ΡΠ°ΡΡΠ΅Π΅ΡΡ ΠΏΡΠ°ΠΊΡΠΈΡΠ΅ΡΠΊΠΈ Ρ Π»ΡΠ±ΡΠΌ ΡΠΈΠΏΠΎΠΌ ΠΎΡΠ½ΠΎΠ²Π°Π½ΠΈΠΉ, ΠΎΠ±Π»Π°Π΄Π°ΡΡΠ΅Π΅ Π²ΡΡΠΎΠΊΠΎΠΉ ΡΠ»Π°ΡΡΠΈΡΠ½ΠΎΡΡΡΡ, ΠΏΠ°ΡΠΎΠΏΡΠΎΠ½ΠΈΡΠ°Π΅ΠΌΠΎΡΡΡΡ ΠΈ Π²ΠΎΠ΄ΠΎΠΎΡΡΠ°Π»ΠΊΠΈΠ²Π°ΡΡΠΈΠΌΠΈ ΡΠ²ΠΎΠΉΡΡΠ²Π°ΠΌΠΈ.
Π’Π°ΠΊΠΎΠ΅ ΡΠΎΡΠ΅ΡΠ°Π½ΠΈΠ΅ ΠΊΠ°ΡΠ΅ΡΡΠ² ΠΌΠΎΠ³Π»ΠΎ Π±Ρ Π²ΡΠ²Π΅ΡΡΠΈ ΠΌΠ°ΡΠ΅ΡΠΈΠ°Π» Π² ΡΠ°Π·ΡΡΠ΄ Π½Π°ΠΈΠ±ΠΎΠ»Π΅Π΅ ΠΏΡΠ΅Π΄ΠΏΠΎΡΡΠΈΡΠ΅Π»ΡΠ½ΡΡ , Π½ΠΎ Π²ΡΡΠΎΠΊΠ°Ρ ΡΡΠΎΠΈΠΌΠΎΡΡΡ ΠΏΡΠΎΠ΄ΡΠΊΡΠΈΠΈ ΡΠ½ΠΈΠΆΠ°Π΅Ρ ΡΠΏΡΠΎΡ ΡΡΠ΅Π΄ΠΈ ΠΏΠΎΠ»ΡΠ·ΠΎΠ²Π°ΡΠ΅Π»Π΅ΠΉ. Π’Π΅ΠΌ Π½Π΅ ΠΌΠ΅Π½Π΅Π΅, ΠΌΠ°ΡΠ΅ΡΠΈΠ°Π» ΡΡΠΏΠ΅ΡΠ½ΠΎ ΠΊΠΎΠ½ΠΊΡΡΠΈΡΡΠ΅Ρ Ρ Π»ΡΠ±ΡΠΌ ΡΠΈΠΏΠΎΠΌ Π½Π°ΡΡΠΆΠ½ΠΎΠ³ΠΎ ΠΏΠΎΠΊΡΡΡΠΈΡ, ΡΠΎΠ·Π΄Π°Π²Π°Ρ ΡΡΠΈΠ»ΡΠ½ΡΠΉ ΠΈ Π²ΡΡΠΎΠΊΠΎΡΡΡΠ΅ΡΠΈΡΠ½ΡΠΉ ΠΎΠ±Π»ΠΈΠΊ Π΄ΠΎΠΌΠ°.
ΠΠΎΠ»Π΅Π·Π½ΠΎΠ΅ Π²ΠΈΠ΄Π΅ΠΎ
ΠΡΠΎΡΠ΅ΡΡ ΡΠΌΠ΅ΡΠΈΠ²Π°Π½ΠΈΡ ΡΠΈΠ»ΠΈΠΊΠΎΠ½Π° Ρ ΠΊΡΠ°ΡΠΊΠΎΠΉ:
beton-stroyka.ru
Π‘ΠΈΠ»ΠΈΠΊΠ°ΡΠ½Π°Ρ ΠΈ ΡΠΈΠ»ΠΈΠΊΠΎΠ½ΠΎΠ²Π°Ρ ΠΊΡΠ°ΡΠΊΠ° Π΄Π»Ρ ΡΠ°ΡΠ°Π΄Π°: ΡΠΎΡΡΠ°Π², ΠΎΡΠ»ΠΈΡΠΈΡ ΠΈ ΡΠ΅Π½Ρ
Π‘ΠΎΠ²ΡΠ΅ΠΌΠ΅Π½Π½ΡΠ΅ ΡΠ°ΡΠ°Π΄Π½ΡΠ΅ ΠΊΡΠ°ΡΠΊΠΈ ΡΠ°ΡΡΠΈΡΠΈΠ»ΠΈ Π°ΡΡΠΎΡΡΠΈΠΌΠ΅Π½Ρ Π·Π° ΡΡΠ΅Ρ ΠΏΠΎΡΠ²Π»Π΅Π½ΠΈΡ ΠΈΠ½Π½ΠΎΠ²Π°ΡΠΈΠΎΠ½Π½ΡΡ ΡΠ΅Ρ Π½ΠΎΠ»ΠΎΠ³ΠΈΠΉ ΠΏΡΠΎΠΈΠ·Π²ΠΎΠ΄ΡΡΠ²Π° ΡΠΈΠ»ΠΈΠΊΠΎΠ½ΠΎΠ²ΡΡ ΠΈ ΡΠΈΠ»ΠΈΠΊΠ°ΡΠ½ΡΡ ΡΠΎΡΡΠ°Π²ΠΎΠ² Π΄Π»Ρ Π½Π°ΡΡΠΆΠ½ΡΡ ΡΠ°Π±ΠΎΡ. ΠΠ½ΠΈ ΠΈΠΌΠ΅ΡΡ ΡΠ»ΡΡΡΠ΅Π½Π½ΡΠ΅ ΡΠ΅Ρ Π½ΠΈΡΠ΅ΡΠΊΠΈΠ΅ Ρ Π°ΡΠ°ΠΊΡΠ΅ΡΠΈΡΡΠΈΠΊΠΈ Π² ΡΡΠ°Π²Π½Π΅Π½ΠΈΠΈ Ρ ΡΡΠ°Π΄ΠΈΡΠΈΠΎΠ½Π½ΡΠΌΠΈ.Β ΠΠΎΠ²ΡΠ΅ ΡΠ²ΠΎΠΉΡΡΠ²Π° ΠΏΠΎΠ·Π²ΠΎΠ»ΡΡΡ ΠΏΠΎΠ»ΡΡΠ°ΡΡ ΡΡΡΠΎΠΉΡΠΈΠ²ΡΠΉ, Π΄ΠΎΠ»Π³ΠΎΠ²Π΅ΡΠ½ΡΠΉ ΡΠ΅Π·ΡΠ»ΡΡΠ°Ρ Π½Π° Π±ΠΎΠ»ΡΡΠΈΠ½ΡΡΠ²Π΅ Π²ΠΈΠ΄ΠΎΠ² ΠΎΡΠ½ΠΎΠ²Π°Π½ΠΈΠΉ (Π±Π΅ΡΠΎΠ½, ΡΡΡΠΊΠ°ΡΡΡΠΊΠ°, ΠΊΠΈΡΠΏΠΈΡ) ΠΈ ΠΏΡΠΎΠ³Π½ΠΎΠ·ΠΈΡΡΠ΅ΠΌΡΠΉ ΡΠ°ΡΡ ΠΎΠ΄ Π½Π° 1 ΠΌ2 ΠΏΡΠΈ Ρ ΠΎΡΠΎΡΠ΅ΠΉ ΡΠΊΡΡΠ²Π°ΡΡΠ΅ΠΉ ΡΠΏΠΎΡΠΎΠ±Π½ΠΎΡΡΠΈ.
ΠΠ³Π»Π°Π²Π»Π΅Π½ΠΈΠ΅:
- Π§ΡΠΎ ΠΏΡΠ΅Π΄ΡΡΠ°Π²Π»ΡΡΡ ΡΠΎΠ±ΠΎΠΉ ΡΠΈΠ»ΠΈΠΊΠΎΠ½ ΠΈ ΡΠΈΠ»ΠΈΠΊΠ°Ρ?
- ΠΡΠ΅ΠΈΠΌΡΡΠ΅ΡΡΠ²Π° ΠΈ ΡΡΠ΅ΡΠ° ΠΏΡΠΈΠΌΠ΅Π½Π΅Π½ΠΈΡ
- Π Π°ΡΡΠ΅Π½ΠΊΠΈ
Π‘ΠΎΡΡΠ°Π² ΠΈ Ρ Π°ΡΠ°ΠΊΡΠ΅ΡΠΈΡΡΠΈΠΊΠ° ΠΊΡΠ°ΡΠΎΠΊ
ΠΠ°ΠΆΠ΄Π°Ρ ΡΠΌΠ΅ΡΡ ΡΠ°Π·ΡΠ°Π±Π°ΡΡΠ²Π°Π΅ΡΡΡ Π΄Π»Ρ ΠΏΠΎΠ»ΡΡΠ΅Π½ΠΈΡ ΠΌΠ°ΠΊΡΠΈΠΌΠ°Π»ΡΠ½ΠΎΠ³ΠΎ ΡΡΡΠ΅ΠΊΡΠ° ΠΏΡΠΈ ΡΠΎΠ±Π»ΡΠ΄Π΅Π½ΠΈΠΈ ΠΎΠΏΡΠ΅Π΄Π΅Π»Π΅Π½Π½ΡΡ ΡΡΠ»ΠΎΠ²ΠΈΠΉ: Π²ΠΈΠ΄ ΠΏΠΎΠ²Π΅ΡΡ Π½ΠΎΡΡΠΈ, ΡΠ΅ΠΌΠΏΠ΅ΡΠ°ΡΡΡΠ° Π½Π°Π½Π΅ΡΠ΅Π½ΠΈΡ ΠΈ ΡΠΊΡΠΏΠ»ΡΠ°ΡΠ°ΡΠΈΠΈ, Π½Π°Π»ΠΈΡΠΈΠ΅ Π°Π³ΡΠ΅ΡΡΠΈΠ²Π½ΡΡ ΡΠ°ΠΊΡΠΎΡΠΎΠ² Π² ΠΎΠΊΡΡΠΆΠ°ΡΡΠ΅ΠΉ ΡΡΠ΅Π΄Π΅.Β ΠΒ ΠΊΠ°ΡΠ΅ΡΡΠ²Π΅ ΠΎΡΠ½ΠΎΠ²Ρ ΠΈΡΠΏΠΎΠ»ΡΠ·ΡΡΡΡΡ Π²ΠΎΠ΄Π° ΠΈΠ»ΠΈ ΡΠ°ΡΡΠ²ΠΎΡΠΈΡΠ΅Π»Ρ. ΠΒ ΡΠ΅Ρ Π½ΠΈΡΠ΅ΡΠΊΠΎΠΌ ΠΎΠΏΠΈΡΠ°Π½ΠΈΠΈΒ Π½Π° ΡΡΠΈΠΊΠ΅ΡΠΊΠ΅ ΡΠΊΠ°Π·ΡΠ²Π°ΡΡΡΡ Π²ΡΠ΅ ΡΡΡΠ΅ΡΡΠ²Π΅Π½Π½ΡΠ΅ ΡΠ²ΠΎΠΉΡΡΠ²Π°Β ΠΆΠΈΠ΄ΠΊΠΎΠ³ΠΎ ΠΈ Π·Π°ΡΠ²Π΅ΡΠ΄Π΅Π²ΡΠ΅Π³ΠΎ ΠΏΡΠΎΠ΄ΡΠΊΡΠ°, ΡΠ°ΡΡ ΠΎΠ΄ ΠΈ ΡΠ΅Ρ Π½ΠΎΠ»ΠΎΠ³ΠΈΡ ΠΎΠΊΡΠ°ΡΠΈΠ²Π°Π½ΠΈΡ.
1. Π‘ΠΈΠ»ΠΈΠΊΠΎΠ½.
Π‘Π²ΠΎΠ΅ΠΌΡ Π½Π°Π·Π²Π°Π½ΠΈΡ ΠΈ Π²ΡΡΠΎΠΊΠΈΠΌ ΡΠΊΡΠΏΠ»ΡΠ°ΡΠ°ΡΠΈΠΎΠ½Π½ΡΠΌ ΠΏΠ°ΡΠ°ΠΌΠ΅ΡΡΠ°ΠΌΒ ΡΠΈΠ»ΠΈΠΊΠΎΠ½ΠΎΠ²Π°Ρ ΠΊΡΠ°ΡΠΊΠ° ΠΎΠ±ΡΠ·Π°Π½Π° Π½Π°Π»ΠΈΡΠΈΡ ΡΠ²ΡΠ·ΡΡΡΠΈΡ ΡΠΌΠΎΠ», ΡΠΌΡΠ»ΡΠ³ΠΈΡΠΎΠ²Π°Π½Π½ΡΡ Π² ΠΎΠ³ΡΠ°Π½ΠΈΡΠ΅Π½Π½ΡΠΉ ΠΎΠ±ΡΠ΅ΠΌ Π²ΠΎΠ΄Ρ.Β ΠΠ½Π° ΡΠΎΠΎΡΠ²Π΅ΡΡΡΠ²ΡΠ΅Ρ ΡΠ°ΠΊΠΈΠΌ ΡΡΠ΅Π±ΠΎΠ²Π°Π½ΠΈΡΠΌ:
- ΠΌΠ΅Ρ Π°Π½ΠΈΡΠ΅ΡΠΊΠ°Ρ ΠΏΡΠΎΡΠ½ΠΎΡΡΡ;
- Π³ΠΈΠ΄ΡΠΎΡΠΎΠ±Π½ΡΠ΅ ΠΈ Π°Π½ΡΠΈΡΡΠ°ΡΠΈΡΠ΅ΡΠΊΠΈΠ΅ ΡΠ²ΠΎΠΉΡΡΠ²Π°;
- Π²ΡΡΠΎΠΊΠ°Ρ Π°Π΄Π³Π΅Π·ΠΈΡ Π±Π΅ΡΠΎΠ½Π½ΡΠΌ, ΡΠ΅ΠΌΠ΅Π½ΡΠ½ΠΎ-Π²ΠΎΠ»ΠΎΠΊΠ½ΠΈΡΡΡΠΌ, ΠΈΠ·Π²Π΅ΡΡΠΊΠΎΠ²ΡΠΌ ΠΏΠΎΠ²Π΅ΡΡ Π½ΠΎΡΡΡΠΌ;
- ΡΡΡΠΎΠΉΡΠΈΠ²ΠΎΡΡΡ ΠΊ ΡΠ»ΡΡΡΠ°ΡΠΈΠΎΠ»Π΅ΡΡ, Π±ΠΈΠΎΠ»ΠΎΠ³ΠΈΡΠ΅ΡΠΊΠΈΠΌ Π²ΠΎΠ·Π΄Π΅ΠΉΡΡΠ²ΠΈΡΠΌ, ΡΠ΅Ρ Π½ΠΎΠ³Π΅Π½Π½ΡΠΌ Π²ΡΠ±ΡΠΎΡΠ°ΠΌ ΠΏΡΠ΅Π΄ΠΏΡΠΈΡΡΠΈΠΉ Π² Π°ΡΠΌΠΎΡΡΠ΅ΡΠ½ΠΎΠΌ Π²ΠΎΠ·Π΄ΡΡ Π΅;
- ΠΏΠ°ΡΠΎΠΏΡΠΎΠ½ΠΈΡΠ°Π΅ΠΌΠΎΡΡΡ.

ΠΠ°ΡΠ²Π΅ΡΠ΄Π΅Π²ΡΠΈΠ΅ ΡΠΈΠ»ΠΈΠΊΠΎΠ½ΠΎΠ²ΡΠ΅ ΠΏΠΎΠΊΡΡΡΠΈΡ ΡΠΎΡ ΡΠ°Π½ΡΡΡ ΡΠ²ΠΎΠΈ Ρ Π°ΡΠ°ΠΊΡΠ΅ΡΠΈΡΡΠΈΠΊΠΈ ΠΈ Π½Π΅ ΡΡΠ°Π½ΠΎΠ²ΡΡΡΡ ΠΏΠ»Π°ΡΡΠΈΡΠ½ΡΠΌΠΈ ΠΏΠΎΠ΄ Π΄Π΅ΠΉΡΡΠ²ΠΈΠ΅ΠΌ ΡΠ΅ΠΏΠ»Π°, ΡΠ°ΠΊ ΠΊΠ°ΠΊ ΡΠΌΠΎΠ»Π° Π² ΠΈΡ ΡΠΎΡΡΠ°Π²Π΅ ΡΠ²Π»ΡΠ΅ΡΡΡ ΠΏΡΠΎΠΌΠ΅ΠΆΡΡΠΎΡΠ½ΠΎΠΉ ΡΠΎΡΠΌΠΎΠΉ ΠΌΠ΅ΠΆΠ΄Ρ ΠΌΠΈΠ½Π΅ΡΠ°Π»Π°ΠΌΠΈ ΠΈ ΠΎΡΠ³Π°Π½ΠΈΡΠ΅ΡΠΊΠΈΠΌΠΈ Π²Π΅ΡΠ΅ΡΡΠ²Π°ΠΌΠΈ. ΠΠ½ΠΈ Π΄ΠΎΡΡΠ°ΡΠΎΡΠ½ΠΎ ΡΠ»Π°ΡΡΠΈΡΠ½Ρ, ΡΡΠΎΠ±Ρ Π½Π΅ ΡΠ°ΡΡΡΠ΅ΡΠΊΠ°ΡΡΡΡ ΠΏΡΠΈ ΡΠΈΠΊΠ»ΠΈΡΠ΅ΡΠΊΠΈΡ ΡΠ΅ΠΌΠΏΠ΅ΡΠ°ΡΡΡΠ½ΡΡ ΡΠ°ΡΡΠΈΡΠ΅Π½ΠΈΡΡ /ΡΠΆΠΈΠΌΠ°Π½ΠΈΡΡ ΠΌΠ°ΡΠ΅ΡΠΈΠ°Π»ΠΎΠ² ΡΠ°ΡΠ°Π΄Π° Π·Π΄Π°Π½ΠΈΡ. ΠΠ΅ΡΠΏΠΎΡΠΎΠ±Π½ΠΎΡΡΡ Π½Π°ΠΊΠ°ΠΏΠ»ΠΈΠ²Π°ΡΡ ΡΠ»Π΅ΠΊΡΡΠΈΡΠ΅ΡΠΊΠΈΠΉ Π·Π°ΡΡΠ΄ ΠΏΡΠΈΠ²ΠΎΠ΄ΠΈΡ ΠΊ ΡΠΎΠΌΡ, ΡΡΠΎΒ ΠΊΡΠ°ΡΠΊΠ° ΠΏΡΠ°ΠΊΡΠΈΡΠ΅ΡΠΊΠΈ Π½Π΅ ΠΏΡΠΈΡΡΠ³ΠΈΠ²Π°Π΅Ρ ΡΠ°ΡΡΠΈΡΡ ΠΏΡΠ»ΠΈ ΠΈΠ· ΠΏΠΎΡΠΎΠΊΠΎΠ² Π²ΠΎΠ·Π΄ΡΡ Π°, Π½ΠΎ ΡΡΠΎ Π½Π΅ ΠΎΡΠ½ΠΎΡΠΈΡΡΡ ΠΊ ΠΆΠΈΡΠ½ΡΠΌ ΠΏΡΡΠ½Π°ΠΌ β ΠΈΡ ΠΏΡΠΈΠ΄Π΅ΡΡΡ ΡΡΠΈΡΠ°ΡΡ.
Π₯ΠΎΡΠΎΡΠΎ ΠΈΡΠΏΠΎΠ»ΡΠ·ΠΎΠ²Π°ΡΡ Π½Π° ΠΎΡΡΡΠΊΠ°ΡΡΡΠ΅Π½Π½ΡΡ ΠΊΠΎΠ½ΡΡΡΡΠΊΡΠΈΡΡ ΠΈΠ· Π½Π΅Π΄Π°Π²Π½ΠΎ ΠΈΠ·Π³ΠΎΡΠΎΠ²Π»Π΅Π½Π½ΡΡ Π³Π°Π·ΠΎΠ±Π΅ΡΠΎΠ½Π½ΡΡ Π±Π»ΠΎΠΊΠΎΠ². ΠΠΎΠΊΡΡΡΠΈΠ΅ Π½Π΅ ΠΎΠ±ΡΠ°Π·ΡΠ΅Ρ ΡΠΏΠ»ΠΎΡΠ½ΠΎΠΉ Π³Π΅ΡΠΌΠ΅ΡΠΈΡΠ½ΠΎΠΉ ΠΏΠ»Π΅Π½ΠΊΠΈ, ΠΎΠ½ΠΎΒ ΠΏΡΠ΅Π΄ΡΡΠ°Π²Π»ΡΠ΅Ρ ΡΠΎΠ±ΠΎΠΉ ΡΡΠ΅ΠΈΡΡΡΡ ΡΡΡΡΠΊΡΡΡΡ, ΡΠ΅ΡΠ΅Π· ΠΊΠΎΡΠΎΡΡΡ ΠΏΡΠΎΡ ΠΎΠ΄ΡΡ Π²ΠΎΠ΄ΡΠ½ΡΠ΅ ΠΏΠ°ΡΡ, ΡΠ³Π»Π΅ΠΊΠΈΡΠ»ΡΠΉ Π³Π°Π· ΠΈΠ· ΡΠ²Π΅ΠΆΠ΅ΠΉ ΠΊΠ»Π°Π΄ΠΊΠΈ ΠΈ ΡΠ°ΡΡΠ²ΠΎΡΠ° Π½Π΅ΡΡΡΠΈΡ ΡΡΠ΅Π½ Π·Π΄Π°Π½ΠΈΡ. ΠΡΠΎΡ ΠΆΠ΅ ΠΏΡΠΈΠ½ΡΠΈΠΏ Π΄Π΅ΠΉΡΡΠ²ΠΈΡ ΠΈΠΌΠ΅ΡΡ ΡΠΈΠ»ΠΈΠΊΠ°ΡΠ½ΡΠ΅ ΠΏΠΎΠ²Π΅ΡΡ Π½ΠΎΡΡΠΈ.
Π‘ΠΌΠ΅ΡΡ ΡΠ°Π·Π±Π°Π²Π»ΡΡΡ Π²ΠΎΠ΄ΠΎΠΉ Π΄ΠΎ Π΄ΠΎΡΡΠΈΠΆΠ΅Π½ΠΈΡ ΡΡΠ΅Π±ΡΠ΅ΠΌΠΎΠΉ ΠΊΠΎΠ½ΡΠΈΡΡΠ΅Π½ΡΠΈΠΈ. ΠΠ° ΠΏΠΎΡΠΈΡΡΡΡ ΠΏΠ»ΠΎΡΠΊΠΎΡΡΡΡ ΡΠ°ΡΡ ΠΎΠ΄ Π²ΠΎΠ·ΡΠ°ΡΡΠ°Π΅Ρ, Π½Π° Π³Π»Π°Π΄ΠΊΠΎΠΌ ΠΎΡΠ½ΠΎΠ²Π°Π½ΠΈΠΈ Π΄ΠΎΠΏΡΡΡΠΈΠΌΠΎ ΠΎΠΊΡΠ°ΡΠΈΠ²Π°Π½ΠΈΠ΅ Π² Π±ΠΎΠ»Π΅Π΅ ΠΆΠΈΠ΄ΠΊΠΎΠΌ ΡΠΎΡΡΠΎΡΠ½ΠΈΠΈ ΠΏΡΠΈ ΡΠΎΡ ΡΠ°Π½Π΅Π½ΠΈΠΈ Π·Π°Π΄Π°Π½Π½ΠΎΠΉ Ρ Π°ΡΠ°ΠΊΡΠ΅ΡΠΈΡΡΠΈΠΊΠΈ ΠΏΠΎΠ»ΡΡΠ΅Π½Π½ΠΎΠ³ΠΎ ΡΠ»ΠΎΡ. ΠΠ°ΠΆΠ½ΡΠΌ ΡΠ²ΠΎΠΉΡΡΠ²ΠΎΠΌ ΡΠ²Π»ΡΠ΅ΡΡΡ ΠΎΡΡΡΡΡΡΠ²ΠΈΠ΅ ΡΠ²Π½ΠΎ Π²ΡΡΠ°ΠΆΠ΅Π½Π½ΠΎΠΉ ΡΠ΅Π»ΠΎΡΠ½ΠΎΠΉ ΡΠ΅Π°ΠΊΡΠΈΠΈ, ΠΊΠΎΡΠΎΡΡΡ Π΄Π°ΡΡ ΡΠΈΠ»ΠΈΠΊΠ°ΡΡ, ΡΠ°ΡΡΠ²ΠΎΡΡ, ΡΠΎΠ΄Π΅ΡΠΆΠ°ΡΠΈΠ΅ ΠΈΠ·Π²Π΅ΡΡΡ, ΠΌΠ΅Π» ΠΈ ΡΠ΅ΠΌΠ΅Π½Ρ. Π Π»ΠΈΠ½Π΅ΠΉΠΊΠ΅ ΠΊΠ°ΠΆΠ΄ΠΎΠ³ΠΎ ΠΏΡΠΎΠΈΠ·Π²ΠΎΠ΄ΠΈΡΠ΅Π»Ρ ΠΌΠΎΠΆΠ½ΠΎ Π²ΡΠ±ΡΠ°ΡΡΒ Π»ΡΠ±ΠΎΠΉ ΠΎΡΡΠ΅Π½ΠΎΠΊ, Π΄Π°ΠΆΠ΅ ΡΡΠΊΠΈΠΉ. ΠΠ°ΡΠ΅ΡΡΠ²Π΅Π½Π½ΡΠ΅ ΡΠΈΠ»ΠΈΠΊΠΎΠ½ΠΎΠ²ΡΠ΅ ΠΌΠ°ΡΠ΅ΡΠΈΠ°Π»Ρ ΡΡΠΎΠΉΠΊΠΎ ΡΠΎΡ ΡΠ°Π½ΡΡΡ ΡΠ²ΠΎΠΉ ΠΏΠ΅ΡΠ²ΠΎΠ½Π°ΡΠ°Π»ΡΠ½ΡΠΉ ΡΠ²Π΅Ρ, ΠΈ ΡΡΠ΅Π½Ρ Π½Π΅ ΠΏΠΎΡΡΠ΅Π±ΡΡΡ ΠΎΠ±Π½ΠΎΠ²Π»Π΅Π½ΠΈΡ ΠΏΡΠΎΠ΄ΠΎΠ»ΠΆΠΈΡΠ΅Π»ΡΠ½ΠΎΠ΅ Π²ΡΠ΅ΠΌΡ.
2. Π‘ΠΈΠ»ΠΈΠΊΠ°Ρ.
ΠΡΠ½ΠΎΡΠΈΡΡΡΒ ΠΊ ΡΠ°Π·ΡΡΠ΄Ρ Π·Π°ΡΠΈΡΠ½ΡΡ ΡΠΈΠ½ΠΈΡΠ½ΡΡ ΠΏΠΎΠΊΡΡΡΠΈΠΉ Π΄Π»Ρ ΡΠ°ΡΠ°Π΄Π° ΠΊΠ°ΠΊ ΠΎΠ±ΡΠ΅Π³ΠΎ, ΡΠ°ΠΊ ΠΈ ΡΠΏΠ΅ΡΠΈΠ°Π»ΡΠ½ΠΎΠ³ΠΎ Π½Π°Π·Π½Π°ΡΠ΅Π½ΠΈΡ. ΠΡΠΈΠΌΠ΅Π½ΡΠ΅ΡΡΡ Π½Π° ΠΏΠΎΠ²Π΅ΡΡ Π½ΠΎΡΡΡΡ , ΠΎΡΡΡΠΊΠ°ΡΡΡΠ΅Π½Π½ΡΡ ΡΠ΅ΠΌΠ΅Π½ΡΠ½ΡΠΌ ΠΈΠ»ΠΈ ΠΈΠ·Π²Π΅ΡΡΠΊΠΎΠ²ΡΠΌ ΡΠ°ΡΡΠ²ΠΎΡΠΎΠΌ, Π΄Π»Ρ ΠΎΠ±Π½ΠΎΠ²Π»Π΅Π½ΠΈΡ ΠΏΠ»ΠΎΡΠΊΠΎΡΡΠΈ, Π½Π° ΠΊΠΎΡΠΎΡΠΎΠΉ ΠΌΠΎΠΆΠ΅Ρ ΠΏΡΠΈΡΡΡΡΡΠ²ΠΎΠ²Π°ΡΡ ΡΠΎΠ»ΡΠΊΠΎ ΡΡΠ°ΡΠ°Ρ ΠΊΡΠ°ΡΠΊΠ° (ΡΠΈΠ»ΠΈΠΊΠ°ΡΠ½Π°Ρ), Π½ΠΎ Π½Π΅ Π°ΠΊΡΠΈΠ»ΠΎΠ²ΡΠ΅, ΠΌΠ°ΡΠ»ΡΠ½ΡΠ΅ ΠΈΠ»ΠΈ Π΄ΡΡΠ³ΠΈΠ΅ ΠΏΠΎΠ»ΠΈΠΌΠ΅ΡΠ½ΡΠ΅ ΡΠΈΠΏΡ.
ΠΡΠ°ΡΠΊΠΈΠ΅ ΡΠ²Π΅Π΄Π΅Π½ΠΈΡ:
- ΠΠ·Π³ΠΎΡΠ°Π²Π»ΠΈΠ²Π°Π΅ΡΡΡ Π½Π° ΠΎΡΠ½ΠΎΠ²Π΅ ΠΆΠΈΠ΄ΠΊΠΎΠ³ΠΎ ΠΊΠ°Π»ΠΈΠ΅Π²ΠΎΠ³ΠΎ ΡΡΠ΅ΠΊΠ»Π° Ρ Π΄ΠΎΠ±Π°Π²ΠΊΠΎΠΉ Π½Π΅Π±ΠΎΠ»ΡΡΠΎΠ³ΠΎ ΠΊΠΎΠ»ΠΈΡΠ΅ΡΡΠ²Π° ΡΡΠΈΠ»ΡΠΈΠ»ΠΈΠΊΠ°ΡΠ° (ΡΠ²ΡΠ·ΡΡΡΠ΅Π΅). ΠΠΎΠΏΠΎΠ»Π½ΠΈΡΠ΅Π»ΡΠ½ΠΎ ΠΌΠΎΠΆΠ΅Ρ ΠΏΡΠΈΡΡΡΡΡΠ²ΠΎΠ²Π°ΡΡ ΠΊΡΠ΅ΠΌΠ½ΠΈΠΉ-ΠΎΡΠ³Π°Π½ΠΈΡΠ΅ΡΠΊΠ°Ρ ΡΠΌΠΎΠ»Π°, ΠΊΠΎΡΠΎΡΠ°Ρ Π½Π΅ΠΌΠ½ΠΎΠ³ΠΎ ΠΏΠΎΠ²ΡΡΠ°Π΅Ρ ΠΏΠ»Π°ΡΡΠΈΡΠ½ΠΎΡΡΡ, Π΄Π°Π΅Ρ Π²ΠΎΠ΄ΠΎΠΎΡΡΠ°Π»ΠΊΠΈΠ²Π°ΡΡΠΈΠΉ ΡΡΡΠ΅ΠΊΡ ΠΈ ΠΏΡΠΎΡΠ½ΠΎΡΡΡ ΠΏΠΎΠΊΡΡΡΠΈΡ.
- ΠΠ°ΠΏΠΎΠ»Π½ΠΈΡΠ΅Π»ΡΠΌΠΈ ΡΠ»ΡΠΆΠ°Ρ ΠΏΠΎΡΠΎΡΠΊΠΈ ΠΌΠ΅Π»Π°, ΡΠ»ΡΠ΄Ρ, ΡΠ°Π»ΡΠΊΠ°, Π΄ΠΎΠ·ΠΈΡΠΎΠ²ΠΊΠΎΠΉ ΠΊΠΎΡΠΎΡΡΡ ΠΏΠΎΠ»ΡΡΠ°ΡΡ Π² ΡΠ΅Π·ΡΠ»ΡΡΠ°ΡΠ΅ Π½ΡΠΆΠ½ΡΡ Π³ΡΡΡΠΎΡΡ.
- ΠΠ½ΡΠΈΠΊΠΎΡΡΠΎΠ·ΠΈΠΉΠ½ΡΠ΅ Π·Π°ΡΠΈΡΠ½ΡΠ΅ ΠΏΠ°ΡΠ°ΠΌΠ΅ΡΡΡ ΡΡΠΈΠ»ΠΈΠ²Π°ΡΡ ΠΏΠΈΠ³ΠΌΠ΅Π½ΡΠ°ΠΌΠΈ β ΠΏΡΠΎΠΈΠ·Π²ΠΎΠ΄Π½ΡΠΌΠΈ Π°Π»ΡΠΌΠΈΠ½ΠΈΡ ΠΈ ΡΠΈΠ½ΠΊΠ°.
- ΠΠΎΠ²ΡΡΠ΅Π½Π½ΠΎΠΉ ΠΆΠ°ΡΠΎΠΏΡΠΎΡΠ½ΠΎΡΡΡΡ ΠΈ ΡΡΡΠΎΠΉΡΠΈΠ²ΠΎΡΡΡΡ ΠΊ Π°Π³ΡΠ΅ΡΡΠΈΠ²Π½ΡΠΌ Ρ ΠΈΠΌΠΈΡΠ΅ΡΠΊΠΈΠΌ ΡΠΎΠ΅Π΄ΠΈΠ½Π΅Π½ΠΈΡΠΌ ΠΎΠ±Π»Π°Π΄Π°ΡΡ ΡΠΈΠ»ΠΈΠΊΠ°ΡΠ½ΡΠ΅ ΡΠΌΠ°Π»ΠΈ, ΠΊΠΎΡΠΎΡΡΠ΅ Π²ΡΠΏΡΡΠΊΠ°ΡΡΡΡ Π±Π΅Π· ΠΎΠΊΡΠ°ΡΠΈΠ²Π°Π½ΠΈΡ (ΠΏΡΠΎΠ·ΡΠ°ΡΠ½ΡΠ΅).
ΠΡΠΈ ΠΏΠΎΠΊΡΠΏΠΊΠ΅ ΡΠΎΠ²Π°ΡΠ° ΡΠ»Π΅Π΄ΡΠ΅Ρ Π·Π½Π°ΡΡ, ΡΡΠΎ ΠΈΠ½ΠΎΠ³Π΄Π° Π²ΡΡΡΠ΅ΡΠ°ΡΡΠΈΠ΅ΡΡ ΠΊΡΠ°ΡΠΊΠΈ Π½Π° ΠΎΡΠ½ΠΎΠ²Π΅ ΡΠΈΠ»ΠΈΠΊΠ°ΡΠ° Π½Π°ΡΡΠΈΡ ΠΈΠΌΠ΅ΡΡ Π±ΠΎΠ»Π΅Π΅ Π½ΠΈΠ·ΠΊΠΈΠ΅ Ρ Π°ΡΠ°ΠΊΡΠ΅ΡΠΈΡΡΠΈΠΊΠΈ, ΡΠ΅ΠΌ ΠΊΠ°Π»ΠΈΠΉΠ½ΡΠ΅.
ΠΡΠΈΡΡΡΡΡΠ²ΠΈΠ΅ Π² ΡΠΎΡΡΠ°Π²Π΅ Π°ΠΊΡΠΈΠ»ΠΎΠ²ΠΎΠ³ΠΎ Π²ΠΊΠ»ΡΡΠ΅Π½ΠΈΡ (Π΄ΠΎ 8%) ΡΠ½ΠΈΠΆΠ°Π΅Ρ Π½Π΅ ΡΠΎΠ»ΡΠΊΠΎ Π΅Π³ΠΎ ΡΡΠΎΠΈΠΌΠΎΡΡΡ, Π½ΠΎ ΠΈ ΡΠΊΡΠΏΠ»ΡΠ°ΡΠ°ΡΠΈΠΎΠ½Π½ΡΠ΅ ΠΏΠ°ΡΠ°ΠΌΠ΅ΡΡΡ. ΠΠ° ΡΡΠΈΠΊΠ΅ΡΠΊΠ΅ Π΄Π°Π½Π½ΠΎΠΉ ΠΏΡΠΎΠ΄ΡΠΊΡΠΈΠΈ ΠΏΡΠΈΡΡΡΡΡΠ²ΡΠ΅Ρ ΡΠ»ΠΎΠ²ΠΎ Β«Π΄ΠΈΡΠΏΠ΅ΡΡΠΈΠΎΠ½Π½Π°ΡΒ».
ΠΒ ΡΠ»ΡΡΠ°Π΅ ΠΏΡΠΈΠΎΠ±ΡΠ΅ΡΠ΅Π½ΠΈΡ ΠΈΠΌΠΏΠΎΡΡΠ½ΡΡ Β ΡΡΡΠΎΠΈΡΠ΅Π»ΡΠ½ΡΡ Π±ΡΠ΅Π½Π΄ΠΎΠ²Β ΡΠ°ΡΡ ΠΎΠ΄Β ΡΠΎΡΡΠ°Π²ΠΈΡ ΠΎΠΊΠΎΠ»ΠΎ 0,2 Π»/ΠΌΒ². ΠΠ»Ρ ΠΎΡΠ΅ΡΠ΅ΡΡΠ²Π΅Π½Π½ΡΡ ΠΌΠ°ΡΠΎΠΊ ΡΡΠΎ ΠΏΠΎΠΊΠ°Π·Π°ΡΠ΅Π»Ρ ΡΠ²Π΅Π»ΠΈΡΠΈΠ²Π°Π΅ΡΡΡ ΠΏΡΠ°ΠΊΡΠΈΡΠ΅ΡΠΊΠΈ Π² 2 ΡΠ°Π·Π° β ΠΎΡ 0,35 Π»/ΠΌΒ² Π΄ΠΎ 0,45 Π»/ΠΌΒ².
ΠΡΠ΅ΠΈΠΌΡΡΠ΅ΡΡΠ²Π° ΠΈ ΡΠ΅Π»Π΅Π²ΠΎΠ΅ ΠΏΡΠΈΠΌΠ΅Π½Π΅Π½ΠΈΠ΅
1. Π‘ΠΈΠ»ΠΈΠΊΠΎΠ½ΠΎΠ²ΡΠ΅ ΠΈ ΡΠΈΠ»ΠΈΠΊΠ°ΡΠ½ΡΠ΅ ΡΠ°ΡΠ°Π΄Π½ΡΠ΅ ΠΊΡΠ°ΡΠΊΠΈ ΡΠ°Π·ΡΠ°Π±ΠΎΡΠ°Π½Ρ Π΄Π»Ρ Π½Π°ΡΡΠΆΠ½ΠΎΠ³ΠΎ ΠΈΡΠΏΠΎΠ»ΡΠ·ΠΎΠ²Π°Π½ΠΈΡ, ΠΈΠΌΠ΅ΡΡ Π²ΡΡΠΎΠΊΠΈΠ΅ Ρ Π°ΡΠ°ΠΊΡΠ΅ΡΠΈΡΡΠΈΠΊΠΈ ΠΏΡΠΎΡΠ½ΠΎΡΡΠΈ, ΡΡΡΠΎΠΉΡΠΈΠ²ΠΎΡΡΠΈ ΠΊ Ρ ΠΈΠΌΠΈΡΠ΅ΡΠΊΠΈΠΌ ΠΈ ΠΈΡΡΠΈΡΠ°ΡΡΠΈΠΌ ΡΠ°ΠΊΡΠΎΡΠ°ΠΌ. Π§ΡΠΎΠ±Ρ ΠΏΡΠΈΠ΄Π°ΡΡ ΠΈΠΌ ΡΡΠΈ ΡΠ²ΠΎΠΉΡΡΠ²Π°, Π΄ΠΎΠ±Π°Π²Π»ΡΡΡΡΡ Π² ΡΠΎΠΌ ΡΠΈΡΠ»Π΅ ΠΈ Π²ΡΠ΅Π΄Π½ΡΠ΅ Π΄Π»Ρ Π·Π΄ΠΎΡΠΎΠ²ΡΡ Π²Π΅ΡΠ΅ΡΡΠ²Π°, ΠΏΠΎΡΡΠΎΠΌΡ Π½Π΅Π»ΡΠ·Ρ ΠΎΡΠΊΠ»ΠΎΠ½ΡΡΡΡΡ ΠΎΡ ΡΠ΅Π»Π΅Π²ΠΎΠ³ΠΎ Π½Π°Π·Π½Π°ΡΠ΅Π½ΠΈΡ, Π½Π°ΡΡΡΠ°ΡΡ ΡΠ΅Ρ Π½ΠΎΠ»ΠΎΠ³ΠΈΡΠ΅ΡΠΊΡΡ ΠΈΠ½ΡΡΡΡΠΊΡΠΈΡ ΠΏΡΠΎΠΈΠ·Π²ΠΎΠ΄ΠΈΡΠ΅Π»Ρ, ΡΠ½ΠΈΠΆΠ°ΡΡ ΡΠ΅ΠΊΠΎΠΌΠ΅Π½Π΄ΠΎΠ²Π°Π½Π½ΡΠΉ ΡΠ°ΡΡ ΠΎΠ΄, ΡΠ°Π±ΠΎΡΠ°ΡΡ Ρ Π½ΠΈΠΌΠΈ Π² ΠΆΠΈΠ»ΡΡ ΠΏΠΎΠΌΠ΅ΡΠ΅Π½ΠΈΡΡ .
2. ΠΠ΅Π²ΠΎΡΠΏΡΠΈΠΈΠΌΡΠΈΠ²Π°Ρ ΠΊ Π²ΡΡΠΎΠΊΠΈΠΌ ΡΠ΅ΠΌΠΏΠ΅ΡΠ°ΡΡΡΠ°ΠΌ, ΠΎΡΠΊΡΡΡΠΎΠΌΡ ΠΎΠ³Π½Ρ ΡΠΈΠ»ΠΈΠΊΠ°ΡΠ½Π°Ρ ΠΊΡΠ°ΡΠΊΠ°Β ΠΏΠΎΠ΄Π±ΠΈΡΠ°Π΅ΡΡΡ Π΄Π»Ρ ΠΏΠΎΠ²ΡΡΠ΅Π½ΠΈΡ ΠΎΠ³Π½Π΅ΡΡΠΎΠΉΠΊΠΎΡΡΠΈ ΡΠ°ΡΠ°Π΄ΠΎΠ² ΠΈ ΠΏΠΎΠ΄Ρ ΠΎΠ΄ΡΡΠΈΡ ΡΠ΅Ρ Π½ΠΎΠ»ΠΎΠ³ΠΈΡΠ΅ΡΠΊΠΈΡ ΠΊΠΎΠΌΠΌΡΠ½ΠΈΠΊΠ°ΡΠΈΠΉ. Π ΠΏΡΠΎΠΌΡΡΠ»Π΅Π½Π½ΡΡ Π·ΠΎΠ½Π°Ρ Π΅Π΅ Π²ΡΠ±ΠΈΡΠ°ΡΡ ΠΈΠ·-Π·Π° ΡΠΏΠΎΡΠΎΠ±Π½ΠΎΡΡΠΈ Π΄Π»ΠΈΡΠ΅Π»ΡΠ½ΠΎΠ΅ Π²ΡΠ΅ΠΌΡ ΠΏΡΠΎΡΠΈΠ²ΠΎΡΡΠΎΡΡΡ ΠΊΠΈΡΠ»ΠΎΡΠ½ΡΠΌ ΠΎΡΠ°Π΄ΠΊΠ°ΠΌ ΠΈ ΡΠ΅Ρ Π½ΠΎΠ³Π΅Π½Π½ΠΎΠΉ ΡΡΠΎΠ·ΠΈΠΈ.
3. ΠΡΠ΅Π΄ΠΎΡΠ²ΡΠ°ΡΠ°Π΅Ρ ΡΠΈΡΠΊ ΡΠ°Π·Π²ΠΈΡΠΈΡ Π½Π° ΠΏΠΎΠ²Π΅ΡΡ Π½ΠΎΡΡΠΈ Π³ΡΠΈΠ±ΠΊΠΎΠ², ΠΏΠ»Π΅ΡΠ΅Π½ΠΈ Π΄Π°ΠΆΠ΅ ΠΏΡΠΈ ΠΏΠΎΠ²ΡΡΠ΅Π½Π½ΠΎΠΉ Π²Π»Π°ΠΆΠ½ΠΎΡΡΠΈ ΠΎΠΊΡΡΠΆΠ°ΡΡΠ΅ΠΉ ΡΡΠ΅Π΄Ρ. Π ΡΠΎ ΠΆΠ΅ Π²ΡΠ΅ΠΌΡ Π²ΡΡΠΎΠΊΠ°Ρ ΠΏΠ°ΡΠΎΠΏΡΠΎΠ½ΠΈΡΠ°Π΅ΠΌΠΎΡΡΡ ΡΠ½ΠΈΠΌΠ°Π΅Ρ Π²ΠΎΠΏΡΠΎΡΡ Π²Π΅Π½ΡΠΈΠ»ΡΡΠΈΠΈ ΠΏΡΠΈ ΡΡΠ΅ΠΏΠ»Π΅Π½ΠΈΠΈ ΠΏΠ»ΠΈΡΠ°ΠΌΠΈ ΠΏΠ΅Π½ΠΎΠΏΠΎΠ»ΠΈΡΡΠΈΡΠΎΠ»Π° ΠΈΠ»ΠΈ ΡΠΏΠ»ΠΎΡΠ½ΡΠΌ Π½Π°ΠΏΡΠ»Π΅Π½ΠΈΠ΅ΠΌ ΠΏΠΎΠ»ΠΈΡΡΠ΅ΡΠ°Π½Π°.
4. ΠΠΎΠ³ΡΡ ΠΏΠΎΠ΄Π²Π΅ΡΠ³Π°ΡΡΡΡ ΠΌΠ΅Ρ Π°Π½ΠΈΡΠ΅ΡΠΊΠΎΠΉ ΡΠΈΡΡΠΊΠ΅ ΠΎΡ Π·Π°Π³ΡΡΠ·Π½Π΅Π½ΠΈΠΉ Π±Π΅Π· Π·Π°ΠΌΠ΅ΡΠ½ΠΎΠ³ΠΎ ΠΈΠ·ΠΌΠ΅Π½Π΅Π½ΠΈΡ Π²Π½Π΅ΡΠ½Π΅Π³ΠΎ Π²ΠΈΠ΄Π° ΠΏΠΎΠ²Π΅ΡΡ Π½ΠΎΡΡΠΈ. ΠΡΠΎΡΠ΅ΡΡ ΠΊΠ°ΡΠ±ΠΎΠ½ΠΈΠ·Π°ΡΠΈΠΈ ΠΆΠΈΠ΄ΠΊΠΎΠ³ΠΎ ΡΡΠ΅ΠΊΠ»Π° Π±ΡΡΡΡΠΎ ΠΏΡΠ΅Π²ΡΠ°ΡΠ°Π΅Ρ ΠΎΡΠ΄Π΅Π»ΠΎΡΠ½ΡΠΉ ΡΠ»ΠΎΠΉ Π² ΠΊΠ°ΠΌΠ΅Π½Ρ.
5. Π ΠΈΠ½Π΄ΠΈΠ²ΠΈΠ΄ΡΠ°Π»ΡΠ½ΠΎΠΌ ΡΡΡΠΎΠΈΡΠ΅Π»ΡΡΡΠ²Π΅ ΡΠ°ΡΠ΅ ΠΈΡΠΏΠΎΠ»ΡΠ·ΡΡΡΡΡ ΡΠΈΠ»ΠΈΠΊΠΎΠ½ΠΎΠ²Π°Ρ ΠΊΡΠ°ΡΠΊΠ°, ΡΠ°ΠΊ ΠΊΠ°ΠΊ Ρ Π½Π΅Π΅ Π±ΠΎΠ³Π°ΡΠ΅ ΠΈ ΡΡΡΠ΅ ΡΠ²Π΅ΡΠΎΠ²Π°Ρ ΠΏΠ°Π»ΠΈΡΡΠ°, ΡΡΠΎ Π²Π°ΠΆΠ½ΠΎ Π² Π΄ΠΈΠ·Π°ΠΉΠ½Π΅ ΠΏΡΠΈΠ΄ΠΎΠΌΠΎΠ²ΠΎΠΉ Π·ΠΎΠ½Ρ. ΠΠΎ ΡΡΠΎΠΈΠΌΠΎΡΡΡ Π½Π° Π½Π΅Π΅ Π²ΡΡΠ΅, ΡΠ΅ΠΌ Π½Π° ΡΠΈΠ»ΠΈΠΊΠ°Ρ.
Π‘ΡΠΎΠΈΠΌΠΎΡΡΡ
| ΠΠ°ΡΠΊΠ° | Π’ΠΈΠΏ | Π¦Π΅Π½Π°, ΡΡΠ±Π»ΠΈ |
| Baumit SilikatFarbe | ΡΠΈΠ»ΠΈΠΊΠ°ΡΠ½Π°Ρ | 110 Π·Π° 1 ΠΊΠ³ |
| Caparol Silitol Bio-Innenfarbe | ΡΠΈΠ»ΠΈΠΊΠ°ΡΠ½Π°Ρ | 4500 Π·Π° 10 Π» |
| LITOKOL LITOTHERM Paint Sil | ΡΠΈΠ»ΠΈΠΊΠΎΠ½ΠΎΠ²Π°Ρ | 4820 Π·Π° 20 ΠΊΠ³ |
| Caparol CapaSilan | ΡΠΈΠ»ΠΈΠΊΠΎΠ½ΠΎΠ²Π°Ρ | 8000 Π·Π° 10 Π» |
| Baumit SilikonFarbe | ΡΠΈΠ»ΠΈΠΊΠΎΠ½ΠΎΠ²Π°Ρ | 190 Π·Π° 1 ΠΊΠ³ |
| PUFAS Fassaden-Silikat | ΡΠΈΠ»ΠΈΠΊΠ°ΡΠ½Π°Ρ | 2150 Π·Π° 10 Π» |
ΠΠ»Ρ ΠΏΠΎΠΊΡΠ°ΡΠΊΠΈ ΠΏΠΎΠ΄Ρ ΠΎΠ΄ΡΡ Π²Π°Π»ΠΈΠΊ, ΠΊΠΈΡΡΡ ΠΈ ΡΠ°ΡΠΏΡΠ»ΠΈΡΠ΅Π»Ρ. ΠΡΠ½ΠΎΠ²Π°Π½ΠΈΠ΅ ΠΏΠ΅ΡΠ΅Π΄ ΡΡΠΈΠΌ ΡΡΠ°ΡΠ΅Π»ΡΠ½ΠΎ Π³ΡΡΠ½ΡΡΠ΅ΡΡΡ ΡΠ°ΡΡΠ²ΠΎΡΠΎΠΌ, ΡΠ΅ΠΊΠΎΠΌΠ΅Π½Π΄ΠΎΠ²Π°Π½Π½ΡΠΌ ΠΏΡΠΎΠΈΠ·Π²ΠΎΠ΄ΠΈΡΠ΅Π»Π΅ΠΌ. ΠΡΠ»ΠΈ Π½Π°Π½ΠΎΡΠΈΡΡΡ ΡΠΈΠ»ΠΈΠΊΠ°ΡΠ½Π°Ρ ΠΊΡΠ°ΡΠΊΠ°, ΡΠΎ ΡΠΎΠ»ΡΠΊΠΎ Π½Π° ΠΏΠΎΠ»Π½ΠΎΡΡΡΡ Π²ΡΡΠΎΡ ΡΡΡ ΠΈ Π½Π°Π±ΡΠ°Π²ΡΡΡ ΠΏΡΠΎΡΠ½ΠΎΡΡΡ ΡΡΡΠΊΠ°ΡΡΡΠΊΡ.
stroitel-list.ru
